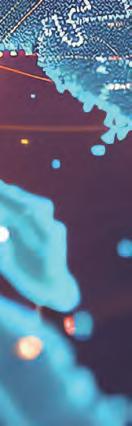

Begging to build
Cash-strapped governments seek financial aid for infrastructure
Trading blows
Trump’s frenzy of tariffs has wreaked havoc on global trade
In deep water
Deep-sea mining for critical minerals provokes criticism

![]()
Cash-strapped governments seek financial aid for infrastructure
Trump’s frenzy of tariffs has wreaked havoc on global trade
Deep-sea mining for critical minerals provokes criticism


After 60 years at the helm of Berkshire Hathaway, Warren Buffett has decided to step down as CEO, leaving behind a lifetime of invaluable advice and a trillion-dollar company










www.investbarbados.org

















Warren Buffett retires after 60 years at the helm of Berkshire Hathaway, leaving a lasting legacy of value investing, ethical leadership, and philanthropy that remains relevant in today’s uncertain markets
Governments face major infrastructure funding gaps and are urging private investors to help. Despite available capital, concerns over risk, liquidity, and shifting policies are hindering investment
DESIGNER:
Sam Millard
REPROGRAPHER: Robin Sloan
PRODUCTION MANAGER: Richard Willcox
WEB AND MOBILE DEVELOPMENT:
Scott Rouse
VIDEO PRODUCER:
Paul Richardson
EDITORIAL: Laura French
Courtney Goldsmith
Neil Hodge
Jemima Hunter
Graham Jarvis
Alex Katsomitros
Claire Millins
John Muchira
David Orrell
Selwyn Parker
Rachel Richards
Khatia Shamanauri
David Worsfold
Offshore finance has evolved from secretive tax havens into complex, adaptive systems. High-net-worth individuals now use crypto, second passports, and legal loopholes, as regulations struggle to keep pace globally
Trump’s sweeping tariffs have disrupted global trade, raising costs and triggering tensions among allies and rivals. Businesses now face uncertainty amid supply chain strain and geopolitical divisions
CONTRIBUTORS:
Martyn Cornell
Vikki Davies
Antonia Di Lorenzo
Barry Eichengreen
Anastassia Fedyk
Catherine Gooderham
Antara Haldar
Nick Hodgson
Emma Holmqvist
Ruth Kibble
Indrabati Lahiri
Stephen Roach
Hannah Smith

ACCOUNTS:
Gemma Willoughby
ILLUSTRATORS:
Richard Beacham
Jim Howells
BUSINESS DEVELOPMENT:
Bryan Charles
Tom Crosse
Michael Harris
Terry Johnson
James Watson
Monika Wojcik
Deep-sea mining in the Clarion-Clipperton Zone promises critical minerals but threatens fragile ecosystems. Amid geopolitical tensions, the US is pushing ahead despite global calls for caution
With climate-conscious Gen Z and Millennials demanding that brands adopt net-zero goals, ESG values, and transparent practices, businesses must act decisively or risk losing market share and talent
The information contained within this publication has been obtained from sources the proprietors believe to be correct. However, no legal liability can be accepted for any errors. No part of this publication may be reproduced without the prior consent of the Publisher.
Editorial on pages 30–37, 52–53, 116 & 124 © Project Syndicate, 2025
Web: www.WorldFinance.com
Email: enquiries@wnmedia.com
9
22
24 Financial History
We look at the evolution of banking, from ancient Mesopotamian grain and gold deposits, to merchant banking in Europe
26 Profile
Nvidia CEO Jensen Huang has helped steer the chipmaker to market dominance, placing it at the centre of the AI revolution
30 Comment
Anastassia Fedyk on the EU’s defence plan, Antara Haldar on the soul of economics, Barry Eichengreen on the dollar’s future and Stephen Roach on stagflation
186 The Econoclast
There is a marked contradiction between real world events and the persisting myths of mainstream economics
44 Neobanks
A hostile regulatory environment is holding back neobanks in Europe as they set their sights on the US market
46 Kazakhstan
Kazakhstan is on a path of economic growth as banks embrace AI and digital banking
50 Sri Lanka
Sri Lanka’s remarkable economic recovery continues, with its banks leading the efforts
56 Nigeria
Despite a global economy in turmoil, Nigeria’s economy actually grew in 2024, relying on its strong financial services sector
62 Macao
The bond market in Macao has exploded in recent years and is now an essential part of the financial ecosystem
64 Digital
CBDCs have become a political issue as China looks to internationalise the renminbi and challenge the dollar’s reserve status
74 Project Finance
Rapid growth of project finance in the GCC could see the Gulf becoming a post-oil leader in global infrastructure financing
78 Investment
Barbados has become a premier jurisdiction and investment hub for global business
88 Trade
Several obstacles stand in the way of Africa’s ambitious plan to revolutionise trade, investment and economic development
90 Insurance
A tailored approach for HNWIs in the form of Private Placement Life Insurance is helping to protect access to global assets
92 Private Equity
The explosion of private credit in the past 15 years could now be heading towards a geopolitical reckoning
94 Pensions
Retirement plans are at risk from global volatility, trade tensions and policy shifts 104 DORA
With a growth in the prevalence of cyber threats, the EU has introduced landmark regulation to protect digital infrastructure
106 Artificial Intelligence
An examination of the effects of AI-trading strategy on market predictability
110 Gaming
Gaming is now a multi-billion-dollar industry, redefining monetisation strategy, user engagement and digital economies
112 Trading
An influx of new traders has reinforced the need for innovation and financial literacy
118 Construction
The building materials industry must adapt to the challenges presented by climate change and resource scarcity
122 Geopolitics
Shifting geopolitical winds have set the stage for India to ramp up its production capabilities with renewed investor interest
132 Security
A structured and proactive approach is needed to combat personal threats levied at executives and leaders
134 Corporate Governance
The role of the board has evolved into one of individual competencies, emphasising longterm success and sustainable growth
144 Wellness
The growth of the wellness sector has made treatments such as cryotherapy and hyperbaric oxygen therapy more accessible
148 Indonesia
Dr Mulyani Indrawati has helped to transform Indonesia’s economy over a long and illustrious career as finance minister
150 Education
A look at how educators can support students in times of global conflict
152 The Arctic
An area of strategic value, the Arctic has long been part of Moscow’s long-term ambitions
160
False narratives spread online can have catastrophic reputational damage for companies and must not be downplayed
162 Revenue
There are increasingly a number of signs that the subscription economy has run into stark economic reality
164 Aviation
The shift towards sustainable aviation may require a multi-pronged approach. And how close are we to seeing autonomous aircraft?
170
A surge in demand for data centres has heightened the focus on more eco-friendly development, aimed at conserving resources









As the 8th largest bank in North America by assets1,2 , we’re fueling progress for individuals, families and businesses.
We’re proud to be recognized as Best Private Bank and Best Commercial Bank in Canada, and Best Commercial Bank in the US by World Finance Magazine.
1 As at January 31, 2025.


A freight train hauls goods along tracks in Brampton, Ontario earlier this year. Trade talks continue between Canada and the US after President Trump imposed 25 percent tariff s on Canadian steel, aluminium and assembled vehicles. Canada responded with 25 percent retaliatory tariff s on approximately $43bn of US imports.


Businesses and markets loathe uncertainty. Obviously, enterprises want to operate in an environment with predictable policies and where they can plan short to long term. Today, however, the marketplace is grappling with an environment that is changing at electric speed. US President Donald Trump is solely responsible for igniting and fuelling the uncertainties with his trade and tariff s war. Trump’s disruptive and flip-flopping policies have become a source of exasperation in boardrooms. The lack of clarity, stability and predictability is creating pandemonium in forecasting. In fact, institutions like the International Monetary Fund (IMF), World Bank, governments, corporations, economists and everyone else are finding it near impossible to make sound projections.
The quagmire is real. In April, for instance, the IMF, which is the heartbeat in economic forecasting and setting the tone in global growth, revised its outlook for 2025 downward to 2.8 percent, slashing some 0.5 points. In the same month, Boeing did something that is very rare – providing shareholders with two sets of earning guidance. One was based on the assumption that the US economy would plunge into recession while the second supposed it didn't. Undoubtedly, the inability to make reliable forecasts does not inspire hope. Coming when the world is easing from the pangs of high interest rates, runaway inflation and biting costs of living, the expectation was a rather optimistic immediate future. For companies, forecasting is critical. By painting a picture of the future, it informs decision-making, risk mitigation, and strategic planning. In short, it creates confidence. On the flip, failure to see the future means walking blind. The fact that predictions made at the beginning of the year have all been rendered ineffective means that businesses must keep going back to the drawing board. For investors, the apparent is elevated risks going by the volatility being witnessed across global markets. Good thing is that after going off a cliff following Trump’s April 2nd ‘Liberation Day’ tariff s, stocks have largely recovered. However, with the cloud of uncertainty still hovering, they remain deep in the woods.
TO READ MORE FROM WORLD FINANCE COLUMNISTS, VISIT: www.worldfinance.com/contributors

The price of gold soared to a record high in April as the safe haven continued its sharp rise over 2025. Spot gold prices hit $3,500 an ounce (see Fig 1), jumping up from $2,623 an ounce in January. The ballooning price means gold has already beaten many analysts’ predictions for the year. As recently as February, Goldman Sachs Research forecast the precious metal would rise to $3,100 a troy ounce by the end of the year, and that was already revised up from a previous prediction of $2,890. Now, experts say gold prices could be on course to $4,000.
It comes as part of a broader shift away from investments that are typically seen as safe havens during times of economic turbulence thanks to US President Donald Trump’s unpredictable trade policies, such as the US dollar and treasury bonds. JPMorgan expects gold prices will surpass its next milestone in 2026 – but it could come even sooner. “Underpinning our forecast for gold prices head-
The $3,500 mark was surpassed in the wake of Trump’s attack on Jerome Powell, the chair of the Federal Reserve. These comments caused an immediate spike over concerns around the future independence of the Fed, and gold prices may rise higher, faster, if Trump’s threats to fire Powell turn into action. But Stephen
SOURCE: TheGuardian
ing towards $4,000 per ounce next year is continued strong investor and central bank gold demand averaging around 710 tonnes a quarter on net this year,” the bank noted. In an “extreme” scenario, gold could even reach $4,500 by the end of 2025.
Innes, managing partner at the Swiss wealth management firm SPI Asset Management, told The Guardian that, regardless of what happens, the bigger picture is driving gold prices higher: “This is about more than Trump vs Powell. It’s about every corner of fiscal and monetary policy flashing one big red warning: confidence erosion.”

Lip-Bu Tan CEO Intel
Chipmaking giant Intel Corporation has appointed LipBu Tan as chief executive officer. Tan, an accomplished technology leader with 20 years of semiconductor and software experience, said he was “honoured” and “eager” to join the company. “I have tremendous respect and admiration for this iconic company, and I see significant opportunities to remake our business in ways that serve our customers better and create value for our shareholders,” he said. From 2009 to 2021, Tan served as CEO of Cadence Design Systems, during which time the company more than doubled its revenue.
VOICE OF THE MARKET
Market analysts celebrated the news of Tan’s appointment, with the company’s stock rising 15 percent immediately after the announcement. Recent financial struggles have made Intel an attractive target for a takeover. Tan, who Intel’s chair Frank Yeary called an “innovator,” is now tasked with turning around the company’s fortunes.
Ivan
Espinosa

CEO Nissan
Nissan has appointed 46-year-old Ivan Espinosa, a Mexico native with two decades of experience at the company, as its new CEO. Succeeding Makoto Uchida, Espinosa previously worked as Nissan’s chief planning officer, and his appointment came amid Nissan’s announcement of a “significantly renewed leadership line-up” in order to set the company up for future longterm growth and success.





Raja Akram CEO Deutsche Bank
The company has faced a string of scandals dating all the way back to 2018, when Carlos Ghosn was arrested on financial misconduct allegations before fleeing to Lebanon while on bail.
VOICE OF THE MARKET
After years of crises, Espinosa is on a mission to change the corporate culture at Nissan, which he has said is “lacking empathy.” He told reporters in March; “we need to work together as one single team.” While he faces a challenging start, Uchida believes he has youth on his side, describing Espinosa as “still in his 40s and full of energy.”
Deutsche Bank’s chief financial officer James von Moltke will be succeeded by Raja Akram, deputy chief financial officer at Morgan Stanley, following a brief transition period. Akram will join as designated CFO from October 2025 and become a member of the board effective January 2026. Prior to taking up his role at Morgan Stanley in 2020, Akram worked for Citigroup from 2006 to 2020, holding leadership positions in finance across multiple regions and businesses. Akram said he was “impressed” with the bank’s transformation in recent years and saw “immense growth potential.”
VOICE OF THE MARKET
Christian Sewing, CEO, praised Akram’s “excellent reputation as one of the most capable finance managers in the industry.” He added that Deutsche Bank will benefit from Akram's experience in senior positions at two leading global banks. The appointment is part of a broader leadership shake-up as the bank seeks to streamline operations.
The US dollar has long been the go-to currency for global trade. As the world’s top reserve currency, the greenback is the most widely used currency for trade and international transactions. However, analysts are starting to consider what ‘de-dollarisation’ would look like – what are the implications if the use of dollars in world trade suddenly plunges?
The dollar's global reserve currency status has been in place since the end of the Second World War, when, at the 1944 Bretton Woods Conference, 44 countries agreed to create the International Monetary Fund (IMF) and the World Bank. There, exchange rates as we know them today were created when the value of each currency was pegged to the dollar. As of 2023, the US dollar accounted for 59 percent of global foreign exchange reserves, with the euro in second place at 19.8 percent, and the Japanese yen in third with just 5.5 percent. Is it time for one of these or the other five major reserve currencies – the Australian dollar, the British pound sterling, the Canadian dollar, the Chinese renminbi or the Swiss franc – to take its throne?
“The narrative that the US dollar’s reserve currency status is being eroded has gained momentum as the world is dividing into trading blocs in the aftermath of Russia’s invasion of Ukraine and heightened US–China strategic competition,” Joyce Chang, chair of global research at JPMorgan, said late last year. The global trade crisis has only deepened in 2025. The BRICS countries, including Brazil, Russia, India, China, South Africa and five others, favour gold as a potential alternative to the dollar, though a central bank digital currency has also been suggested.
Meanwhile, European financial leaders could seize an opportunity. In April, the euro achieved its strongest level in three years, and European Central Bank vice president Luis de Guindos has touted the euro as an alternative to the dollar as a reserve currency in the coming years, so long as Europe continues to integrate. While the appetite for alternatives is growing, dedollarisation is unlikely to be right around the corner. For a framework as entrenched as the global financial system, change will not happen overnight.
TO READ MORE FROM WORLD FINANCE COLUMNISTS, VISIT: www.worldfinance.com/contributors




Streets filled with frustrated workers walking back home. Traffic lights and ATM machines out of service. Hospitals relying on generators to keep their intensive care units running. No, these are not scenes from the latest MadMaxsequel. The blackout in Spain and Portugal in April plunged both countries into chaos, a stark reminder of how critical energy security remains. Sure, older citizens may remember three-day weeks and power outages during the two oil crises in the 1970s. Yet, few anticipated witnessing such apocalyptic scenes half a century later. Modern economies were supposed to rely on a diverse mix of energy sources to ensure a minimum level of security. Is this a glimpse of the future? Hopefully not, but some caution is warranted. Climate change has pushed developed economies to accelerate their transition to clean energy and reduce carbon emissions. Spain has emerged as a world leader in renewable energy, tapping into its Mediterranean climate and vast swathes of land that are ideal for solar panel installation. One key takeaway is that the infrastructure has to be there before we bet the house – often quite literally – on renewables. International power grids have to be reliable. The problem seems to have originated in Spain due to a sudden spike in solar energy supply, but it soon spread to Portugal and parts of southern France. Alternatives like nuclear power should not be off-limits. Overreliance on renewables could prove disastrous for a continent grappling with war, inflation and strained relations with its trade partners. This does not mean that we should scrap net zero and revert to the good old days of ‘drill, baby, drill.’ Despite the Trump administration’s attempt to undo massive investment in renewables through the Inflation Reduction Act under Biden, Western economies should keep investing in green technologies. Environmental concerns aside, this is a geopolitical imperative if we want to reduce our dependence on gas and oil producing countries run by authoritarian regimes. However, this transition has to be smooth, cost-effective and secure. The chaotic scenes in Madrid and Lisbon last April suggest we still have a long way to go.
TO READ MORE FROM WORLD FINANCE COLUMNISTS, VISIT: www.worldfinance.com/contributors
Search giant Google announced its largest, most expensive acquisition to date, with a $32bn deal to buy the cloud security start-up Wiz. Wiz will join Google Cloud to ‘turbocharge’ cloud security as the company seeks to invest in trends accelerated by the AI era. Google CEO Sundar Pichai said businesses and governments that run in the cloud today are looking for stronger security solutions and greater choice in cloud computing providers. “Enabling more companies to prevent cyber attacks, including in very complex business software environments, will help organisations minimise the cost, disruption and hassle caused by cybersecurity incidents,” added Google Cloud CEO Thomas Kurian. The two companies “share a joint vision to make cybersecurity more accessible and simpler to use for organisations of any size and industry,” he said. The deal, Google hopes, will boost its cloud services arm, which lags behind those of rivals Amazon and Microsoft. While Google’s cloud earnings rose to $43bn in 2024, Amazon’s swelled to $107.6bn and Microsoft’s to $105.4bn. Wiz has quickly become a go-to name in the industry, with annual revenue
M&A
Rio Tinto has established itself as a global leader in the supply of lithium – a crucial element in products from smartphones to electric vehicles – following the completion of a $6.7bn deal to buy Arcadium Lithium. The acquisition, which will see Arcadium renamed to Rio Tinto Lithium, means the metals and mining corporation will have one of the largest lithium resource bases. “Together, we are accelerating our efforts to source, mine and produce minerals needed for the energy transition,” said Rio Tinto chief executive officer Jakob Stausholm. “By combining Rio Tinto’s scale, financial strength, operational and project development experience with Arcadium’s Tier one assets, technical and commercial capabilities, we are creating a world-class lithium business which sits alongside our leading iron ore, aluminium and copper operations.”

soaring from $1m to $100m in just 18 months in 2022. Now, the business is turning over $350m per year. The acquisition, Assaf Rappaport, co-founder and CEO of Wiz, said, will “bolster Wiz’s mission to improve security and prevent breaches by providing additional resources and deep AI expertise.”
However, Google’s success in leveraging this will require navigating a challenging integration, as well as regulatory concerns. Despite this, industry experts believe the acquisition could be a shot in the arm for the IPO market, as M&A activity has slowed. Cybersecurity companies have become particularly appealing in light of the rapidly growing AI market, with CB Insights naming it as a top acquisition target area of 2025.
M&A
Two Swiss insurers have agreed to merge to create Switzerland’s largest employer and its second-largest insurance company. The boards of Helvetia and Baloise decided on a merger of equals, creating a firm called Helvetia Baloise Holding, which will be listed on the SIX Swiss Exchange. With a combined market share of 20 percent, the deal is one of the biggest in Europe’s finance sector this year, and it is the biggest in Switzerland. Thomas von Planta, chairman of Baloise Holding, called the merger “a significant milestone in the history of the Swiss insurance industry,” and said it was “the next logical step” for both companies. “We are very excited about this amazing opportunity to build a European insurance leader with strong Swiss roots,” added Fabian Rupprecht, CEO of Helvetia.


A view of the Los Indianos Festival in Santa Cruz de La Palma, Canary Islands. It reenacts the return of Canarians who emigrated to the Americas and symbolises prosperity, nostalgia, and the historical ties between the Canary Islands and Latin America. Last year, holidaymakers spent a record breaking €22.9bn in the Canary Islands.

Two major US stock indices had their worst quarter since 2022 amid uncertainty in the US market sparked by president Donald Trump’s trade policy. The S&P 500 fell by more than 4.5 percent for the first quarter, but the tech-focused Nasdaq dropped even further, notching a 10.4 percent decline (see Fig 1). Meanwhile, the Dow Jones Industrial Average closed 1.3 percent down. This marked its first consecutive monthly drop since October 2023.
The losses bring an end to five straight quarters of gains and represent the worst quarter since 2022, when Russia’s invasion

Back in January, as the world was either anticipating or bracing itself for President Trump’s inauguration, few were expecting that his agenda would be as brutally fast as it has turned out to be. Internationally, the first salvos came in week two, with the announcement of tariffs against Canada, China and Mexico; now in week 10 we are embroiled in a full-scale trade war. Not even the man himself could accurately predict the state of US international trade or opinion by the time this issue hits the shelves.
of Ukraine shook the global economy and sanctions lifted prices of commodities like oil. The key difference this time around is that much of the economic pain is isolated to the US. Indeed, the first quarter was the S&P’s worst performance compared with the rest of the world since 1980, according to Dow Jones. In Europe, the Euro Stoxx 600 index rose five percent in the first quarter; the UK’s FTSE 100 jumped by more than five percent; and the MSCI index in China soared 16 percent. However, the wide-ranging impact of Trump’s tariffs mean that the rest of the world will not be immune for long.
stocks struggled during the first quarter of 2025
Domestically, in January corporate defence expert Kai Liekefett was advising companies to “buckle up and prepare themselves” for a rough proxy season. “Activist [investor]s were champing at the bit, they were popping champagne when Trump was elected,” he said in a video interview with WorldFinance
There were three main reasons why activist investors had supported Trump’s candidacy, he explained: “Number one, it’s taxes, it’s all about taxes. Trump, in his first administration, adopted massive tax cuts set to expire at the end of 2025, and activist investors – like many other investors – hope that those tax cuts will be extended.
“The second reason is deregulation. Trump was campaigning on the promise to deregulate America, and the hope, just generally speaking, is that deregulation will result in more economic growth.”
The third reason was tariffs. “Some activist investors I’ve spoken to say ‘well look, there may be market disruption as a result of those tariffs – that might not necessarily be bad for us activists because it’s going to result in market dislocation that we can exploit’,” he said.
However, the stock market volatility and potential impact to businesses caused by the tariffs may now be giving activists pause. “If activists launch a proxy contest, they generally must be prepared to remain in the stock… at least until the shareholder meeting and, if successful in obtaining board seats, at least six–12 months beyond that,” Liekefett explains in a shareholder activism update published to sidley.com. “From an activist’s perspective, now is a risky time to make a multi-year commitment to a particular company.”
TO FIND OUT MORE:
www.worldfinance.com/videos

percent market share and is one innovation, agility, and digital technologies; providing a memorable experience to our clients, supported by the best talent in the country,” said BPD’s Executive Vice President of Personal Business and Branches, Francisco Ramirez, in a video interview. “We promote innovation: streamlining project implementation and fostering an innovative culture through an Innovation Lab, where agile teams operate under scrum methodology.”
Some of these innovations have been recently launched as part of the Banco Popular Apps ecosystem – individual apps targeting niche segments of the population with services to meet their specific needs, instead of a single, overwhelming, all-or-nothing application.
“In the Micro-business App, the main goal is to drive cashless transactions within a vital sector of the economy,” Ramirez said. “This new application facilitates collections through QR technology, mobile top-ups, service payments, fund transfers, and cash withdrawals, offering an excellent user experience.”
A Remittance App “allows recipients to become bank clients and receive remittances through digital onboarding – offering convenient account management, direct remittance deposits, and versatile transactions through the extensive ATM network,” while the Youth Segment App “provides young individuals with a 100 percent digital user experience, facilitating their first account, debit card issuance, savings goal planning, and credit card requests.”
BPD’s long-term goal is supporting the economic health of the Dominican Republic and its people, Francisco explained. “Our digital transformation and ongoing innovations will play a huge part in achieving that.”
TO FIND OUT MORE: www.worldfinance.com/videos

Cryptocurrency supporters have called on the Swiss National Bank (SNB) to hold bitcoin in its reserves. The campaigners say that by buying bitcoin alongside its gold reserves, it will diversify its assets considerably, setting it on a much stronger footing amid the fallout of global trade tensions. In late 2024, the campaigners launched a referendum to change the Swiss constitution to require the SNB to buy bitcoin.
“Holding bitcoin makes more sense as the world shifts towards a multipolar order, where the dollar and the euro are weakening,” campaigner Luzius Meisser, a member of the advocacy group Bitcoin Initiative and board member of Bitcoin Suisse, said recently. Three-quarters of the bank’s foreign currency holdings are in dollars and euros, Meisser said. “Politicians eventually give in to the temptation of printing money to fund their plans, but bitcoin is a currency that cannot be inflated through deficit spending.”
Of any central bank that might take a punt on cryptocurrency, Switzerland is well placed. The country is home to ‘Crypto Valley’ in the small city of Zug, where decentralised blockchain and cryptocurrency Ethereum was founded. As of 2021, it was the most mature global blockchain hub, with a valu-
The SNB has rejected the idea, saying liquidity and volatility remain issues. “For cryptocurrencies, market liquidity, even if it may seem OK at times, is, especially during crises, naturally called into question,” said Martin Schlegel, SNB president, at the bank’s general assembly in April. “Cryptocurrencies also are known for their high volatility, which is a risk for long-term value preservation. In short, one can say that cryptocurrencies, for the moment, do not fulfill the high requirements for our currency reserves.” The campaigners have argued that by adding bitcoin to the treasury, the Swiss bank will complement its portfolio and gain hefty returns. “We are not saying ‘go all in with bitcoin,’ but if you have nearly one trillion francs in reserves, like the SNB does, then it makes sense to have one to two percent of that in an asset that is increasing in value, becoming more secure, and that everyone wants to own,” said Yves Bennaim of the Bitcoin Initiative.
ation over $500bn and boasting 14 unicorn companies. Along with a favourable regulatory environment, the Swiss have an open mind about crypto. One study by the Lucerne University of Applied Sciences and Arts found that 11 percent of the Swiss population has invested in cryptocurrency assets.



Marquinhos lifts the Champions League trophy at the end of final between Paris Saint-Germain and Internazionale in Munich on May 31, 2025. In its quest for silverware, PSG have spent over €1.9bn on players since state-operated Qatar Sports Investments (QSi) arrived ahead of the 2011–12 season.












Compounded by geopolitical tensions, the rise of AI and ever-evolving tools, cybercrime is predicted to cost an estimated $10.5trn by the end of this year, and it’s on the up; a recent cyber-attack on British retailer Marks & Spencer wiped £500m off its stock market value in a single week. Below are the statistics behind this growing threat, and its cost to individuals, businesses and economies.
Confidence in cyber resilience by country
Cybercrime expected to skyrocket
ESTIMATED ANNUAL COST OF CYBERCRIME WORLDWIDE (IN TRILLION US DOLLARS)
450,000+
New pieces of malware detected each day
$1.54 million
The average ransomware pay-out globally in 2023
$12.5 billion
Losses from cybercrime in 2023 in the US alone
1.24 million
Employees in cybersecurity in the US in September 2024
$9.36 million
Average cost of a data breach in the US in 2024
$15.63 trillion
Estimated global annual losses from cybercrime by 2029
$4.88 million
Average cost of a data breach globally in 2024
$29 billion
Projected global cyber insurance premiums by 2027
1 in 6 Internet users in Europe have experienced a data breach
78%
Increase in cybercrime spending from 2018 to 2024
97 %
Of organisations have seen an upsurge in cyber threats since the start of the Russia-Ukraine war in 2022
87%
Of C-level employees say their company isn’t adequately protected from cyber-attacks
69%
Increase in cybercrime victims from 2019 to 2020











climate agreement, it feels like the international commitment to keep global warming “well below 2°C” is ancient myth. President Trump has once again pledged
plans will see warming of 3.8°C by 2100, and barely five percent of signatory countries have submitted their latest 10-year plans to reduce emissions ahead of Brazil’s COP30 in November.
Some forward-thinking businesses, however, like Qatar-headquartered telecoms multinational Ooredoo, are serious about their responsibilities to mitigate climate change.
“Sustainability is a core value for Ooredoo,” Hilal Mohammed Al Khulaifi told WorldFinancein a video interview.
“To reduce our impacts on the environment, we are working towards reducing our carbon footprint,” the Group Chief Legal, Regulatory and Governance Officer explained. “We are increasing our usage of renewables to power our data centres, and implementing effective e-waste management programmes.”
Ooredoo has expanded rapidly through the MENA region, and serves 51 million customers across 10 different countries. This “posed some challenges in terms of governance,” Al Khulaifi said. “To ensure uniformity while allowing local execution, we adapted a centralised framework. This means that core governance principles remain the same, but there is flexibility to adapt to local regulations and cultural norms.”
For Al Khulaifi, “the sky is the limit. I see Ooredoo becoming a market leader in every country we operate – not just in numbers, but also in customer satisfaction and innovation.
“Sustainability will remain a cornerstone, with a goal to become a zero-carbon company by 2030… we also want to make sure that our workforce is as diverse and inclusive as the market we serve. Our guiding principles remain customer focus, innovation, integrity, and social responsibility. These aren’t just words; they are the DNA of Ooredoo.” TO FIND OUT MORE: www.worldfinance.com/videos

By the end of the decade, global public debt levels could rise to nearly 100 percent of the world’s gross domestic product (GDP), soaring above levels seen during the Covid-19 pandemic. Public debt will rise 2.8 percentage points to 95.1 percent of global GDP in 2025, according to the International Monetary Fund’s (IMF) Fiscal Monitor projections.
The group said debt would then continue to grow, reaching 99.6 percent of global GDP by 2030, and exceeding the 2020 rate of 98.9 percent of GDP, when governments around the world borrowed for economic relief during the pandemic. However, there is a chance global debt could balloon even higher.
The IMF’s forecast, as well as its projections for global GDP to rise 2.8 percent this year, is based on trade tariff developments through to April 4th. If higher tariffs and weakened growth prospects cause economic output to decline more than expected, the IMF said debt levels may rise above 117 per-
Global debt numbers are hiding a wide diversity across countries, with larger economies bearing the brunt of much of the recent debt growth, the IMF said. Of the IMF’s member countries, debt for around a third is growing at rates faster than before the pandemic, but these countries make up about 80 percent of
cent of GDP by 2027. This would represent the highest figure since the Second World War. An unpredictable trade war is not the only factor contributing to global debt. European countries have also taken an unprecedented stance to public spending in recent months as countries seek to boost defence spending following expectations President Donald Trump will pull back from prior US commitments to protect allies in Europe. “In view of the threats to our freedom and peace on our continent, ‘whatever it takes’ must now also apply to our defence,” said German chancellor Friedrich Merz. Germany made significant reforms to the cap on its budget deficit to allow it to direct more money into defence and infrastructure.
While this strategy still poses risks, the move marks “one of the most historic paradigm shifts in German postwar history,” Robin Winkler, chief economist at Deutsche Bank Research, told Politico
the global GDP. Finance ministers face “stark tradeoffs and painful choices,” said Vitor Gaspar, the IMF’s fiscal affairs director. “In these times of high uncertainty, fiscal policy must be an anchor for confidence and stability that can contribute to a competitive economy, delivering growth and prosperity for all,” Gaspar said.
Amid ongoing cost-of-living rises across the world, we look at how countries tally up and compare, as ranked by Wise’s Cost of Living Index. The index takes into account rent, food, transport and other factors, for nations spanning the globe
1 Switzerland (Rank 1)
Topping the list as the most expensive place to live in the world is Switzerland, where salaries averaged more than £75,000, gross per year, in 2022, according to the Federal Statistics Office. Business opportunities abound here, but they come with a hefty price tag; a one-bedroom flat in Geneva’s city centre costs an average of around £1,847 per month, according to Numbeo, and a threecourse lunch for two at a midrange restaurant in the city will set you back around £110. The city of Zurich follows closely behind Geneva for rent and food, while capital city Bern is a little more affordable, with monthly rent averaging around £1,096.
2 Singapore (Rank 4)
Following closely behind is Singapore, where rent is especially high – around £2,078 for a onebedroom flat in the centre of the city – but food is a little cheaper here; a three-course lunch costs an average of £48 for two people. A well-developed housing system means around 90 percent of residents in Singapore own their own homes, and the country benefits from a good public health system as well. The average gross salary is around £40,220 a year, according to research by Morgan McKinley, with a UBS 2024 report finding that the average Singaporean adult has £300,000 in wealth. There is also an impressive 330,000 millionaires currently living in the country too.
3
(Rank 7)
Among the most expensive countries in Europe is Denmark in the north. The city of Copenhagen ranked 11th in the world in Mercer’s Cost of Living City Ranking 2024, with rent for a central onebedroom flat in the city costing around £1,384 on average, and other living expenses estimated at around £890 per month, according to Numbeo. Three courses at a mid-range restaurant in the capital comes in at an average price of around £90 for two people. The costs are well compensated for by an exceptionally high standard of living and this is perhaps reflected in the fact that the country has featured in the top 10 of the World Happiness Report every year since 2013.
4 US (Rank 9)
The US makes the top 10 and ranks 9th on the cost-of-living list, with New York officially the country’s most expensive city to live in. The city scores 100 on Wise’s Cost of Living index (compared to a nationwide average of 70.4), with monthly rent averaging around £2,110, according to Zillow. It is followed closely by San Francisco, where rent averages about £2,031 per month, while Tucson, Las Vegas, Phoenix, San Antonio, Austin and Boise are all counted among the cheapest spots. As a country-wide average, statistics by Numbeo say a three-course meal at a mid-range restaurant will cost around £56 for two people, a loaf of bread costs around £3 and a pint of beer costs around £6.
5 Australia (Rank 10)
Following hot on the heels of the US is the country of Australia in tenth place. Sydney ranks as the world’s 58th most expensive city, according to Mercer’s Cost of Living Ranking, with the average monthly rent in the city centre coming in at around £1,193, compared with the marginally cheaper offerings of around £894 in Melbourne and about £839 in Perth. Groceries in Australia are among the most expensive in the world, with the cost of meals comparable to London. The country’s minimum wage is also among one of the highest in the world, coming in at £11.60 an hour, with average salaries around 30 percent higher than in the UK, according to Clear Currency.
6
(Rank 27)
Ranked as the second most expensive country in the Middle East, the UAE has an average cost of living score of 55.8. Dubai is the country’s priciest city, with rent for a city-centre, one-bedroom apartment averaging around £1,314, according to Pacific Prime Insurance. On average, Numbeo says a mid-range three-course meal in the country costs around £60 for two, a local beer costs around £8, and a loaf of bread costs around £0.95. The World’s Wealthiest Cities Report 2025 by Henley & Partners meanwhile found there were 72,500 millionaires and 20 billionaires in Dubai in 2024, although the average monthly net salary across the country after tax is only £31,260.
7
(Rank 53)
Mexico ranks third in Latin America after Costa Rica and Panama, but prices vary significantly across the country. Mexico City, Los Cabos, Monterrey, Cancun, Curenavaca and Guadalajra rank among its most expensive cities, while Tlaxcala, Zacatecas, Guanajuato and Tuxtla Gutierrez are its cheapest. Rent in a large apartment in Mexico City averages roughly £800 a month, compared to around £462 in Guadalajara and around £527 in Cancun. Average household net-adjusted disposable income per capita is around £12,264 a year, according to the OECD Better Life Index, giving the country a relatively high cost of living, with the biggest salaries in Mexico City and Nuevo León.
Counted among the cheapest countries featured in the ranking is India, with an overall cost of living score of 21.2. Mumbai ranks as the country’s costliest city, with Gurgaon (India’s second biggest tech hub and largest civil aviation hub), Bangalore and Delhi following behind. A three-course meal in a mid-range restaurant in Mumbai costs around £16 for two people, an inexpensive meal costs around £3.50 and a local beer is around £1.80, according to Numbeo. Rent in the city is on average 81.4 percent lower than in New York, the same source says, with a one-bedroom city centre flat going for an average of £517 per month; the equivalent in Delhi is just £190 per month.
From grain and gold deposits in the temples of ancient Mesopotamia and Greece to the rise of merchant banks across Europe and beyond, the financial system is no new phenomenon. Here we chart its evolution, from the birth of central banks to the digital era, and explore just how far banking has come in the past five millennia.
3000–200 BC

The world’s first banking systems emerged in ancient Mesopotamia over 5,000 years ago. Temples were used to store grains, gold and other commodities; these would be lent to local farmers and merchants, who would repay the loans with interest from the harvest. Centuries later in ancient Greece and Rome, temples were used again, and argentarii bankers would provide loans, accept deposits and offer currency exchange.


and then redeem it in Jerusalem, protecting pilgrims from theft en route. Templars also offered loans to monarchs, brokered deals and managed estates, mirroring many modern financial services.


In the 14th and 15th centuries, Italy became a leading hub for banking. In 1397, the Medici family founded Medici Bank in Florence, introducing double-entry bookkeeping, bills of exchange and letters of credit. They also used their wealth to support Italian artists, helping to fuel the Renaissance. Other banks followed, including Banca Monte dei Paschi di Siena in 1472, and Berenberg Bank, founded in Germany in 1590.
The following years saw several institutions founded across Europe, including the Bank of Amsterdam in 1609. Considered by many as the first central bank, it was established to stabilise local currency and support the city’s trade. At the time, coins from different countries were circulating without a stable exchange rate system; the bank adjusted supply to match demand and issued deposits backed by metal reserves.

A number of other central banks began to appear in the 17th century – including Sweden’s Sveriges Riksbank in 1668, and the Bank of England, founded in 1694. The following year, the Bank of England became one of the first to issue banknotes. These first came in the form of handwritten promissory notes, then printed notes backed by reserves. By the mid-1700s, notes from £20 to £1,000 were in circulation.
As banking continued to grow in Europe, Alexander Hamilton – the first secretary of the US Treasury – argued for a national financial system in the US. As it stood, there was no single currency, and states printed their own money. The First Bank was founded in 1791 to support the federal government. It closed 20 years later, but laid the foundations for the Federal Reserve, founded in 1913, which established a uniform national currency. 1694

The 19th and 20th centuries saw several innovations, including the invention of the telephone, which transformed communication between banks, enabling the first wire transfers. 1967 saw the introduction of the first ATM, installed by Barclays Bank. In the 1980s, digital banking began to appear; the Bank of Scotland offered home banking as early as 1985, and Stanford Credit Union launched the first online banking website in 1994.

The 2000s saw the dawn of mobile banking, revolutionised by smartphones. In the 2010s, digital-only challenger banks such as Revolut and Starling appeared and banks began to use AI and machine learning. How these technologies will impact the sector is uncertain, but one thing is clear – it is unlikely the Mesopotamians, Greeks and Romans could have envisaged just quite how far their temple deposits and seed loans legacy would develop.

















Whether you're starting a new project or looking to grow your business, we're here to support you every step of the way.



We're proud to have been recognised as the Best Retail Bank in Portugal 2025, by World Finance magazine. This recognition inspires us to continue helping you turn your ideas into reality.
Find out more at santander.pt The prize is the sole responsibility of the entity who awarded it.











Jensen
Huang
CEO & CO-FOUNDER, NVIDIA
After decades of quiet success building chipmaker Nvidia, Jensen Huang is reaping the rewards of hugely profitable bets. Can the CEO of the now-trilliondollar company’s winning streak continue?
It would be virtually impossible to find a member of the public, let alone one who works in business and finance, who could not recognise six of the seven socalled ‘Magnificent Seven’ technology stocks. These companies – Apple, Microsoft, Googleparent Alphabet, Amazon, Facebook-owner Meta and Tesla – have long been household names. They are makers of products and software that millions of consumers use on a daily basis. But the seventh and most-recent entrant into the ranks of the most valuable tech companies is still unknown to many, despite being at the very centre of today’s most explosive market.
Nvidia is a trillion-dollar company that still manages to fly under the radar. A swift acceleration in its share price, from around $14 per share at the start of 2023 to more than $153 this year, has sent its valuation soaring, but the company is no newcomer to the tech world – and neither is its CEO, Jensen Huang.
Huang has been at the helm of Nvidia since its founding more than three decades ago, steering the company through economic shocks, near collapse and, finally, to wild success. What started as a maker of computer chips designed to render realistic 3D video game graphics now provides the technology that trains the world’s most powerful artificial intelligence (AI) programs.
Many attribute Nvidia’s success to Huang’s leadership and vision. “Nvidia’s rise from a
small graphics chip maker to the AI giant it is today is nothing short of remarkable, and the success story has a lot, if not everything, to do with Nvidia’s co-founder and CEO, Jensen Huang,” Kate Leaman, chief market analyst at AvaTrade, told World Finance.
For some CEOs, a little bit of luck can lead to overnight success. But despite achieving this in the most literal sense – Nvidia’s market value increased by about $200bn in one day alone after it became known that its chips powered ChatGPT – Huang’s slow and methodical rise is a different story.
Still, critics question whether the AI boom, which has powered Nvidia’s growth, is sustainable. And as chips become prized national assets, geopolitical tensions are ramping up over these precious materials, but a fragmented market could be a problem for a company with global ambitions. Is Huang, who is tasked with walking the line between the world’s largest global powers all while staying at the cutting edge of a rapidly growing industry, the man for the job?
A vision of the future
Invariably dressed in his iconic black leather jacket, Huang’s uniform is reminiscent of Steve Jobs’ plain black turtleneck or Mark Zuckerburg’s casual T-shirts. But while he looks the part of the CEO of a $3trn tech company today, he was not entirely confident of Nvidia’s success from day one. About the company’s
early days, Huang is said to have described its prospects with his typical down-to-earth sense of humour, saying it had a “market challenge, a technology challenge, and an ecosystem challenge with approximately zero percent chance of success,” according to a report by Quartr. What, then, led him to overcome those challenges to reach such great heights?
“Huang is a visionary,” Leaman said. “He saw, since 1993, the year of Nvidia’s inception, a bigger future for the company than just chips for gamers. Today, Nvidia’s chips are used to train and run some of the most powerful AI computing systems in the world.”
Indeed, under Huang’s leadership, Nvidia has capitalised on the explosive interest in AI. Today, more than 35,000 companies use its AI technologies, including most major tech firms, from Amazon to Google to Microsoft. Tech heavyweights and even world leaders court Huang as they jostle for a larger share of Nvidia’s sought-after chips.
Huang bet on the right technologies to propel Nvidia to success. But there is more to it than his vision alone, according to Alex de Vigan, founder and CEO at Nfinite, a Parisbased tech firm that works with Nvidia. “For me, what sets Jensen Huang apart isn’t just vision – it is patience and precision. Nvidia didn’t pivot to AI overnight. They invested in developer ecosystems, scientific computing and graphics at a time when few others saw the throughline.”
CURRICULUM VITAE
BORN: 1963 | EDUCATION: OREGON STATE UNIVERSITY, STANFORD

1992
Huang gained a master’s degree in electrical engineering from Stanford after graduating from Oregon State University, where he met his future wife.
1993
Alongside Chris Malachowsky and Curtis Priem, Huang created Nvidia in a Denny’s booth with $40,000 of starting capital and a plan to bring 3D graphics to gaming.
From dishwasher to CEO
Huang has attributed the resilience that helped him build one of the world’s biggest tech companies to his childhood. Born JenHsun Huang in 1963 in Taiwan, Huang arrived in the US when he was nine years old and soon became the youngest child at a boarding school in rural Kentucky. His first working experience was a typical teenager’s first job, working as a dishwasher at a local Denny’s restaurant. This experience has stayed with him, and he has claimed his ability to stay calm and perform under pressure is down to spending his formative years working through long rush hours at the diner chain. Huang worked his way up from dishwasher to waiter, and, years later, in a Denny’s booth outside of San Jose, he, along with Chris Malachowsky and Curtis Priem, founded Nvidia. Huang’s connection with the diner chain has been immor-
1999
After nearly crashing out of business in 1996, Nvidia invented the graphics processing unit (GPU), which would go on to reshape the computing industry.
2006 Nvidia launched its CUDA architecture, which created the possibility for GPUs to be used in other sectors and subsequently opened the door for explosive growth.
talised with a commemorative plaque on the booth where it all started. After graduating high school early, Huang attended Oregon State University to study electrical engineering. There, he met his wife Lori, and the pair eventually moved to Silicon Valley to join the fast-growing market for semiconductors. Before starting Nvidia, Huang gained industry experience with a short stint at AMD, working on microprocessors, and climbing the ranks at LSI Logic, a semiconductor manufacturer. AMD and Broadcom, which bought LSI Logic, are now rivals of Nvidia.
From the Denny’s booth, Huang and his two co-founders named their company after the Latin word for envy, invidia, and competitors today would surely agree it was a prescient word to choose. But Nvidia’s road to success wasn’t easy or straightforward. Just a few years after its founding, Nvidia came danger-
“Building a company turned out to be a million times harder than any of us expected it to be”
Jensen Huang
2024
Huang announced Nvidia’s Blackwell chip, “a processor for the generative AI era,” at GTC, an annual developer conference. The entire 2025 production quickly sold out.
2025
This year, a stock market filing revealed Huang would receive his first pay rise in more than a decade, with total pay rising to just under $50m, with a base salary of $1.5m.
ously close to bankruptcy, but it was saved by the launch of the RIVA 128 graphics card in 1997. This was the first chip that put Nvidia on the map. “Building a company, and building Nvidia, turned out to be a million times harder than any of us expected it to be,” Huang said on the podcast Acquired, which covers tech listings and acquisitions. “If we had realised the pain and suffering and just how vulnerable you are going to feel and the challenges that you are going to endure and the embarrassment and the shame and the list of all the things that go wrong, I don’t think anybody would start a company.”
But those struggles paid off because Nvidia built more than a product. “Nvidia has succeeded because it didn’t just build chips, it built an ecosystem,” said de Vigan. The creation of CUDA, Nvidia’s computing platform, in 2006, was “brilliant,” he said. CUDA allowed
graphics processing units (GPUs), which were then only for gaming, to be used more widely, thus expanding Nvidia’s potential market size. “By enabling developers early on to build and scale (machine learning) workloads on their architecture, they locked in relevance before AI was mainstream.”
This strategy is one Huang continues to employ. “Today, their edge is not just silicon, but platforms like Omniverse,” de Vigan con tinued. Omniverse, according to Nvidia’s web site, “plays a foundational role in the building of the metaverse, the next stage of the inter net.” De Vigan said this platform “speaks di rectly to where AI is going: physical simula tion, robotics, and digital twins. They are not selling hardware, they are really enabling the future of machine perception and autonomy.”
Breaking conventions
Nvidia’s company culture is as eye-catching as its product, and another likely cause of its success, yet Huang receives almost as much criticism for it as he does praise. In an inter view with CBS News’ ployees labelled Huang as ‘demanding’ and a ‘perfectionist’ and said he wasn’t easy to work for. Huang, who is known for his angry out bursts, didn’t disagree with this assessment. “It should be like that,” he told journalist Bill Whitaker. “If you want to do extraordinary things, it shouldn’t be easy.”
Start-ups are known for challenging con ventions in workplace culture and company structure, but it is much less common to see large companies like Nvidia bucking trends. Huang has made a point of doing so as Nvidia’s size has grown exponentially. For example, Huang has as many as 50 direct reports, compared with most CEOs, who have a dozen or fewer. The reason? To do away with unnecessary management and keep the company agile. However, it could also be seen as an attempt to micromanage rather than delegate.

dollar club,” Leaman explained.
As well as keeping up with dozens and dozens of direct reports, Huang receives tens of thousands of emails per week detailing employees’ priority areas. The T5T, to ‘top five things’ emails are brief, bullet-pointed notes where employees can discuss what they are working on or most interested in, and they have become a way for Huang to keep his finger on the pulse of the business. It all feeds into his vision of constantly being on the lookout for the next big thing. He reads each email, and it is not unusual for him to reply.
It is evident that Huang still enjoys being deeply involved in the day-to-day operations of Nvidia. “More than just a CEO, Huang is an engineer,” Leaman said. “He likes to get involved in the details.”
School of Business, harking back to his days at Denny’s washing dishes and cleaning toilets. “If you send me something and you want my input on it and I can be of service to you – and, in my review of it, share with you how I reasoned through it – I have made a contribution to you,” he said. He doesn’t simply jump into his reports’ projects and take over. “I show people how to reason through things all the time: strategy things, how to forecast something, how to break a problem down,” he said. “You’re empowering people all over the place.”
Huang is known for explaining difficult tech in simple words and for creating a company culture where taking risks is part of the job, Leaman said. “Inside Nvidia, it is common to hear people say ‘fail fast.’ They know that trying, failing, and trying again is how breakthroughs happen.” Indeed, Huang frequently asks employees to act as if the company has only 30 days until it goes bust.
It is this culture – reminiscent of Mark Zuckerberg’s famous motto, ‘Move fast and break things’ – that has driven Nvidia to where it is today. “In the 2000s, during the tech crash, while his counterparts were cutting back, Huang went all-in on research, a move that surely helped propel the company
While his leadership style may be unconventional, his longevity and many loyal employees speak to its success. Still, his greatest asset may be his ability to predict the next big thing in tech. “What makes Huang stand out is his ability to see 10 years ahead and build the tools the world will need when it catches up,” Leaman said. If he can leverage this skill today, when uncertainty is on the rise worldwide, the coming years could prove another pivotal point for Nvidia.
With the artificial intelligence sector in the midst of rapid growth, the question experts are asking now is how much more room it has to grow. The US remains the hottest market, with private investment in the sector growing to $109.1bn in 2024, nearly 12 times China’s $9.3bn, according to Stanford’s 2025 AI Index Report. More and more companies are integrating AI into their systems, with 78 percent of organisations reporting using AI in 2024, up from 55 percent the previous year. As AI remains in its early development phase, there are still opportunities to take a slice of the market, and companies continue to crop up in the sector.

$3.6trn
he agreed that some speculative capital will “evaporate,” he called the overarching changes “foundational.” “AI isn’t a single product category – it is becoming the operating system of both the physical and digital economy.”
bad thing. It is driving innovation. The key is that this can benefit everyone if we maintain open access to models, new AI algorithms, model training innovations and responsible AI safety standards.”
$130.5bn
Full-year revenue of fiscal 2025, up 114%
Nvidia’s record market value $50m
Huang’s annual salary for 2025 32
Years Huang has been CEO of Nvidia 3
Between 2010 and 2023, the number of AI patents has grown from around 3,800 to more than 122,000. In the last year alone, the number of AI patents rose 29.6 percent. For some critics, the AI industry’s ballooning growth is ringing alarm bells. Jim Chanos, the founder of Kynikos Associates, a short-selling specialist, pointed out to Reuters that tech capex in the US contributed almost a full percentage point to gross domestic product (GDP) in the first quarter of 2025. The last time it did that was just before the peak of the dotcom bubble.
“There is no question we are in a phase of inflated expectations,” said Neil Cawse, founder and CEO of Geotab, a Canadian creator of fleet management technology. “But calling it a bubble misses the point. AI isn’t a passing trend; it is infrastructure. Like electricity or the internet, it is becoming part of the baseline of how work gets done.” Cawse admits there is a lot of hype surrounding AI, and not every start-up or use case for the technology will succeed. “But the core technology is already delivering. At Geotab, we are starting to see 30–50 percent efficiency gains. That is not speculative; it is real, measurable output. A potential game changer on the scale of the Industrial Revolution,” he said.
De Vigan believes that AI is not a bubble but a “restructuring of the value chain.” While
Yet even if there is no bubble, more challenges will arise as companies like Nvidia are forced to keep pace with competition. With companies like AMD snapping at Nvidia’s heels and threatening to take more GPU market share, and growing ranks of new start-ups entering the sector, AI will remain a fiercely competitive industry. Meanwhile, the very foundations of the sector are being shaken by geopolitical forces.
As the go-to chipmaker around the world, Nvidia has seen demand soar, but the US government is attempting to put the brakes on some avenues for growth – namely, the Chinese market. “Chips are now strategic assets, sitting at the intersection of national security, industrial policy, and economic sovereignty,” de Vigan said.
With much at stake in this still-young industry, geopolitics has the power to reshape AI, especially in semiconductors and AI infrastructure, said Cawse. “We are seeing a new kind of race: not just for economic dominance, but for technology, data, algorithms, and talent.” In an aim to restrict China’s military from accessing advanced US technology, president Donald Trump, like Joe Biden before him, has sought to limit China’s access to the technology by blocking exports of key microchips. Huang called these export controls “a failure,” as they cause more harm for US businesses than China.
Losing access to the world’s second-largest economy, essentially abandoning a $50bn market, would cause Nvidia to take a huge hit, Huang has said. Speaking at the Milken Institute annual meeting, he said it risks letting Huawei step in to take Nvidia’s place, allowing it to become a significant competitor and cutting American technology – currently the world standard – out of a huge market.
De Vigan agreed that the block on exports puts Nvidia in a tough position. “I think the challenge will be continuing to lead globally while navigating increasing pressure to localise or decouple,” he said. Beyond this, the sector could see more fragmentation as regions of the world, such as the US, China and Europe, create their own regulatory and computing backbone.
As Cawse sees it, there are positives to be found even in the challenging outlook. “The China–West dynamic is pushing investment and competition, which isn’t necessarily a
While challenges remain, Nvidia is nearly untouchable thanks to its novel position of market dominance. “Today, Nvidia finds itself at the very heart of the AI revolution,” said Leaman. “The world’s biggest tech players –Microsoft, Amazon, Google, and Meta – are not just customers; they are partners, relying on Nvidia’s GPUs to drive everything from cloud computing to the next breakthroughs in generative AI.
“Nvidia isn’t competing with companies like OpenAI or Google to build AI apps or chatbots,” Leaman continued. “It plays a different role. You could think of Nvidia as the engine under the hood as its chips are what power the AI models these companies create.” With AI finally delivering in real, measurable ways, Nvidia now has countless pathways to further growth. “It doesn’t matter if it is a chatbot, an image generator, or an autonomous car. Behind the scenes, chances are Nvidia is providing the hardware – and increasingly, the software – that makes it all possible.
“And it is not only tech giants in Silicon Valley using it,” Leaman said. “Hospitals are using Nvidia’s AI for medical imaging. Car companies are using it to develop self-driving vehicles. Industries far beyond tech are now part of what Nvidia calls multibillion-dollar AI markets in areas like automotive and healthcare.”
Huang, as the architect of this success, is now tasked with continuing to steer the company on an upward trajectory. Based on the amount of money big tech firms have pledged for investing in computing infrastructure in the coming years, analysts at the Bank of America calculated that Nvidia’s data centre networking solutions stand to benefit significantly, with the stock expected to rise to a whopping $190 per share. Elsewhere, however, questions are rising over Nvidia’s nearmonopoly of the sector.
Yet, Huang’s unique position of power in the AI space gives him the authority not only to negotiate with geopolitical forces but also to look into his crystal ball to see where the sector is headed next – and have a hand in steering it there, too. One day in the coming years, Nvidia’s many fans and loyal employees may begin to worry over the company’s lack of succession planning, but for now, they are all in on Huang. n






Stephen Roach



Amid seismic shifts in trade policy, supply chains, and political interference in central banking, the world may be headed for a sustained downturn that rivals the turbulence of the 1970s as protectionism rises and global economic uncertainty deepens
Nearly five years ago, I warned that stagflation was only a broken supply chain away. A temporary outbreak did indeed occur in the immediate aftermath of the Covid-19 shock, as a surge in inflation coincided with an anemic recovery in global demand. But, like the pandemic, that economic disruption quickly subsided. Today, a more worrisome form of stagflation is in the offing, threatening severe and lasting consequences for the global economy and world financial markets.
An important difference between these two strains of stagflation is the nature of the damage. During the pandemic, supply chains were stressed by significant demand shifts – during early lockdowns, people consumed more goods and fewer services, with a sharp reversal taking place after reopening. This led to soaring commodity prices, semiconductor shortages, and global shipping bottlenecks, which collectively accounted for about 60 percent of the surge in US inflation in 2021–22. It took roughly two years for those supplychain disruptions to begin to fade, allowing inflationary pressures to ease.
Such temporary disruptions now seem almost quaint compared to the fundamental reordering of global supply chains sparked by US President Donald Trump’s ‘America First’ protectionism. The US, for all intents and purposes, is disengaging, or decoupling, from global trade networks, especially from China-centric supply chains in Asia and potentially even from the supply chains that knit together North America through the US-Mexico-Canada Agreement, the so-called ‘gold standard’ of trade agreements.
These actions will reverse the supplychain efficiencies that academic research suggests have reduced the US inflation rate by at least 0.5 percentage points per year over the past decade. This reversal, driven by
“The US, for all intents and purposes, is disengaging, or decoupling, from global trade networks”
America’s newfound disdain for its former trading partners, will likely be permanent. Whereas the Covid-19 turmoil had a clear end point, distrust of the US will persist long after Trump has left the scene. This time, there will be no quick or easy fi x.
The reshoring of production to the US will not be seamless. Trump points to foreign and domestic firms’ outsize investment announcements as signs of a phoenix-like rebirth of US manufacturing. Yet production platforms cannot be snapped apart and reassembled like Lego. Under the best of circumstances, these projects take years to plan and construct before gradually coming online.
But in today’s climate of extraordinary policy uncertainty, with tit-for-tat retaliatory tariffs and sanctions dangerously dependent on Trump’s whims, reshoring investments are likely to be deferred, if not cancelled altogether. Nor will it be easy for the rest of the world to pick up the pieces after America’s retreat from globalisation, and develop new supply chains.

Just as it will take time for the US to rebuild domestic capacity, other countries’ efforts to restructure trade arrangements will be drawn out over a long period. To the extent that global value chains reflect the efficiencies of comparative advantage, this reconfiguration of production, assembly, and distribution platforms threatens to add new inefficiencies that will raise costs and prices worldwide.
There is an even more insidious ingredient in this stagflation cocktail: the politicisation of central banking. Here, again, the US is leading the way. Trump insists that he has the right to weigh in on the Federal Reserve’s policy actions, and has loudly and repeatedly conveyed his displeasure with the Federal Open Market Committee’s recent decisions to keep policy rates on hold.
The risk is that Trump will go even further in attacking the Fed’s independence. The president recently proclaimed that he could force out Fed Chair Jerome Powell, noting that his “termination can’t come fast enough.” While Trump has since backtracked from that threat, such a move would be consistent with
his broader – and seemingly unconstitutional – push to expand executive authority. As part of this power grab, he has already taken aim at other independent agencies, illegally firing leaders of the National Labor Relations Board, the Equal Employment Opportunity Commission, and the Federal Trade Commission for political purposes. Who is to say the oft-volatile Trump won’t backtrack again and renew his attacks on Powell?
At a minimum, Trump is ramping up political pressure on US monetary policy precisely when inflationary pressures are mounting in the face of new supply-chain disruptions. Add to the mix Trump’s well-known preference for a weaker US dollar, and the current circumstances bear a striking resemblance to those of the late 1970s, when a weak dollar and a weak Fed compounded America’s first outbreak of stagflation. Remember the clueless G. William Miller, who was Fed chair at the time? That is a painful part of my own experience as a Fed staffer that I would rather forget.
The other side of the stagflationary coin is the increasing risk of US and global recession. Again, this goes back to the growing possibility of a pervasive, long-lasting uncertainty shock bearing down on the US and global economies, and the associated paralysis of business and consumer decision-making. Trump celebrated the imposition of so-called ‘reciprocal’ tariffs on April 2 as ‘Liberation Day.’ To me, it was more like an act of sabotage, triggering retaliation and a likely decline in the global trade cycle. If this continues, it will be exceedingly difficult for the world to sidestep recession.
The outcome of Trump’s agenda could be as destructive as that of the early-20thcentury global trade war that followed the 1930 Smoot-Hawley Tariff Act, another protectionist policy blunder. With US tariffs now even higher than they were back then (and, in fact, higher than at any point since 1909), it is worth remembering the 65 percent contraction in global trade that occurred from 1929 to 1934. Today’s world might be lucky to get away with stagflation. n









Anastassia Fedyk ASSISTANT PROFESSOR OF FINANCE AT THE UNIVERSITY OF CALIFORNIA, BERKELEY
With war on Europe’s doorstep and the transatlantic alliance under strain, the EU’s bold €800bn rearmament plan marks a pivotal shift in defence strategy
The European Commission recently unveiled a plan for rearming the European Union and strengthening the bloc’s defence capabilities. By 2030, the Commission intends to arm Ukraine and develop member states’ militaries to the extent needed to deter or counter Russian aggression. To fund this effort, the Commission plans to borrow €800bn over the next four years.
It is encouraging that Europe has fi nally woken up to the Russian threat and developed a credible medium-term defence strategy, especially as the transatlantic rift widens. But the bloc may not have as much time to prepare as it would like. Fortunately, there are ways to accelerate the plan’s implementation.
Perhaps the most important question concerns funding. Around one-quarter of the €800bn that the Commission wants to mobilise can be obtained immediately by exchanging frozen Russian assets (90 percent of which are in cash) for EU bonds. Given the reluctance of some member states to seize Russian state assets, exchanging them for, say, 20-year, zero-interest bonds could be a politi-
cally palatable compromise. More generally, there is little to suggest that the seizure or exchange of these assets would materially affect the euro or the rule of law in Europe. In fact, it may even increase the likelihood of ultimately collecting compensation from Russia for the damages caused by its aggression.
Second, while information and soft-power threats may be less tangible than the cyber threats that the Commission’s plan rightly emphasises, they are just as dangerous and must be addressed. A prime example is the rising popularity of far-right and far-left populist forces supported by Russian and Chinese influence operations on TikTok and other social-media platforms. These political parties often promote the Kremlin’s agenda, including ending support for Ukraine.
The consequences of such forces coming to power could be devastating. Aside from aligning with Russia, their inclination to implement simplistic solutions to complex problems would create uncertainty and chaos,
undermining the EU’s governing institutions and its internal cohesion. This institutional weakness and fractured unity would only spur Russian aggression.
Freedom of speech should not apply to disinformation peddlers. The EU must therefore ban Russian and Russia-related media, including seemingly independent outlets, and more closely monitor the use of TikTok, Telegram and other social-media platforms for potential dissemination of pro-Kremlin propaganda. European politicians with ties to Russian President Vladimir Putin, like those who lobbied for the Nord Stream II project, should also face repercussions, so that the domestic costs outweigh the benefits conferred by these connections.
Similarly, the governance mechanisms of Europe’s rearmament effort should be ‘Orbánproof’ to prevent a single Kremlin-aligned European country – such as Hungary under Prime Minister Viktor Orbán – from derailing the project. Creating a ‘coalition of the willing’ would also allow Canada, Japan, South Korea and other countries to join the effort.

To be sure, Russian influence campaigns are not the only or even the main reason why populist far-right parties have gained traction in Europe. To erode support for these parties, European leaders must address the genuine problems that have fuelled their rise. For example, European leaders can weaken antiimmigrant sentiment by reforming migrantsupport programmes in ways that encourage employment, such as by coupling integration services (including language training) with the gradual phase-out of social benefits.
The bloc can also counter populism by improving outcomes for European workers and economies. The very act of rearming will create new jobs, while soft-power efforts could also benefit European industry. The ‘Grain from Ukraine’ humanitarian programme, which supplies Ukrainian products to countries in Africa and Asia facing food shortages, could easily be expanded to include European foodstuffs (which the EU can finance through its Common Agricultural Policy).
Lastly, the EU should use options other than hard force to mitigate the strategic
threat posed by Russia. For example, EU leaders could discreetly assure the leaders of nations currently occupied by Russia of the bloc’s recognition of them as independent states. This has worked before: Polish leaders privately told Leonid Kravchuk, who subsequently became Ukraine’s first president, that Poland would recognise an independent Ukrainian state.
The Kremlin’s paper tiger Russia may seem like a powerful monolith, but in reality it is a paper tiger with a crumbling economy. Regional elites will soon realise that they no longer have to tolerate the Kremlin’s racism, economic exploitation and expansionism. In fact, many free countries (including Poland and Finland) emerged from the disintegration of the Russian Empire in 1917, after its defeat in World War I, and from the collapse of the Soviet Union in 1991, after its withdrawal from Afghanistan two years earlier. Extending the life of an imperial entity that is seemingly permanently at war makes little sense.
“Russia may seem like
a powerful monolith, but in reality it is a paper tiger”
The EU must take these steps alongside its rearmament efforts – regardless of any negotiations or ceasefire agreements. Russia has shown that it can talk for years, as it did between 2015–22, to no effect, and Putin will use any ceasefire to prepare for another attack, while also intensifying Russia’s hybrid warfare, including information operations and sabotage. Putin’s imperial ambitions will not be derailed by talking, and any hope of ‘striking a deal’ with Russia will only help him reach these goals. If Europe wants to live freely, it must act fast. n

Antara Haldar ASSOCIATE PROFESSOR OF EMPIRICAL LEGAL STUDIES
Pope Francis was a quiet revolutionary in economic thought. Challenging market orthodoxy with a deeply humanist vision, he called for a moral reawakening in economics, where solidarity, justice and care for creation take precedence over profit and growth
Pope Francis redefined the papacy in profound ways. As the leader of the Catholic Church, he worked to make it more inclusive of women and the LGBTQ+ community. As the first Latin American pontiff, he became a voice for the Global South. And by taking his name – and inspiration – from St. Francis of Assisi, he positioned himself as a champion of the poor and marginalised.
One of the most surprising – and oftenoverlooked – aspects of Francis’s 12-year papacy was his emergence as an incisive economic visionary. In a world where economics is dominated by models, markets and metrics, Francis insisted on a different standard: a moral one.
Throughout his papacy, Francis consistently challenged the assumptions of today’s prevailing economic orthodoxy. In his 2013 exhortation Evangelii Gaudium (‘The Joy of the Gospel ’), he issued a stinging rebuke of what he called “an economy of exclusion and inequality” – a system that, as he put it, “kills.”
Unlike many critics of capitalism, however, Francis did not call for its outright rejection.
He adopted a more pragmatic approach, urging economic thinkers to ask deeper, more fundamental questions: What sort of markets do we want? Who should govern them, and to what end? His was a call to rethink not just our economic policies, but also the priorities that shape them.
In his 2015 encyclical Laudato Si’ (‘Praise Be to You’ ), Francis went further, integrating ecological and economic critiques into a unified moral vision. Climate degradation, he argued, is not merely a “negative externality” to be managed; it is the inevitable outcome of an economy that commodifies nature and marginalises the poor. Viewed through this lens, economics and ecology are not separate academic fields but intertwined arenas of moral responsibility. “The earth herself,” he wrote, “is among the most abandoned and maltreated of our poor.”
At the 2020 Economy of Francesco summit, Francis brought together young economists and entrepreneurs to imagine a new economy rooted in solidarity, justice and ecological stewardship. His message was une-
quivocal: it is no longer enough to patch up the old system – a moral re-founding is needed.
Francis’s views stood in stark contrast to the neoclassical assumptions that have long dominated economic policymaking. Neoclassical economics treats individuals as isolated utility maximisers, markets as largely selfcorrecting and growth as an unalloyed good. Poverty, inequality and environmental damage are seen, if at all, as technical problems at the margins of an otherwise efficient system.
Francis recognised a more profound threat: economics had ceased to be a tool for advancing human prosperity and had become an ideology that corrodes solidarity and encourages indifference. In theological terms, what he diagnosed was not mere inefficiency or imbalance but sin: structural sin, embedded in the systems we take for granted.
Francis’ critique is striking precisely because it comes from outside the technocratic priesthood of academic economics. While he did not propose marginal tax rates or carbon-

pricing mechanisms, he was returning economics to its foundations in moral philosophy and placing himself within a humanist tradition deeply rooted in the history of economic thought.
That tradition is exemplified by Nobel laureate economists such as Joseph Stiglitz, who has exposed how information asymmetries distort market ‘efficiency,’ and Amartya Sen, who has argued that development should focus on expanding human capabilities rather than GDP. It also includes Dani Rodrik, who has advocated re-embedding markets within democratic governance, and Thomas Piketty, who has laid bare the structural dynamics of wealth concentration.
Even Adam Smith, widely regarded as the father of free markets, would have found echoes of his thinking in Francis’ project. In his 1759 book The Theory of Moral Sentiments, Smith warned that economic life must be grounded in sympathy, justice, and norms of civic trust. The quest for a moral economy also animates the work of scholars like economist Samuel Bowles, who argues that well-de -
signed incentives and institutions can encourage pro-social behaviour. But where Bowles sees economics as a behavioural system to be redesigned, Francis viewed it as a moral system in need of redemption.
Unlike neoclassical economists, Francis was not merely concerned with fostering social cooperation; he was concerned with the formation of souls. For him, the stakes were not the success of markets but the survival of dignity, solidarity and creation itself. This was not moralism for its own sake; it was a reminder that economic life always entails moral choices, whether we acknowledge them or not.
Every budget, tax policy, and trade regime reflects a set of values. Francis refused to let those values remain hidden. Some economists bristle at this intrusion, insisting that the strength of economics lies in its value neutrality and ability to provide a rational – rather than sentimental – basis for hard choices. But that stance itself reflects a choice to protect the status quo rather than question it.
Francis’ intervention revealed that the claim to neutrality is, in fact, a form of moral abdication. At a time when neoclassical models increasingly struggle to explain or contain the crises facing humanity – rampant inequality, climate breakdown, political instability, and the rise of populism – Francis’ message feels especially urgent. It speaks directly to the spiritual ailments at the heart of our failing economies.
While he did not present an alternative model in spreadsheets or regression tables (the kind of economic language that often alienates ordinary people), he offered something more intuitive: the capacity for moral imagination.
Most importantly, Francis was not an enemy of economics. He was its custodian, reminding its practitioners of their forgotten calling: to serve the common good. Economists would do well to heed his message. If a 2,000-year-old institution like the Catholic Church can change, so can an economic consensus that has prevailed for only a few decades. n



Barry Eichengreen PROFESSOR OF ECONOMICS AND POLITICAL SCIENCE AT THE UNIVERSITY OF CALIFORNIA, BERKELEY
As the US faces growing pressure to safeguard the dollar’s global role, historical parallels offer sobering lessons on the perils of monetary overreach, economic myopia and the fragility of financial power
In April 1925, 100 years ago, Winston Churchill, in his capacity as chancellor of the exchequer, took the fateful decision to return pound sterling to the gold standard at the pre-war rate of exchange. Churchill then, not unlike US Treasury Secretary Scott Bessent now, was torn between two objectives.
On one hand, he wanted to maintain sterling’s position as the key currency around which the international monetary system revolved, and preserve London’s status as the leading international financial centre. On the other hand, he, or at least influential voices around him, saw merit in a more competitive – read ‘devalued’ – exchange rate that might boost British manufacturing and exports.
Why Churchill chose the first course is uncertain. The weight of history – British economic preeminence under the gold standard prior to World War I – pointed to restoring the monetary status quo ante. The City of London, meaning the financial sector, lobbied for a return to the pre-war exchange rate against gold and the dollar. The most articulate opponent, John Maynard Keynes, had an off night
when given an opportunity to make his case to the chancellor. The effects were much as predicted. Sterling regained its position as a key international currency, and the City its position as a financial centre. Now, however, they had to contend with New York and the dollar, which had gained importance, owing to disruptions to Europe from the war and the establishment of the Federal Reserve System to backstop US financial markets.
Also as predicted, British exports stagnated. At current prices, they were lower in 1928–29 than in 1924–25, when the decision to stabilise the exchange rate was taken.
Jostling for position
Here, clearly, a strong pound and the high interest rates required to defend its exchange rate were unhelpful. But to attribute the British economy’s poor performance entirely to the exchange rate is to jump to conclusions.
For one thing, the export industries on which Britain traditionally relied – textiles, steel and shipbuilding – were now subject to intense competition from later industrialis-
ers with more modern facilities, including the US and Japan. The situation was not unlike the competition currently felt by US manufacturing from China and other emerging markets. Then as now, it is not clear that a weaker exchange rate would have made much difference, given the emergence of these rising powers. Nor did the tariffs the UK imposed in the 1930s revive its old industries.
Moreover, Britain had difficulty developing the new industries that constituted the technological frontier – electrical engineering, motor vehicles and household consumer durables – even after devaluing the pound in 1931. The US and other countries were quicker to adopt new technologies and production methods, such as the assembly line.
Union militancy discouraged investment. Workers with the relevant skills and work ethic were in short supply. Again, these are not unlike complaints heard today from the operators of TSMC’s new semiconductor fabrication facilities in Arizona or Samsung’s chipmaking plants in Texas. And, of course, it did not help that the 1930s were marked by

trade wars and a decade-long depression. Notwithstanding these problems, sterling’s position as an international currency survived the 1930s. In fact, the pound regained some of the ground as a reserve and payments currency that it lost to the dollar in the preceding decades. Whereas Britain was broadly successful in maintaining banking and financial stability, the US suffered three debilitating banking and financial crises.
The UK maintained stable trade relations with its Commonwealth and Empire under a system of imperial preference that negated the effects of otherwise restrictive tariffs. And it remained on good terms with trade partners and political allies beyond the Commonwealth and Empire, including in Scandinavia, the Middle East and the Baltics, where monetary authorities continued to peg their countries’ currencies to sterling.
“The lessons for those seeking to preserve the dollar’s status as a global currency are clear”
The lessons for those seeking to preserve the dollar’s status as a global currency are clear. Avoid financial instability, which in the current context means not allowing problems in the crypto sphere to spill over to the rest of the banking and financial system. Limit recourse to tariffs, since the dollar’s wide international use derives in substantial part from America’s trade relations with the rest of the world. And preserve the country’s geopolitical alliances, since it is America’s alliance partners who are most likely to see the US as a reliable steward of their foreign assets and hold its currency as a show of good faith.
The US, to all appearances, is going down the opposite path, risking financial stability, imposing tariffs willy-nilly, and antagonising its alliance partners. What was achieved over a long period could be demolished in the blink of an eye – or with the stroke of a president’s pen. Churchill was aware of the risks. As he put it, “To build may have to be the slow and laborious task of years. To destroy can be the thoughtless act of a single day.” n


The legendary investor has shaped the world of finance for more than half a century. But despite his imminent retirement, Warren Buffett’s investment philosophy will continue to have a lasting influence »
Words by: Rachel Richards
fter a career spanning more than eight decades, it turns out that Warren Buffett had one last trick up his sleeve. The veteran inves tor shocked his audience when he announced his retirement from Berkshire Hathaway at the company’s annual shareholder meeting in May, bringing an end to a 60-year spell at the helm of the trilliondollar conglomerate. This was news to the vast majority of the 40,000-strong crowd, including vice-chairman Greg Abel, who will succeed Buffett as CEO when he steps down at the end of the year.

At the age of 94, Buffett’s retirement should perhaps come as no surprise. But it is hard to imagine an investment landscape without the financier at the very forefront. For more than half a century, Buffett has been considered one of the world’s leading business voices, with his investment acumen earning him the nickname the ‘Oracle of Omaha.’ Under Buffett’s shrewd leadership, Berkshire Hathaway has been transformed from a failing textile manufacturer into a $1.1trn conglomerate, boasting dozens of businesses in insurance, rail transportation, retail and more. The firm also holds significant stakes in global brands such as Apple, Coca-Cola, Domino’s and American Express, making it one of the most influential companies in the world.
Significantly, Buffett built Berkshire Hathaway into an industry titan by following a simple approach to investing. Buffett’s preferred method – known as value investing – prioritises buying quality companies and holding them for the long term. Buffett adopted this approach early in his career, by searching for companies that were underperforming relative to their potential. It didn’t take long for this astute strategy to pay off, propelling Buffett and Berkshire to immense wealth and influence. In an age when investors are increasingly short-term in their thinking, there may still be much to be learnt from Buffett’s patient approach.
good about American capitalism and America itself,” said Jamie Dimon, the Chief Executive of JPMorgan Chase, after hearing of the investor’s retirement announcement. In many ways, Buffett has become synonymous with the American dream and a particular US brand of capitalism. Born in Omaha, Nebraska in 1930, Buffett has often spoken of his luck at winning “the ovarian lottery” by being born in the US and coming of age when America was enjoying a post-war economic boom. Growing up far from the frenzy of Wall Street, Buffett nevertheless developed an interest in business and investing from an early age.
everything that is good about American capitalism and America itself ”
At just seven years old, Buffett stumbled upon a book at the Omaha Public Library that would change the course of his life. After reading Frances Minaker’s One Thousand Ways to Make $1000, Buffett’s fascination with the world of finance started to grow. Inspired by the book’s practical advice on ways to make money, Buffett threw himself into several different business ventures, selling packs of chewing gum to his neighbours and collecting empty Coca-Cola bottles to trade for cash at local stores. By the age of 11, Buffet claims to have read every book at his local library on the subject of investing, arming himself with the right knowledge to make his very first stock purchase: $114.75 for three shares in natural gas company Cities Service.
“I had become a capitalist, and it felt good,” Buffett later reflected on his first foray into the stock market. While this first purchase did not propel Buffett to instant wealth, it taught the young investor many crucial lessons –most importantly, the value of patience and long-term thinking.
After graduating from high school, Buffett was eager to focus on his business ventures, but his parents encouraged him to attend university. This proved to be useful advice, as Buffett was ultimately able to study under
$1.1trn
Estimated value of Berkshire Hathaway $56bn
Donated to charitable causes by Buffett 300m
Shares in Apple held by Berkshire Hathaway 60
Years Buffett has spent at the helm of Berkshire Hathaway

to many as the ‘father of value investing,’ had a profound influence on Buffett as a young man, with his focus on minimising risk and recognising intrinsic value guiding many of Buffett’s decisions in the first decades of his storied career. In 1954, Buffett joined Graham’s own investment firm, moving his family to New York as he prepared for a new life working with his mentor. This was shortlived, however, as the following year, Graham told Buffett of his plans to retire. For a homesick Buffett, this news gave him the impetus he needed to return to Omaha and set up his own investment partnership, aged just 25.
“Although I had no idea, age 25 was a turning point,” Buffett later told Forbes magazine. “I was changing my life, setting up something that would turn into a fairly good-size partnership called Berkshire Hathaway. I wasn’t scared. I was doing something I liked, and I am still doing it.”
In the early 1960s, Buffett’s partnership began strategically buying shares in the struggling textile company Berkshire Hathaway. By 1965, Buffett’s aggressive investment strategy allowed him to take control of the firm and begin shifting Berkshire’s business strategy away from textile manufacturing and towards investments and acquisitions. The rest, as they say, is history.
Foundations for success
“Forget what you know about buying fair businesses at wonderful prices; instead, buy
wonderful businesses at fair prices,” Buffett famously advised in his 2015 shareholder letter, attributing this maxim to long-time friend and business partner, Charlie Munger. This simple approach to investing has transformed Berkshire Hathaway into a powerhouse holding company, with 189 operating businesses to its name. From its billion-dollar railroads to its bevy of fast-food companies, Berkshire’s investments have always been focused on quality brands and long-termism.
“In fact, when we own portions of outstanding businesses with outstanding managements, our favourite holding period is forever,” Buffett said in his 1988 letter to his shareholders. True to his word, Buffett remains loyal to the brands that he favours. He has never sold a share in Coca-Cola since first investing in the company in 1988 and is said to drink five cans of the fizzy beverage every day. Given that Berkshire Hathaway is set to receive $816m in dividends from the brand in 2025, this is a longstanding relationship that continues to pay off.
Buffett’s connection to Coca-Cola is emblematic of another of his investment principles – buying American. Throughout his investment career, Buffet has been a staunch supporter of US businesses, even in the most
“Buffett has been able to steer Berkshire Hathaway through a host of economic booms and busts”
turbulent economic circumstances. In 2008, with the global economy still reeling from the financial crash, Buffett wrote an op-ed for The New York Times, in which he encouraged readers to follow his lead and ‘buy American.’
“Bad news is an investor’s best friend,” he wrote. “It lets you buy a slice of America’s future at a marked-down price.” In the years since the financial crash, Buffett’s pro-American strategy hasn’t changed, with Berkshire Hathaway continuing to snap up shares in well-established US firms such as Domino’s Pizza and beverage company Constellation Brands. By focusing on quality brands with consistent cash flows, Buffett has been able to steer Berkshire Hathaway through a host of economic booms and busts, delivering market-beating returns for shareholders over the last six decades.
This patient, long-term approach has also allowed Buffett to avoid speculative bubbles, famously staying away from dot-com stocks in the late 1990s, which then crashed in the year 2000. Resisting the temptation of rapid buying and selling has served Buffett incredibly well, but that’s not to say his career has been entirely without missteps.
Even the very best investors can make mistakes – a fact that Buffett himself is willing to admit. Seeking to break the industry ‘taboo’ around getting things wrong, Buffett penned a candid letter to Berkshire shareholders earlier this year, detailing some of the missteps he has made while leading the company, and the

lessons he has learned. “Problems cannot be wished away,” he wrote. “They require action, however uncomfortable that may be.”
It may be this shift in mindset that saw Buffett reverse his longstanding position on tech investments. Having passed up early opportunities to invest in technology giants such as Amazon, Google and Microsoft, Buffett missed out on significant financial windfalls as these companies became household names. After watching the dot-com bubble burst, avoiding tech stocks may have seemed like a sensible precaution in the early 2000s, but Buffett’s hesitancy ended up costing him. Not one to take failure lying down, Buffett has been beefing up Berkshire Hathaway’s tech investments over the past decade. The conglomerate now owns 300 million shares in Apple – worth a staggering $60bn – and has been raising its stake in Amazon since first snapping up shares in the e-commerce giant in 2019.
While Buffett may have softened his stance when it comes to tech investments, many of the veteran investor’s core principles continue to shine through in his relationship with both Amazon and Apple. Both firms boast powerful brand names, and can be considered consumer companies, rather than strictly tech. In the fast-paced and everchanging tech world, Amazon and Apple have demonstrated durable success, enjoying customer loyalty and steady profits which don’t necessarily depend on constant innovation. For someone who values long-term stability, the two firms represent consistency and dependability in a sector defined by constant change. Despite some early missed opportuni-
“Buffett has continued to insist that the super-rich have a responsibility to give back to society”
ties in the tech world, Berkshire Hathaway’s $1.1trn valuation suggests that the financial impact of these mistakes is minimal. For Buffett, the more serious career challenges may well have been the threats to his reputation over the years. In 1991, Buffett’s leadership was tested when investment bank Salomon Brothers was embroiled in a bond trading scandal. As a major shareholder in the firm, Buffett was forced to bail out Salomon in order to protect his investment, even stepping up to act as the bank’s chairman until the crisis passed. In his 1991 testimony to Congress during the scandal, Buffett warned Salomon employees: “lose money for the firm and I will be understanding, lose a shred of reputation for the firm, and I will be ruthless.”
But this wasn’t Buffett’s last brush with Wall Street controversy. During the early, panicked days of the 2008 global financial crash, Berkshire Hathaway invested $5bn in Goldman Sachs, in an effort to help the bank bolster its balance sheet. While Buffett saw the investment as a necessary shot in the arm for the country’s financial sector, critics chided him for defending Goldman, which had been one of the largest players in the subprime mortgage market. Many accused the firm of profiting from an economic crisis that it helped to create, and Buffett’s association with the firm may have tarnished his reputa-
tion among an outraged public. For someone as acutely aware of their own position as Warren Buffett, the experience may have served to re-emphasise the importance of integrity and ethical conduct.
While Buffett’s influence over the investment landscape is undeniable, the legendary financier has also had a profound impact on the world outside of business, too. As one of the world’s leading philanthropists, Buffett has donated over $56bn to charitable causes over the course of his lifetime, with plans to give away 99.5 percent of his remaining wealth when he dies. Along with his own charitable donations, Buffett also seeks to inspire other super-rich individuals to join his philanthropic efforts.
In 2010, he co-founded the Giving Pledge with long-time friend Bill Gates – a campaign which encourages wealthy individuals to give at least half of their wealth to philanthropic causes during their lifetime or in their will. In the 15 years since its launch, the campaign has gathered 245 pledgers – a healthy number, but fewer than its founders may have hoped for. In fact, in recent years, support for the pledge appears to be waning, even as the number of billionaires continues to grow. The 2025 edition of the Forbes annual rich list features a record-breaking 3,028 billionaires – and the 245 Giving Pledge members account for just eight percent of this ultra-wealthy group.
As the world’s sixth-richest man, Buffett should be only too aware of the growing issue of income inequality. Billionaire wealth has surged since the 1990s, with poverty charity Oxfam predicting that at least five people will become trillionaires within the next decade. Meanwhile, the number of people living under the World Bank poverty line has barely changed over the same time period, accounting for 44 percent of the world’s population. Last year, the wealth of the world’s 10 richest men jumped by an average of almost $100m a day, making the gap between rich and poor grow ever wider.
Against this troubling backdrop, Buffett has continued to insist that the super-rich have a responsibility to give back to society. Alongside his philanthropic donations, Buffett has also campaigned for higher taxes on wealthy individuals, and an end to “unfair” tax breaks for the mega-rich. In a 2011 article penned for The New York Times, he argued that the Bush-era tax regime was overly generous to the wealthy, while those on lower incomes struggled to make ends meet.
“My friends and I have been coddled long enough by a billionaire-friendly Congress,” he wrote. “It is time for our government to get serious about shared sacrifice.”
Corporations, too, ought to pay their fair share, according to Buffett. Last year, Berkshire Hathaway paid the largest corporate tax bill in US history, putting $26.8bn into the treasury coffers. But, far from bemoaning this significant sum, Buffett hopes that his firm will send “even larger” tax payments in the future. In a typically candid annual letter to shareholders, Buffett urged the US government to spend this tax money sensibly and use it to support those who are less fortunate.
“Spend it wisely,” he advised. “Take care of the many, who, for no fault of their own, get the short straws in life. They deserve better.”
This message is very much at odds with the current fiscal thinking in the White House. Republicans in the House and Senate are working to make permanent the tax cuts that President Trump first introduced in 2017, which lowered the corporate tax rate from 35 percent to 21 percent. Despite costing the federal government an estimated $240bn in lost tax revenue between 2018 and 2021, the Trump administration is forging ahead with its plans to extend the controversial tax cuts.
The bill to enact this tax agenda is now heading to the Senate after passing in the House of Representatives by just one vote.
Trump’s 1,100-page “big beautiful bill” not only seeks to advance corporate and individual tax cuts, but also looks to tighten eligibility for health and food programmes for the disadvantaged, in a move that has been roundly criticised by Democrats. According to the nonpartisan Congressional Budget Office, the bill, if enacted, would reduce income for the poorest 10 percent of households and increase incomes for the top 10 percent. With working-class families set to bear the brunt of these contentious policies, Buffett’s vision of a fairer system seems to be moving further out of reach.
Trump’s second term has thus far seen a significant shift in economic policy. Upon his return to the White House, Trump announced a host of sweeping trade tariffs, which have disrupted global markets with unprecedented intensity. Long-time trade partners have scrambled to negotiate new deals with the US, and China has only recently stepped back from the brink of an all-out trade war with its western rival. The era of free trade may well be over, and market volatility is fast becoming the new normal.
These fraught economic conditions look very different to those of Buffett’s heyday. But, ironically, it is this current market volatility that may see Buffett’s investment principles come back into fashion. For some years now, short-termism has dominated the investment

SOURCE: Forbes
turns over potential long-term growth. The fast-growing tech sector has also attracted hordes of investors in recent years, with the so-called ‘Magnificent Seven’ tech stocks taking off astronomically at the end of 2022. By the end of 2024, stocks in these seven companies – Alphabet, Amazon, Apple, Meta Platforms, Microsoft, Nvidia and Tesla – accounted for around one-third of the S&P 500’s total market capitalisation, giving them immense influence over the markets and the wider global economy.
However, amid widespread trade tensions and growing global economic uncertainty, a more traditional approach to investing may be coming back in vogue. Buffett’s brand of value investing can prove popular in times of economic turbulence, as investors look towards more stable parts of the market. Resilient sectors such as utilities, healthcare
“Buffett has every intention of keeping a watchful eye on the markets – in 2025 and beyond”
tractive to investors who are looking to make lower-risk investments, or seeking to diversify their portfolio away from tech. In this rapidly evolving market landscape, there may still be a place for old-fashioned value investing, after all. Buffett’s retirement marks the end of an era for both Berkshire Hathaway and the investment sector as a whole. But as the financier prepares to step down from his role as CEO, his strategies will continue to influence new generations of investors.
Buffett’s focus on intrinsic value and playing the long game are, in many ways, timeless values, and can prove their worth in testing economic circumstances. But even as Buffett moves away from his full-time duties, we can still expect to hear more from the outspoken investor. In an interview with the Wall Street Journal, Buffett revealed that he plans to keep on contributing his investment ideas to the firm even once he retires. “I am not going to sit at home and watch soap operas,” he said. Retirement, for Buffett, doesn’t mean disengaging from his lifelong passions. As he looks towards his 95th birthday in August, Buffett has every intention of keeping a watchful eye on the markets – in 2025 and beyond. n
The old continent’s digital banks are setting their collective sights across the pond at the US market – but they must overcome considerable regulatory obstacles and cultural differences in order to thrive
WORDS BY Alex Katsomitros FEATURES WRITER





As one of Europe’s leading digital banks, Bunq hoped for quick approval when it applied for a US banking licence in 2023. One year later, the Amsterdam-based fintech firm withdrew its application due to a misalignment between US and Dutch regulators. The company is now making a second attempt, fi ling in April for a broker-dealer licence that will allow its US users to invest in stocks, mutual funds and ETFs. This is only the first step in an ambitious American adventure, says a Bunq spokesperson, adding that it will “start by making investing effortless and fully transparent, with no hidden fees,” possibly a jab at its US competitors and their practices. Bunq, which boasts 17 million European users, plans to reapply for a banking licence later this year.
Growth above all
Bunq is not the only European digital bank that is seeking expansion across the Atlantic. UK digital banking leaders Revolut and Monzo have also been eyeing the US market, riding a wave of renewed interest from investors following a post-pandemic funding crisis. The strategy is a no-brainer, given slower customer acquisition in Europe after a decade of manic growth and intensifying competition that compresses margins. A sense of urgency is also taking over the fintech market as it matures and fewer digital banks (also known as neobanks) are expected to become dominant globally. Some are in the black after years of losses; 2024 was Bunq’s second consecutive year of profitability.
One problem for neobanks is that they lag behind incumbents in the quintessential banking business: credit extension. Their lending operations are relatively small, meaning that revenue has to come from payment fees and premium accounts.
Regulation has also become stricter. “Europe has become increasingly hostile ground for fintechs, with tighter funding conditions and tougher regulations throttling growth,” says Carrie Osman, founder of Cruxy, a UK growth consultancy working with fintech firms. A wave of regulatory reform across the Atlantic, including the recent ‘1033 rule’ that has unlocked access to consumer financial data, has put the US on their radar, she adds. “The upside is that because they operate under more stringent regulations and thinner margins in Europe, they are better placed to innovate in transparency, cost efficiency and cross-border functionality,” argues Alessandro Hatami, former chief operating officer of digital banking at Lloyds Banking Group and author of Inclusive Finance: How Fintech and Innovation Can Transform Financial Inclusion
Despite these reforms, navigating the country’s Byzantine regulatory landscape remains an obstacle to conquering the $24trn US market. Obtaining a banking licence requires approval from state and federal regulators, while state-by-state money transmission licences are necessary to operate in several states. On top of a banking charter, aspiring lenders need to secure deposit insurance and proof of sufficient funds. Rising US protectionism adds an extra barrier, says Hatami: “Current instability in engagement with foreign providers is possibly making the rollout of a European fintech in the US problematic.”

Glaser, CEO of Dwolla, a US payment service provider, whereas opportunities exist for those who recognise that modernising their payment infrastructure involves adapting to America’s complex financial backbone.
Past attempts to crack the US market have proved traumatic. Monzo withdrew its banking licence application in 2021 when regulators warned that approval was unlikely. Berlin-based neobank N26 closed down its US operations in 2021, having failed to offer there its profit-making membership deals. Revolut’s delay in obtaining a UK banking licence made a US application practically impossible.
Dealing with US payment infrastructure can also be tricky. In Europe, neobanks benefit from interbank payment systems that enable customers to make transactions seamlessly, whereas US banks have been slower in adopting similar technologies. European entrants who view the US as a single market have struggled, says Dave
Without a banking licence, digital banks are unable to generate revenue through credit products. “Previous attempts faltered due to underestimating the complexity of US regulation, overestimating brand pull and launching without a compelling local value proposition,” says David Donovan, head of financial services North America at digital transformation consultancy Publicis Sapient.
For fintechs unable to obtain their own banking charter, partnering with a US bank is a no-brainer. Monzo has partnered with Sutton Bank to hold users’ deposits. Cleo AI, a UK fintech which offers personalised financial assistance through a chatbot, has partnered with Thread Bank and WebBank and boasts seven million customers in North America. The downside is that partners retain a share

of card transaction fees, a major revenue source since they are significantly higher in the US. “It eats into your margins; you have less autonomy around product decisions; and you are often tied to the maturity of the partner bank’s risk and compliance processes, which can feel very outdated,” argues Stephen Greer, banking industry consultant at analytics platform SAS, adding: “This means the entry point to the US market is building services on top of a simple demand deposit account, which is a very low-margin product and typically doesn’t outpace your cost to acquire new customers.”
The recent collapse of Evolve Bank, triggered by its partner Synapse’s mismanagement of customer funds, has also intensified regulatory scrutiny of such partnerships. More ambitious neobanks have decided that going it alone is a bet worth taking. Revolut offers its card through its partner Lead Bank, but also has a US broker licence and is now seeking its own banking licence.
“The best strategy for a European fintech is to create a US entity and nurture this by tapping into the US investor markets, from venture capital all the way to IPO. And to play down its European roots as far as possible,” says Hatami.
US retail banking is a competitive market, with over 3,000 institutions including regional banks, savings banks and credit unions, meaning that European fintechs must be prepared for slower growth and higher customer acquisition costs. US fintechs like Venmo, SoFi, Zelle and Chime have massive marketing budgets. “Word of mouth and referrals can only get you so far in the US,” says Dylan Lerner, a digital banking analyst at Javelin Strategy & Research, a US market intelligence provider. “You might have to spend some serious money to establish yourself – from heavy spending on advertising to naming rights on stadiums and sports sponsorships.”
The flipside is that new entrants can focus on niche markets that are large enough to be profitable. European neobanks can offer onestop banking solutions to customers hungry for digital-first experiences with fancy addons on top of savings accounts, such as investing tools and real-time spending analytics. “Many US fintechs are built on banking-asa-service models that limit control and innovation. European firms, having built more of their stack, can differentiate on both cost and customisation,” says Donovan. Remittances is one potential revenue stream, notably offering cross-border and multicurrency services to around 20 million US-based immigrants. A case in point is the success of Wise, a platform that “addresses international money movement with a clarity and fee structure that is still uncommon in the US,” Hatami says. Bunq is also targeting digital nomads, “especially the nearly five million European expats who struggle with banking bureaucracy while pursuing a location-independent lifestyle,” according to the firm’s spokesperson.
Cultural differences also come into play. American customers are more credit-focused than Europeans and are constantly offered customer rewards and loyalty deals, meaning that new entrants must provide expensive perks to lure them. Their loyalty to traditional banks is also rock-solid. “Americans are largely satisfied with their financial institutions. They are not eager to switch banking relationships,” says Lerner from Javelin Strategy & Research. A recent survey by the firm found that 77 percent of consumers were unlikely to switch away from their primary financial institution. Foreign neobanks focused on business-to-customers solutions face an uphill battle due to relatively high customer acquisition costs, argues Kevin Fox, chief revenue officer at Thredd, a UK payments processor that recently expanded into
the US and has helped several neobanks scale internationally. “Without a pivot to some differentiated credit product, prepaid and debit offerings often don’t generate enough revenue to warrant those costs,” Fox notes, adding that fintechs moving to a business-to-business model by providing solutions to SMEs, such as expense management services, have a better chance of US success.
Surprisingly enough, the biggest opportunity for European fintechs may be disrupting the technological backwardness of the US banking system. Perhaps the starkest example is the persistence of cheques, still widely used by banks and corporations, in a digital era. “What they [European neobanks] bring is primarily tech: fast onboarding, seamless user experience, a fully digital experience. That is not something the US banking system excels at yet,” says Arthur Azizov, founder of fintech alliance B2 Ventures.
For European fintechs, the biggest prize that comes along with US presence is the possibility of a public listing. US IPOs typically achieve higher valuations and provide access to the world’s biggest investment pool. Revolut and Monzo are expected to go public by the end of the decade, and their leadership has indicated preference for a US listing. Such decisions, however, have a political dimension that can cause friction at home. “Revolut was recently granted a banking licence – probably in part because of a promise to list in London, not in the US. Most companies want to list on Nasdaq or NYSE, raise a tonne of money and cash out. But governments want to keep their unicorns close to home,” says Azizov, adding: “For a serious US expansion, they will need to go all in: full teams, full infrastructure, full commitment. They may even need to move their HQ.” For sceptics though, going public might be a premature step without a clear US-orientated strategy and profitability model – the latter being the holy grail that will seal their position in the banking world.
“The real endgame is profitability at scale. This is something that has eluded most fintechs, regardless of listing venue,” says Donovan from Publicis Sapient. “It would prove that a digital-native, product-led model can work even in the world’s most competitive and entrenched banking market.” n
In Kazakhstan’s dynamic banking sector, ForteBank is setting a new standard for disciplined growth and digital innovation, driven by CEO Talgat Kuanyshev’s results-focused leadership and international ambitions
WORDS BY Malika Karajanova DIRECTOR, PUBLIC RELATIONS, FORTEBANK






In the fast-evolving financial landscape of Kazakhstan, ForteBank stands as a testament to pragmatic leadership and disciplined strategy. Under the stewardship of CEO Talgat Kuanyshev, ForteBank has entered a new chapter defined by universal growth, operational excellence and international ambition. With over three decades of experience, including senior roles at ATF Bank, KassaNova Bank and ForteBank, Kuanyshev brings a clear, results-orientated approach to the institution; one that prioritises delivering tangible value in every decision.
Today, ForteBank ranks among Kazakhstan’s leading financial institutions, holding a confident market position as the fourth-largest bank in the country by assets, loans and deposits. It maintains a seven percent market share in assets and deposits and six percent in loans among privately owned banks. Its balanced portfolio spans retail, SME and corporate segments almost equally, protecting the bank from market fluctuations and ensuring resilient, sustainable expansion. This diversification has become a hallmark of ForteBank’s strategic direction.
A major milestone in the bank’s international presence was achieved in February 2025 when ForteBank became the first privately owned Kazakhstani bank in over a decade to issue Eurobonds. The $400m placement attracted more than $1bn in orders from investors across Europe, the Middle East and the Gulf, affirming the bank’s growing reputation on the global stage. These funds are being directed to finance strategic projects across
industries such as transport, construction, logistics and gold production – further amplifying ForteBank’s impact on Kazakhstan’s real economy.
Digital transformation has been a cornerstone of ForteBank’s strategy. With more than 85 percent of services now offered through digital channels, and its in-house developed ForteApp boasting over 950,000 monthly active users, the bank is redefining convenience for retail and corporate clients alike. In the SME sector, ForteBusiness offers full digital onboarding for legal entities, a pioneering achievement in Kazakhstan. This digital-first approach significantly reduces onboarding time, strengthens risk controls, and allows customers across the country – including remote regions – to access high-quality banking services.

its. The bank’s capital adequacy ratio stood at 23.9 percent, well above the regulatory minimum, reflecting strong capitalisation and prudent risk appetite.
The bank’s retail operations are organised around three value propositions: ‘Forte’ for general retail customers, ‘Solo’ for affluent clients and ‘Premier’ for high-net-worth individuals. Meanwhile, the SME and corporate divisions are expanding rapidly, supported by an integrated branch network of 21 regional branches and nearly 100 service points. ForteBank’s physical infrastructure remains a critical asset, complementing its digital presence by acting as consultative centres for more complex client needs.
Financially, ForteBank’s discipline is evident: return on average equity stood at 33.1 percent by the end of 2024, while the cost-to-income ratio fell to an efficient 28.8 percent. The bank’s non-performing loans ratio declined to 3.6 percent, and total assets grew by 25.8 percent year-on-year to KZT 4.1trn ($8bn),
One standout feature of ForteBank’s performance has been the growth in net interest income, which reached KZT 262.7bn ($510m) by year-end 2024, supported by a steadily increasing net interest margin of 7.5 percent. While maintaining this growth, the bank continues to hold a highly liquid balance sheet with 50.4 percent of total assets in liquid form, providing resilience amid external shocks.
ForteBank’s risk management framework has evolved into a strategic strength. The cost of risk decreased to 2.4 percent in 2024, while impaired loans as a share of gross loans dropped to five percent, down from 6.6 percent the year before. The bank has taken a disciplined approach to portfolio diversification and maintains a conservative exposure to high-risk sectors. Additionally, it keeps related-party lending below one percent of its total loan book, signaling a transparent and institutionally robust credit process.

Yet ForteBank’s ambitions extend beyond fi nancial metrics. Its environmental, social and governance (ESG) agenda embeds sustainable principles into the core of the business. Among recent initiatives are the construction of a secondary school for 900 pupils, sponsorship of Kazakhstan’s national paralympic tennis team, environmental programmes including waste reduction and tree planting campaigns, and efforts to enhance financial literacy among vulnerable groups.
From an environmental standpoint, ForteBank has developed a green procurement policy and measures greenhouse gas emissions (Scope one and two) for both operations and pilot loan portfolios. Over 115 tons of wastepaper was collected for recycling in 2024, and the bank is transitioning to energyand water-efficient technologies across its offices. On the social side, employee well-being programmes include voluntary health insurance, financial support for family events, and extended leave entitlements based on tenure.
ForteBank is also one of the few banks in Kazakhstan with a formal accessibility programme for customers with disabilities, including accessible branch infrastructure, a web version optimised for users with hearing or visual impairments, and ongoing front-
Worth of orders in Eurobonds for ForteBank in 2025
THE BANK’S APPROACH TO HUMAN CAPITAL IS BOTH STRUCTURED AND PROGRESSIVE
line staff training. In 2024, ForteBank also became a participant in the financial regulator’s initiative to improve access to banking services for individuals with limited mobility, solidifying its commitment to financial inclusion.
The bank’s leadership philosophy, shaped at the board level by Chairman Timur Issatayev, is grounded in clarity and pragmatism. ForteBank evaluates every initiative against a simple but rigorous standard: if a project cannot demonstrate at least three tangible benefits – whether financial, operational, or reputational – it is reconsidered or redesigned. This disciplined approach to decision-making ensures a clear focus on outcomes over optics.
Internally, ForteBank’s culture reflects its leadership values, with strong employee engagement supported by initiatives such as preferential mortgage support and seasonal transportation programmes that foster a cohesive and motivated workforce. More than 3,850 employees work across the country, many of whom have been with the bank through multiple stages of its evolution.
The bank’s approach to human capital is both structured and progressive. Employee training and development remain a key fo -
cus area, with mandatory compliance programmes and role-specific upskilling rolled out bank-wide. Leadership talent is actively cultivated, with internal mobility and succession planning serving as central pillars of ForteBank’s long-term workforce strategy.
ForteBank’s contribution to Kazakhstan’s economy is significant not only in numbers but also in its ability to support broader development goals. Its loan portfolio – KZT 1.82trn ($3.5bn) as of January 2025 – is well diversified by sector, including manufacturing, infrastructure, retail and services. Meanwhile, its deposit base of KZT 2.87trn ($5.6bn) reflects high levels of public trust and a strong reputation for safety and reliability. Top-10 borrowers represent only 25.6 percent of the total loan portfolio, underscoring a healthy distribution of credit exposure.
As Kazakhstan continues its trajectory of diversified economic growth and cautious fiscal management, ForteBank is poised to maintain and strengthen its market position. The bank’s strategic priorities include increasing the loan-to-assets ratio from 42 percent to align with the market average of 57 percent, optimising the balance sheet structure, enhancing digital onboarding across segments, and growing the share of online lending.
It is also investing in AI-driven models for credit scoring and fraud detection, further improving decision-making and client protection. Performance metrics such as net promoter score (NPS) are now monitored across products and channels, serving as additional feedback loops in the bank’s client-centric operating model.
While many institutions in emerging markets are still navigating structural reforms, ForteBank has already adopted a platformbased IT landscape, enabling faster development cycles and scalability. A new mobile app tailored for business clients has been launched, while core processes across customer service, compliance, and underwriting are being automated to improve both speed and accuracy.
In an era where financial institutions must balance innovation with responsibility, ForteBank provides a model for success: leadership that values simplicity and results, a strategy rooted in universal growth, and a vision firmly anchored in the future. Empowering people, championing businesses and shaping the future – ForteBank embodies these commitments, both at home and abroad. n
Bulgaria’s banking sector enters 2025 with strong foundations, demonstrating resilience through digital innovation, capital stability and strategic focus as the country prepares for eurozone integration and sustained economic growth



WORDS BY
Petia Dimitrova CEO, POSTBANK & CHAIRPERSON AT THE ASSOCIATION OF BANKS IN BULGARIA




In 2024 the Bulgarian banking sector demonstrated stable growth, despite the economic challenges related to inflation and international uncertainty. The banking system continued to develop sustainably, preserving its capital stability and maintaining high levels of liquidity. This resilience was the result of effective risk management, strategic investments in digitalisation and innovation, as well as the ability of banks to adapt to the dynamically changing economic environment. Despite rising costs, the banking sector managed to maintain its stability thanks to well-structured management decisions and optimised resource allocation.
Regulatory mechanisms imposed in recent years ensured high levels of capital adequacy, which contributed to confidence in the sector. Digitalisation remained a top priority, with banks making significant investments in new technologies, improving access and efficiency of the services offered. Customer service also underwent transformation, driven by automation and the introduction of modern remote banking platforms, which facilitated financial transactions for businesses and households.
Bulgaria also went through a complex political situation in 2024. The parliamentary elections, as well as international geopolitical events, led to some postponement of the investment intentions of entrepreneurs. Thus, growth of corporate lending slowed down to about 10 percent on an annual basis, while the retail segments continued to steam ahead –mortgage lending maintained strong dynamics with an annual growth of over 25 percent, while consumer loans grew by 17 percent. It is important to note that this was not on behalf of risk – the levels of non-performing loans are at historically low levels, decreasing significantly on an annual basis.
Since the beginning of 2025, Bulgaria has become a full member of the Schengen Area, which has opened new opportunities for business and improved conditions for trade and investment. This factor is expected to have a positive impact on economic growth in the coming years.
At the same time, the effect of the European Central Bank’s interest rate cut will begin to be reflected in the banking system, as ECB will continue its gradual reduction of key interest rates in 2025. It is expected that by mid-year the key interest rate will be reduced to two percent, which will have an impact on banks’ interest income and will lead to better lending conditions.
In 2025, efforts will be intensified to increase financial and digital literacy so that all economic participants can effectively adapt to the new conditions. In addition, banks will continue to invest in innovation and technology to ensure a smooth and effective transition to the euro and to offer even more flexible and accessible services to their customers.
As one of the leaders in the financial sector setting trends and shaping the direction of development, Postbank is an active participant in the processes affecting Bulgarian society. We offer modern solutions, high-tech innovations, and innovative products and services that ensure speed, security, and excellent

The main focus this year will be the successful transition to the eurozone. The adoption of the euro is a strategic moment for the country and will support Bulgaria’s economic integration, strengthening its competitiveness on international markets. It is expected that the new currency will contribute to the enhancement of international trade and will provide Bulgarian companies with easier access to capital markets. The reduction of currency risk will encourage the inflow of capital and the financial system will become even more transparent and predictable.
The banking sector will continue to play a key role as a stable partner to businesses and households, providing support during the transition to the euro.
“Our mission is to make banking more accessible, faster and more secure”
quality for a seamless banking experience. Our mission is to make banking more accessible, faster and more secure.
We continue to successfully implement our digital strategy, and we believe that Postbank will soon be transformed into a technology company that provides customers with full control over their finances through intelligent, personalised services.
In conclusion, the banking sector in Bulgaria entered 2025 on a solid foundation, ready for new challenges and a clear focus on the country’s successful integration into the euro area. Despite the dynamics of macroeconomic processes, banks remain stable and continue to be a reliable partner for businesses and citizens. n

Sri Lanka’s economic recovery gained momentum in 2024, with political stability and policy consistency driving growth. Sampath Bank played a key role, aligning its strategy to support national resurgence and innovation
WORDS BY


Ajantha de Vas Gunasekara EXECUTIVE DIRECTOR/CFO, SAMPATH BANK

Sri Lanka is a comeback story that economists are closely monitoring as it still has some way to go, despite the significant progress made in the aftermath of the financial crisis that unfolded in 2022. Recording its first quarter of growth in the third quarter of 2023 after six consecutive quarters of negative growth, the country maintained its growth momentum in 2024 to record five percent growth, albeit from a low base. The country held Presidential and Parliamentary elections in 2024 with a smooth transition of power during the year. The stability achieved through consistently applied policies is commendable as the country achieved stability in the trifecta, inflation, interest rates and exchange rates of abnormally high levels in 2022 and 2023. Exports, tourism and worker remittances increased foreign currency inflows supporting stability and growth. The restructuring of the international sovereign bonds and the release of the third tranche of the Extended Fund Facility from the International Monetary Fund strengthened the economy. The country’s gross official reserves stand at 3.9 months by the close of 2024 and the country’s default rating was revised upwards, giving rise to a pervasive sense of renewed optimism among the people.
From its inception in 1986, Sampath Bank has transformed the banking industry in Sri Lanka using technology and innovative products to achieve financial inclusion, a term not yet coined at the time. From being the first bank in Sri Lanka to operate a multi-point network of Automated Teller Machines (ATM) in 1988 or the first to issue debit cards in South Asia in 1997, Sampath Bank has continuously sought to democratise convenient banking, seeking
higher penetration levels with affordable and convenient banking. Accordingly, Sampath Bank aligned its priorities to support the recovery and growth of the economy. Supporting the revival of businesses was a key area of focus, and the Business Revival Unit was set up to provide financial advice and management tools to move beyond cashflow constraints to thrive in a reviving economy. Over 74 businesses that were revived, stabilised and moved out of the bank’s stage two and stage three portfolios are testimony to the effectiveness of this new unit. These businesses are now stable with improved management and practical repayment schedules with sufficient headroom for growth.
The loan book of the bank increased by 10 percent during the year compared to a decline of 4.7 percent in the previous year, as the bank supported growth in active sectors of the economy such as tourism, information and communication technology and healthcare.
The bank retained its leadership position in worker remittances and increased market share, assisting a growing migrant population to support their families in Sri Lanka by reimagining the offering with relevant benefits and extending our reach. Growth in digital transaction volumes and values continue to nurture our legacy of leveraging relevant technology to integrate Sri Lankans with a digital era and the benefits of access to opportunity and financial services.
A new strategy was crafted in 2024 to position the bank along a new growth trajectory to be the best in whatever we do. It builds on the bank’s legacy of meeting the needs of the future through enhanced stakeholder value propositions. The strategy focuses on five pillars: corporate, SME, transaction banking, high-net-worth families, and advanced analytics. This strategy enables the bank to extend SME value chains, thereby enhancing our value proposition for the SMEs, entrepreneurs and farmers by building resilient eco-

cess to markets and finance. The bank has a sound launching pad for this strategy with leadership in cards, loyal customer base, customer insights, a motivated team and solid financials, facilitating the development of unique and purposeful offerings for target customer segments. Advanced analytics and use of AI tools will support efficiency and growth as we harness the advancements in technology to level up the bank’s operating model.
Sampath Bank made the highest investment in its history in digital technologies in 2024 and is on the next phase of transitioning the people to the new norm. Teams are being coached to unlearn, relearn and improve, in order to drive both their own and the bank’s performance. This was underpinned with the highest training spend in the history of the bank. This approach aims to drive growth, improve customer loyalty, and position the bank for future success while strengthening its leadership in key business verticals.
Sampath Bank delivered strong PAT growth recording an EPS of Rs23.30 in 2024 compared to Rs14.62 reported in 2023 as delivery on strategy was buoyed by a recovering economy. Net interest income growth and a significant decrease in provisions for impairment contributed to profit growth. Profit after tax amounted to Rs27.3bn ($93m), an increase of 59.4 percent, reflecting the value created for investors.

percent as the balance sheet expanded to Rs1,778bn ($6.1bn), reflecting a focused growth strategy. Loans and advances recorded growth of 10 percent to Rs964.6bn ($3.3bn) as business confidence increased with economic stability. Investment portfolios increased by 28.7 percent to Rs801bn ($2.7bn), reflecting the cautious approach to growth in 2024 as well as our capacity for future growth.
Strong deposit growth of 16.2 percent to Rs1,469bn ($5bn) funded growth as increased customer centricity strengthened brand leadership. The Current Account and Savings Account (CASA) growth was also encouraging at 18.3 percent, easing pressure on NII margins as interest rates declined. Importantly, the bank’s Tier 1 capital adequacy ratio improved marginally, remaining well above industry standards while also recording significant improvement in asset quality indicators.

Sampath Bank continues to enhance the sustainability of the business model while also investing in the future of the planet and its people through targeted sustainability initiatives. The Environmental and Social Management System is now an institutionalised process that assesses the environment and social impact of loan facilities above Rs100m. Financial inclusion is supported through multiple initiatives as well as our subsidiary, Siyapatha Finance. Additionally, implementing SLFRS sustainability standards in 2025 will ensure that controls over sustainability reporting are as rigorous as those over financial reporting.
The bank minimised scope one and two emissions by increasing our own solar generation capacity, which generated 664.6Mwh in 2024. Additionally, lending Rs1,440m ($4.9m) in renewable energy projects with a total installed capacity of 10Mw helped minimise scope three emissions. Initiatives to minimise and manage waste continue to transform how we work while enhancing awareness of the need for action by all throughout the bank.
The bank’s sustainability initiatives have been strategic in nature, nurturing environmental and social ecosystems that support each other to thrive. ‘Wewata Jeewayak,’ the bank’s flagship project, is now in its 24th year having undertaken a total of 30 reservoirs that are vital for the country’s food production, supporting the livelihoods of over 3,700 families in farming communities. This milestone was marked with the restoration of nine tanks in 2024, the highest undertaken in a single year. The project helps to irrigate 3,400 acres
of paddy fields, enabling farmers to work two seasons instead of one. These reservoirs store and distribute rainwater to fields and homes, while also rejuvenating the flora and fauna. Project partners enhance the scope, extending it to financial inclusion, entrepreneurship development, and good agricultural practices, to name just a few aspects of this increasingly multifaceted project that delivers benefits at grassroots. ‘A breath to the ocean’ looks at restoration of mangroves, coral replanting and turtle conservation to support life below water. ‘Gasai Mamai Pubudu Pothai’ (The Tree, Me and My Savings Book) inculcates awareness of the importance of nurturing trees in the next generation. Environment restoration projects undertaken by the bank include the Kanneliya and Udawalawe forest restoration projects as well as the Mangrove Restoration Project in Anawilundawa Ramsar Wetland, reflecting our commitment to the environment.
We continue to invest in our people, supporting their career progression through focused training while also implementing initiatives to support their health and well-being, including their mental wellbeing. Over 16 programmes were implemented for health and well-being covering over 23 percent of employees. The renewed focus on training resulted in an average of 45 hours of training per employee and 98.5 percent coverage of employees. We promoted 458 employees during the year to meet the business needs of a bank in a growth phase. The bank’s retention rate of 96.8 percent and the return-to-work rates after maternity leave stand testimony to our holistic employee value proposition.
Sri Lanka had a strong start for 2025 with a convergence of positive factors. Political stability, an improved sovereign rating, growth in trade, tourism and remittances together with improved business confidence augur well for the country’s ability to reach the forecasted GDP growth of approximately five percent in 2025. The banking sector is expected to be a catalyst and a beneficiary of the improved prospects for the country.
The multi-pronged strategy for growth described above will guide our quest to be the best bank in the country. We remain confident about realising our aspirations as we build on solid foundations with a motivated team. n
The global economy has weathered recent shocks, but mounting debt – now far above pre-pandemic levels – is pushing many developing countries toward crisis. Without urgent reforms, high borrowing costs and weak growth could trigger lasting setbacks
WORDS BY H
Indermit Gill CHIEF ECONOMIST, WORLD BANK








Despite a succession of shocks since 2020, the global economy has held up remarkably well – so far. But the margin for error is dwindling. Total global debt is now nearly 25 percent higher than it was on the eve of the Covid-19 pandemic, when it already was at an all-time high. This overhang could undercut all economies’ ability to shield themselves against the latest shock: higher trade tariffs.
Although debt is crucial for driving economic growth, it should be understood as a form of deferred taxation. By borrowing rather than taxing, governments can make long-term investments that will benefit future taxpayers without burdening the current generation; or they can prop up national growth and incomes during an economic emergency, when hiking taxes would only deepen the downturn. Eventually, however, the piper must be paid, and if national income does not grow faster than the cost of borrowing, taxes must be raised to repay the debt. Persistently high debt thus becomes a barrier to economic progress. That barrier has seldom been higher. Over the last 15 years, developing countries got hooked on debt, which they amassed at a record-setting clip: six percentage points of GDP per year, on average. Such rapid debt buildups often end in tears. Indeed, the odds that they will trigger a financial crisis are roughly 50-50.
Moreover, this particular surge has been punctuated by the fastest increase in interest rates in four decades. Borrowing costs doubled for half of all developing economies, with net interest costs as a share of govern-


an all-out mobilisation of private capital to boost growth and development over the next five years. But foreign private capital is unlikely to flow into highly indebted economies with weak growth prospects. Private inves-
growth will magically return. Policies that impede trade and investment – like tariffs and non-tariff barriers – should be rolled back as soon and as much as possible. For many developing economies, cutting tariffs equally with
respect to all trading partners could be the fastest way to restore growth. Developing economies also have much to gain by fostering a more investmentfriendly regulatory environment. And those gains can be used to shift the national focus back to development, particularly by ratcheting up investments in health, education, and
As the saying goes, when you are in a hole, it is wise to stop digging. An era of extraordinarily low interest rates encouraged too many countries to spend far beyond their means. A string of catastrophes – both natural and man-made – made it impossible for them to do anything else in the last five years. But prudence is now essential. Governments should revert to previous norms on what constitutes excessive sovereign debt. Call it the 40-60 maximum: 40 percent of GDP for low-income economies, 60 percent for high-income economies, with everyone else in between. n

In a challenging global climate, Crédit Mutuel has delivered robust results for 2024, driven by strong fundamentals, mutualist values, and a clear focus on long-term resilience and sustainability
WITH Isabelle Ferrand
CHIEF EXECUTIVE OFFICER, CONFÉDÉRATION NATIONALE DU CRÉDIT MUTUEL
What is the Crédit Mutuel group doing to address the environmental challenge?


In a year of ongoing economic uncertainty and global challenges, Crédit Mutuel has emerged with strong fi nancial results and a clear strategic direction, which is a testament to the strength of its diversified banking and insurance model. With a focus on long-term value creation, operational efficiency, and a mutualist ethos, Crédit Mutuel continues to distinguish itself.
In this interview, Crédit Mutuel reflects on the drivers of its 2024 performance, its priorities for 2025, and its growing role in supporting the energy transition and addressing climate risks. The conversation also reinforces the group’s deep commitment to its founding values of solidarity, responsibility, and service to the common good.
What is your analysis of Crédit Mutuel’s performance in 2024?
Crédit Mutuel group, France’s third-largest banking group, is demonstrating the strength of its diversified banking and insurance model with net income of more than €4.5bn in 2024. Crédit Mutuel group’s excellent operating efficiency continued to drive its net revenue, which reached €19.3bn, confi rming the vigour of its business growth. Net income, up 50 percent over the last 10 years, bears witness to the relevance of Crédit Mutuel group’s business model. Founded on the principles
of freedom, responsibility, solidarity and subsidiarity, it enables us to make long-term strategic choices and ensure long-term profitability to meet the needs of our members and customers. The mutualist group continues to demonstrate that diversification, innovation and commitment to the common good, notably through value sharing, are key factors for navigating this period of political and economic turbulence with resilience. Backed by the commitment of its 87,000 employees and nearly 20,000 elected representatives, serving its 37.8 million retail, professional and corporate customers and members in France and Europe, Crédit Mutuel group once again demonstrated its efficiency, with a cost/ income ratio that improved significantly by 1.5 points to 57.7 percent. Crédit Mutuel group’s financial solidity was fully confirmed with a CET1 ratio of 19.4 percent.
What are the drivers of this financial performance?
This result is based on three key pillars: strong commercial momentum, leading financial strength, and continued improvements in operational efficiency. We remain the leader in France in this area, with the best cost-toincome ratio.
What are the group’s current priorities? We will work to strengthen our resilience and to advocate for the cooperative and mutual banking model at both European and international levels. We firmly believe that the cooperative model is a true asset in today’s world, and the values it embodies resonate strongly with the aspirations of younger generations.
In view of the issues of global warming, loss of biodiversity and damage caused by exposure to climate hazards, Crédit Mutuel group stepped up its eco-responsible initiatives and offerings to support its customers in their ecological and energy transition projects. In addition to strong strategic ambitions, in 2024 Crédit Mutuel group continued to integrate climate and environmental risks into its overall risk management and developed a methodology for assessing its customers’ geographic exposure to climate hazards. This methodology is an invaluable tool for assessing environmental and climate risks by sector, as well as providing a framework for internal stress testing of climate risks. Through these commitments, Crédit Mutuel group is committed to reducing its negative impacts, in particular on climate and the environment, for the benefit of all its stakeholders, and in particular its members and customers. Driven by a shared determination, all the group’s networks are taking increased steps to help transform our economy in environmental terms and create a trajectory in line with the Paris Agreement.
What would be the ideal for a bank like Crédit Mutuel?
It would be – and in fact, it is – to remain deeply mutualist, useful, and supportive, in the service of clients, members, and society as a whole. Mutualism remains our founding principle and at the heart of our movement. Our goal is to be both supportive and efficient – to become ever more efficient in order to be even more supportive. n

After much uncertainty and volatility over the last 12 months, the Nigerian economy has demonstrated remarkable resilience and potential for growth, buoyed by a strong financial services sector
WORDS BY Dr. Adaora Umeoji GROUP MANAGING DIRECTOR/ CEO, ZENITH BANK








There is good reason why Nigeria is known as ‘the giant of Africa.’ Boasting vast land, rich resources and a vibrant economy, the West African nation has established itself as a rising global power. Despite its size and resilience, however, Nigeria is certainly not immune from economic shocks. 2024 was a challenging year on many fronts. The global economy was rocked by trade tensions and geopolitical uncertainty, while tight monetary conditions constrained developed markets. Internally, Nigeria also had to contend with persistent inflationary pressures, currency volatility, high interest rates and the socio-economic consequences of bold governmental reforms. Yet, amid these challenges, resilience has emerged as a defining theme for the Nigerian economy.
In fact, Nigeria’s economy grew by 3.4 percent in 2024, marking the country’s fastest rate of economic growth in a decade, excluding the 2021–22 Covid-19 rebound. While inflation remains stubbornly high, this recent acceleration in economic activities may give some hope that the nation may now be on a path towards sustainable growth.
At Zenith Bank, we understand that challenges often create the impetus for innovation and positive change. Just as the nation’s economy has demonstrated adaptability and strength in the face of significant macroeconomic headwinds, Zenith Bank is proud to see opportunity where others see challenge. In this fast-paced economic environment, we do not merely react to the shifting landscape –we anticipate, adapt and act with agility. This proactive approach helps Zenith Bank to stay at the forefront of emerging trends, and to best serve our customers as their needs and
requirements change. In a year when many financial institutions have been grappling with rising costs and constrained liquidity, Zenith Bank has shown unmatched financial discipline, robust asset quality and investor confidence, and has met and exceeded the ₦500bn ($315m) recapitalisation target set by the Central Bank of Nigeria (CBN). By accelerating our digital transformation, sharpening our strategic priorities and enhancing the customer experience, we are proud to be driving positive change in Nigeria’s ever-evolving financial landscape.
One of the most profound changes of the last few years has been the rapid development and uptake of Artificial Intelligence (AI) technologies. Indeed, 2024 was a landmark year for AI, marked by new breakthroughs and widespread adoption across industries. AI is already reshaping the financial services sector, with banks using the technology to enhance customer services, prevent fraud and better manage risk. According to the McKinsey Global Institute, generative AI could add between $200bn and $340bn to the global banking sector each year, largely through increased productivity. Given the efficiency gains that AI can enable, it is no surprise that financial institutions are racing to implement this new technology – but this is an important transformation that banks need to take care to get right.
At Zenith Bank, we are committed to delivering innovative, customer-centric solutions that meet the evolving needs of our customers in the digital age. With this in mind, we have successfully integrated AI into our Customer Relationship Management (CRM) system to enhance response times and improve customer service delivery. We have also embedded AI capabilities into our anti-fraud system, which is strengthening the protection of our customers’ funds and enhancing fraud detection.
RESILIENCE
To deepen customer engagement, Zenith Bank is also deploying advanced tools that track customer journeys across different digital touchpoints, helping to refine the design and delivery of hyper-personalised solutions. The bank also has its own AI-powered chatbot, named ZIVA (Zenith Bank Intelligent Virtual Assistant), which can offer banking services on WhatsApp and other social media platforms. This allows customers to access services in a way that best suits their needs, making bill payments, fund transfers and account management simpler and more accessible than ever before.

One of Zenith Bank’s most significant milestones in 2024 was the successful completion of its digital transformation journey. This transformation was not merely about technology upgrades – it represented a holistic revamp of the bank’s customer engagement channels, internal processes and operational backbone. By leveraging AI, data analytics and cloud-based platforms, we enhanced the speed, reliability and personalisation of our services.
These new and improved capabilities help us to provide seamless, hyper-personalised banking experiences for all of our customers, and place us at the very forefront of digital banking in Nigeria and across our African markets.

Nigeria boasts a thriving entrepreneurial culture, with small-to-medium businesses contributing 48 percent of the national GDP. SMEs are the growth engine behind Nigeria’s developing economy, employing over 80 percent of the country’s total workforce and keeping day-to-day business activity moving. However, despite the size of the SME sector, small-business owners continue to face a myriad of challenges, including regulatory hurdles, high operating costs and limited access to finance.
At Zenith Bank, we understand the challenges faced by SMEs, and are passionate about empowering small businesses to thrive, especially in testing times. In 2021, the bank launched a trailblazing new product, called SME Grow My Business (SME-GMB). Specifically designed for small businesses, SMEGMB is an innovative platform that offers a range of benefits, including access to free digital tools and services that can help business owners and entrepreneurs to take the next step in their business journey. Outside of the SME-GMB platform, Zenith Bank offers a range of digital products – such as online payment gateway GlobalPay and e-commerce solution ZiVA Stores – which can help SMEs to carry out transactions quickly, efficiently and on the go.
Beyond access to finance, one of the most significant issues facing small businesses is the need to increase visibility in what is becoming an increasingly competitive and demand-driven market. To help our business customers combat this issue, Zenith Bank has partnered with Google to offer Google Business Profile (GBP), which creates a free business profile for users, allowing them to easily connect with potential new customers across Google Search and Maps.
The platform allows businesses to effortlessly share information, receive reviews, provide location directions and contact details, enhancing their visibility and accessibility for new and existing customers. It also provides subscribers with a range of enhanced data and analytics, giving SME owners useful insights into how their businesses are performing.
Along with its efforts to support the nation’s flourishing network of SMEs, Zenith Bank is equally committed to driving financial inclusion in Nigeria. Despite significant progress over the past decade, access to financial services remains a pressing challenge, particularly for women and those living in rural communities. According to Women’s World Banking, only 47 percent of Nigerian women accessed formal financial services in 2023, compared to 58 percent of men, highlighting a clear gender gap when it comes to financial inclusion.
Zenith Bank recognises the critical role that financial inclusion plays in driving economic growth, reducing poverty and improving living standards. With this in mind, we have launched a range of products and services specifically designed to cater to the unbanked and underbanked population, with a view to driving further financial inclusion across Nigeria.
THE FINANCIAL SERVICES SECTOR HAS A SIGNIFICANT ROLE TO PLAY IN IMPROVING INCLUSIVITY
What’s more, GBP subscribers can also enjoy access to regular training sessions on adopting and optimising digital marketing strategies. By equipping SMEs with both the knowledge and tools that they need to thrive, Zenith Bank is playing its part in helping to create a healthy business ecosystem in Nigeria.
Our agency banking programme, ZMONEY, was launched to cater to the financially excluded population, and supports wider government efforts to reduce levels of poverty in Nigeria through financial education and inclusion. The programme brings banking services closer to customers in harder-to-reach communities, through a network of agents who can deliver basic financial services such as account opening, cash deposits, withdrawals, bill payments and more. Since launching five years ago, the agency programme is now in operation across 774 local government areas, with over 120,000 individual agents bringing vital banking services to Nigerians living in traditionally underserved and excluded areas. Through partnering with third parties, our agents are able to operate out of a range of accessible locations, including convenience stores and petrol stations. Over five million accounts have been opened through our agents since the launch of the programme, and they have enabled over 165 million transactions. For those without access to a physical bank branch, our agency business offers a practical way to access a range of vital financial services.
New technologies are another useful tool in breaking down barriers to financial inclusion. Zenith Bank has recently introduced its
digital wallet, eaZybyZenith, which caters to those who have traditionally been excluded from accessing financial services. Designed with accessibility in mind, the wallet offers a seamless onboarding process, and a range of convenient remote banking services. With eaZybyZenith, customers can use their mobile phones to make deposits and withdrawals, transfer funds and pay bills, and even request physical or virtual payment cards. The app is designed to be simple and easy to use, ideal for day-to-day transactions. By reducing barriers to entry for new customers and previously unbanked individuals, eaZybyZenith is helping to unlock financial freedom and drive financial inclusion in more isolated communities.
At Zenith Bank, we are also acutely aware of the financial inclusion gender gap in Nigeria, and are committed to improving access to banking services for women. We understand that female entrepreneurs still face significant barriers, and the financial services sector has a significant role to play in improving inclusivity and supporting women-led businesses. Zenith Bank is committed to female empowerment, and seeks to provide women with better opportunities to manage their finances, build assets and secure their economic future. In 2019, the bank launched Z-Woman, a unique loan product exclusively for women-led businesses. Available only to businesses where a woman is the major shareholder, Z-Woman offers competitive interest rates for businesses across all sectors. We are proud to offer this product, which demonstrates our ongoing commitment to female empowerment and supporting women entrepreneurs.
Making a difference
In today’s world, customers are increasingly looking to make financial choices that align with their own values and principles. According to research commissioned by CRIF, over half of US and European consumers want their banks and insurers to offer greener products and services, and a significant portion would switch providers if they discovered that their existing provider was not aligned with their values. This growing consumer interest in ethical, value-led businesses cannot be ignored by the financial services sector – an industry which has a significant role to play in supporting the transition to a more inclusive, sustainable world.
At Zenith Bank, we recognise that ethical conduct and responsible banking are fundamental to building trust and long-term relationships with our customers, stakeholders, and the communities we serve. In line with
this, we have strategically embedded sustainability and social values at the heart of our business philosophy, and are committed to boosting prosperity across Nigeria.
This community-centred approach is reflected in the bank’s investments in social projects across the country, including investments in educational initiatives, health outreach programmes and vocational training, reaching thousands of beneficiaries every year. The bank has also renovated and upgraded the Iga Idunganran Primary Healthcare Centre on Lagos Island, which provides crucial care to the community. The upgrade introduced modern amenities and state-ofthe-art medical equipment, as well as expanding capacity at the centre in order to cater to the growing healthcare needs of Lagos Island citizens. With the addition of new, specialised dental, eye and ENT clinics and tuberculosis screening centres, the centre is now better equipped to meet the needs of the community.
Along with our investments in communities, at Zenith Bank we are also conscious of our environmental impact. Our financing strategy has increasingly focused on green and environmentally responsible investments, as we have made sustainability a core tenet of our company. We support clean energy, sustainable agriculture, waste recycling and climate-smart infrastructure, and are always looking for ways to implement these principles. Our restoration of the Iga Idunganran Primary Healthcare Centre included the installation of a 34 Kilowatt-capacity solar energy supply, to assist the hospital in reducing its diesel usage. By promoting the use of sustainable energy in our external investments, Zenith Bank is leading by example when it comes to CSR practices.

WE CONTINUALLY INVEST IN TALENT DEVELOPMENT,
For businesses of all sizes, principles need to come from within. Internally, our values are at the heart of what we do, and environmental and social principles guide our day-to-day operations at Zenith Bank. We understand that long-term success must go beyond profitability to include positive outcomes for the communities we serve and the environment around us. In line with these values, we have committed ourselves to the United Nations Sustainable Development Goals (SDGs), and fully comply with internationally established standards and guidelines
Operationally, we have taken concrete steps to reduce our carbon footprint. We are expanding the deployment of solar-powered branches and ATMs, optimising energy use, and incorporating resource-efficient technologies across our facilities. These efforts have not only reduced our carbon emissions, but have also positioned Zenith Bank as a key player in Nigeria’s low-carbon transition.
As well as being conscious of our environmental impact, at Zenith Bank, the wellbeing of our employees is another core priority. We continually invest in talent development, diversity and employee wellbeing, recognising that a motivated, inclusive workforce is essential to our success. Staff from all departments are trained on environmental, social and governance (ESG) principles and sustainable finance, while our inclusive policies ensure gender balance and equitable opportunity across our business. Our robust whistleblower framework fosters accountability, while regular ethics training reinforces an expectation of integrity within the organisation. From fair and open recruitment practices, to structured
THE

banking. This comprehensive approach ensures that Zenith Bank is not only a financial services provider, but a values-driven organisation that leads by example when it comes to ethical banking and sustainability. Across every level of our organisation, we are proud to have an empowered workforce that is capable of championing sustainability in everything that they do.
Zenith Bank’s core principles and clear strategic focus have set solid foundations for success. But these are turbulent times for the global economy, and many financial institutions are feeling exposed to a vast array of risks. Across the globe, banks are having to contend with a challenging set of macroeconomic conditions, with geopolitical tensions creating a highly unpredictable business environment. Nigeria also faces a myriad of challenges on the home front, with high inflation, currency volatility and supply chain disruption all putting pressure on the nation’s economy. In this volatile and unpredictable
In the face of this heightened economic uncertainty, Zenith Bank has introduced a proactive and localised risk management approach, tailored to its unique business model and strategy. To navigate the challenges posed by high volatility, inflation, oil price dependency and regulatory shifts, the bank has implemented a combination of carefully considered strategies. These include a high-yield asset focus, effective liability cost management, active asset and liability management, and data-driven decision-making. Our risk management strategies are fully compliant with regulatory requirements, and incorporate the ESG principles that are at the heart of our business. By optimising assets and income while controlling liability costs, the bank has been able to maintain substantial net interest margins and profitability, demonstrating Zenith Bank’s resilience in the face of economic challenges.
To stay ahead of the curve, the bank continuously monitors geopolitical and economic developments, and proactively adapts its strategies depending on emerging data
and trends. Zenith Bank has incorporated a number of digital innovations into its risk management approach, allowing it to improve efficiency and ensure value for money, ultimately giving the bank a competitive advantage when it comes to mitigating emerging risks. By employing these proactive risk management strategies, the bank is well-equipped to navigate Nigeria’s economic and regulatory landscape, ensuring strong oversight of its core risk areas and compliance with global standards.
Despite the challenges posed by the current macroeconomic environment, the future looks bright for Zenith Bank. The firm has established itself as one of Nigeria’s most profitable banks, and has made banking more accessible and convenient for customers across its home market. Beyond these borders, the bank is emerging as a leading financial institution across West Africa, with a growing presence in Ghana, Sierra Leone and the Gambia. Further expansion is already underway, and is not only limited to the African market. The bank already boasts a presence in the UK, France and the UAE, and has a representation office in China. These foreign subsidiaries contribute an impressive 18 percent of the bank’s total gross revenue, and scaling these subsidiaries is a key area of focus over the medium term. In fact, with ₦140.4bn ($88.5m) specifically earmarked for global market expansion, Zenith Bank is set to pursue a bold plan for international growth over the coming years.
The bank’s current expansion strategy focuses primarily on Francophone Africa, with a two-pronged approach targeting the West African Economic Monetary Union (WAEMU) and Central African Economic and Monetary Community (CEMAC) regions. In the WAEMU region, Zenith Bank plans to start with Cote d’Ivoire, leveraging its significant economy, before expanding to Senegal and other high-growth markets. Similarly, in the CEMAC region, the bank will use Cameroon as a gateway, utilising the unique single licence approach to enter other countries in the region.
With the opening of Zenith Bank Paris in November 2024, the bank has already taken a significant step towards realising its global expansion plans. Over the next few years, Zenith Bank aims to establish a significant presence across major cities on the continent and beyond, solidifying its position as a leading financial institution in West Africa and a major player in the global banking industry. n

AI is rapidly reshaping finance, but regulation is struggling to keep up. As rules lag behind, leading banks are embedding responsible AI principles early – turning governance into a strategic advantage
AI risk compliance, policy, ethics and more. This means oversight is needed too. Already, 18 of the 50 banks tracked publicly in our AI Index have formed a cross-functional AI Risk or Governance Committee. The rapid growth in RAI hiring in the UK means that ‘Head of Responsible AI’ positions are more common there, though it is likely we will see more of these roles appearing elsewhere alongside broader AI growth.
Despite regional differences, the message is clear: Responsible AI cannot be retrofitted. The leading banks are applying RAI principles not only at the end of the line in model validation or compliance review, but earlier on in problem definition and data selection too. This full lifecycle approach is noticeable in high-impact areas such as credit scoring, lending, and fraud detection, where trust is particularly essential.
WORDS BY Alexandra Mousavizadeh CO-FOUNDER & CEO, EVIDENT INSIGHTS






AI has transformed the financial services industry at speed. From fraud detection and customer onboarding to trading powered by AI insights, it is already reshaping infrastructure and competitive dynamics. According to the Bank of International Settlements, 70 percent of global banks are already deploying or piloting AI in core business functions.
But global AI regulation remains fragmented. The US still lacks comprehensive federal laws and the EU AI Act is redrawing the compliance landscape. For the financial services industry, navigating this picture is a strategic challenge. Many banks are choosing not to wait, moving faster than lawmakers. Evident’s ‘Responsible AI in Banking’ report found that 41 of the world’s 50 largest banks now have dedicated RAI risk and ethics specialists.
The real story isn’t banks surging ahead of regulators though – it is that they have recognised the need to do so. AI is both a potential competitive advantage that cannot be ignored and a different type of risk – one that extends beyond traditional model governance into the systems, structures, and culture that support its use. In a high-stakes environment where trust, compliance, and competitiveness are
converging, the most advanced banks are redefi ning what good governance looks like in anticipation of regulation, rather than waiting and reacting. A consensus is emerging: the core principles of RAI must include accountability for outcomes, explainable AI development, and a clear alignment with company ethics and standards. But this is not a checklist; it is becoming a set of strategic imperatives for banks.
Nowhere is this shift clearer than in hiring. RAI-related recruitment has surged 41 percent year-on-year, even in an otherwise cautious hiring environment. That isn’t just a data point, it is a signal of priorities. Where the talent goes, strategy follows. The number of RAI roles is growing across territories, but the drivers vary. While anticipation of new AI regulations and standards is universal, exposure to EU regulatory pressure may be an accelerator for European and UK banks, which have seen fastest growth in talent.
North American banks are still signalling that they are taking RAI seriously. Four of the top five banks publishing research papers on RAI-related topics like control mapping and explainable AI are headquartered in the US or Canada, with JPMorgan Chase leading the way. Hiring is not limited to technical teams. Banks are recruiting across
Having strong guardrails in place doesn’t need to be a brake – it can be a catalyst to innovation. With governance in place, banks can move quickly on high-potential use cases – like accelerating document processing, improving customer service, and enhancing fraud detection – without fear of backtracking later. First hand experience from leaders quoted in our recent RAI report shows that embedding risk management and ethics into a company’s culture as part of the early development lifecycle is crucial to avoid the loss of invested cost – not to mention to avoid potential damage to customer trust. The smarter approach is to build resilient systems now.
First movers are also in a better position to shape future regulation, not just follow it. These banks can bring real-world insight into consultations as lawmakers define what best practice looks like. For the customer, RAI ensures fairer, more transparent decisionmaking. Younger consumers in particular are embracing AI-powered tools to help support their financial wellbeing, but their expectations are high. Good governance is needed to make sure models are explainable and that bias is mitigated.
Banks know they can’t afford to wait. Being ahead of regulation isn’t about avoiding oversight, it is about setting a higher standard. Embedding responsible practices early will allow banks to innovate, protect customers, and stay ahead of future compliance challenges. Responsible AI is no longer a final checkpoint. It is fast becoming the foundation for how banks operate, compete, and create lasting trust. Those leading the charge aren’t just ready for the future, they are helping to build it. n






Macao
Macao is accelerating its economic diversification by positioning modern finance –especially its fast-growing bond market – as a strategic pillar, transforming from isolated initiatives into a robust, internationally connected financial ecosystem
WORDS BY Niu Jianjun CEO, INDUSTRIAL AND COMMERCIAL BANK OF CHINA (MACAU)



To address challenges of its unbalanced industrial structure, Macao has highlighted the importance of economic diversification, and prioritised modern finance, especially the bond market, as a cornerstone of its strategic transformation. Recent years have witnessed the birth, expansion and maturation of Macao’s bond market, and its progress from isolated breakthroughs to systemic advancement. With fruitful results, the construction of the bond market has enriched Macao’s financial ecosystem, and laid a solid foundation for economic diversification in the future.
Strategic expansion: high-speed growth
In 2020, the Macao SAR government first introduced the concept of ‘modern fi nance’ in its policy address. Later, in 2022, the ‘one plus four’ appropriate economic diversification strategy was formalised (‘one’ refers to the diversified development of the integrated tourism and leisure industry, and ‘four’ refers to four major industries: health, modern financial services, high technology and finally the convention, exhibition, trade, culture and sports industry.
Today, the financial sector has grown to become the second-largest industry in Macao, with an ecosystem led by banking and insurance, together with bonds, funds and other financial business.
The development of Macao’s bond market dates back to 2018, and in 2021 the Central Securities Depository (CSD) system was implemented. In recent years, the Macao SAR gov-
ernment has undertaken efforts to enhance bond issuance mechanisms, financial infrastructure, supporting laws and regulations, and the collaboration with Chinese Mainland, Hong Kong and other regions.
Nowadays, notable issuers include the Ministry of Finance of China, People’s Government of Guangdong Province, and mainstream financial institutions and enterprises. Bonds in Macao are issued in different currencies, namely in Chinese Yuan, US dollars, Hong Kong dollars and Macau Patacas. By 2024, the total value of publicly offered and listed bonds in Macao reached $100bn.
As a mainstream local commercial bank and the Chair Institution of the Securities and Funds Industry Association of Macao, ICBC (Macau) plays a pivotal role in the development of Macao’s bond market. The bank serves in multiple capacities including issuer, institutional investor, underwriter, clearing bank, agency bank and trustee administrator, providing comprehensive services that span the entire bond market value chain.
For the past few years, the bank has witnessed important moments of Macao’s bond market, and spearheaded significant transactions. It has executed over $1bn of bond issuance across four consecutive years, making it the most active and diversified bond issuer with the largest scale of issuance among its local peers. It has also pioneered innovative products in offshore bonds, such as ‘Kung Fu Bonds,’ ‘Dim Sum Bonds,’ ‘Lotus Bonds,’ ‘Pearl Bonds’ and ‘Yulan Bonds,’ creating a multi-market and multi-product underwriting portfolio. Leveraging its advantage of a full bank license, ICBC (Macau) makes extensive investment in various bond markets.
Macao’s ascendancy in modern finance is underpinned by its unique geopolitical, institutional and policy advantages.
$100bn
Value of publicly offered and listed bonds in Macao

As a strategic gateway between Chinese Mainland, Portuguese-speaking countries, and the Belt and Road Initiative (BRI) markets, Macao leverages its unique status as a free port, independent tariff zone, and integral part of the Guangdong-Hong Kong-Macao Greater Bay Area (GBA). In the context of China’s expanded opening-up policy, this strategic location amplifies Macao’s prominent advantage as a regional hub.
Macao and its surrounding area boast a sound financial ecosystem and business-friendly climate, characterised by internationally recognised confidentiality standards, with abundant fiscal reserve and social wealth, competitive tax rates (lower than major global financial centres), and an open finan-

cial system. Its financial regulatory authority has consistently maintained an open and pragmatic regulatory stance, and supported financial innovation. By the end of 2024, international assets accounted for 83.4 percent of total assets of the banking sector in Macao.
The Guangdong-Hong Kong-Macao Greater Bay Area is now a $1.8trn economy, which provides fertile ground for Macao’s financial development. As one of the four centre cities within the Greater Bay Area, Macao stands to gain from the diverse financial service demands and vast market of the area, which propels the growth of its modern financial sector.
Meanwhile, the deep integration between Macao and Hengqin has formed a distinctive mechanism and provided strong support for Macao’s modern financial advance-
ment, through effectively combining Macao’s strength of internal and external connectivity and resource coordination with Hengqin’s capacity for real economy support, financial development and adequate infrastructure. As of the end of 2024, the asset management scale of fund companies in the Guangdong-Macao In-Depth Cooperation Zone in Hengqin has reached $600bn.
Having successfully established Macao’s bond market ‘from zero to existence,’ it calls for market participants to further explore a pathway ‘from existence to excellence.’ Looking into the future, Macao is equipped to leverage its dual markets at home and abroad by anchoring its strategy in the bond market. Through measures such as broadening and deepening market participation, innovating
The construction of the bond market has enriched Macao’s financial ecosystem”
product and service offerings, and cultivating a dynamic industry system, Macao will be able to enhance its market competitiveness, and achieve the strategic goal of appropriately diversified economic development.
First, Macao will focus on precise management of regional markets, including boosting bond market liquidity, strengthening fintech applications, and introducing more innovative investment products. Particularly in advancing the development of Macao’s secondary bond market, market participants could provide tailored services in areas such as valuation, trading, and funding support, in order to improve liquidity of the bond market.
In addition, Macao will leverage the development of the Greater Bay Area and its role as the platform connecting China and Portuguese-speaking countries as strategic opportunities, and continue to strengthen cooperation and exchanges with financial institutions and industry organisations in Chinese Mainland and Portuguese-speaking countries. Through measures such as crossborder collaboration, resource sharing, and the integration of complementary advantages, Macao aims to achieve synergistic effects and increase the scale of cross-border investment and financing, therefore promoting its bond market across domestic and international spheres.
Last but not least, Macao will align with the global sustainable finance initiatives, and intensify partnerships with regional and international institutions to broaden investor engagement in its bond market. Macao will also explore the application of blockchain and digital currency solutions in the bond market, to optimise cross-border connectivity, elevate total factor productivity, and strike a strategic balance between risk mitigation and growth opportunities. n
As global rivalries deepen, digital currencies are becoming powerful geopolitical tools. Economist Brunello Rosa warns that central bank digital currencies may shape the next Cold War, unless the West catches up
INTERVIEW WITH
Brunello Rosa AUTHOR AND ECONOMIST
Would a retail CBDC pose a threat to commercial banks?






If money is politics in an era of shifting geopolitical sands, central bank digital currencies (CBDCs) and the underlying infrastructure will be a crucial chip in the competition between China and the West, claims Brunello Rosa, head of consultancy firm Roubini & Rosa Associates, in his book Smart Money: How Digital Currencies Will Shape the New World Order. A former Bank of England economist who teaches at the LSE and Bocconi University and advises a UK parliamentary committee on CBDCs, the Italian thinker has an inside view of how technology shapes the emerging monetary order. In an exclusive interview with World Finance ’s Alex Katsomitros, Rosa argues that China’s digital renminbi is part of a ploy to undermine the western monetary system in tandem with its Belt and Road Initiative, whereas President Trump’s digital dollar ban and culture wars over privacy and ‘programmability,’ the ability of CBDC issuers to automatically set conditions for their use, may set the US back.
Why has a technical topic such as CBDCs become so politicised?
They are indeed a technical adjustment to the liability side of central banks’ balance sheets. But there is also a geopolitical dimension, because this is how China can internationalise the renminbi. There are also concerns over privacy, an inherently political issue. Finally, flags, national anthems and currencies are symbols of sovereignty. Once you start altering them, politicians want to have a say.
Are concerns over privacy and programmability warranted?
The ability to track transactions raises concerns, but banks and credit card issuers already do that. Central banks provide stronger privacy guarantees. An authoritarian government could use this information against you.
But the problem is the authoritarian state, not the instrument. They could abuse any technology. So this concern is not entirely warranted. Plus, there are ways to minimise the problem, although not completely eliminate it. It is different with programmability. People believe that governments and central banks will control how they spend money. You want to buy cigarettes and the state forbids that. But the probability is low. Programmability allows money to do things it couldn’t do before due to embedded smart contracts. This feature could be used for good or bad purposes. Think of nuclear energy: you can have unlimited energy or a nuclear bomb. It is not the technology that matters, it is the way it is used.
The new US administration supports cryptocurrencies, but President Trump has banned the digital dollar. What is your take on US policy?
The US has a different tradition from China’s, so instead of a state-backed CBDC, they chose a private-sector solution: stablecoins. They will just regulate stablecoins and other cryptos. Eventually they will realise, possibly after a crisis, that the system only works well with a CBDC as the foundation of trust. Without it, the digital asset environment is inherently unstable.
Some think that stablecoins could help the dollar remain the global reserve currency in the digital era. Do you agree? I do. China has made its move with a statebacked solution that will facilitate the international use of the renminbi. The US decided to go the other way with stablecoins. Even with the narrower definition of stablecoins, issuers will need to keep a large amount of liquid assets to guarantee the one-to-one peg with the dollar. Those dollar-denominated assets are almost certainly US Treasuries, which helps sustain demand for them despite reduced confidence in US assets amidst a trade war. The US response is a smart move, but their success depends on how acceptable these stablecoins will be worldwide.
People fear it could lead to disintermediation and ask: Why should I keep my money in a commercial bank deposit account, when I can keep it in a safer central bank account? There is only limited risk, because in a two-tier system, the central bank would have liabilities, but commercial banks would maintain the customer relationship, issuing the wallets. You can introduce – and Europeans want to do that – holding limits on the amount of CBDC held by individuals. Eventually banks will continue to extend credit, not central banks. If you want a loan, you will still have to go to the bank. But banks will need to adapt to the new reality. Making money out of payments to people and companies may not be possible. They need to find new revenue streams. For example, they can issue their own stablecoins or tokenise their deposits and add functionalities to their liabilities.
What is the link between smart money and the global race for resources?
It is the same geopolitical dimension at play when we talk about rare earths, tariffs, seizing territory, say Greenland or Taiwan. China has launched the Belt and Road Initiative, its sister project called Digital Silk Road, its CBDC and also agenda 2025. So there is a continuum of projects bringing China to the next level of technological development. Once you start building infrastructure for bridges and ports, you also build digital infrastructure: payment centres, data centres, 5G, telecommunication satellites, e-government in various countries. Part of this is the payment system where the digital renminbi will run. All these things are closely related.
Is de-dollarisation their endgame?
After WWII, to turn the dollar into the global reserve currency the US decided to run a current account deficit, which is what the current administration is worried about. Well, they wanted it in the first place! They also accepted having an open capital account, meaning that they had to send dollars overseas to pay for imported goods, but also to be converted into other currencies. China does not want to do that. China wants to remain an export-led economy, not a consumption-led economy like the US, and therefore it has a current account surplus, meaning that more renminbi



comes in the country than goes out. They do not want to open their capital account. That would cause a massive outflow of money because people fear that the government can seize their money. So how can the renminbi become a reserve currency? Well, technology is the answer. If China builds the rails on which digital payments are run, it wouldn’t matter whether it has a current account surplus. What matters is who builds and controls that infrastructure, and it’s China. That is the way for China to establish a reserve currency in its sphere of influence.
Are there any risks for China?
If China does not achieve these goals peacefully, it may become more aggressive geopolitically. Instead of focusing on economic prosperity, it may get into foreign adventures, something it has avoided over the last 100, if not 1,000 years. China has never been expansionist. They might be tempted to do so, but I don’t see this as the most likely scenario.
“If China does not achieve these goals peacefully, it may become more aggressive geopolitically”
“People believe that governments and central banks will control how they spend money”
You can’t provide full anonymity; only cash guarantees that. But you can make sure that people’s identity cannot be discovered without a judicial warrant and they can spend money without government interference. Programmability will only be used when you receive money so that governments can implement targeted fiscal policies focusing on specific groups or even individuals, but there will be no control of how money is spent. Authoritarian CBDCs could be used as instruments of surveillance to prevent people from doing what they want. But it is the country’s leadership, not the technology, that matters. Authoritarian regimes will choose authoritarian solutions.
Doesn’t that lead to a fragmented global monetary system?
The system needs to be interoperable, meaning that solutions adopted by individual countries should be integrated internationally. If not, instead of having a homogeneous monetary system whereby money can flow instantaneously, we will have a more balkanised system where money meets more obstacles. Countries need to cooperate and find common protocols, but in the current fragmented geopolitical environment, this might be a challenge.
Can the West catch up, given China’s 10year head start?
It is difficult. If you are 10 years behind, you can’t catch up in 10 months. But the EU has shown that if you put your mind to it, you can achieve remarkable results relatively quickly. They started working on it around 2018. They are now finishing their investigation and preparation phase and implementation starts in October, which could lead to a 2027 launch. You cannot catch up, because meanwhile China will have progressed. But you can partly recover the lost ground, if you are consistent. For the US, the problem is the presidential ban. It will be difficult to catch up, because they will waste four more years. They bet that private solutions will do the job, and a public safe asset won’t be needed. That is not a safe bet. The US should adopt a public safe asset for its citizens’ digital wallets.
What will be the differences between liberal and authoritarian CBDCs?
The technology offers the issuer plenty of control. Potentially, you can track or at least reconstruct ex post every transaction, which could be a significant control tool. The challenge is having good governance that makes the system less pervasive.
Is a global CBDC, like a digital version of Keynes’s Bancor, a viable solution?
Keynes proposed Bancor in Bretton Woods, knowing that history could repeat itself with protectionism, trade wars, authoritarian regimes and eventually war. He thought that reducing trade imbalances was important to avoid a repeat of history. The IMF was established to do that and make sure that no country could exploit the exorbitant privilege a reserve currency offers – first to Britain, then the US. But he lost the argument to Harry Dexter White, the US envoy, on the grounds that the dollar could serve as a reserve currency. Could we see a digital Bancor? As it was not accepted back then, it is unlikely to be accepted now. Which central bank will issue and manage that currency? Theoretically speaking, perhaps the IMF. But there is no consensus for making them an international currency issuer. Bretton Woods institutions are under attack, even from the US where they are based. So I do not see a digital Bancor emerging anytime soon. If anything, we are moving in the opposite direction: a plethora of private-issued stablecoins that may mark the return of ‘free banking’: institutions issuing their own liabilities. This is the risk the Bank for International Settlements has identified and why they do not like stablecoins. n
Blending tradition with bold innovation, Banco Popular Dominicano has emerged as the most digitally advanced bank in the Dominican Republic, revolutionising customer experience through cutting-edge technology, human-centred service, and strategic transformation
WORDS BY Francisco Ramirez EXECUTIVE VP OF PERSONAL BANKING AND


compromising service quality. Additionally, routine services have been redirected to the teller area, streamlining internal office flows and allowing staff to focus on more valueadded consultations for customers.
The bank has also migrated non-face-toface services to a highly efficient internal service centre, further reducing wait times and enhancing the customer experience. This strategy enables higher-quality in-branch interactions, turning each meeting into an opportunity to deepen the client relationship. In this model, each officer is not merely a manager, but a true financial advisor.

sitioning itself at the forefront of modern banking in Latin America. This bold redesign has transformed its branches into more spacious, efficient, and technologically advanced environments that offer customers a more agile and personalised experience, promoting self-service alongside tailored attention. The bank’s aim is to ensure high-quality customer interactions by dedicating more time to strengthening relationships, allowing clients to see each banker as a trusted financial advisor.
Delivering greater value to the customer
As a result of this transformation, wait times in branches have consistently improved by 50 percent, offering a faster experience without
cards. Standout products include the Visa ISI and Mastercard Infinia cards, and the BIZ portfolio for business clients. The Mastercard United MileagePlus card was also relaunched with an enhanced value proposition.
Unlike other digital transformation models that reduce human interaction, Banco Popular has embraced a unique approach: ‘More digital, more human.’ This philosophy is embodied in a customer service model that prioritises relationships, guidance, and closeness –even in digital settings. Today, more than 100 financial officers provide remote assistance, doubling the number of customers served by personal advisors.
100 million
Transactions in the last year on App Popular
Banco Popular has also demonstrated an ability to understand and meet evolving customer needs – from young people purchasing their first home to entrepreneurs seeking capital. Accordingly, the bank has expanded its presence beyond traditional branches by deploying business units directly within real estate agencies, car dealerships and retail stores. This proximity allows them to be present at critical moments in customers’ fi nancial lives. The success of this transformation is not measured solely by efficiency or digitalisation metrics. It is also reflected in the strength of the bank’s organisational culture, driven by professionals committed to the economic and social development of the country. At Banco Popular, we embrace the challenge of constantly evolving for the benefit of our customers and the country’s development.
In the ‘Digital and Multichannel 2024’ study conducted by Finalta (a McKinsey & Company subsidiary) – which evaluates and compares the performance of over 200 banks across 50 countries – Banco Popular Dominicano ranked above the Latin American average and even outperformed global digital leaders in customer activity at ATMs and branches, product sales, officer productivity and new customer acquisition.
Additionally, having been recognised for four consecutive years as the ‘Most Digital Bank in the Dominican Republic’ by the Superintendency of Banks’ Digital Banking Ranking, and having received numerous international accolades from institutions such as World Finance, The Banker, Latin Finance and Euromoney, Banco Popular demonstrates that the future of banking lies not only in technology, but in its thoughtful integration with empathy, strategic insight, and long-term vision. n



GOVERNMENTS AROUND THE WORLD ARE BANKING ON INFRASTRUCTURE INVESTMENT TO RETURN ECONOMIES TO GROWTH. BUT WHERE WILL THE MONEY COME FROM? DAVID WORSFOLD REPORTS »

ith fiscal constraints a dominant feature of the economic landscape across major economies, politicians’ eyes are increasingly alighting on the trillions managed by financial institutions. They are knocking on the doors of banks, pension funds, insurance companies, sovereign wealth funds and asset managers in a drive to persuade them that investing in a wide range of infrastructure projects would be good for their balance sheets, their investors and their policyholders.
The sums are huge. McKinsey & Company has estimated that globally an average of $3.7trn of infrastructure investment will be needed every year just to keep pace with economic growth. A large slice of this will be financed by governments, but this will only go so far, according to the Global Infrastructure Hub, a G20 initiative supported by the World Bank. In a recent report it estimated that by 2040 the world faces an investment gap of $15trn. However you look at the challenge, the sums needed from the private sector to address it are huge.
Institutional money is there and is constantly seeking the most appropriate assets to invest in, but the willingness to commit it to massive public infrastructure projects is very restrained, according to Manpreet Kaur Juneja, an infrastructure specialist with the World Bank: “Despite their ample resources, private financiers often view infrastructure investments as high risk. These perceived risks are the result of a complex set of issues, such as large asset sizes, long project life cycles, complex structuring, large initial irrecoverable costs, political and regulatory changes, wariness of citizens to accept privately run services due to perception of higher prices, and the lack of tradability of infrastructure assets,” she said in a recent World Bank blog.
The shopping list of projects debt-constrained governments are seeking injections of vast amounts of private sector finance for gets longer every time a finance minister is forced to answer the question: how are you going to pay for that?
Many of the projects seeking private sector finance have been talked about for several years and some have already found a place in investment portfolios, either through direct participation or through one of the many infrastructure bond offerings (see Fig 1). So, what do these projects look like and why might they appeal to private investors?
When some of the world’s biggest investors gather in Los Angeles in September for McKinsey’s 10th Global Infrastructure Summit, they will be tackling a broad, ambitious agenda that embraces a wide range of opportunities:
Delivering smart, green infrastructure: The energy and digital transitions require a huge portfolio of new assets, from chip plants to offshore wind farms and modern port terminals.
Renewing critical infrastructure assets: While there is significant demand for construction of new projects, most of the world’s infrastructure already exists. Much of this brownfield infrastructure requires rejuvenation to become more technology-enabled and energy-efficient.
Integrating AI and disruptive technologies: An enduring industry challenge given long asset lifecycles, technology fragmentation, and other hurdles from privacy concerns to skill gaps.
Embracing the age of digital infrastructure: Data centres, fibre networks and semiconductor fabrication facilities will all become critical assets for investors and governments.
Transforming this shopping list into attractive investment opportunities will run into the harsh realities of geopolitical uncertainty and financial volatility, reinforcing the longstanding reluctance of potential investors.
As the world emerged from the Covid-19 pandemic, there was a burst of enthusiasm for stimulating the urgently needed economic recovery through infrastructure projects.

This was typified by President Biden’s Green New Deal, with its echoes of his predecessor Franklin D. Roosevelt’s New Deal that revived the US economy so successfully in the 1930s. Biden wrapped up a range of green transport projects, such as encouraging a switch to electric vehicles and the development of sustainable aviation fuels, along with major investments into renewable energy, grid modernisation, carbon capture and adaptations to meet the challenges of climate change. These plans were launched through the Inflation Reduction Act 2022 and the Infrastructure Investment and Jobs Act 2021. These committed hundreds of billions of dollars in public funding but also touted the prospect of raising $250bn from the private sector. This process had barely started when Donald Trump entered the White House at the beginning of the year, quickly making it clear that the Green New Deal was dead and that the flow of public money into hundreds of projects underway or ready for launch could be about to dry up.
The winds of change
Inevitably, investment portfolios are being rebalanced in response to these shifting policy priorities, further complicated by the contin-

uing shock waves from the Trump administration’s unpredictable tariff policies. It is no surprise given the shunning of net zero ambitions and the reversal of policies for reducing the use of fossil fuels that renewable energy projects, in particular, are struggling to raise finance. Some renewable-focused funds have seen reduced inflows, while traditional infrastructure assets – such as roads, bridges and airports – are regaining prominence.
This does not mean that the flow of money into renewable energy projects will dry up, says Illia Kyslytskyi, asset manager at Florida-based Yaru Investments: “The threat of the downfall of the Biden administration’s Green Deal initiatives has consequences for green infrastructure investment in America’s future. Whereas certain initiatives would be denied federal support, state governments and the private sector may still drive investment into wind and solar power, electric vehicle charging stations, and climate adaptation programmes.”
Investors will still be looking for some reassurances, however: “As far as such programmes go and whether they continue to gain institutional investors, that hinges on regulatory guarantees, tax credits, and the development of new funding vehicles.”
These shifting priorities are not unique to the US. In the UK and Europe, the need to ramp up defence spending has led to a reappraisal of government spending priorities. In
The International Finance Corporation, part of the World Bank, has led the creation of a viable green bond offering. The aim is simple: to finance sustainable, climate-smart projects with a positive environmental impact, with the goal to speed the transition to a lowcarbon economy. IFC green bonds were first issued in 2008 as senior unsecured debt, following that in 2013 with the first global US Dollar benchmark green bond in the market, which took green bonds from being niche products to mainstream assets. Other multi-national institutions, such as the Asian Development Bank, have also helped grow the market. The IFC’s green bond programme is now complimented by a similar social bond programme with broader objectives, including affordable housing, access to healthcare and education, food security and clean water projects. It is estimated that by mid-2024 the global green bond market surpassed $2trn in cumulative issuance since inception, with over $500bn issued in 2023. For social bonds the cumulative issuance is now over $800bn.
some countries – Germany being the most obvious example – it has also led to long-standing fiscal and debt rules being reassessed. Such major policy shifts have consequences across other asset classes.
Germany’s shift from its historic reluctance to borrow to a ‘whatever it takes’ plan for military and infrastructure spending helped boost 10-year Bund yields to nearly three percent in March, a two-year high. This has driven up bond yields across the Eurozone, thanks to German debt’s role as the de facto benchmark for the bloc’s market.
This has led to warnings that the additional borrowing costs countries might incur relative to Germany could widen, making it much harder for some countries to borrow to support increased military expenditure. Cue yet more eyes being cast towards the private sector, along with new solutions coming on stream. It has given a fresh impetus to the development of blended finance solutions – vehicles for bringing together private and public finance in a way that delivers for both sides. These are nothing new.
In the UK in the mid-1990s and into the current century, the Private Finance Initiative played a major role in UK infrastructure development, building many new schools and hospitals. This served its purpose at the time but needs a rethink, said investment special-
ist HICL Infrastructure in a recent report published by Investors Chronicle : “There is now a pressing need for a new public-private co-operation model. One that retains successful elements of past initiatives, while learning from their shortcomings. This evolved model should be less cumbersome, allowing private capital to engage more dynamically with public projects.”
The Labour government in the UK is making plenty of noise about the need for infrastructure investment, giving the green light to projects such as the Lower Thames Crossing and unleashing a series of reforms to the planning system to make it easier for major housing and industrial developments to be approved. It will have to move quickly if it wants to attract large sums of highly mobile international capital.
Across Europe, everyone is in the same position. France, Germany and the Nordics are already leveraging new models of publicprivate partnerships (PPP) to drive infrastructure expansion. The European Union’s Recovery and Resilience Facility is also playing a critical role by providing grants and loans for strategic infrastructure projects, providing that secure foundation of public financing private investors are looking for.
Europe, faced with the urgent need to boost its defence spending in the face of America’s equivocal attitude to maintaining its long-term commitment to European security, is also exploring the integration of infrastructure development with defence needs. Dual-use infrastructure, such as ports, railways, and cyber networks, already serve both economic and security purposes. This blending of infrastructure and defence spending is in its early days but is an attempt to address the fears of some that defence spending may crowd out infrastructure funding.
Canada has long been regarded as a PPP leader using an availability payment structure, where the government pays the private operator fixed periodic fees in return for delivering and operating the infrastructure to agreed service levels. Because the government assumes usage risk in this model, private partners enjoy a secure revenue stream as long as they meet performance standards.
According to the Inter-American Development Bank, many Latin American countries have successfully embraced PPPs to close infrastructure gaps. It says the region leads the developing world in attracting private participation in infrastructure, with an estimated $770bn of private investment pulled in over the last 30 years – roughly 25 percent more than East Asia and Pacific countries in the same period.
These PPP models mitigate some of the risk involved in infrastructure investments, but they have not been sufficient to close that huge gap. More needs to be done. The projects are there, governments are almost pleading for private sector investment, so what more is now needed to unlock those funds?
Some of the reluctance of the decisionmakers controlling major investment funds to commit to large-scale investment in infrastructure has been the lack of liquidity. The long-term commitments implicit in major infrastructure projects often means the assets are locked into a portfolio, even when the promised returns do not materialise. This especially inhibits direct investment in major infrastructure projects, unless other incentives offset the liquidity concerns.
Investment via bonds provides some protection against this, but often there is no readymade market so exit options can be very limited. Kyslytskyi says the illiquidity challenge is a significant barrier but solutions are at hand: “Liquidity remains a fundamental concern in infrastructure investment, as such assets are illiquid and long-term in nature. Investors are circumventing this issue by increasing their
participation in secondary market transactions, where infrastructure stakes are traded to manage portfolio flexibility. Infrastructure debt instruments, such as project bonds and infrastructure debt funds, offer access to the asset class with greater liquidity than direct equity investment. Other investors are also matching listed infrastructure equities with private ownership of infrastructure as a means of balancing liquidity needs.”
Infrastructure bonds are not new but have been a relatively neglected asset class. The renewed pressure to attract private sector funds has led to an expansion in volume and variety, especially with the emergence of a new generation of Green Bonds designed to attract pension funds, insurance companies, and sovereign wealth funds.
These bonds are usually long-duration and inflation-linked, offering predictable, stable returns aligned with the needs of long-term investors such as pension funds. Those features need to be overlaid with governmentbacked guarantees or co-investment structures to reduce risk, which takes many forms with large-scale projects. The most obvious risk is abrupt changes in government policies, a fear rekindled by the gyrations in US government policy following the change in administration. Another key fear that is never far from the surface in conversations about infrastructure investment is deliverability.
This was highlighted in a recent report from the Boston Consulting Group which explored the UK’s infrastructure challenge: “Announcing new projects is the easy part. Based on historical data from 2010 to 2015 we estimate that 16 percent of announced projects did not, in the end, proceed, while a further 21 percent have become stuck in the pre-construction period for over a decade.”
One of the key challenges – by no means unique to the UK – is the supply chain. With the global demand for materials, skills and expertise ramping up at the same time this could impose a major constraint. The Covid-19 pandemic, geopolitical uncertainties and the blocking of the Suez Canal by just one huge container ship, the Ever Given, for six days in March 2021, reminded everyone of the fragility of complex supply chains.
Fund managers will expect solutions, says Boston Consulting: “In the face of such huge demand, it is not surprising that supply chains might be unable to respond effectively. Based on a series of industry case studies we have identified five common challenges in UK supply chains which underpin this,” providing a tough list for investment managers to address
BONDS ARE NOT NEW BUT HAVE BEEN A RELATIVELY NEGLECTED ASSET CLASS

before committing their funds: 1) Scarcity of key inputs across both skills and key components. 2) Lack of co-ordination and leadership at national level and within supply chains. There is no clear pipeline or prioritisation at national level and too little leadership within very fragmented supply chains. 3) The move to a seller’s market: suppliers increasingly face the choice of which clients and countries they work with. 4) Poorly scoped projects: at national and project level there has often not been proper scope optimisation. 5) Lack of effective and integrated commercial strategy.
The UK’s National Audit Office also highlighted the need for greater commercial awareness in a report – Lessons for public infrastructure investment using private finance – published at the end of March: “The government should adopt a commercial strategy to deliver successful outcomes. To achieve this, commercial expertise is needed to undertake an efficient procurement process, supplier contracts must be managed effectively, and contingency plans should include protections and alternative options to mitigate supplier risks.”
While reassurance on these key issues and the development of a more sophisticated

infrastructure bond market – with its own robust indices and greater liquidity – will go some way to stimulate the flow of private money, it will have to be matched with some serious incentives.
Tax incentives are an obvious route and have been used widely in several major economies, including the US, India and Brazil, where a new law in 2024 exempts foreign investors from the 15 percent withholding tax on interest from infrastructure bonds issued abroad. Promising stable revenue streams from investments is another tool governments can use, although this comes with political risks as it raises important questions about pricing, access, and equity. As more projects move to user-pay models, such as with the mammoth Lower Thames Crossing project east of London, there is a risk of public backlash, especially if service quality does not match increased costs.
Many institutions also point to the very restrictive treatment of infrastructure assets – mainly because of their illiquidity and valuation challenges – by regulators. This has particularly applied to the European Union and the UK, where tough solvency rules have proved a heavy disincentive. Both the EU and
UK regulators are looking at reducing the capital charges levied against infrastructure assets. This has been a prominent theme in the lobbying of the UK’s Prudential Regulation Authority by the sector, aided by pressure from the UK Chancellor of the Exchequer Rachel Reeves, who has brought leading financial institutions together in a new Infrastructure Taskforce. She has made it clear she expects the private sector to fill the UK’s infrastructure funding gap and has not been shy about taking a more interventionist stance if the incentive route does not produce results.
For China, infrastructure has long been a major driver of economic growth, including its 30,000-mile high-speed rail network, costing around $500bn, the Three Gorges Dam and hydropower project and the South-North Water Transfer Project that involves diverting the Yangtze River. Private sector funding plays a very small part in these projects, with money coming from the state-funded China Development Bank and various central and local government loans. Outside of China, its foreign infrastructure investment, and particularly the Belt and Road Initiative, has been about leveraging its economic power to strengthen its strategic and military power base. It has not been without its critics as it has left the recipient countries with debt sustainability problems. This has led China to adjust its strategy, with more focused, commercially viable investments often involving co-financing with multilateral institutions.
markets, with half of that required to be channelled into UK-based investments.
This has attracted some sharp criticism from advisers who sit at the interface between institutional fund managers and policyholders. “Forcing pension funds to tilt portfolios toward one geography regardless of market conditions could distort asset allocation, reduce diversification, and expose millions of future retirees to lower performance,” warns Nigel Green, CEO of deVere Group, a global independent financial advisory and asset management firm.
TAX INCENTIVES ARE AN OBVIOUS ROUTE AND HAVE BEEN USED WIDELY IN SEVERAL MAJOR ECONOMIES
The UK government is already forcing through a major merger of vast local government pension funds in the belief this will make them look more favourably at infrastructure investment opportunities. The UK Treasury is reportedly preparing to formalise an agreement – possibly backed by legislation – that would require pension funds to commit up to 10 percent of assets into private
“It is not the job of pension managers to carry the weight of industrial policy. If UK firms are being overlooked, there is a reason for it. The solution isn’t to coerce capital into local markets. The solution is to make those markets perform better,” Green says. “People expect their pension contributions to be professionally managed in their best interests and not treated as a national piggy bank,” added Green. It demonstrates just how challenging it is going to be for governments to plug the investment gap. For every solution offered, there is a potential downside, or at least a very careful balancing of competing interests to be worked through. n
Project finance in the GCC is evolving rapidly, driven by maturing markets, reduced political risk, and growing collaboration between international and local banks to support ambitious, post-oil infrastructure goals

WORDS BY Graham Jarvis FEATURES WRITER

Project finance in the Gulf Cooperation Council (GCC) region is shifting. Hugh Morris, Senior Research Partner at Z/Yen, thinks this is because the market is maturing – particularly in terms of how political risk is seen in the region. This maturity has supported the creation of a pipeline of projects and funding because investors perceive that the geopolitical risks in the region are reducing, which permits more competition.
As a market the GCC is also attractive to them because in comparison the West offers lower risk and yields, and around the world there is a lack of low-risk, high-yield assets. Higher risk and higher yields tend to be available in the East. However, the Gulf sits in the middle of the two both geographically and from a risk profile perspective.
Morris therefore comments that lower risk makes it easier to finance projects, and so this is leading to an increased collaboration between international banks. While they have access to funds and the expertise in project finance, local GCC banks have the local market expertise and local contacts to ensure that a project is successful.
Risks nevertheless still exist. Some project finance contracts can last 20 years at least. Yet while repayments can take 12–25 years to complete, and while the duration of project finance deals is getting longer around the Gulf, many projects are refinanced early. As for debt financing, project owners do not
guarantee repayment. That tends to come from any revenue that is generated from a completed and fully functional facility.
Repayment therefore depends on each project succeeding. This increases risk, and so banks expect to be paid a premium in return for accepting the high risks associated with it. To be competitive, lenders are offering better value deals. That is a hard prospect to achieve when they need to factor in industry rules on how much capital banks must hold. So, whenever the perceived or actual risk of supporting a project is high, banks understandably want to charge a premium in order to obtain a return.
With an eye on the increasing opportunity in the region, international banks, local banks, and credit agencies are working collaboratively to provide both short- and long-term financing. To get projects off the ground, project managers are opting for short-term financing, and over a longer period of time they typically replace bank financing with longer-term bond financing. “This enables them to lock in lower rates of interest and match long-term liabilities with long-term asset revenues,” Morris explains. It also permits the matching of revenue and costs to generate a return over the lifetime of an asset.
Saudi Arabia and the United Arab Emirates lead the pack in the Gulf, Morris says, because the largest finance projects are typically in one of those countries. A key driver is the “diversification away from oil and gas to build a post-oil and gas economy in Gulf countries,” and Morris suggests the nature of the centralised directives that emanate from

their ruling families creates a short chain of command from political leaders to infrastructure projects.
For example, Morris reveals that “Saudi Arabia is investing in green hydrogen, and the UAE is investing in nuclear power. There are also major urban development projects, such as – in Saudi – the substantial development of Al Diriyah under the At-Turaif District Development Plan consisting of $50bn investment near Riyadh. The aim is to create a major cultural and tourist destination which will tap into the tourism market and replicate in Saudi Arabia what Dubai has achieved on the coast.” Nevertheless, a spokesperson for Bank ABC – Arab Banking Corporation, suggests that not everything is all rosy. It says there is allegedly a $5trn annual investment gap for clean energy and there are some COP29 short-
“Banks expect to be paid a premium in return for accepting the high risks associated”

comings. The bank therefore feels that there is a need for financial institutions to take on a leadership role. This view highlights why so many of them are concentrating their investments on energy transitioning.
However, there has also been a shift to financing projects such as hospital and education infrastructure. Ehab Nassar, a director at Fitch Ratings, comments: “It is coming on the back of the strategic shift away from oil dependency, and the governments are financing the projects as Public-Private Partnerships (PPPs).”
Initially, before 2019, project finance was limited and GCC countries such as Saudi and the UAE began to develop their PPP frameworks in the GCC region’s bid to diversify away from oil and gas, while maintaining course with renewable energy and while moving towards social infrastructure.
Nevertheless, Christiane Kuti – a senior director at Fitch Ratings – says the Barakah nuclear plant in Abu Dhabi was not financed using a PPP structure. Instead, the finance
“The aim is to create a major cultural and tourist destination”
involved a combination of debt and equity, including loans of $16.2bn from the Department of Finance of Abu Dhabi, and $2.5bn from the Export-Import Bank of Korea (KEXIM). There were also equity investments of $4.7bn from Emirates Nuclear Energy Corporation (ENEC) and Korea Electric Power Corporation (KEPCO) to establish the Barakah One Project Joint Venture Company.
The UAE recognised the project as being given a green loan because it is perceived by the authorities as playing a role in decarbonising the power grid, and for its contribution to the UAE’s green economy. Moreover, the project was refinanced in July 2023 by two leading Emirati banks: Abu Dhabi Commercial Bank (ADCB) and First Abu Dhabi Bank (FAB). They took over the loan facilities previously held by KEXIM.
Abbas Husain, Head of Infrastructure and Development Finance at Standard Chartered, says there is a financing evolution in certain infrastructure projects in the GCC region. This is because re-financing is increasingly borne by the off-taker – the buyer of the product or service produced by a project. While structured on a ‘hard mini-perm’ basis, with a shorter date, they benefit from a long-term concession agreement.
Husain explains why this is invaluable: “Key benefits include lower financing cost that results in tariff competitiveness as well as an increase in liquidity to finance these projects. Deals are re-financed by project bonds or long-term commercial debt.” However, Husain adds that infrastructure projects, where the re-financing risk is not covered, “continue to be financed by long term commercial debt, including ECA financing which provides stability and cost-effective financing over the tenor.”
Credit agency support, from either export credit agencies or development finance institutions, is available to enhance the credit profile of projects. The aim is to make them more attractive to long-term investors. “This structure also facilitates access to alternative capital sources such as infrastructure funds and institutional investors that may otherwise be wary of early-stage construction risk,” Husain suggests.
Mazen Singer – Partner in Infrastructure Finance at PwC Middle East, says that most project owners (sponsors) tend to want to refinance after a project has been operational over a period of five to eight years because the project will be at a stage where construction is complete, operations are stable, and at a point where revenue flows are more predictable.
Singer remarks: “At that point, the project’s risk profile has improved significantly, opening the door to more favourable financing terms, and this gives sponsors an opportunity to lower the overall cost of capital, optimise their debt structure, and in some cases, release capacity to fund future development.”
Singer warns that waiting longer could dilute some of the refinancing benefits, particularly as the remaining debt tenor shortens, and because this can reduce the posi-

tive impact of refinancing once a project is self-sustaining. However, Singer is seeing a broadening of the financing landscape in the region. For example, more export credit agencies are active. Singer says this reflects the scale of infrastructure investment there. This includes infrastructure funds that are “drawn by mature, cash-generative assets, and capital markets are increasingly receptive to well-structured opportunities.”
Husain adds: “As the Gulf has matured as a project finance destination, with better regulatory and governance frameworks, clearer procurement processes, and higherquality sponsors, banks have become more comfortable with the risk.” Husain believes this is complemented by the region’s strong sovereign backing as the off-take risk is typically emanating from a state-owned utility “or back-stopped by a Ministry of Finance, which has reduced perceived credit risk, allowing banks to price more competitively.”
Morris suggests there are a sufficient number of completed projects in the GCC region to see a “pipeline of successful financing, and so the projects look sensible to invest in one after another.” The projects and the collaborative nature of financing and investing in them, Morris says, demonstrate the determination
of the governments in the region to build a post-oil future that involves well-run infrastructure projects as they can be a very good class of asset for investment.
However, Morris warns, there is a need to maintain tight control of what investors take out in equity returns because they can be accompanied by debt loading. Morris argues this is what the regulator in the UK failed to do with that country’s water industry. This action left the industry saddled with debt, while investors took out handsome equity returns.
Nassar and Kuti think there is still a lack of case history, which brings uncertainty. For example, the enforceability of security in the Gulf region and a higher level of transparency in the sharing of information are much needed. So there is still some work to do to reduce risk by enforcing laws, and by developing appropriate regulatory frameworks across the GCC.
“The Gulf is well-placed to be among the leaders of the next phase of global infrastructure financing”
Regulatory frameworks are key to boosting project finance across the region, as they will bring in the capital markets at a time when the funding needs are significant. This stage of development differs materially across the GCC, with the UAE and Saudi being the most advanced markets.
Husain concords with industry analysts that progress in project finance transformation is nevertheless significant within the Gulf. However, Husain would like to see a greater standardisation of PPP frameworks across jurisdictions to enhance bankability, and deeper secondary markets to support refinancing and portfolio diversification. If refinancing risk were borne by the off-takers, there would be an enhancement of liquidity for financing infrastructure projects.
Husain ends by saying that with continued regulatory innovation and stakeholder collaboration, the Gulf is well placed to be among the leaders of the next phase of global infrastructure financing.
To achieve this end, Singer concludes that the region needs to continue to attract and develop the necessary expertise and institutional capacity. That can be done by fostering national and regional champions in project finance. n







Barbados blends idyllic island living with a world-class business environment, offering global investors a stable, transparent, and wellregulated jurisdiction backed by innovation, talent and international tax compliance
WORDS BY
Kaye-Anne Greenidge CHIEF EXECUTIVE OFFICER, INVEST BARBADOS
tation of the pillar two subject to tax rule. Investments in R&D activities also benefit from a refundable R&D credit of 50 percent of eligible expenditure. Qualifying activities span fields such as medical sciences, engineering and technology, natural sciences and financial technology. Additionally, income arising from intellectual property located in Barbados is subject to a favourable tax rate of 4.5 percent. These reforms signal Barbados’ continued commitment to ensuring a level playing field for MNEs, while strengthening the nation’s corporate tax system in the process. Barbados’ value proposition for business goes beyond compliance.






Barbados has long been synonymous with warm hospitality, pristine beaches and a high quality of life. But beyond its natural Caribbean charm emerges a well-regulated and robust business centre that has positioned the nation as a premier jurisdiction for global business.
In a world where much uncertainty exists across the globe, the discerning investor seeks a jurisdiction that provides a welcoming investment climate, one that is grounded in substance and good governance. As the most easterly of the Caribbean islands, with a size of 166 square miles, Barbados checks the box for all this and more, while delivering a compelling value proposition.
Over the years, Barbados has evolved into a respected jurisdiction for global business, offering a diverse range of investment opportunities. These include financial services, insurance, wealth management, fintech, ICT, renewable energy and R&D, to name a few. The jurisdiction continues to offer a competitive advantage for global investors and business entities. Boasting a tradition of political and social stability and a developed legal system
based on English common law, Barbados continues to attract investors near and far, who are seeking to expand their global footprint. Additionally, the jurisdiction features an expanding network of double taxation agreements with 40 countries.
Barbados is fully committed to international best practices and adheres to global standards of transparency and tax cooperation, as endorsed by the Organisation for Economic Cooperation and Development (OECD). As such, the country’s general corporate tax rate is nine percent with some sector exceptions including small businesses earning less than $1m, taxed at five percent; international shipping, taxed at 5.5 percent to one percent on a sliding scale; and insurance, with class one entities taxed at zero percent and classes two and three at two percent.
Furthermore, another major development in Barbados, influenced by the OECD’s base erosion and profit shifting (BEPS) pillar two tax initiative, has been the introduction of a 15 percent qualified domestic minimum top-up tax, which is applied to in-scope large multinational enterprise (MNE) groups with annual consolidated revenue of at least €750m. Barbados has also since signed the multilateral convention to facilitate the implemen-
What sets Barbados apart is not only the strategic benefits of doing business but the fact that its workforce is well educated and its people are warm, friendly and welcoming. Investors will also find Barbados to be a location that offers a talented and available pool of qualified industry professionals, excellent physical infrastructure including a modern seaport and international airport with efficient air connectivity, as well as a sound ICT infrastructure with fibre-optic high-speed internet. Barbados also offers an attractive option for high-net-worth individuals including quality healthcare facilities and a range of accommodation (from budget to luxury) and other amenities.
Additionally, the Barbados government has made significant strides in digital transformation with initiatives that seek to simplify the process of doing business and enhance the ease of access to services.
When you add the jurisdiction’s delectable cuisine, lively arts and music culture, as well as its year-round sunshine to the mix, Barbados offers a compelling alignment of opportunity and quality of life. In fact, the jurisdiction has emerged as an attractive location for remote work and digital nomads. The Welcome Stamp, a 12-month visa for remote workers, serves as an added bonus for business professionals who value lifestyle, connectivity and stability – key components of the Barbados brand and an ideal place to live and work.
Indeed, Barbados isn’t just a destination; it is an experience and an informed choice. Whether you are an MNE considering expansion to a safe and thriving domicile or an entrepreneur ready to scale globally, consider Barbados, a welcoming investment climate that facilitates investment, partnership and growth.
There is no better time than now to explore the opportunities. Further information can be found at www.InvestBarbados.org n


















Water is becoming one of the world’s most critical resources –essential to life, vulnerable to conflict, and increasingly investable, as technology, climate stress and social equity collide over its control
WORDS BY Oliver Hackel
SENIOR INVESTMENT STRATEGIST, KAISER PARTNER PRIVATBANK AG


In an age of accelerated climate change and increasing environmental stress, water is becoming an ever scarcer strategic natural resource. Water, however, is not just an elixir of life, but is also associated with natural catastrophes and geopolitical conflicts. As the granddaddy of sustainability, the water theme offers huge potential for investors. Investments in innovative water enterprises generate not just a financial return and diversification, but also a societal dividend.
Addressing environmental stress
We have an apparent superabundance of water in our corner of the world, but globally, (potable) water is a rare commodity that is becoming ever scarcer. Increasing environmental pollution caused by industrial waste, chemicals, and plastics is putting a strain on water resources around the world. At the same time, climate change is causing extreme weather events like droughts, floods, and severe storms that disrupt the natural hydrological balance and further strain an already tight water supply. Agricultural, industrial and urban overuse of water resources additionally worsens the problem and endangers entire ecosystems. These ecological challenges have far-reaching social implications.
In many developing countries, millions of people lack access to clean drinking water, which causes health risks like cholera and typhus and results in high child mortality. Women and girls particularly suffer because they often are the ones responsible for fetching water and thus miss out on educational and career opportunities.
Entire communities literally have ‘water up to their neck.’ According to the World Health Organisation (WHO), investments in clean water could prevent up to 1.6 million deaths each year. Committed governmental and corporate involvement and investment in water matters is both economically and ethically imperative.
Wells are running dry | Global water resources in continual decline
Per capita water availability (1961 = 100)


“If sources of water run dry, production and economic growth stall”
The thirst of artificial intelligence
Water is playing an ever more important role in the technology sector. The rapid rise of artificial intelligence (AI) and cloud technologies is particularly driving up water consumption because high-performance data centres consume enormous amounts of energy and accordingly have to be efficiently cooled.
Although part of the water used to cool them can be recycled, a lot of it gets lost to evaporation. Moreover, water abstraction for data centres is often regionally concentrated, which creates additional challenges in arid areas like the US state of Arizona or parts of Spain. So, pressure is mounting on technology companies to develop more sustainable methods. Closed recirculating cooling systems, rainwater utilisation, and low-evaporation technologies are considered promising solutions for quenching AI’s thirst for water without further straining global water resources.
In addition, site selection is playing an ever bigger role in protecting water reserves. Meanwhile, investors and the public are demanding transparency, compelling companies to disclose their water consumption and to present strategies to reduce it.
Over 97 percent of the water on Earth is not drinkable fresh water, but is salty and unpotable. Desalination of sea water is thus widely considered one of the most promising approaches to sustainably alleviating the stress on global water resources. Advancements in areas like reverse osmosis and innovative membrane technologies enable ever more efficient treatment of salt water.
The high energy demand of desalination plants had long been a drawback, but renewable energy and heat recovery lower their consumption these days by up to 40 percent. Examples like Israel and Singapore demonstrate how quasi-autarkic water circuits can be created through a combination of desalination, sustainable water management and recycling. This can relieve traditional sources of fresh water and ease regional shortages. Rigorous research and investments in expanding these technologies in an environmentally sound way are needed to enable solutions of this kind to catch on worldwide and make water infrastructure more resilient.
Only 2.5 percent of the water on Earth is fresh water… | …and 70 percent of it is locked in ice Where is Earth’s water located?
Sources: USGS & Kaiser Partner Privatbank
Water as a growth factor
Water is a driver of economic advancement. From the food and beverage and textile sectors to semiconductor manufacturing and AI-supported data centres, virtually every industry depends on a secure water supply. The dwindling availability of ‘blue gold’ directly impacts the production capacity of entire branches of industry and can permanently slow economic growth in the regions affected. If sources of water run dry, production and economic growth stall. The OECD warns that the worsening water crisis could reduce global economic output by eight percent by the year 2050. Some developing countries could even see a 15 percent drop in economic output. Outdated water infrastructure today already causes economic costs totalling $470bn annually.
Water, however, is not just a growth factor, but also a risk factor. The World Bank calculates that the damage wreaked by urban flooding causes costs amounting to $120bn per annum. While builders have to ask themselves whether they want to continue building in areas threatened by water risks, insurance companies are increasingly weighing whether they still want to insure those risks in the future. For other businesses as well, water is increasingly becoming a strategic issue necessitating proactive management. Regulatory requirements are mounting, as are the penalties that loom for noncompliance. Moreover,
if companies disregard sustainability in their water management practices, they also risk harming their reputation and losing the trust of investors, customers and the public.
$470bn
Annual costs due to outdated water infrastructure
>97%
Of Earth’s water is not drinkable fresh water 8%
Potential reduction in global economic output by 2050 from water crisis
Water – and the scarcity thereof – is also increasingly the cause of geopolitical confl icts. One example of this is the Grand Ethiopian Renaissance Dam, the construction of which is further straining the already fragile relations between Ethiopia, Egypt and Sudan because the falling water level of the Nile River threatens the livelihoods of countless people.
In Iran, in turn, persistent droughts exacerbated by decades of mismanagement are pushing people to take to the streets in mass protest while water scarcity is depopulating entire regions and fuelling social strife. Even in the US, overutilisation of the Colorado River is increasingly becoming a stress test because drastic water conservation measures are inevitable and agriculture and urban water supply networks are both reaching their limits. Diplomatic skill and foresightful policy strategies are called for to avert escalations and safeguard long-term stability.
A force of nature | Water is the greatest natural risk factor Cause of economic losses inflicted by climate-related catastrophes, 1970–2021
“The first ‘water mutual funds’ were launched around 25 years ago”
Granddaddy of sustainability
Water can be unpredictable and immensely powerful. But humanity has also been harnessing the power of water for decades. As the granddaddy of sustainable power generation, water is compellingly convincing as a steady, dependable and flexibly deployable source of energy that does not run dry even during ‘dark doldrums’ (periods of little or no sunlight and no wind). Hydroelectric power contributes to energy supply security and is an invaluable backbone of the energy transition. The subject of water also features prominently in the United Nations’ Sustainable Development Goals (SDGs), weaving through them like a blue ribbon due to its social, economic and environmental relevance. Water also is explicitly mentioned in sustainability goal number six (clean water and sanitation), which unfortunately is a still a long way from being achieved. Although access to clean drinking water and sanitation is a basic human right, 2.2 billion people around the world were still denied this fundament of health and well-being in 2022.
Hydroelectric power… | …meets 14 percent of worldwide demand for electricity Percentage share of total electricity generation
Strong sectoral concentration | Industrials and utilities heavily overweighted
Sector weighting of water-related indices versus a broad index
Investing with depth
Water is an established theme also with regard to sustainability investing. The first ‘water mutual funds’ were launched around 25 years ago. They invest predominantly in companies connected with water supply utility operation, water technology and environmental services. The utility and industrial sectors usually make up more than 80 percent of a typical ‘water portfolio,’ which thus combines both defensive and offensive qualities and promises a good risk/reward trade-off at least on paper. However, due to the high sectoral concentration, the supposedly good risk-adjusted return comes only at the cost of having to put up with an elevated tracking error relative to the world equity market (eg MSCI All-Country World Index), and that’s if the performance promise is even kept at all.
Sources: MSCI, S&P Global, Kaiser Partner Privatbank
Although active management of a thematic fund makes a lot of sense in theory because it enables one to react to subtrends and to over- or underweight fundamentally strong or weak companies, in real-world practice the majority of water fund managers do not succeed in beating the relatively simple passive water indices. Investors therefore must think about whether they have the ability to identify the best managers or should favour the more promising and cheaper alternative presented by a water ETF. There is also a third option, though it only comes into question for active investors, and that is to discerningly pick individual water-related stocks instead of investing in a mutual fund or ETF. That way you avoid product fees, but bear the risk of active management yourself. Whatever variant an investor chooses in the end, in an era of richly valued US technology stocks, a ‘water portfolio’ not only creates a diversifying counterbalance, but may even contribute to easing an investor’s conscience. n
Similar performance | but with a clear conscience
Performance of water-related indices versus world stock index










Plunging oil prices are forcing Saudi Arabia’s powerful Public Investment Fund to slash spending, threatening mega-projects, foreign investment and jobs – with global consequences for contractors, economies and markets
WORDS BY Martyn Cornell FEATURES WRITER




When the Public Investment Fund (PIF) sneezes, a very large number of companies catch colds. And plunging oil prices have given Saudi Arabia’s massive sovereign wealth fund a definite case of the sniffles, with serious implications for a huge swathe of concerns.
The PIF was worth $941bn in 2024, according to its latest annual report, making it the sixth largest sovereign wealth fund on the planet. Its assets rose almost fivefold in the eight years since 2016, a compound annual growth rate of 22 percent. It has a stated aim of seeing its assets under management pass $1.1trn by the end of 2025 and hitting $2trn by 2030 (see Fig 1). PIF has four global offices, and more than 2,500 employees.
Right now, however, the PIF is slowing down and cutting back, with serious implications for the more than 13 million foreign workers in Saudi Arabia and the many hundreds of companies that rely on the Saudi economy to keep going.
The fund, which was founded in 1971, has around 170 subsidiaries, and has been credited with stakes worth hundreds of millions of dollars at a time in household name companies including Facebook owner Meta ($522m), Disney ($500m), BP ($830m), Boeing ($700m), Uber ($2.7bn) and Citigroup ($520m).
The biggest single slice of its investments is in the energy sector, at 23 percent, followed by property, at 17 percent, IT at nine percent
and financials and communications services are at around seven percent each.
It invested more than $100bn in the US alone between 2017 and 2023, generating, according to its own estimate, 103,000 US jobs and $33bn in GDP. By 2030, PIF claims, it and its portfolio companies will have invested $230bn in the US and supported the creation of more than 440,000 US jobs.

freezes and project delays.
In the first half of 2024 the PIF was the world’s highest-spending state-owned investor, according to the consultancy Global SWF, and it was expected to raise its annual spending to $70bn in 2025, a year earlier than previously announced, according to the International Monetary Fund.
But this spring the PIF, which is chaired by Crown Prince Mohammed bin Salman,
Some budgets have been cut by as much as 60 percent, according to the web-based business news service Arabian Gulf Business Insight (AGBI). The five so-called ‘giga-projects,’ massive real estate schemes such as Neom, a planned $500bn new city meant, eventually, to cover more than 10,000 square miles in the north-east of Saudi Arabia, and Red Sea Global, a huge effort intended to massively boost tourism to the country through plans such as a 1,500 square mile new tourist des-
tination including 25 new hotels, have been
A $5bn contract at Neom was cancelled the day before the signing ceremony was due -

ject is a linear city called ‘the Line,’ originally billed as 170km long. After a host of delays, Wall Street Journal of huge salaries for imported management and a toxic work culture, the initial stage of the project has been scaled back to just five kilometres to be completed by 2030.
There have also been reports of cash flow problems leading to payment delays for contractors, particularly in the construction sector, with one leading international contractor reportedly claiming it was owed $800m by Saudi clients. The company blamed prolonged payment delays as a significant factor in its decision to scale back operations in the kingdom. One big European construction company has allegedly withdrawn from the Saudi market altogether, blaming payment risks and financial uncertainties.
Oil prices decimated
The big problem, on the financial side, is the plunging price of oil. The International Monetary Fund has declared that oil needs to be $91 a barrel to balance Saudi Arabia’s budget. But oil has not been above $90 a barrel since August 2022. At Easter this year the price of Brent crude was down below $67, and the US crude benchmark, West Texas Intermediate, had fallen to less than $64, some 30 percent below that Saudi break-even price. Soon after, at the beginning of May, Brent had dropped to $61.63, which is 30 percent down on its 12-month high, and WTI to $58.56, also 30
$6bn
Loss in income to the PIF from Aramco dividends
20%+
Level of spending cuts ordered by the PIF
percent down. The result is that the country’s giant stateowned oil company, Saudi Aramco, has already slashed its estimate for its total dividend payout for 2025 by almost a third, to $84.5bn, and may not even hit that. The PIF owns 16 percent of Aramco, and will thus see its own income from Aramco dividends drop by at least $6bn.
The PIF wants to, for example, spend money on the resorts being built along the Red Sea coast to eventually bring in 19 million tourists a year as part of Saudi Arabia’s ‘Vision 2030’ project to reduce its reliance on oil revenue. The main objective is to raise the private sector’s contribution to the country’s GDP from 40 percent to 65 percent by the start of the next decade. But the irony is that Saudi Arabia needs the oil revenue to fund the developments that are meant to eliminate the need for oil revenue.
Pat Thaker, editorial director for Middle East and Africa at the Economist Intelligence Unit, told FDI Intelligence that she expected “several large-scale initiatives may be reevaluated, postponed or even scrapped due to financial limitations.”
World Cup
One answer is to try to get more foreign investment into PIF projects. Money is required for several big and prestigious projects in the coming decade that Saudi Arabia has committed itself to, including international events such as the Asian Winter Games in 2029, Expo 2030 and the football World Cup in 2034. The country appears to be currently struggling to attract overseas interest: overall FDI flows in the third quarter of 2024 were down by 21 percent on the same period a year earlier, at $4.27bn, Saudi Arabia’s General Statistics Authority said.
However, in March, the PIF signed a memorandum of understanding (MoU) with Goldman Sachs to create funds to invest in Saudi Arabia and the wider Gulf region. The same month it struck an agreement worth $3bn with Italy’s export credit agency, Sace, saying that the deal provided “support for cooperation between Italian companies in the private sector and PIF and its portfolio companies.”
ANOTHER WAY TO RAISE MONEY IN THE FACE OF FALLING OIL REVENUES IS TO TAP THE BOND MARKETS
including Mizuho Bank, MUFG Bank and Sumitomo Mitsui Financial Group worth up to $51bn to help support funding via its local capital markets.
Another way to raise money in the face of falling oil revenues is to tap the bond markets. In January this year, the PIF unloaded $4bn of bonds in a sale that was four times oversubscribed, after attracting investors with credit spreads 95 and 110 basis points above US Treasury bonds. At the end of April the fund shifted $1.25bn in seven-year sukuk, or shariah-compliant bonds, with the offer more than six times over-subscribed. The eagerness with which investors have snapped up the bond issues at least eases fears that the news of enforced budgetary cutbacks could hit investor confidence in the giga-projects and the broader Saudi economy.
The PIF’s importance as a generator of employment cannot be exaggerated. By 2024, it is reckoned to have contributed to the creation of more than one million jobs in three years and supported the establishment over the same period of almost 50 companies in 13 strategic sectors. However, the effect of falling oil prices, a report by the consultancy JLL Middle East predicts, will be that employment growth in Saudi Arabia will plunge after hitting a high of nearly 10 percent in 2022, slowing to three percent by 2026 as the kingdom reins in spending.
This will affect a host of countries in the Middle East and South Asia that have been sending surplus workers to Saudi Arabia, and enjoying the wages they send back home. Nearly two million expatriates, skilled and unskilled, have joined the Saudi workforce in Saudi Arabia over the past two years. The country’s construction industry has more than doubled in size. But the slowdown means that workers are now looking for jobs elsewhere in the region, even if it means taking a pay cut to relocate or shift to other PIF-backed companies, according to Shyam Visavadia, the founder of WorkPanda Recruitment, a specialist in construction hiring based in Dubai.
In addition to the plunge in oil revenues, Visavadia told AGBI, “Giga-projects are scaling too quickly without long-term planning or clear strategy.” Now, future phases are “either postponed, remastered, or not receiving budget approvals,” he said.
It has also signed MoUs with Japanese financial institutions
Yet another problem is that the scale and complexity of the various giga-projects means that costs can easily exceed initial estimates. It appears the PIF may now be looking to prioritise projects with more immediate economic returns, and/or those that are further along in development. n
Brussels-based bank-insurance group KBC Asset Management is a major European player serving some 13 million clients. Despite its scale and innovative, digital-first approach, the company carefully maintains its longstanding sustainable values and personal touch
WORDS BY Frank Van de Vel CHIEF INVESTOR SUPPORT OFFICER, KBC ASSET MANAGEMENT




Leading bank-insurance group KBC Asset Management (KBC AM) – the investment arm of KBC – specialises in the sale of investment funds, advisory support and the development of innovative financial products. It has more than 41,000 employees, offering a fi ne-tuned menu of services to millions of clients across Europe, including Belgium, the Czech Republic, Slovakia, Bulgaria and Hungary. Serving 13 million clients – including 2.92 million retail and institutional investors – across Europe, KBC AM understands the importance of tailored investment solutions. With this in mind, we have developed a diverse range of services, catering to retail investors, high-net-worth individuals and institutional clients. Our expertise in discretionary portfolio management and investment funds ensures a professional, client-centric approach – and one that is carefully customised to suit individual financial needs.
So what makes KBC AM stand out? We distinguish ourselves from our peers through continuous innovation and we strive to set industry standards rather than merely following them. By staying ahead of market trends, we help clients simplify the transition from saving to investing, making it a seamless and reassuring process.
KBC Mobile, an advanced app featuring the virtual assistant ‘Kate,’ who is on hand to provide personalised investment insights. Kate’s AI-driven capabilities ensure that precise recommendations are provided, making the investment journey intuitive and efficient.
As for products and services, our digital offerings include the ‘spare change investing’ feature, where daily transactions are rounded up to the nearest euro and the difference automatically invested when it reaches a certain amount. This innovative approach allows clients to invest effortlessly, reinforcing the company’s goal of making investing a natural financial habit.
principles. KBC AM employs a stringent RI methodology to offer investment solutions that contribute to three key missions: reducing greenhouse gas intensity (CO2), meeting the United Nations Sustainable Development Goals (SDGs), and enhancing corporate governance and social responsibility.
Number of clients that KBC AM serves across Europe
To reinforce KBC AM’s commitment to ethical investing, we exclude companies involved in controversial sectors such as tobacco, gambling and weapons. As a major financial institution, we actively support the transition to a low-carbon economy and a more sustainable society by collaborating with stakeholders across various sectors.
KBC AM has been a pioneer in sustainability since as far back as 1992, when it launched Belgium’s first RI fund. Over the years, the firm has continuously refined its methodology, introducing new sustainable solutions to meet ever-changing market demands.

Our dedication to sustainability is reflected in our policy on fossil fuel-free RI funds, introduced in November 2017. In May 2018, we launched Pricos SRI, Belgium’s fi rst SRI pension savings fund, and by 2019, all our RI funds in Belgium had been certified with the ‘towards sustainability’ label, the quality standard of Febelfin, the Belgian financial sector federation.
Our well-developed digital-first approach is evident in the approximately two million active investment plans, with 59 percent of all plans sold digitally. Our focus on accessibility, meanwhile, has resulted in an impressive 92 percent customer satisfaction rate – an encouraging figure underscoring KBC AM’s commitment to service excellence.
Digital innovation with a personal touch
Our digital-first approach is key; but crucially, we are embracing the digital transformation without compromising the human aspect. Our mobile-first strategy is exemplified by
KBC AM’s expertise also extends to AIpowered advisory services, and our smart advisory engine conducts daily portfolio screenings for private wealth clients. A tool designed to inspire confidence, this system analyses risk and return factors, ensuring tailored, data-driven investment strategies.
Sustainability has become an undeniable global priority, driven by ethical concerns, financial imperatives and environmental responsibilities. At KBC AM, sustainability is seamlessly integrated into our corporate strategy. We fully recognise that financial resilience and sustainable development go hand in hand. Responsible Investing (RI) allows clients to align their financial ambitions with environmental, social, and governance (ESG)
As we are all aware, staying at the forefront of RI requires continuous adaptation. KBC AM recently updated its RI approach to place a stronger emphasis on biodiversity. The company now excludes businesses that engage in controversial land use practices or activities that negatively impact biodiversity without sufficient mitigation measures being put in place.
KBC AM remains dedicated to being a market leader in investment innovation and RI. We continuously develop strategies to reflect market trends and client preferences, ensuring that our services remain relevant and forward-thinking. By combining cuttingedge digital solutions with a firm commitment to sustainability and customer satisfaction, KBC AM is poised to remain a key player in the financial sector, shaping the future of investing. n
Afreximbank champions Africa’s long-term growth and prosperity.
For 30 years, the Bank has been deploying innovative structures to deliver financing solutions that support the transformation of the structure of Africa’s trade, accelerating industrialisation and intra-regional trade, thereby boosting economic expansion in Africa.
Subsidiaries:
Specialized Initiatives:








Six years after its signing, the African Continental Free Trade Area (AfCFTA) remains more promise than progress – hindered by weak implementation, structural barriers, and deep-rooted political and economic challenges
WORDS BY John Muchira
FEATURES WRITER



Historically, Africa has been consistent in creating a pattern of pursuing integration through grand masterplans. Many have remained just plans on paper due to mediocre implementation. A similar trend is shaping up with the African Continental Free Trade Area (AfCFTA), an agreement that was touted as the holy grail in revolutionising trade, investments and economic development.

On May 30, the continent marked the sixth anniversary of the signing of the AfCFTA agreement. Like many other grandeur treaties, AfCFTA is at the risk of losing its allure. Granted, only Eritrea has openly called the agreement pointless and opted to keep away.
Burkina Faso, Niger and Mali have been suspended after military juntas instigated coups. In essence, 45 countries of a total of 48 that have ratified the agreement believe in the principles of AfCFTA. In reality, this is as far it goes – belief in the ideals of the agreement.
Africa Kiiza, PhD Fellow at Germany’s Universität Hamburg, captures the picture. “The aspirations and ambitions of AfCFTA are brilliant. The problem was in putting the cart before the horse,” he says. He explains
a rosy picture. First was the elevation of AfCFTA to the pinnacle of Agenda 2063, putting the agreement as one of the flagship projects. The expectation was that the agreement would be the ultimate solution in resolving fundamental economic problems bedeviling the continent, namely low levels of integration, overreliance on commodity exports and limited market access for African businesses. By creating a single market for goods and services, the agreement would solidly lay the foundations for the establishment of a continental customs union. Notably, these are key preconditions for the establishment of the African Economic Community.
For AfCFTA, the goals are clear-cut, at least on paper. The overriding goal is the creation of a single market of 1.3 billion consumers with a combined gross domestic product of $3.4trn. It has other vast benefits. Most prominent is boosting intra-Africa trade by 53 percent, growing the manufacturing sector by $1trn, generating income worth $470bn, creating 14
THE FACT IS THAT AFRICA’S FUTURE IS BEING IMAGINED THROUGH FRAMEWORKS IMPORTED FROM ELSEWHERE
established in 2020, continues to be financed by the German development agency GIZ, which also finances negotiations besides offering technical assistance. Thanks to GIZ, progress has been achieved on the legal construct of the agreement cutting across rules of origin for some sectors, dispute settlement mechanism and digital trade, among others. GIZ’s support cannot be underestimated. However, it has exposed Africa on two fronts, one being administrative inefficiency and the other being the tendency to cling to the dependence of the ‘economy of borrowed institutions.’ “The fact is that Africa’s future is being imagined through frameworks imported from elsewhere,” observes Prof Dunia Zongwe, Associate Professor of Law at the University of Namibia. He adds that the situation is complicated by deep-running historical ideological tensions between Africa’s
neoliberal and Pan-Africanist doctrines that have catalysed the continent’s integration

The impact has been a slow implementationment, total formal trade within the continent totaled between 12 and 18 percent. In 2022, the Guided Trade Initiative was launched to kick start actual trading under AfCFTA. Yet, intra-Africa trade remains at below 20 percent. Last year, trade between African countries rose by 7.7 percent to hit $208bn, according to the African Export-Import Bank. The level of value addition remains lacklustre, with total value of exports standing at $682bn and imports $719bn.
By the end of 2024, 31 countries out of the 45 had initiated some form of trade, albeit quite negligible. The growing number, a significant increase from seven in 2023, coupled by the adoption of three new protocols on investments, intellectual property and competition, are a demonstration that Africa is committed to building momentum in deepening the goals of the framework. The ultimate hope is to increase intra-African trade to 53 percent, putting it on par with other continents where intra-trade is booming. In Europe, it stands at 68 percent, Asia at 59 percent and North America at 51 percent.
“The fruits of the trading bloc are lowhanging, but they will ripen incrementally depending on the implementation of the agreement,” observes Prof Zongwe. He adds that, so far, the continent is performing dismally, with a low policy implementation rate of only seven percent. Even the Africa Union (AU), the highest governing body, has admitted that so far, it has been a case of misses rather than hits on AfCFTA.
A number of obstacles to overcome
The reality is emerging that to make AfCFTA work and for Africa to realise the full benefits, the difficult task lies in tackling the myriad structural, logistical, political, economic and other obstacles facing the agreement. Addressing these challenges is proving to be slippery mainly because most countries, particularly the least developed, peg their development on inward looking as opposed to outward integration. Most aver that AfCFTA is ultimately designed to benefit the big economies that are in desperate need of new markets for their goods and services. For them (small economies), the agreement is a pursuit of profits as opposed to equality.
Kiiza gives practical examples. A US citizen has the luxury of traveling to 24 African countries without a visa. For a Uganda national, the same applies to only nine countries. This sorry state of affairs has come about by the deliberate refusal by countries to ratify the AU’s protocol on free movement of persons. Only four countries have ratified the protocol.
It gets worse. Despite being a major producer of cocoa, only second to Côte d’Ivoire and accounting for a quarter of global production, chocolate exports from Ghana to South Africa attract 30 percent in tariffs. For Switzerland, chocolate exports to South Africa attract zero tariffs.
If that is not preposterous enough for a continent craving integration, the economic disparity gives context. Burundi, whose economy is worth $3bn, is expected to open 97 percent of its market. The same applies to Nigeria, with a $487bn economy.
“The idea that liberalisation and tariff removal before building the capacity of small nations will automatically increase trade is flawed,” notes Kiiza. He adds that the continent must apply brakes on political expediency and focus on the fundamental blocks that will make AfCFTA work.
In fact, the inability of the various regional economic community blocs to flourish, despite being the foundations on which AfCFTA stands, offers vital lessons. The East Africa Community (EAC), for instance, is disintegrating due to political and economic rivalry.
Expensive barriers in the way
Top on the list of enablers that need fixing is the infrastructure conundrum. Undoubtedly, poor transportation networks, inadequate logistics systems, and inefficient border procedures are huge obstacles to trade. The physical barriers make it more expensive for businesses in Africa to trade with each other than with partners outside the continent. It is not hard to see why. In sea trade, for instance, 98 percent of shipping lines are foreign owned. For them, it makes economic sense to flood Africa with foreign-made goods that struggle to fill a container with goods produced in the continent. The challenge extends to rail transportation, where low investments have bred insignificant connectivity at a mere 0.1 percent.
While poor connectivity is a major factor in the high costs of goods produced in Africa, non-tariff barriers (NTBs) have become the toys of trade in pursuing political interests and entrenching protectionism. Subsidies, import bans, complex customs procedures, regulatory inconsistencies, corruption and other administrative hurdles continue to impede cross-border trade. In EAC, for instance, the direct cost of NTBs was estimated at $17m in 2023. Considering that AfCFTA lacks any prohibition on subsidies, which together with dumping cases count among the most litigated issues before the World Trade Organisation, it means Africa can expect NTBs to continue being used to undermine fair competition.
On tariffs, the continent has structured a progressive reduction over a 15-year period, with the ultimate goal being to liberalise 97 percent of goods by 2034. This is already proving problematic, with many of the scheduled tariff reductions yet to take effect, yet the deadline is less than a decade away. “Some countries balk at fully opening their markets because they fear losing revenue from tariff reductions or the adverse effects of stiffer competition on domestic industries,” says Prof Zongwe. He adds the fear emanates from the fact that, for most countries, the production structures are largely similar.
As a pain-reducing mitigation on the effects of tariff reduction, the continent has a $10bn Trade Adjustment Fund in place. Apart from mitigating potential negative impacts, such as tariff revenue losses and market disruptions, the fund will also be utilised in addressing the infrastructure deficits and supply chain bottlenecks. This is critical because Africa understands that for AfCFTA to have any semblance of success, the continent must break from the colonial yoke of exporting raw materials and commodities and importing finished goods. Essentially, value addition must become the new mantra. n
As today’s high-net-worth individuals face increasing financial restrictions, Private Placement Life Insurance (PPLI) is emerging not only as a tool for legacy planning but as a gateway to cross-border investment access and global portfolio diversification
Nikita Gibson


MANAGING DIRECTOR, GENEVA INTL. INSURANCE & SENIOR VICE PRESIDENT, CLARITY LIFE

Private Placement Life Insurance (PPLI) is a form of variable universal life insurance offered privately to qualified investors. Unlike traditional retail life insurance products, PPLI can be fully tailored to address global or country-specific planning needs. Whether the goal is wealth protection or enabling strategic access to investments and currencies otherwise restricted or costly, PPLI offers a versatile, legally recognised framework for high-networth individuals (HNWIs) and families.
In an era marked by growing regulation, political instability and capital constraints, PPLI has become especially relevant. Countries with foreign exchange controls, limitations on outbound investment, or underdeveloped capital
Africa and Latin America. Both carriers deliver solutions grounded in regulatory integrity and built to solve real-world financial challenges such as capital mobility, investment access and long-term succession planning.
Traditionally, PPLI has been associated with tax deferral, estate planning and asset protection – particularly in jurisdictions like the US (under IRC 7702) and Canada (under Exempt Testing). These functions remain vital. However, today’s market has evolved. Families are now seeking more than protection; they want participation – access to and protection of private equity, venture capital, real estate, intellectual property, ESG-aligned investments and even alternative assets like art. Imagine a successful family business in a country with outbound investment restrictions – seeking to diversify not just its corporate assets but its generational wealth. Through Geneva entities’ PPLI offering, the family may pay premiums into a Barbadosdomiciled policy, appoint a globally recog-

markets, present real challenges for globally mobile families seeking diversification and long-term preservation. Offshore PPLI, when structured correctly, can offer a compliant and efficient bridge between onshore limitations and global opportunities.
Within this context, the Geneva entities –comprising Geneva International Insurance, a Barbados-based 953(d) electing carrier, and Clarity Life Insurance, a non-953(d) PPLI provider – offer clients a dual-pathway approach to cross-border planning. While Geneva International focuses on US-connected clients seeking compliant offshore structures, Clarity specialises in addressing the needs of non-US clients, including families from regions such as
“Clients no longer ask only how to protect wealth – they ask how to grow it, use it and pass it on”
cess, repatriation of funds and institutional barriers to investing internationally. Geneva entities have supported clients from such jurisdictions by creating compliant, robust policy structures that offer both protection and participation. These policies become a gateway to managed investment portfolios denominated in USD or EUR, administered by professional asset managers outside the constraints of the client’s local financial system. This capability transforms PPLI from a passive holding structure into a dynamic financial tool – one that enables liquidity, flexibility and global reach while retaining the traditional benefits of insurance and wealth transfer.
Barbados has steadily built a reputation as a cooperative, compliant and capable jurisdiction for wealth structuring. It maintains economic substance requirements, has a strong bilateral treaty network and offers regulatory transparency aligned with OECD and FATF standards. The country also provides a mature legal and financial services environment supported by experienced professionals. For Geneva entities, Barbados is more than a base – it is a strategic platform. The jurisdiction enables us to meet the complex needs of globally mobile clients while adhering to international regulatory expectations. In a world where compliance and substance are as critical as innovation, Barbados offers the right blend of both.
nised investment advisor and custodian, and structure the policy to reflect their risk appetite. The result is a globally diversified investment portfolio that complies with international standards while preserving capital, ensuring continuity and enabling intergenerational transfer. This is the core of what we refer to as participatory wealth planning – a philosophy where protection and access are not mutually exclusive but work together to serve broader family and financial goals.
Access to global assets is not guaranteed for many investors. Families in countries which often face challenges with hard currency ac-
Geneva entities are actively advancing its digital transformation to deliver a more seamless and transparent PPLI experience. From streamlined onboarding to improved policy access and compliance workflows, our goal is a responsive, tech-enabled platform. As part of this evolution, investment profiling – including ESG alignment and risk scoring – will ensure each policy reflects the client’s unique objectives and values.
As wealth planning shifts away from secrecy toward strategy, clients no longer ask only how to protect wealth – they ask how to grow it, use it and pass it on. PPLI, especially when structured from a forward-looking jurisdiction like Barbados, offers a clear path toward that vision.
Geneva entities are proud to stand at the intersection of access and protection, helping clients around the world unlock new possibilities through a reimagined approach to private wealth. n



















As private credit markets balloon into opaque, cross-border megafunds chasing yield in unstable regions, the sector is hurtling toward a geopolitical reckoning – one that could blindside institutional investors and reshape global capital flows

WORDS BY Scott Rouse
FEATURES WRITER






Early in 2025, the private credit market surpassed $3trn in assets under management (AUM) and has been one of the “fastestgrowing segments of the financial system over the past 15 years,” according to an article by McKinsey. This meteoric rise has seen the industry grow by a factor of 10 between 2009 and 2023, adding $1trn in the past 18 months alone. The leading cause? Bank retrenchment. Traditional banking was forced to pull back following the global financial crisis in 2007–08, shifting away from traditional lending and becoming more reliant on debt markets and shadow banking.
Since then, of course, we have witnessed global economic uncertainty in the form of the pandemic, the Russia-Ukraine war, ongoing conflict in the Middle East and more recently, whenever the US President leaves a comment on social media or gets in front of a camera. Recent retrenchment isn’t solely driven by market volatility but also by tightening regulatory pressure, including Basel
III Endgame proposals, which would require banks to increase their capital reserves in a range of lending areas and introduce liquidity rules that would reduce banks’ appetite for longer-term loans, according to McKinsey.
With the banks sensitive to market shocks and stymied by policy, private credit has moved in, with a recent EY report estimating that “Europe accounts for roughly 30 percent of the private credit market.” There are plenty of key drivers for growth across the continent, including investment in infrastructure and
energy. Private credit is expected to play a leading role in the global green energy transition “with estimates suggesting that between $100trn and $300trn will be necessary by 2050,” according to EY. Private credit appears now to be a mainstay of the financial landscape, a counter-cyclical champion in times of economic turbulence, but what happens when private capital meets geopolitically unstable jurisdictions, and how exposed are financial markets to risks they can’t see coming?
The private credit explosion
Post-GFC, the failure and near-failure of several ‘too big to fail’ banks helped trigger the Great Recession, the most severe downturn in the global economy since the Great Depression. Millions lost their homes, their savings
30%
Of the private credit market is accounted for by Europe

and their jobs. While the economic downturn did have an effect on private credit, the data shows that “historically, private equity portfolios have generally experienced shallower peak-to-trough declines than the public markets,” according to a study on return patterns during economic downturns by Neuburger Berman (see Fig 1). While the banks had to limit their exposure, the private deal-making landscape bounced back during the later part of the recession, in 2009. The post-GFC environment was private equity’s first real stress test and it passed, albeit narrowly. A recent report on private equity during the Great Recession discusses how fund managers in private equity missed opportunities “to acquire high-quality assets at steep discounts” despite the surge in deals.
Analysts attribute the historic rise of private credit to three key characteristics. In stark comparison to the banks, PE has better access to capital and more freedom to deploy it, allowing it to increase market share and experience higher asset growth during crisis. Most global funds also have active management with a heavier focus on value creation. This provided decisive support for funds to develop new capabilities and drive transformation projects. Lastly, private equity is relatively illiquid, meaning that during economic downturns it can help insulate investors from panic selling, which typically comes with higher losses. With higher yields, bespoke terms and less oversight, the appeal of private credit cannot be overstated.
The past 15 years has seen private credit explode, but buried within this success story are reasons for caution. The most obvious is the illiquidity risk. While helpful during a downturn, the ability to get money out of an investment quickly is generally considered to be a good thing. Coupled with the fact that geopolitical instability is rarely priced in adequately, cracks could quickly form.
In comparison to market risks, geopolitical risks are incredibly difficult to hedge against. The effects of political instability, trade disputes, war, cyberattacks, climate change and natural disasters can be sudden and severe.
Not long before Russia’s invasion of Ukraine, Horizon Capital, Ukraine’s largest private equity group, had just launched its fourth flagship fund. Sarah de St Croix, head of private funds at law firm Stephenson Harwood, commented on the importance of having provisions in place to help fund managers respond to geopolitical developments. In this instance “affected managers were able to rely on their generic right to forcibly withdraw an investor from the fund where their continued participation breaches law or regulation.” Even though these clauses were drafted without a clear sense of when they might be needed, funds were able to “manage the problem of having a sanctioned investor in a commingled pool following the broad imposition of sanctions on Russian individuals in 2022.”
Private credit went global after the GFC, during a time when geopolitical risk wasn’t front of mind. Weijian Shan, executive chairman and co-founder of investment firm PAG, says “the geopolitical risks are very real nowadays. You used not to have to think very much about it. Now you really need to think about decoupling risks; you really need to think about restrictions to international flow of goods, people and capital.”
And this comes rather sharply into focus when you consider things such as sanctions risks, political unrest or local capital controls trapping foreign investments, or populist governments overturning investor protections.
Indonesia, which produces 37 percent of the world’s nickel and is a major global exporter of coal, palm oil, copper, gold and other minerals, has been engaged in a decade-long programme of resource nationalism. Indonesia’s programme has coincided with heavy demand from China and as Dr Eve Warburton of the Australian National University notes, “over this same period, the Indonesian Government introduced more and more nationalist policies – new divestment obligations for foreign miners, a ban on the export of raw mineral ores, stringent new local content re-
quirements and restrictions on foreign investment in the oil and gas sector.” Additionally and perhaps most tellingly, “observers noted an increase in court cases and popular mobilisation against foreign companies.” This is particularly significant given nickel’s essential role in electric vehicle batteries and renewable energy storage, placing Indonesia at the heart of the global energy transition.
The private credit market must navigate considerable obstacles if it is to avoid becoming a victim of its own success. Rapid growth has increasingly pushed funds into new niches, often in emerging and frontier markets where the yield – and the risk – is highest.
In Geopolitical Influence and Peace, a report by the Institute for Economics and Peace, they state that “geopolitical risks today exceed levels seen during the Cold War, driven by heightened military spending, stalled efforts at nuclear disarmament and a diminished role for multilateral institutions like the United Nations.” At the same time, we are witnessing active wars in Ukraine and Gaza, the US-China decoupling, increasing political instability and polarisation, the spread of misinformation, and a rise in the use of crossborder sanctions and capital controls.
The risk of financial contagion is also a concern for the industry. Anyone who has loaded up on private credit – think pension funds, sovereign wealth funds or insurers – increasingly has their capital tied up in opaque, illiquid private deals.
Investors run the risk of being exposed to losses they neither anticipated nor adequately priced for. Any crisis in the private credit market could have a significant knock-on effect with the broader financial system. As private credit funds stretch further into higher-risk jurisdictions to meet yield expectations, the potential for sudden, severe losses rises dramatically.
Private credit’s success has been built on access to capital, flexibility, and the ability to go where banks won’t. But those advantages can quickly become liabilities in an unstable world. As geopolitical risk surges, private credit managers and their investors must rethink how they assess the rapidly changing modern landscape. The next market crisis may not start on Wall Street or in the bond markets – but in a foreign ministry, a war room, or a populist parliament. Private credit needs to be ready. n
As financial markets face growing turbulence, the ripple effects are increasingly shaping the future of pension systems. This article explores how global volatility, trade tensions, and policy shifts are challenging long-term retirement security
WORDS BY David Razú Aznar CHIEF EXECUTIVE OFFICER, AFORE XXI BANORTE



The volatility of financial markets has ceased to be a concern exclusive to sophisticated investors. In today’s context of global interdependence, any stock market fluctuation reverberates directly through the lives of millions. One of the most sensitive and least visible links in this chain of volatility is its impact on pension funds. Indeed, the fate of future retirees is increasingly tied to the compass of global markets.
On April 2, a surprise announcement of a broad package of reciprocal tariffs affecting nearly all major trading partners was unveiled in the US. The market reaction was immediate. The S&P 500 fell by 4.8 percent, the Nasdaq plunged by six percent and major European and Asian markets followed the same downward trajectory. Shares of technology giants such as Apple, Nvidia and Tesla recorded losses between five percent and nine percent. These declines reflected investor concerns over the potential for a broad-based trade conflict.
A week later, on April 9, President Trump introduced a tactical adjustment: a 90-day pause on these trade measures and a reduction to 10 percent of the initially announced tariffs, triggering a significant market rebound. However, the truce was only partial: China was excluded and subject to a 125 percent tariff, highlighting a strategy of selective negotiation that introduced both flexibility and uncertainty.
Around the same time, the President’s criticism of Federal Reserve Chair Jerome Powell intensified, particularly over the pace of interest rate adjustments. These public statements had noticeable effects on the markets,
at times contributing to volatility. The Fed’s traditionally independent role – long seen as a foundation of US economic stability – faced heightened scrutiny.
Yet, the most consequential episode to date occurred on May 12, when the US and China negotiated a 90-day commercial truce. The agreement dramatically reduced bilateral tariffs and triggered another equity rally. In a single session, the Nasdaq jumped 4.3 percent, and the S&P 500 gained 3.2 percent. The dollar strengthened, the yuan appreciated and global markets rejoiced.
Is this the end of volatility? Hardly. Rather than isolated events, these developments point to the broader uncertainty introduced by a new, more assertive US approach to trade policy – one marked by bold negotiation strategies aimed at achieving more favourable outcomes for the American economy.
Investments with vulnerabilities
In this context, it is important to recall that pension funds allocate a significant portion of their assets to equities, even when regulations limit those investments. In Mexico, pension fund administrators (Afores) have 19.2 percent of their assets invested in equities, of which 70 percent is in foreign markets. For the funds targeting younger workers, that share rises to 23.7 percent.
$344.5 bn
Value of Mexico’s pension system, as of March 2025

of the Mexican Afore system in 1997, the real annual return has averaged 4.8 percent (or 10.5 percent in nominal terms), despite various financial crises over the decades: the 1997–98 Asian episode, the 1995–2002 tech bubble, the 2008 real estate global financial crisis driven by subprime mortgages in the US, the 2010–13 European sovereign debt crisis, the 2020 pandemic-induced market collapse, and now, the turbulence caused by President Trump’s trade policies.
THE FATE OF FUTURE RETIREES IS INCREASINGLY TIED TO THE COMPASS OF GLOBAL MARKETS
This means that although pensions are inherently long-term instruments, short-term market shocks can cause considerable impacts. In April, for example, the Afores recorded a monthly effective return of –0.6 percent, equivalent to an annualised –6.9 percent. However, the outlook is not entirely negative. Year-to-date (YTD) returns as of April, even before the rally triggered by the US-China agreement, stood at a positive effective return of 3.7 percent, or nearly 12 percent annualised. In fact, since the inception
Moreover, even in the short term, not all funds experience the same level of exposure. The Target Date Fund, managed by the Afores and designed for workers born after 2000, posted a monthly return of –0.5 percent in April, but a YTD effective return of 4.2 percent, equivalent to an annualised return of over 13 percent. In contrast, the Target Date Fund targeting individuals aged 60 and above was barely affected, recording a –0.05 percent monthly return and a 5.1 percent YTD return, equivalent to over 16 percent annualised. These differences reflect the generational structure of the Mexican system: those closer to retirement are better shielded from volatility through a higher allocation to safer assets, such as government bonds.
The good news is that Mexico’s change in scheme of Target Date Funds has proven it-

recent market recoveries, the international context remains complex and uncertain, potentially hindering long-term strategies as trade tensions become structural.
What is at stake is not merely the health of quarterly earnings or stock performance. It is the very model of economic globalisation that has underpinned global growth for decades. The protectionist policies adopted by the US, while nuanced in their implementation, challenge core principles of free trade.
Even after the truce with China, average US tariffs remain at levels not seen since the 1930s. According to estimates from the Budget Lab at Yale, the average US tariff now stands at 16.4 percent following recent adjustments. Trading partners, including Europe, have responded by hardening their own trade barriers. The result: an international climate of mounting tension and reduced cooperation.
For now, the International Monetary Fund (IMF) has revised down its forecast for global trade growth in 2025 to just 1.7 percent. It is estimated that this year global GDP growth will outpace trade growth, implying that trade as a share of world output will decline. In this environment, global economic growth is at
cent in 2025, down from 3.3 percent in 2024. The US has already reported a real GDP contraction of 0.3 percent in the first quarter. Trade, historically a key engine of expansion, is now being undermined by the closing of economic borders.
Moreover, the Federal Reserve has faced pressure from President Trump to lower interest rates. The objective is clear: to support economic growth and bolster stock market performance. However, Jerome Powell has resisted these calls, stressing the importance of carefully monitoring inflation, especially in the face of cost increases driven by tariffs.
This dilemma between orthodox monetary policy and short-term political considerations is becoming more common in advanced democracies. What is at stake is not merely the interest rate level but the institutional autonomy of central banks. This tug-of-war also affects markets, contributing to heightened uncertainty.
Amid this scenario, it is worth returning to basics: pensions rely on sustained economic growth and positive real long-term returns.
Achieving this requires more than short-term stock rallies: it requires investment in human, physical and technological capital.
Productivity – not protectionism – is the key to securing dignified retirements. If the world falls into a cycle of diminished cooperation, reduced trade, and heightened uncertainty, the effects will be more lasting than any temporary Nasdaq recovery. At the end of the day, international trade, by expanding markets, promoting specialisation and increasing competition, foster economic growth by creating jobs, also lowering production costs, increasing innovation and technology transfer, and therefore, improving living standards.
There is no doubt that the performance of the stock markets depends on the growth of global consumption and investment in world economic development. And the recent decades showed that the widespread surge of consumption in all regions came hand-in-hand with the expansion of international trade.
Mexico’s pension system has demonstrated resilience, achieving a 32 percent increase in assets over just two years, reaching $344.5bn as of March 2025. This is a good sign, but complacency is not an option. Global economic policy is shaping the structural conditions that will determine the viability of future pensions.
Recent market volatility is not accidental. It reflects a deeper transition in the rules of the global economic order. In this context, the Afores and pension funds worldwide face the challenge of navigating uncertainty with a long-term perspective, recognising that institutional stability, international trade, and productive investment remain the cornerstones of any viable retirement system, because they are the foundation of sustained economic growth.
It is the responsibility of long-term actors, such as pension systems, to remain anchored in the long term, because ultimately, this is not just about markets – it is about the people who, after a lifetime of work, expect to retire with dignity. n
Jamaica’s idyllic image masks a pressing issue: many older citizens lack financial security. With only 12 percent of adults enrolled in pension plans, urgent action is needed to address this crisis
BY Antonio Spence


Jamaica, a vibrant and culturally diverse Caribbean country, is known for its reggae music, stunning white sand beaches and warm hospitality. However, beneath the surface of this paradise exists a significant issue that is seemingly going unnoticed: low economic protection for people over 65 years old.
Research in 2022 by the International Labour Organisation (ILO) Regional Office for Latin America and the Caribbean uncovered that more than a third of retirees face a grim reality. The ILO report, Overview of Social Protection in Latin America and the Caribbean states, “The proportion of older people without labour income or pension increased from 31.9 percent in 2019 to 34.6 percent in 2020 and 34.5 percent in 2021. This coverage gap is the highest since 2012.”
This alarming statistic represents a disturbing trend and is further exacerbated by the economic challenges Jamaicans currently face coupled with the traditionally limited access to socio-economic protection nets over the years.
According to the Private Pension Industry Quarterly Statistics published by the Financial Services Commission (FSC) in 2014, Jamaicans enrolled in a private pension arrangement totalled 101,066. Ten years later, the total enrolments stood at 163,958 – a 62 percent increase in enrolments over the period. When one considers that the total working population in Jamaica is approximately 1.3 million, it means that only 12.4 percent of adult Jamaicans have a pension plan. This low adoption is an ominous indicator of Jamaica’s socio-economic well-being.
This reality begs the question, what are the systemic barriers to the broader adoption of pension saving in Jamaica? How can institutions with the ability and capacity work to shift this deep-seated and concerning reality so that there can be more involvement in re-
tirement planning? As part of NCB Financial Group, Jamaica’s largest financial institution (by asset base), NCB Insurance Agency and Fund Managers (NCBIA) plays a vital role in the nation’s financial landscape. This position gives NCBIA unique insight into the economic challenges Jamaicans face. The company is cognisant of some of the nuances that shape the financial behaviour of Jamaicans across savings, investments, insurance, payments, and pensions. From our vantage point in the industry, many of the barriers have been cultural and economic in nature and are at the heart of the slow adoption of pension schemes. Institutions must therefore work intentionally to change this reality as quickly as possible.
Cultural significance of family structure
Jamaicans place a high value on the extended family, where children often provide financial support to their parents in their old age. This cultural norm has been deeply ingrained for generations and has played a significant role in the deprioritising of investments in formal pension schemes. Many Jamaicans believe their children will care for them in their old age, making them less inclined to save for retirement.
While that reality might have held true in times past, many millennials and younger generations now face significant financial obligations of their own such as student loan debt, the cost of housing (either rent or mortgage), and the cost of their own living expenses. This situation creates a conundrum for the older parent and the young adult. In most cases, both prioritise immediate needs over future savings, leaving pension planning as another ‘nice-to-do’ activity.
Jamaica’s economy has a substantial segment of workers in roles like hairdressing, barbering, vending, carpentry, masonry, plumbing, small-scale agriculture and other independent or casual labour. Participants in this informal economy oftentimes do not participate in formal pension schemes. The reality is that, traditionally, access to such schemes was nonexistent outside of being formally employed,
101,066
Jamaicans enrolled in a private pension in 2014
163,958
Jamaicans enrolled in a private pension in 2024

leaving individuals to fend for themselves when saving for retirement. This is seen in the behaviour of the Jamaican populace, who rely on less formal financial structures such as ‘throwing a partner’ – a collective noninterest-bearing saving activity.
The reliance on informal ways to save for one’s retirement is further magnified by the fact that, historically, access to a pension scheme was limited to those Jamaicans who were employed by an institution that positioned pensions as an employment benefit. Given this positioning, and despite the advent of approved private retirement schemes, where people in the informal section can set up and benefit from a formal pension arrangement, individuals have still viewed formal pension plans as an option that is either too complicated to understand or something meant for blue-collar employed people or wealthier individuals.
A general mistrust of financial institutions is another cultural barrier to pensions in Jamaica. This distrust is fuelled by various historical and socio-economic factors. The infamous financial meltdown in the 1990s, which resulted in significant losses for investors, left a lasting impression on many Jamaicans. The mistrust has been further magnified by recent and repeated incidents of fraud in the financial sector. Unfortunately, this mistrust has carried over to formal pension planning, as people harbour scepticism about entrust-

Jamaica, institutions such as NCB Insurance Agency and Fund Managers have had to implement strategies aimed at making it easier to access pension funds and serve as advocates for the average Jamaican as they seek wider participation in this aspect of financial planning.
The first step in overcoming cultural barriers is to continue to educate the population about the importance of pensions and long-term financial planning. Public awareness campaigns, workshops, and seminars can help dispel myths and misconceptions about pensions and build trust in the formal financial sector. NCBIA has recently launched a robust public education campaign to help position pension planning as a critical component of one wealth preservation plan. The ‘Retire like a Boss’ initiative seeks to go to the hearts and minds of members of the informal economy, by tapping into their inherent nature to survive in their current lives and using that appeal to encourage them to also thrive after retirement. Similarly, increased awareness needs to be had around the performance of pension funds and how this augurs well for investors and recipients of pensions. Oftentimes, news of financial and economic challenges highlights the negative performance of invested pension funds.
tive performances of said funds. In this vein, NCBIA is proud to boast an enviable performance of its pension funds, delivering a 10year average composite yield of 11.4 percent as of the end of 2023.
Policymakers and financial institutions should be culturally sensitive in their approach to promoting pensions. By understanding the strong family bonds in Jamaica, they can emphasise how pension savings can complement, rather than replace, family support in retirement. Similarly, understanding and engaging the new workforce will require financial institutions to rethink how pension planning is positioned. The imagery of the ‘rich old person’ on a beach somewhere, while the desired reality, has not been the experienced reality of many millennials and Gen Zs and their retired parents. As such, creating a vision of the ‘real’ future has to be reimagined by players in the industry and reflected in their efforts to increase the take up of private pension plans.
Pension providers must provide online platforms to allow tech-savvy millennials and Gen Z access to these services without needing to visit a physical location. In addition, customers who engage with financial
institutions at physical locations should be introduced to pension planning at all points of onboarding or servicing, given the positive impact a pension arrangement will have on their financial futures. NCBIA is proud to be one of the forerunners in Jamaica in providing a fully digital application process for its clients. Our NCB pensions portal allows clients to select the funds they want their savings to be invested in and select how their savings should be allocated across different funds. Once enrolled, clients can also track their pension fund performance via the portal. Solutions such as this should see a shift in the number of active pension plans in the society
Finally, the role of government in creating an enabling environment for pension planning is imperative. In Jamaica, significant work has to be done to make the industry more amenable to modern realities. However, given the threat to the socio-economic fabric of society brought on by a financially unstable and ageing society, it is imperative that the government seriously considers making pension participation mandatory for all persons earning an income in Jamaica. This is a necessary step in rapidly improving the retirement fortunes of hundreds of thousands of Jamaicans. Organisations such as the Pensions Industry Association of Jamaica, of which NCBIA is a part, continue to lobby for the adoption of automatic pension enrolments, and this forms a key pillar in our advocacy strategy for the well-being of Jamaicans. In fact, the Jamaican government has already taken positive steps through the creation of the Tourism Workers Pension Scheme, which is a positive step in the right direction. NCBIA is of the view that this approach, applied nationally, will usher in a better day for so many hard-working Jamaicans.
In conclusion, Jamaica’s cultural and economic barriers to pension planning adoption are deeply rooted and multifaceted, making them challenging to address. However, with the right mix of education, innovation, and government support, these barriers are gradually being overcome. Pensions are not just for the office worker, the well-to-do, or the sophisticated investor. Living one’s best life after retirement should be an expectation for all Jamaicans, and this is the mantra that continues to drive us at NCBIA as we play our part in building a better Jamaica. n

Once the hallmark of secrecy and security for the ultra-wealthy, traditional offshore tax havens are losing their grip under mounting global scrutiny. As pressure grows from international tax reforms and transparency measures, the world’s richest are finding new ways to shield their wealth. Jemima Hunter reports »

o an outsider, offshore tax havens might look like minor jurisdictions on a map, but for the world’s most wealthy, they are anything but, acting as mechanisms for protecting and controlling vast sums of money. There has always been a distance between wealth and visibility, whether through the turquoise shores of the Cayman Islands or the golden vaults of Swiss banks. But in a sudden reversal, these very havens that once promised discretion and protection no longer work quite like they used to.
Offshore finance rarely disappears. Instead, it adapts to changing rules and oversight, while steadily continuing to grow in scale. Estimates suggest that between $21trn and $32trn of global financial assets are now held offshore, although the confidentiality of these jurisdictions makes reliable figures few and far between. The Tax Justice Network believes that the world loses around $427bn in tax revenue every single year to these illicit arrangements.
But tax avoidance is not the simple affair it once was. Traditional secrecy jurisdictions face greater pressure under OECD’s Global Minimum Tax and Reporting Standard, which has made the once convenient offshore loophole more visible and costly. In response, the ultra-wealthy are not retreating, they are adapting.
When old tricks stop working, new ones take shape. Today’s high-net-worth individuals find refuge in dual passports, tax-friendly residencies, DeFi platforms and the odd private island thrown in for good measure. Some of these choices offer genuine financial advantages; others arguably offer the illusion of escape. Still, the inventiveness of these workarounds suggests that the offshore mindset remains firmly intact, only now it is just more scattered across the globe and less reliant on the familiar offshore havens.
Burying fortunes in offshore sand is not impossible today, but it is far more difficult than it once was. With stricter regulations in place about greater transparency, financial havens are finding it difficult to operate under the radar as they once did. Leading the way is the OECD, whose two big initiatives, the Com-
mon Reporting Standard (CRS) and Global Minimum Tax (GMT), are directly challenging the structure of offshore finance. The CRS launched in 2014 and changed everything by requiring financial institutions to share information on foreign account holders within their legal domicile. According to Tax Justice UK (TJUK), “The CRS has helped reduce tax evasion, not only because of the foreign account information that countries got, but also because it has caused a deterrent effect.” The mere threat of being exposed has prompted many to come clean.
But even the CRS has its limits. “There are many loopholes still,” Tax Justice UK warned. Not every country participates – especially developing countries that lack the infrastructure to cooperate. The US opted out of joining, relying on its own regime, FATCA. “The US receives a trove of information, but shares little in return,” TJUK explain.
Then came the OECD’s Global Minimum Tax, introduced in 2021, a supposed fix for profit shifting. On the surface, it may seem like trouble for tax havens, but upon digging deeper things aren’t quite as clear cut. As Tax Justice UK puts it, “Pillar two was never about tax avoidance, but about minimum taxation.” What this means is that it doesn’t prevent companies from moving profits to tax havens; it simply ensures that at least 15 percent tax is collected on those profits. Ironically, this made the proposal appealing to some low-tax jurisdictions, as they saw it as a way to profit while technically adhering to the rules.
The GMT’s coverage is also limited. Only multinational groups with revenues over €750m are covered, excluding a substantial portion of influential companies. Because of its complexity, the system is challenging for countries with fewer resources to implement, often the very ones that are hit hardest by tax avoidance. “These are the countries that suffer the most from tax avoidance in proportion to their budget,” Tax Justice explains. Ultimately, a solution that neglects the Global South cannot effectively be considered a global solution.
“TRADITIONAL TAX HAVENS HAVEN’T VANISHED, THEY HAVE JUST ADAPTED”

Despite the tight fiscal regulations, tradi tional tax havens haven’t vanished, they have just adapted. Jason Sharman, Professor of Politics and International Studies, who spent years researching offshore finance and tax havens, commented: “Offshore financial centres in general are doing fine, there is probably more money offshore than ever before, subject to the caveat that it is harder than it might seem to distinguish ‘offshore’ from ‘onshore.’” They have re-emerged as sophisticated destinations for transparent and compliant wealth management. The Caymans maintain a register of beneficial ownership, a clear reversal from how things ran in the past. Although it wasn’t entirely self-initiated, it was a response to escalating international expectations. In November 2023, the Cayman Islands passed the Beneficial Owner Transparency Act, which came into effect in July 2024. The law broadened the rules around disclosure, requiring entities that were previously excluded like exempted limited partnerships and foundation companies, to identify and report their beneficial owners.
Although tax-friendly options have stayed high in demand, now we are seeing them take very different forms from that which we are used to. Citizenship-by-investment (CBI) schemes are growing massively in popularity, offering passports to wealthy individuals looking for flexibility. The OECD is pushing back, but as with past efforts, opportunities may develop faster than it takes the regulations to respond.

So, are tax havens on their way out? Not exactly. But the days of undisclosed dealings and no accountability are possibly behind us. Today, it is getting more expensive to comply with time and resources, regulatory loopholes are narrowing, scrutiny is unrelenting. In the words of Tax Justice UK, “Even before the new Trump administration, parts of the package were faltering, and now even the global minimum tax has an uncertain future.” It is not so much that tax havens are vanishing, but it is that they no longer look or operate as they used to. The traditional model is replaced by new and more compliant forms of wealth management. In this sense, ‘decline’ is more about evolution than extinction. History shows us one thing for certain: where wealth flows, new solutions follow.
In place of secluded financial havens stands a whole new spectrum of strategies designed to optimise tax efficiency. Whether we are talking digital currencies, decentralised financial platforms, second citizenship schemes or entire private island developments, those looking to safeguard their wealth have had to become more resourceful in recent years. While traditional tax havens aren’t irrelevant, they are in the midst of significant change. The tighter regulations, greater political pressure, and need for transparency has become more pronounced and pushed the industry to adapt. Some of these adaptations are pushing the limits of legality, while others are chal-
THOSE LOOKING TO SAFEGUARD THEIR WEALTH HAVE HAD TO BECOME MORE RESOURCEFUL”
lenging ethically. But all of them signal one thing: offshore wealth isn’t going away any time soon, it is just getting more sophisticated.
As touched upon, one of the most talked about trends in recent years has been the rise of Citizen-by-Investment (CBI) schemes. These initiatives, granted by countries including St. Kitts and Nevis, Malta, Vanuatu and many more, allow individuals to purchase citizenship in exchange for investments, often in real estate, government bonds or direct payments to state development funds. Since 2014, Eastern Caribbean countries alone have issued over 100,000 CBI passports, which just goes to show the growing popularity of these schemes across markets globally.
But are these schemes undoubtable gamechangers for tax avoidance? Not everyone is convinced. Professor Sharman comments, “The potential of CBI for tax evasion is vastly over-hyped and makes no sense. With the exception of the US, tax is based on residency, not citizenship. I am an Australian living in Britain; this doesn’t mean I am exempt from UK tax.” Still, some researchers say the story doesn’t end there, as recent data shows a more complex picture of how CBI schemes may, in
Estimated loss in tax revenue as a result of offshore finance
practice, enable financial opacity. A 2023 study published in the Journal of Public Economics found that countries introducing CBI programmes experienced a significant rise in cross-border bank deposits in tax havens, suggesting that second passports may be used to sidestep automatic information exchange between countries. Since tax havens typically share financial data based on the account holder’s citizenship, not residency, CBI can be used as a loophole. A new passport can allow individuals to open accounts under their new nationality, potentially shielding those assets from their home country’s tax authorities. As the study puts it: “CBI programmes offer citizenship rights in return for a financial investment or donation as low as $100,000. If the tax evader uses the acquired citizenship to open a bank account in a tax haven, the tax haven will exchange tax information with the country of acquired citizenship – not the actual country of (tax) residency. CBI programmes enable tax evaders to escape tax information exchange.”
Further supporting this concern, research from the EU Tax Observatory showed that jurisdictions with high-risk CBI programmes, such as Dominica, St. Lucia, Cyprus, Grenada, Malta and Vanautu, saw bank deposits in tax havens increase up to 55 percent after their CBI schemes were launched or expanded.
So, while CBI initiatives may offer lifestyle perks such as visa-free travel or a hedge against political uncertainty, their potential to encourage a lack of financial transparency still remains controversial. Some argue they facilitate corruption, contribute to housing crises in smaller economies and undermine the push for tax transparency internationally. As Tax Justice UK explains, “Citizen-by-investment programmes have negative spillovers in other jurisdictions and we have seen high-profile cases where authorities challenge the validity of these schemes.”
Heavily debated? Undoubtedly. Misused? At times. But at the end of the day, a second passport can bring leverage and freedom, regardless of the reason someone is reaching for it.
If CBI is a political workaround, then decentralised finance (DeFi) is the technological one. Built on blockchain technology, DeFi platforms create a world where you can lend, borrow, trade and invest without ever stepping foot in a bank. No middlemen, no paperwork, just code. In theory, it is financial freedom, giving users total control and instant access to powerful tools. But in practice? It comes with its own unpredictable challenges.
Cryptocurrencies and DeFi frameworks allow cross-border transactions that are difficult to trace, regulate, or tax, especially when users rely on self-hosted wallets or anonymous profiles. Still, sceptics say the hype often exceeds reality. “Crypto is not even that great for evading taxes or laundering money; cash works better,” Sharman puts it bluntly.
Tax Justice UK shared its concerns – not about crypto’s effectiveness, but about the lack of oversight. “DeFi provides greater risks of tax avoidance because unlike in the case of traditional finance, the middleman is automated – merely a smart protocol on the blockchain.” But, they note, “there was a person involved in putting this protocol there, owning, managing or earning income off it. It is a matter of creating the right reporting liability. The problem is that the technology evolves much faster than government can keep up.”
In practice, DeFi operates in a grey zone: transactions can be difficult to trace without an identity being linked, but once that link is made, the full transaction history is laid bare. In fact, a study by the National Bureau of Economic Research estimated that the average amount of unpaid taxes among crypto non-compliants ranges between $200 and $1,087 per person per year. So, while many crypto investors fail to declare their holdings, each typically owes a modest amount of taxes which, across millions of users, adds up to a substantial loss in public revenue.
In response, institutions globally are ramping up their regulations. The OECD’s upcoming Crypto-Asset Reporting Framework (CARF), set to take effect in 2026, is designed to bring crypto transactions under the same level of reporting and transparency as traditional financial accounts. But as with the Common Reporting Standard (CRS), implementation may be sporadic, particularly in developing countries, which often lack the technical capacity to participate fully.
The irony is that this blockchain, which is known for its privacy, is also an irrevers-

ible public ledger. Once linked to an identity, a user’s entire transaction history becomes visible. Crypto isn’t invisible, it is permanent. This divide could make DeFi an effective tool for transparency or expose a plethora of financial misconduct.
The most literal take on going offshore might just be this: buying your own island. What once felt like cinematic fiction is now becoming a reality for ultra-high-net-worth individuals looking for seclusion, control and a place to entirely call their own. Some are even taking it a notch further by developing ‘seasteads’ or floating city states designed to have minimal government oversight. One such example is Freedom Haven, a project in the South Bay of Bengal designed to create a community outside any nation’s Exclusive Economic Zone, providing a new form of governance with self-sovereignty and the freedom to experiment with alternative systems that avoid traditional state regulations.
But experts remain unimpressed. “Attempts at the creation of self-governing territories have been going for at least 50 years,
“DEFI FRAMEWORKS ALLOW CROSS-BORDER TRANSACTIONS THAT ARE DIFFICULT TO TRACE, REGULATE, OR TAX”
they have always been flops and farces,” says Sharman. “I don’t see anything changing.” While appealing in theory, the logistics and legal hurdles in creating these unrestricted private jurisdictions are enormous. A lot of these projects become unsuccessful or end up rebranded as high-end real estate ventures, rather than actual self-governing communities. Nevertheless, the idea still holds a certain allure. As surveillance tightens and financial oversight expands, private islands stand as the dream escape, not just from taxes, but from accountability all together.
Everyone has got their own theories on how to tackle tax avoidance, but let’s be honest, the solution will always change depending on where you are standing and who stands to gain. Tax Justice UK calls this the ABCDEFG3.
“To guarantee wealthy individuals and corporations pay their fair share of taxes we need the ABCDEFG3. That starts with the ABC of tax transparency: automatic information exchange, beneficial ownership transparency through public registers for companies, trusts and other legal vehicles, and public country-by-country reporting for multinationals. Then there is the DE of domestic measures to ensure transparency results in effective accountability, through the disclosure of sufficient public data, and

“OFFSHORE WEALTH ISN’T GOING AWAY ANYTIME SOON, IT IS JUST GETTING MORE SOPHISTICATED”
enforcement by well-resourced and operationally independent tax authorities.
“The FG2 covers the international elements: formulary apportionment with unitary taxation, to end corporate tax abuse by ensuring that profits are taxed in the location of the real, underlying economic activity; governance reform, centred on the establishment of a genuinely, globally inclusive process for the setting of tax rules and standards, under UN auspices; and a Global Asset Register (GAR), to connect and broaden the range of beneficial ownership registers across all legal vehicles and high-value assets, across jurisdictions, to provide a critical tool against abuse of tax regulations and sanctions.”
“Finally, G3 stands for good taxes – a catch-all covering a progressive and effective overall tax system, and significant individual components of the tax justice agenda including wealth taxes, climate-related tax measures, excess profits taxes and minimum effective tax rates.” Apostolos Thomadakis, Head of Research at the European Capital Markets Institute, isn’t one to mince words when it comes to tax evasion. In a report for the Centre for European Policy Studies, he laid out
his clear and pragmatic vision. “The progress made has been substantial,” Thomadakis acknowledges. “But much remains to be done.” For him, confronting offshore systems and modern forms of tax dodging means moving promptly and decisively.
“Implementation should be enforced, not only with the automatic exchange of information, but also in the context of beneficial ownership registries. Information exchange frameworks should be adapted to the current realities (crypto-assets), and the assets falling under their scope should be expanded (real estate, art and gold). Tax authorities need to be equipped with all the necessary tools (artificial intelligence) and rules that will allow them to identify tax compliance risks and to process the data collected.” But technology won’t fix a broken system alone. “International cooperation and communication between jurisdictions and different standard-setters should be strengthened, as well as in-country communication between the relevant authorities,” he says.
Whether it is regulators, compliance authorities or oversight institutions, Thomadakis wants everyone on the same page, working together in a way that can keep up with the pace of today’s financial scene.
A system built to survive
Offshore finance isn’t what it used to be, and neither are the reasons people use it. What once operated with little oversight now runs through legal grey zones, regulatory gaps, and sophisticated planning. It is no longer just about outright tax evasion anymore; it is about protecting assets, managing uncertainty, and dealing with a more fragmented international landscape. As Tax Justice UK puts it, “Tax havens and secrecy jurisdictions did not come into being overnight, and they won’t disappear quickly.” Much of that resilience lies in the fact that “the financial sector is captured by a tax avoidance industry,” which they argue “negatively impacts the democratic process and how well the economy works for regular people.”
So, what now? The intention to take action hasn’t disappeared. “There is still clearly political will,” TJUK says, “which often stems from popular dissatisfaction with tax abuse from big multinationals and wealthy individuals.” Even in a world where international cooperation feels very strained, they suggest that tax policy may be one of the few areas that is making steady progress. By 2027, a new UN tax convention, backed by countries in the
“THE PUSH FOR A FAIR TAX SYSTEM IS STILL VERY MUCH IN MOTION”
Global South, could fundamentally change how international tax cooperation works. Perhaps the most unpredictable influence is the US. Under President Trump, the US pulled back from OECD initiatives and slowed progress, often influencing the direction of talks, only to withdraw when an international agreement was close. “The withdrawal of Trump and the US may have a positive impact on the field of international tax cooperation. This is because in the last decade the dynamic has been that the US has tried to control the direction of cooperation on several occasions. They take the negotiations in the directions they prefer, and at the last moment they end up abstaining from participating,” TJUK explained.
They suggest that the US’ decision to step back from these negotiations, whether by abstaining or taking a more confrontational stance, might actually remove a longstanding obstacle. Without that involvement, there may be space for other countries to move forward effectively. There is no doubt it is a complicated situation, but the push for a fair tax system is still very much in motion. If anything, changing geopolitical influences could open the opportunity for a stronger, more balanced international tax framework, depending on how EU countries respond.
Tax policies globally have long been influenced by those with the loudest voices and the deepest pockets. But with the US retreating from international negotiations surrounding tax, it might give other countries the space to push for reforms that better reflect those that are most affected but heard the least. Still, change won’t come easily.
The offshore system often adapts more quickly than the regulations designed to contain it. Even if new regulations tighten, those determined to protect their wealth will always have the incentive to look for the next loophole, jurisdiction or digital workaround. Whether it’s decentralised finance or second passports, strategies today are harder to trace and are increasingly designed to stay just within the bounds of legality.
What has really changed is not the intent, but the method. And unless regulations keep pace, the gap between practice and policy will only widen. n

The European Union’s financial sector stands at a pivotal juncture. As cyber threats become increasingly sophisticated, discover how the implementation of the Digital Operational Resilience Act (DORA) marks a significant shift towards a more resilient and secure financial ecosystem
WORDS BY
Georgios Argytakis
EXECUTIVE DIRECTOR, JUST2TRADE
The five pillars of DORA
DORA became an official regulation on January 16, 2023, but did not come into full effect until January 17, 2025 following a two-year implementation period, during which time financial entities were expected to align their operations with the new requirements.





The Digital Operational Resilience Act (DORA) is a landmark European regulation that aims to strengthen the digital infrastructure of financial entities, ensuring they can withstand and recover from information and communication technology (ICT) disruptions. DORA introduces a uniform ICT risk management framework across the EU. However, given that many firms still have fragmented systems, legacy infrastructure, and inconsistent risk practices, aligning existing risk management frameworks to DORA’s demands will require overhauling governance, technical controls, and reporting, especially for firms operating in multiple jurisdictions. DORA also makes financial entities directly
accountable for the ICT risks posed by thirdparty vendors, such as cloud service providers or data processors.
Because of this, these companies will require far more rigorous vendor contracts, monitoring, and exit strategies. It is important to highlight that some large vendors, especially US-based cloud providers, may not easily align with DORA’s EU-centric standards.
As a leading European brokerage firm which provides its clients with access to over 128,000 financial instruments, including stocks, bonds, futures, options, mutual funds and forex, Just2Trade is at the forefront of implementing the rigorous requirements of DORA in its business model and aligning DORA with existing regulations such as the General Data Protection Regulation (GDPR) and European Banking Authority (EBA) guidelines, along with other sector-specific cyber standards.
The regulation is enforced by the three European Supervisory Authorities (ESAs): the EBA, European Securities and Markets Authority (ESMA), and European Insurance and Occupational Pensions Authority (EIOPA), who are responsible for developing Regulatory Technical Standards (RTS) and Implementing Technical Standards (ITS) to provide detailed guidance on DORA’s provisions. While some standards are already in force, others are pending adoption, necessitating proactive engagement from fi nancial entities to stay abreast of regulatory developments. As a regulatory framework, DORA is designed to enhance the digital operational resilience of the EU financial sector, and it has five key pillars that capture what it aims to accomplish and the kind of strong, healthy business environment it wants to support. Its primary objective is to ensure that financial entities can maintain critical operations during severe ICT disruptions, thereby safeguarding the stability of the financial system.

As risk management is a cornerstone of the mandate, financial entities are required to establish robust ICT risk management frameworks. This includes implementing comprehensive policies for identifying, assessing, and mitigating ICT risks, ensuring that systems are secure, up-to-date, and capable of withstanding cyber threats. DORA also mandates standardised procedures for reporting major ICT-related incidents, requiring organisations to classify incidents based on severity and report them to relevant authorities within specified timeframes, which allows for prompt responses and systemic risk assessments.
party ICT service providers, DORA imposes stringent requirements for managing these relationships. Financial entities must conduct proper due diligence, maintain detailed records of contractual arrangements, and ensure that critical service providers comply with resilience standards. The final pillar encourages voluntary information sharing among financial entities regarding cyber threats and vulnerabilities, enhancing sectorwide awareness and response capabilities.
DORA has a comprehensive scope encompassing a wide array of financial entities, including: credit, payment, and electronic money institutions, investment firms, crypto-asset service providers, insurance and reinsurance undertakings, central securities depositories, trading venues, and crowdfunding service providers. Additionally, DORA extends to ICT third-party service providers, particularly those deemed critical to the operations of financial entities. These providers will be subject to an oversight framework established by the ESAs, ensuring their compliance with resilience standards.
DORA IS
DESIGNED
DORA highlights the importance of regular digital operational resilience testing, which is compulsory for most investment firms. This involves a variety of tests, including scenario-based tabletop testing, vulnerability assessments, open-source analyses, performance testing, and threat-led penetration testing (TLPT), for entities deemed systemically important, to ensure preparedness against potential cyberattacks.
TO ENHANCE THE DIGITAL OPERATIONAL RESILIENCE OF THE EU FINANCIAL SECTOR
Given the heavy reliance on third-
Implementing DORA to ensure compliance and resilience has several challenges for financial entities, not least the need to carry out extensive reviews of their current ICT infrastructures to identify all vulnerabilities and implement robust risk management frameworks. This will also mean updating information security policies and establishing business continuity plans, to ensure that ICT systems are resilient against emerging cyber threats. To comply with DORA’s incident reporting requirements, it will be necessary for financial entities to develop and maintain standardised procedures to detect, classify, and report ICT-related incidents quickly and accurately. This demands investment in monitoring tools and comprehensive staff training, which can strain resources and operational capacity.
Under DORA, regular testing of operational resilience is essential to assess preparedness against cyberattacks and operational disruptions, with any identified weaknesses addressed through targeted remediation efforts, which can be operationally disruptive. And while DORA promotes collaboration, building a culture of open information can be difficult as some institutions may be hesitant due to competitive concerns or fear of reputational damage, making it a challenge to create trust and transparency across the sector.
With the sector’s reliance on third-party ICT service providers, financial institutions
need to apply stricter due diligence processes. This means that the legal and compliance teams play a pivotal role in navigating the new and complex regulatory landscape. They need to interpret regulatory requirements and ensure organisational alignment, draft and review contracts with ICT service providers to include DORA-mandated provisions, develop internal policies and procedures for incident reporting and risk management, and provide training and guidance to staff on compliance obligations.
Implementing DORA will result in a number of significant benefits for Just2Trade’s clients, specifically the ability to prepare for and manage potential IT incidents effectively, which translates to less downtime, fewer service disruptions, and smoother access to financial services for clients, even during technical or cyber crises. Additionally, the implementation of robust cybersecurity controls and regular testing will ensure clients benefit from better protection of personal and financial data against hacks, leaks and fraud.
Like all financial entities, under DORA, Just2Trade must log and report major ICTrelated incidents, including their impact and response, which will result in increased transparency on issues that could affect their clients’ money, personal data, or digital services. Additionally, the application of stricter rules on how thirdparty tech partners and cyber risks are managed will result in services becoming more reliable and resilient, increasing client confidence levels when using Just2Trade’s trading platforms and investment tools.
Overall, implementing DORA reduces the systemic ICT risks which Just2Trade faces, resulting in a safer financial ecosystem for clients with fewer chances of industry-wide failures due to tech outages or cyberattacks. That is why Just2Trade has prioritised DORA compliance to safeguard its operations and maintain stakeholder trust. While the journey presents challenges, it also offers an opportunity to enhance digital resilience and foster a culture of security and preparedness.
By embracing DORA’s framework, the EU financial sector can stay better protected against growing cyber threats, ensuring stability and continuity in an increasingly digital world. n
markets
Once dominated by human intuition, gut feelings, and the occasional lucky guess, trading floors have now welcomed a new player: AI. But with AI-driven trading strategies becoming the norm, are they making investing smarter or just more unpredictable?
Artificial Intelligence WORDS BY
Claire Millins
FEATURES WRITER






Artificial Intelligence (AI) exploded into the mainstream in 2023, and its adoption is showing absolutely no signs of slowing down. From technology, health, and manufacturing to customer services, marketing, and even retail, AI is everywhere. And let’s face it, who hasn’t used Chat GPT (other LLMs are available) for a bit of inspiration or help sometimes. But, AI itself is nothing new. It has been around since the 1950s, and the financial sector was an early adopter back in the early 1980s when James Simons founded quantitative investment firm Renaissance Technologies. Early financial use of AI included power trading and expert programmes, and as computing power has improved over the intervening years, so too has AI’s capabilities, shifting how markets operate from trading algorithms that execute within milliseconds to predictive analytics anticipating market shifts.
The role of AI in financial markets
From machine learning algorithms to natural language processing, AI technology is designed to mimic how the human brain thinks, understands, learns, and remembers, but with one valuable difference, which is especially useful when it comes to finance: it removes emotion. Analysing huge amounts of complex, unstructured datasets and realtime data in a fraction of the time it takes a human agent, AI can spot patterns that the human analyst may overlook, due to various biases, conscious or otherwise, detect data outliers and anomalies, and forecast market trends with pinpoint accuracy. Obviously, this means that this efficiency, speed and accuracy are a few of the key advantages of using AI in market analysis. However, one of the standout features of AI is in its scalability to work equally as well with large datasets as it does with small, niche ones, making it suitable for
both large-scale data analysis and the management of diverse investment portfolios. AI can also help to provide continuous monitoring of market movements, observing trading trends, and anomalies in trades, and flagging suspicious behaviour in real time, making it an efficient way to minimise risk and mitigate fraudulent activity.
As AI’s capabilities have improved over recent years, it has become a significant tool in asset management, specifically generative AI (GenAI). AEIQ, launched in 2017, was the first public AI-driven fund, and many more funds have since also added AI tools and big data into their strategies. PwC’s 2023 ‘Global Asset and Wealth Management Survey’ predicted that the amount of assets managed by algorithmdriven, AI-enabled platforms will double to almost $6trn by 2027 (see Fig 1), while their 2024 survey revealed that 80 percent of asset and wealth management organisations say AI will fuel revenue growth, and those organisations adopting ‘tech-as-a-service’ could potentially see a 12 percent revenue boost by 2028. As an example, hedge fund start-up, Minotaur Capital, has replaced traditional analysts with AI and, since its launch in May 2024, has seen a 13.6 percent FYTD increase against a 2.03 percent 12-month increase of the global stock market (MSCI All-Country World Equity Index).
Traditional algorithmic, rule-based trading systems rely on static conditions and predefined rules, whereas algorithmic strategies underpinned by AI and machine learning can help institutional and retail traders adapt, refine, and improve their decision-making process in real-time in an effort to outwit the market. While they can help generate ideas, develop strategies, and even execute trades, they are, however, just tools, and should never be used to replace human judgment, but rather complement it to enhance performance. In general, trading models are built following a structured fourstage process: collecting and analysing market
AS AI’S CAPABILITIES HAVE IMPROVED OVER RECENT YEARS, IT HAS BECOME A SIGNIFICANT TOOL IN ASSET MANAGEMENT

data to recognise patterns, identifying factors that filter out unnecessary noise, training the model with historical data so it learns how different market conditions impact trade volumes, and then testing in the live market and continually monitoring performance. High-frequency trading (HFT) is one trading method that takes algorithmic execution to the extreme. It uses complex algorithms for lightning-fast analysis of multiple markets and trades are executed in microseconds. And because speed is of the essence, AI and machine learning are vital to HFT success. The algorithms need to process enormous streams of real-time data, order books, price ticks, news feeds, and decide, in fractions of a second, whether to enter or exit positions. Reinforcement learning (RL) and neural networks are often used to optimise execution, manage risk exposure, and identify fleeting market inefficiencies faster than any human could.
Using statistical and data analysis techniques, predictive analytics is used to forecast future market trends based on historical and current data. AI-driven models are still trained using historical data to identify patterns, relationships, and trends, but the big difference is that while traditional models required manual adjustments and pre-defined assumptions, the AI model continuously refines itself. Machine learning algorithms, deep learning networks, and natural language processing (NLP)

risks, and optimise their portfolio. Additionally, using real-time data sources from social media, news articles and internet sources, AI can measure the sentiment towards a stock, sector, or general market, and detect any movement; positive, negative, or neutral, signalling a potential movement in price, before others flag it. Using this ‘sentiment analysis,’ investors can take better advantage of market unpredictability and make smarter, more data-driven decisions, though it does have its drawbacks. AI-based sentiment analysis is volatile and unreliable for long-term investments: just look at what
happened to the share price of GameStop in January 2021, after Reddit investors fuelled the fire. The share price doubled over two days from $4.99 on January 12 to $9.98 on January 14, before shooting up to a high of $120 on January 28 and crashing back down to $10 by February 19. Further fluctuations followed, but on average, the share price has been bumbling along around $20 since then. The other challenge AI-based sentiment analysis has is that it can’t distinguish whether online information is true or false. According to Forbes, 48 percent of all business-related messages contain false or irrelevant information; just because social media is buzzing about something, good or bad, this doesn’t always translate to movement in the stock price.
The uncharted territory of AI in trading There is no doubt that AI is improving the ability to forecast market movements more accurately and trade quicker, but as systems become more advanced, is there a risk of AI being able to anticipate and reshape market behaviour, simulate entire economies, or even generate trading strategies with minimal human input?
Currently, technologies like RL and GenAI are increasingly being used in financial markets. Through RL, algorithms learn optimal behaviour through trial and error, adjusting strategy according to results, thus improving performance over time, while the possibility of using GenAI for risk assessment and strategic planning is also being investigated. Quantum computing has the potential to supercharge current AI capabilities and solve optimisation problems in seconds, opening new windows for predictive modelling and portfolio management. However, it is still at least a decade away from mainstream adoption. This all sounds wonderful, but by automating more and more of the financial decision-making process, will this create smarter markets, or make them more fragile?
With similar AI models trained on overlapping, or even the same, data, there is a distinct possibility that algorithms could amplify price swings, causing more ‘flash crashes’ than any government spending announcements or mini-budgets could make if the algorithms misinterpret signals or react at the same time. Not to mention, the complexity and speed of these systems also make it hard to predict how they will behave under stress. Additionally, there is the ethical dilemma of whether AI should make high-stakes financial decisions without human oversight. When billions of trades are at stake, how do you audit a neural network’s decision path? These are the questions that need answering before travelling past the point of no return as they affect regulatory frameworks, risk management strategies, and even the very definition of understanding the market.
For retail and institutional investors, staying informed and adaptable is more important than ever. Moving forward, it may not be enough to understand technical analysis alone; there will probably be a need to understand algorithm ethics, data bias, and AI governance.
At the end of the day, as much as AI is shaping the financial markets, like every other sector, it is how we choose to use it that will shape the outcomes. But the million-dollar question is: will it ever guarantee to beat the market 100 percent of the time? n THERE
The AI boom is entering a new phase. In 2025, investor focus is shifting from bold promises to measurable profits, putting pressure on tech giants to turn record investments into real returns, says Rosen Traykov, Senior Writer at XMTrading
The summer of 2025 brings a noticeable shift in the financial markets, especially for companies that may have relied too heavily on the now-familiar two-letter acronym – AI. A couple of years ago, investors were buzzing with euphoria around artificial intelligence plays. Just the mention of AI in the earnings call could inflate valuations. This year, investor sentiment has evolved. Capturing investor attention today requires more than hype and ambitious growth projections – it demands solid earnings growth.
The first wave: narrative over numbers
The first wave of AI enthusiasm, spanning 2023 and 2024, was driven by compelling narratives and substantial investment inflows – amounting to hundreds of billions of dollars. Many companies capitalised on the excitement, often without the earnings to justify the momentum. An elite group of seven companies didn’t need blockbuster profits to attract matching inflows.
Their rocketing valuations were driven more by future potential rather than present performance. These seven names – Microsoft, Google parent Alphabet, Tesla, Amazon, Apple, Facebook parent Meta and Nvidia –emerged as the chief architects of the AIfuelled revolution and saw their share prices soar to record highs. Collectively known as the ‘Magnificent Seven,’ they are the tech giants that are in a race to build the infrastructure layer so AI can thrive.
What is the common ground between the first six companies? They are all major customers of Nvidia, apart from Apple, which spends a tiny amount of money on Nvidia hardware. All the rest are buying boatloads of Nvidia chips to train their large language models (LLMs) and fuel their AI capabilities. This is how Nvidia sparked the AI rally – and the gains followed.
Is Nvidia losing investor confidence?
Nvidia’s shares were up 239 percent in 2023 and another 171 percent in 2024. However, despite strong fundamentals, the tech heavyweight has been struggling to gain traction in 2025. At the start of the year, a whopping 114 percent annual revenue increase was not enough to get traders and investors racing to load up on the shares. Nvidia reported $130.5bn in revenue for 2024 (fiscal 2025) –more than double the $60.9bn it posted the previous year.
Investors’ reaction? A few polite claps, some yawns, and just enough buying momentum to keep Nvidia’s shares steady after the February 26 earnings report, which included fiscal 2025 performance. The market’s muted response suggested that even sky-high expectations may have already been priced in. Does this mean investors are becoming less interested in fundamentals and more attached to the idea of stratospheric growth? After all, Nvidia set the bar high in the fourth quarter of 2023, crushing Wall Street’s expectations with an explosive 265 percent year-over-year revenue jump.

THE COMPANIES THAT CAN TURN AI INNOVATION INTO CONSISTENT, LONGTERM PROFITS WILL STAND OUT
As the AI sector evolves, differentiation will be key. Investors are now paying closer attention to fundamentals: sustainable margins, monetisation strategies, and disciplined capital spending. The companies that can turn AI innovation into consistent, longterm profits will stand out. At the same time, others may struggle to justify their elevated valuations in a market that’s increasingly focused on earnings. Before those earnings have a chance to materialise, some spending must take place – and given time to yield results.
Capital expenditures, or capex, refer to the amount of money a company allocates for investment in innovation, upgrades and new assets like hardware or software. In the context of AI, companies usually spend on purchasing high-performance computing hardware and building data centres to support it. Unlike operating expenses, which cover day-to-day costs, capex is focused on projects that are expected to deliver value over years, even decades.
Capex does not always sit well with investors, because these kinds of investments require patience and long-term vision. This is where the market tends to split – between those with the discipline to wait for long-term value and those chasing quick wins.
That is a distinction the market’s biggest players appear to understand well – even if it means being misunderstood by investors. The Magnificent Seven has turned this year into a year of bold investments, showing a solid conviction in the future of artificial intelligence through record levels of capital expenditure.

Microsoft has committed $80bn to expand its data centres and build its AI infrastructure. This daring investment effort is designed to power its Azure cloud platform and its broader enterprise ecosystem. Microsoft’s AI chatbot Copilot is expected to become a mainstay tool for both businesses and consumers aiming to optimise their workflow and daily tasks.
As an early backer of ChatGPT parent OpenAI, in which it holds a 49 percent stake following a bold $13bn bet, Microsoft has positioned itself front and centre in the generative AI space. Close behind is Google’s parent Alphabet, which has earmarked around $75bn for similar initiatives. The commitment reinforces the search giant’s position in AI research and cloud services.
A significant portion of it supports the development of Gemini – Google’s flagship generative AI model and a direct competitor to both ChatGPT and Copilot. Amazon is making the boldest move of all, with capital expenditures exceeding $100bn for 2025. Much of that spending will be funnelled into AI infrastructure for Amazon Web Services (AWS) – the backbone of its enterprise operations and a major driver of its profitability.
Of capital expenditure on AI in 2025 by the biggest firms
THE MAGNIFICENT SEVEN HAS TURNED THIS YEAR INTO A YEAR OF BOLD INVESTMENTS
Similarly, Meta has revised its outlook sharply upwards, committing a totoal of between $60bn and $65bn – a nearly 70 percent increase over prior projections. The lion’s share of that big-ticket spending will go towards building warehouse-size data centres to power the AI products across the company’s apps, which include Facebook, Instagram and WhatsApp.
The rest of the Magnificent Seven group, Apple, Tesla and Nvidia, have not disclosed official capex projections. Still, their forward guidance and spending activity suggests continued, sizable investment in AI and related technologies. For Apple, the focus is on developing AI-enabled iPhones powered by Apple Intelligence, the tech titan’s way of catching up in the AI race. For Tesla, it is the autonomous driving capabilities through Full SelfDriving, the EV maker’s highest-level driver assistance software.
For Nvidia, it is about the continued innovation in GPU and chip manufacturing, with Blackwell as the next big thing that should keep demand growing. These are only some of the ways these tech leaders are positioning themselves for long-term relevance.
Taken together, this wave of capital investment in 2025 – totaling over $300bn among the top players alone – signals more than just an optimistic note. It reflects a fundamental shift in how value will be created in the coming decade.
Despite market volatility, occasional pushbacks from investors, and macroeconomic challenges, these firms are not backing down on their bold investment initiatives. Instead, they are doubling down – investing today for tomorrow’s growth, fully aware that the returns may take time to materialise.
In AI 1.0, markets rewarded guidance and expectations. In AI 2.0, they reward performance. The speculative phase has given way to operational discipline and value creation rooted in the adoption of new technology.
High interest rates, compared to just four years ago, have reintroduced the idea that capital comes at a cost. This has brought a sharp focus on those who hold the upper hand. The big infrastructure players, with their pricing power and established supply chains, are the main winners.
After a couple of years defined by euphoric share-price gains, followed by a breakneck rush to lay out infrastructure, the market is entering a new chapter – one grounded in execution, efficiency, and results. As we look ahead to 2026, three trends are likely to influence the AI earnings cycle.
Firstly, enterprise adoption becomes the real litmus test. Are companies paying for AI at scale? Are workflows evolving in ways that are both meaningful and monetisable? Do consumers need AI daily? These questions will take centre stage.
Secondly, margins will come under pressure. Infrastructure costs are high, and energy prices are rising. Companies with leaner and more efficient models will be better positioned to maintain profitability.
And thirdly, competitive moats will start to matter more. In the early innings of the AI race, ambition and access to capital were enough to keep companies in the game. By 2026, investors will want clear answers: Who owns the data? Who controls distribution? Who has proprietary models, scale advantages, or ecosystem lock-in?
As the space matures, staying power – not just innovation – will separate the frontrunners from the fading hype. n
Once seen purely as entertainment, gaming has evolved into a global economic force – reshaping finance, investment, and digital engagement through virtual economies, innovative monetisation, and gamified business strategies

WORDS BY Maryam Shahvaiz FEATURES WRITER



From the launch of gaming consoles like the Xbox and Playstation to the rise of mobile games and e-sports, gaming has become a significant part of people’s lives. The gaming industry, which includes the development of software, hardware, game development, e-sports and game streaming platforms, is evolving rapidly like any other mainstream industry in the world. Valued at around $300bn, the gaming industry has become a multi-billion-dollar industry, surpassing both the music and movie industry. The year 2024 was tough for many industries, mainly for two reasons: one is global economic instability and the other is the emergence of AI. However, the gaming industry proved resilient. It appears the owners of gaming studios know how to stay in the game. According to Deloitte’s 2024 Report, the gaming industry will reach a value of $485bn by the year 2028. Financial strategy is playing a critical role in the success and growth of top gaming companies. Investors now understand that games are not just made for entertainment but it is a serious business that requires effective investment forecasts, well-planned business strategies and market adaptability. Therefore, game developers and producers across the globe are focusing on financial strategies
that boost revenues without disrupting users’ gaming experience. These strategies are changing the canvas of conventional financial strategies and re-shaping business ideas about investment and long-term planning.
From entertainment to enterprise
Today, gaming companies place emphasis more on operating as a tech company rather than focusing merely on entertainment. Many are either investing in games development or launching their own games. They recognise that the gaming industry is now based on data, engagement and diversified revenue streams. Even Netflix, a well-known entertainment platform, has introduced a separate section for games, while Meta, which owns Facebook, Instagram and WhatsApp, has also launched different VR headset games.
The primary aim of gaming companies has traditionally been to produce games that will stand the test of time and keep gamers coming back again and again, driving a continuous revenue stream over the years. Their monetisation strategies are now considered some of the most innovative in the digital world, as they continue to evolve and explore different revenue channels.
As a result, a conventional one-time purchase by gamers is now an old tale. Modern games earn money through in-app purchases, virtual rewards and optional ad-skipping. Subscription services and in-game video ads have also increased the revenues of video game producers.
Many of today’s games come with vibrant ingame virtual economies. Unlike other companies that follow traditional financial models, gaming companies emphasise diversified revenue streams. Diversification has enabled the gaming companies to shift their risks effectively.
Introduction of virtual assets and virtual currency is a part of that fi nancial strategy. Gamers use virtual currencies to buy virtual items like tools, costumes and power-ups. This motivates players to purchase and sell in-game assets to improve their gaming experience and upgrade their gaming profile.
In many cases gamers spend real money to purchase virtual assets. While these virtual assets hold no real-world value, they can significantly enhance the gaming experience. Some games allow the players to sell their virtual assets, enabling gamers to earn profit from their in-game investments. This shift has removed the difference between digital and physical economies, creating a new economic model now being observed closely by many financial institutions and researchers.
In addition to that, earning from virtual purchases has become a major part of gaming companies’ revenues. This is a marked changed from traditional financial


$485bn
transactions that usually require formal agreements. So on one hand players are playing, socialising and engaging, but also using virtual currency to upgrade their gaming experience. Furthermore, virtual currency in games has also enabled gaming companies to enhance their CSR strategies.
Apart from the birth and exploration of this digital economy, a parallel economy has taken investors by storm. NFTs and the Metaverse are the latest technological developments that are boosting the spread of virtual economies. NFTs allow gamers to own unique virtual assets, enabling them to develop new value chains in games. Moreover, the Metaverse is changing the gaming industry by implementing Virtual Reality (VR) and Augmented Reality (AR) and thus offering players a unique and therefore valuable gaming experience. According to a Statista report, the Metaverse market alone is expected to reach a market volume of $490bn by 2030 (see Fig 1).
There are many companies that are involved in the Metaverse and NFTs, and these NFT-based platforms are created to grab the attention of gamers. A few of the prominent ones include: Axie Infinity, Gods Unchained, The Sandbox, Meta(Facebook), Epic Games and Decentraland. These platforms allow players to invest in virtual assets, trade assets and characters that hold value in the real economy. This creates opportunities for both players and investors.
As the gaming industry turns into a proper economic force, investors and entrepreneurs alike are responding by creating financial instruments like ETFs and experience-driven processes like gamification. However, developing new games and related technologies requires heavy investment and naturally comes with a degree of risk. The success of a new game hinges on its reception upon launch.
Gaming ETFs are quite similar to mutual funds and are spread across a variety of different companies. Some of the famous gaming ETFs are VanEck Video Gaming and eSports ETF (ESPO). When it comes to making financial decisions, ETFs are also easy to invest in because, unlike individual stocks, even a casual investor can evaluate which ETFs are better to invest in.
Additionally, gamification strategy is being adopted by various companies across the globe. Game mechanics are being included in some form within nearly every company’s app. Even the banks and trading apps now include game-like engagement features. The reason behind introducing these features is that it makes the whole process, that which was previously considered tedious, more fun and interesting. Gamification also helps new investors to understand stocks and investments. Apps like Robinhood offer simple features and rewards to assist users trading stocks, which is again quite similar to games rewarding gamers for levelling up.
Beyond finance, this strategy is adopted by food delivery services, online shopping apps and fitness apps. These apps offer a certain level of gaming experience. Even Temu, the popularity of which has skyrocketed, now offers in-app games to improve engagement and spending. The aim of this strategy is to engage their consumers to stick to their apps for a longer time because the longer the stay, the more likely they are to spend.
Apart from the gaming industry’s monetisation strategies, their social media strategy is also different from other industries. For gaming studios, this shift has changed the conventional gaming formats and given rise to social gaming platforms. Social platforms such as Discord and Steam have provided gaming companies a path to showcase their social media presence in a whole different way. It has transformed gaming into more of a social experience. Many online games like PUBG, Call of Duty and DOTA are not just focusing on games but also on building a gamer community. So for gamers, the game becomes not the only attraction; they also go to the platform to interact, share experiences and connect.
Now this is a paradigm shift for gaming studios because it enables them to not only promote their games but also increase players’ engagement, something previously unheard of in the first days of games consoles.
Today, some gamers do not see games as purely a hobby. For them it can also be a business opportunity and a potential way to earn a living. Developers are earning money by selling their games and in-game items, while players are monetising their skills by live streaming their video games on platforms like Twitch and YouTube. Both platforms allow a wide range of monetisation options, including subscriptions, Bits, live stream ad revenue and affiliate marketing. Through these avenues, the gaming industry is influencing individuals to act as digital entrepreneurs. It teaches players how to invest, save, exchange and develop items that can earn them money.
Gaming isn’t just changing entertainment; it is transforming mindsets about finance, investment and digital economies. The gaming industry has in fact helped to reshape financial strategy by incorporating a perfect combination of user engagement, innovation and technology.
From virtual currencies and NFTs to ETFs, and to the gamification of finance, the impact of the gaming industry has branched out to both players and investors. It has allowed players to become digital pioneers, investors and entrepreneurs, all while indulging in their favourite hobby.
Because of these developments, the financial strategies pioneered by the gaming industry are likely to become a blueprint for the next generation’s business models. As gaming continues to influence each and every industry, one thing is certain. The future of business will be more interactive, engaging and play-driven.
Online trading is undergoing a transformation, driven by technology, accessibility, and education. As platforms evolve, a new era is emerging – one where innovation empowers traders of every experience level
Hisham Mansour
CO-FOUNDER & MANAGING DIRECTOR, CFI FINANCIAL GROUP








CFI Financial Group is a leading global online trading provider that has been empowering traders for more than 25 years. Co-Founder and Managing Director Hisham Mansour spoke to World Finance about the group’s ambitions to redefine trading, promote financial literacy and stand out in a crowded marketplace.
What is CFI’s overarching vision for the future of trading and how does your mission shape the way you operate day to day?
At CFI, our vision is to redefine the future of trading by making financial markets accessible, intuitive and empowering for everyone, whether you are just starting out or an experienced professional. We are committed to breaking down the barriers that typically limit access to these markets, providing the most advanced yet user-friendly tools and resources to ensure all traders and investors can make informed and confident decisions. Our goal is not just to meet industry standards but to set new ones by continuously innovating to enhance the trading experience for all.
How does CFI differentiate itself in a crowded trading platform market? What makes you stand out to both new and seasoned investors?
CFI stands out from the crowd by combining cutting-edge technology and platforms, a strong focus on financial education and strategic global partnerships. Our platforms cater to all traders, offering advanced tools, commission-free, zero-pip spreads and ultrafast execution. We are committed to promoting financial literacy, offering structured programmes such as multilingual webinars and in-person seminars designed to help traders make informed decisions.

sible to all, starting with fair execution, transparent conditions and a comprehensive range of products. We ensure that anyone interested in exploring trading can do so with confidence and without barriers.
To support both beginners and experienced traders, we have designed our platform to provide access to a variety of markets, including forex, stocks, energies, metals, indices, ETFs, futures and options. This diversity of financial instruments allows traders to choose the markets and strategies that best suit their needs and risk profiles.
How do you personalise the services you offer to clients?
One of the key ways we personalise our services is through our proprietary Kaiana AI, which analyses individual trading behaviours and market data to provide personalised insights, recommendations and real-time support. This AI-driven approach ensures that traders receive guidance that is specifically relevant to their strategies and risk profiles.
Additionally, our platform offers customisable features, such as personalised alerts, dashboards and trading preferences, allowing clients to tailor their experience to their unique
tance, ensuring that clients feel supported at every stage of their trading journey.
How do you use technology on your platform to cater to both novice and professional traders?
Alongside Kaiana AI, we have a platform suite, including the CFI Trading App, CFI Webtrader, MT4, MT5, C-Trader and CFI MultiAsset, which was designed with both new and experienced traders in mind. Tools like TradingView and Hoko Cloud provide advanced charting, real-time data and analytics to further elevate the user experience. For those looking to automate their strategies, Capitalize.ai makes automation accessible without needing coding skills.
By continuously investing in technology, CFI is able to offer traders smarter, more intuitive tools that streamline decision-making, improve strategy execution and provide personalised insights – making the trading experience both powerful and user-friendly for all.
“We aim to create a platform that is intuitive, responsive and easy to navigate”

At CFI, we believe financial literacy is the cornerstone of empowering traders to make informed decisions. To help traders of all experience levels build their knowledge, we offer a wide range of resources, including multilingual webinars, foundational and advanced online courses and an extensive library of articles, blogs and explainer videos. These materials cover everything from basic principles to advanced trading strategies, enabling traders to learn at their own pace.
We also host in-person seminars worldwide that offer interactive learning, personalised guidance and valuable networking opportunities. For a hands-on experience, our CFI Demo account lets traders practise in a risk-free environment before diving into live markets. To further support informed decision-making, we provide access to premium research tools like Trading Central and TIPranks, along with daily market insights and reports on social media. All these resources are available in multiple languages, ensuring accessibility for a global audience.
CFI has aligned with world-class names including Brand Ambassador Lewis Hamilton. What do these partnerships say about the brand and how do they reflect your values?
CFI’s partnerships with AC Milan (Global Partner), Lewis Hamilton (Global Brand Ambassador), FIBA WASL and the Department of Culture and Tourism – Abu Dhabi reflect our commitment to excellence, innovation and global connectivity. These collaborations showcase our belief in the power of success, drawing inspiration from these top-tier organisations and offering our traders the opportunity to engage with globally trusted brands.
We also prioritise diversity and inclusion through these partnerships, engaging local communities and empowering individuals to succeed. These alliances create unique experiences for our traders, such as CFI Rewards, meet and greets and exclusive panel discussions with global icons, offering unforgettable opportunities to connect with champions from various fields. By aligning with these renowned leaders, CFI strengthens its commitment to world-class standards, while building a community where success, inspiration and collaboration thrive.
How important is user experience in the design and development of your platform and how do you gather feedback to continuously improve?
User experience is a top priority at CFI. We aim to create a platform that is intuitive, responsive and easy to navigate, ensuring traders at all levels can make informed decisions with ease. Our design focuses on accessibility, real-time decision-making and customisation to meet each user’s unique needs.
To continuously improve, we gather feedback through client surveys, in-app tools, customer support interactions and by analysing user behaviour. This feedback loop helps us make data-driven updates and ensure the platform evolves with the needs of our users. We also use analytics and heatmaps to monitor user interaction across the platform, allowing us to pinpoint areas of friction and opportunities for improvement. Ultimately, our goal is to deliver an empowering trading experience that supports long-term success for every client.
In what ways has CFI adapted to the rise of mobile trading and the changing expectations of a digital-first generation of investors?
CFI has embraced mobile trading by prioritising a seamless, mobile-optimised experience for all traders. We have developed and enhanced the CFI Trading App to ensure that users can trade and manage their investments easily on the go. The app features intuitive design, real-time updates and robust functionality, allowing traders to execute trades, monitor markets and access educational resources anytime, anywhere.
We also recognise the importance of speed and convenience, so we have focused on streamlining processes for mobile users, ensuring fast execution, personalised alerts and access to advanced tools, all from a mobile device. In addition, we have integrated features like in-app learning, AI-driven insights through Kaiana and easy access to research, all tailored for mobile use.
How do you ensure security and data protection across your digital platforms, especially in an era of heightened cyber threats?
At CFI, cybersecurity and data protection are foundational to our operations. We deploy a comprehensive, multi-layered security framework designed to safeguard client data and ensure the integrity of our platforms at all times. Our systems are regularly audited and tested by external experts to ensure compliance with international data protection standards. We also invest in employee training and robust governance protocols to reduce risk across all levels of the organisation, creating a secure trading environment where clients can operate with complete confidence.
Finally, what is next for CFI? What are your strategic priorities for this year and beyond and where are you seeing future opportunities for the business?
In 2025, CFI will focus on sustaining growth through a clear vision and focused execution. Our top priority is strategic expansion, both regionally and globally. We plan to strengthen our presence in established markets while actively entering new, high-potential regions. This includes launching in key financial hubs, deepening regulatory footprints and acquiring or building local entities where this aligns with our long-term vision.
We will continue to enhance our technology, particularly Kaiana AI, to provide personalised insights and support. Our CFI Trading App will also receive new features to improve accessibility and real-time decision-making for all traders. Additionally, we are expanding asset classes, including boosting our cryptocurrency offerings and broadening access to diversified multi-asset portfolios.
Our approach to growth is anchored in a people-first mindset, whether it is with our clients, our team, or the wider communities we serve. We are dedicated to fostering longterm value by prioritising inclusion, continuous learning and a steadfast commitment to consistency.
As we move forward, our ambition is not only to grow, but to lead responsibly, building a trading ecosystem that is innovative, inclusive and sustainable. n

One firm is revolutionising online trading with advanced technology, diverse instruments and innovative features that empower traders of all levels to succeed in global markets, writes XTrend Speed
In the fast-paced world of online trading, XTrend Speed has emerged as a powerful and innovative platform that caters to both novice and experienced traders. With its advanced technology, user-friendly features, and extensive range of trading instruments, XTrend Speed has positioned itself as a toptier platform that provides users with unparalleled opportunities in the financial markets. Whether a trader is looking for a diverse selection of assets, cutting-edge trading tools, or a rewarding community-driven environment, this platform delivers a seamless and engaging experience that ensures success for all types of investors.
XTrend Speed offers an extensive selection of over 600 trading instruments, including stocks, forex, commodities and indices. This diverse range allows traders to build well-balanced and diversified portfolios while taking advantage of opportunities in multiple global markets.
Real-time market data and analysis tools further enhance the trading experience, ensuring that users can make informed decisions backed by the latest financial insights. Whether traders are looking to invest in major tech stocks, trade currency pairs, or explore commodities like gold and oil, XTrend Speed provides all the necessary resources to navigate the markets effectively.
One of the platform’s standout features is its copy trading function, which has revolutionised the way people engage with financial markets. Copy trading allows beginner traders to replicate the strategies of experienced professionals in real-time, eliminating the steep learning curve that often comes with trading. This means that even those with little to no experience can potentially earn profits by following successful traders. Meanwhile, experienced traders who act as ‘copy trading masters’ can monetise their expertise by earning commissions whenever other users
copy their trades. This creates a mutually beneficial ecosystem where knowledge is shared, and both new and veteran traders can thrive together.
In addition to its robust trading tools, XTrend Speed continuously seeks to improve user engagement and education through its live stream feature. This interactive function offers real-time market updates, expert insights, and in-depth trading strategies presented by financial professionals. Through live streaming sessions, traders can stay informed about market trends, learn new techniques and gain valuable perspectives from experienced investors. Whether it is a technical analysis breakdown, a macroeconomic discussion, or an in-depth tutorial on trading strategies, the live stream feature ensures that users have access to top-tier educational content.
Another key component of XTrend Speed’s ecosystem is its credit system, which enhances trading flexibility by providing users with additional funds. This system allows traders to access more capital, helping them seize market opportunities without requir-

THROUGH LIVE STREAMING SESSIONS, TRADERS CAN STAY INFORMED ABOUT MARKET TRENDS
ing a large initial deposit. The credit system is particularly beneficial for those looking to test new strategies, explore different trading instruments, or maximise their trading potential. By offering this feature, XTrend Speed ensures that traders can take full advantage of market movements while managing their risk effectively.
For those looking to take their involvement in the financial markets to the next level, XTrend Speed offers an introducing broker (IB) programme, which allows individuals and businesses to earn commissions by referring clients to the platform. This programme is ideal for financial influencers, professional traders and business owners who want to leverage their network and help others discover the benefits of trading on XTrend Speed. Participants in the IB programme earn commissions based on the trading volume of their referrals, creating a lucrative opportunity for those who wish to build a sustainable income stream. With a transparent commission structure and dedicated support, the IB programme is a perfect avenue for those looking to expand
600
Trading instruments offered by XTrend Speed
EVEN THOSE WITH LITTLE TO NO EXPERIENCE CAN POTENTIALLY EARN PROFITS BY FOLLOWING SUCCESSFUL TRADERS
their financial horizons. Beyond its innovative features and user-centric initiatives, XTrend Speed has also made significant strides in the global financial industry through strategic sponsorships. The platform proudly sponsors ACF Fiorentina, one of Italy’s most renowned football clubs, as well as the Argentine Football Association (AFA), the governing body of Argentina’s national football teams. These sponsorships reflect the platform’s commitment to excellence and its mission to build strong connections with a diverse audience worldwide. By partnering with prestigious sports organisations, XTrend Speed continues to enhance its brand visibility while supporting the spirit of competition and success.
XTrend Speed’s dedication to innovation and excellence has earned it industry recognition, with the platform recently winning the ‘Best Copy Trading Platform Global 2025’ award from World Business Outlook. This prestigious accolade reaffirms XTrend Speed’s position as a market leader and highlights its commitment to providing a superior trading experience. The recognition serves as a testament to the platform’s cutting-edge technology, user-focused initiatives and continuous efforts to improve the trading environment for its global user base. As XTrend Speed continues to evolve, it remains focused on delivering top-quality services, expanding its product offerings, and creating opportunities for traders of all levels. Whether it is through the copy trading feature, a diverse selection of trading instruments, live market analysis, or innovative campaigns, XTrend Speed is setting new standards in the world of online trading. With a vision centred on accessibility, education and growth, the platform continues to empower traders worldwide, making financial markets more inclusive and rewarding for everyone. n
With food prices soaring and farmers’ incomes shrinking, Europe’s food supply chain is under mounting pressure. A fairer, more sustainable system – rooted in reforms like three-party contracts –offers a path forward for producers and consumers alike
WORDS BY
Elmar Hannen
FORMER VICE PRESIDENT, EUROPEAN MILK BOARD
with retailers, all three parties agree in advance on suitable partners and enter into long-term agreements – typically lasting three to five years – with clearly defined pricing structures.







Food prices have surged in recent years across the European Union. In March 2023, foodprice inflation hit a record high of 15 percent. In Germany, consumers are paying nearly 30 percent more for food than they did in 2021, even though energy and production costs have declined. Some economists have attributed this to food processors and retailers reaping windfall profits at the expense of low-income households. Meanwhile, the share of retail food prices reaching farmers keeps shrinking. German producers, for example, received just 21.7 percent of retail prices in 2021, and this figure continues to decline. The fall in farmers’ share of bread prices is a striking example: in 1970, farmers earned 19.2 percent of the shelf price; by 2022, that share had plummeted to five percent.
Milk producers face similar challenges. Between 2014 and 2024, milk prices consistently failed to cover rising production costs. As a result, many farms operate at a loss and depend on subsidies to survive. Farmers are expected to produce high-quality food while also providing – often under burdensome bureaucratic requirements – environmental, climate and animal protection. But as value creation shifts away from producers, profits are increasingly concentrated among a few powerful processors and retailers.
The widespread farmers’ protests of early 2024 revealed deep-rooted frustration across the EU’s agriculture sector. The political response was underwhelming. Meanwhile, the core issue – ensuring fair prices along the value chain – has not been sufficiently addressed.
Fixing Europe’s broken food supply chain will require more than cosmetic changes. Prices must be set from the bottom up, which implies four key reforms, starting with the enforcement of contractual obligations. Dairy farmers, in particular, often deliver their products without knowing the price – an arrangement that would be unthinkable in most other
sectors. EU law already provides leeway for reform, as seen in France and Spain, where binding written contracts are mandatory. Spain even prohibits sales below production costs. In Germany, however, attempts to introduce similar measures have been blocked by the agricultural lobby and its conservative and liberal allies.
Second, contractual obligations must extend to farming co-operatives. Although founded on progressive principles, many of these co-operatives now operate like conventional large corporations, prioritising the lowest possible purchase prices over the interests of milk producers. Yet in countries like
Such three-party contracts contain clauses mandating quarterly reviews to adjust for market and cost fluctuations. Beyond pricing, they address product layout, marketing strategies, and standards for animal welfare and environmental sustainability. By fostering a sense of shared responsibility, these agreements promote quality improvements and fair compensation. They also help shield producers and consumers from market volatility, create added value throughout the supply chain, and offer a foundation for best practices that can be scaled both nationally and regionally.
Given that European agriculture can remain viable only if farmers are able to cover their costs, the European Milk Board sees three-party contracts as an important step toward a fairer and more sustainable market structure. These agreements could provide

Third, the rights of producer organisations must be strengthened. While dairy giants like Arla and DMK would control up to 13 percent of the EU’s milk volume following their planned merger, current EU rules cap the market share of farmer-led producer organisations at just four percent. Despite years of intensive discussions, this imbalance persists, hindering fair negotiations.
Lastly, EU policymakers must curb market concentration in food retail. In Germany, just four retailers control 85 percent of the food market. The food processing sector is also highly concentrated. A 2024 report by the German Monopolies Commission warned that rising market concentration is harming both producers and consumers.
Amid these challenges, promising models are beginning to emerge. One example is Germany’s recently piloted three-party contract, which is based on the French model. Instead of producers blindly delivering products to processors, who then sign separate contracts
FIXING EUROPE’S BROKEN FOOD SUPPLY CHAIN WILL REQUIRE MORE THAN COSMETIC CHANGES
income stability and planning security, benefiting all stakeholders: farmers, processors, and consumers, who currently overpay for low-cost, mass-produced food.
Fair pricing would also enhance Europe’s resilience to crises, war, and climate change. Today’s artificially low prices are made possible by the overexploitation of natural resources – both in Europe and globally – alongside poor animal welfare, precarious migrant labour, and the relentless financial pressure placed on farmers. With many EU farmers facing crushing debt and rising input costs, it is no surprise that under 12 percent are under the age of 40. If Europe wants to feed itself in the future, it must make farming economically and ecologically sustainable – not by increasing subsidies, but by establishing fair market conditions and introducing robust sustainability standards. Market-based solutions like three-party contracts show that positive change is possible, so long as Europe stays the course. n

Volkswagen reported a sharp 30.6 percent drop in profits for the first quarter of 2025, driven by rising costs and weaker sales in the Chinese market — historically the company’s largest and most profitable region. While global deliveries fell by 7.4 percent year-
on-year, the China market posted a steeper 21.3 percent decline amid increased competition from domestic electric vehicle (EV) brands and shifting consumer preferences. Rising raw material and logistics costs, up 12.7 percent from a year earlier, added further
pressure to margins. Despite these challenges, Volkswagen retained a global market share of 6.1 percent, down slightly from 6.5 percent in Q1 2024. The company is expected to unveil an updated EV strategy for Asia-Pacific markets later this year.
Volkswagen’s net profit fell by 30.6% year-on-year in 2025 Q1
Sales in China declined by 21.3%, marking the steepest drop since 2018
Raw material and logistics costs rose by 12.7% compared to Q1 2024
The company maintained a global market share of 6.1%
Volkswagen delivered 2.15 million vehicles globally in Q1 2025
In a fast-evolving world, innovation is key to growth – especially in building materials. TITAN Group explains how it is using advanced materials, technology and AI to grow, while creating value for all its stakeholders and reducing its carbon footprint
WORDS BY
Marcel Cobuz CEO, TITAN GROUP


Today’s world is changing at an unprecedented pace. Driven by urbanisation and population growth, demand for affordable housing and resilient cities and infrastructure is increasing. The advances in data and connectivity, analytics and human-machine interaction are disrupting every sector in every part of the world. Climate change and resource scarcity call for a transition to durable and sustainable solutions. With the innovation drive in the US and in Europe with the new Industrial EU Green Deal, the building materials’ sector is changing fast across its value chain, requiring new technologies and investments in AI and in building new capabilities.
Against this backdrop, businesses like TITAN – a global leader in the building materials industry – cannot merely react and adapt. They need to anticipate, lead and act. And that is exactly what TITAN is doing through innovation, digitalisation and new investments. We are transforming our materials and product range across more than 25 countries to address evolving customer needs, tackle modern construction challenges and help build faster,

durable and resilient cities. Challenges and ambitious goals don’t daunt us; they energise us, and our purpose – making the world around us a safe, sustainable and enjoyable place to live – is deeply embedded in everything we do.
We are fully aware of our responsibility to meet the increasing performance needs of our customers and at the same time we are committed to lower the carbon footprint of our materials and operations, with the target of keeping global warming under 1.5°C. To rise to the challenge, we are implementing a comprehensive growth and sustainability strategy, targeted at achieving net-zero greenhouse gas emissions across our entire value chain by 2050. We have set additional near-term targets for 2026; these include doubling our innovative low-carbon product portfolio, so that it will account for at least 40 percent of our total portfolio, by integrating more alternative cementitious materials; reducing specific, net-direct carbon emissions to below 550kg per tonne of cementitious product; and more than doubling our use of low-carbon alternative fuels and renewable electricity. The relevant roadmap of actions is already in motion, backed by over 100 value-adding initiatives and growth investments across all our geographies and value chain.
We are active on multiple fronts: In 2023, our teams launched the development of a pioneering carbon capture project in Greece, near Athens, which is partly financed by the EU Innovation Fund. The project is designed to capture 20 percent of the group’s carbon emissions and enable the production of more than three million tonnes of innovative zerocarbon cement for future concrete construction across Europe.
Meanwhile, at our plant in Roanoke, Virginia, we are developing a first-of-its-kind calcined clay production line that expected to offer our customers an innovative alternative material with superior performance, while reducing carbon emissions by up to 50 percent. This is partly financed by an award from the US Department of Energy.
INNOVATION IS ALSO
In addition, we are making significant investments to support the introduction of alternative cementitious materials to our markets. After activating partnerships in pozzolanic natural materials in Greece and Turkey, in slag waste from the steel industry in Indonesia, as well as in clay in the US earlier this year, we launched new joint ventures, this time focused on fly ash in India and the UK.

Last year, we launched TITAN Edge, our family of innovative, high-performance, lowcarbon cementitious products. These include limestone-based and pozzolanic cements, which can replace a large part of clinker in traditional cement, further helping to reduce carbon emissions. New innovative products like VELTER concrete, introduced in Greece, also demonstrate how we are advancing performance in superior low-carbon construction.
These innovations are already being used. Current iconic projects we are providing materials for include Ellinikon – the largest urban regeneration project in Europe, set to be built on the site of Athens’ former airport. It will comprise a series of low-carbon, energy-efficient buildings, including Greece’s tallest skyscraper, alongside a huge park, new coastal waterfront area, as well as resilient infrastructure. We are also supplying innovative low-carbon, high-durability concrete to next-generation data centres in Virginia, and to new construction projects in Florida that demand stringent standards.
Our responsible growth strategy is bearing fruit. We made considerable progress in reducing our carbon footprint in 2024, cutting carbon emissions to less than 600kg per tonne of cementitious product. We achieved this through a record 21 percent use of lowcarbon alternative fuels and through the

€2.64bn
Record sales in 2024
€315m
Net profit in 2024
integration of over two million tonnes of cementitious and alternative materials in our supply chain. Our innovative cementitious products accounted for almost 30 percent of our production volumes.
Our efforts to date have earned the loyalty of our customers and partners and global recognition; in 2024, the Financial Times named us one of Europe’s Climate Leaders, and we were awarded Leadership Status on climate change by the CDP (formerly the Carbon Disclosure Project) for the fourth consecutive year. The same year, the FTSE4Good Index Series also acknowledged our performance.
Digital innovation is also a key driver of TITAN’s success and growth, and we are accelerating our efforts in this space. To this end, in 2024 we continued our investments in research and innovation and significantly advanced our Venture Capital initiative, launched in 2023. We are planning to invest up to €40m in relevant start-ups over a threeyear period, targeting ventures that can create business value and advance innovation with and for our customers and stakeholders.
Our first four investments focused on coastal protection materials and solutions, next-generation cementitious materials and energy storage technologies. We also invested in a global, early-stage VC fund focused on innovative sustainable construction in the built environment. More recently, we made three new investments in companies working on artificial intelligence, waste upcycling, and
and ClimateTech. We also invested in a leading venture capital firm focused on technology for the real estate industry.
These collaborations underscore our commitment to supporting innovative technologies and start-ups that have the potential to enhance the competitiveness of our industry, address challenges in the building materials sector and promote innovative and sustainable construction. At the same time, they are designed to enhance our exposure to disruptive technologies and bolster our growth strategy through innovative products, services and materials.
The industry’s digital transformation
We are also investing heavily in our own technology, and embracing digitalisation to support our growth goals, boost our overall efficiency and enhance the experience of our customers through value-added services. Driven by our deep-rooted, entrepreneurial spirit, TITAN was among the first companies in the global cement industry to explore and leverage the opportunities and advantages created by digital technology and AI. We started early – back in 2017 – and have since conceived, designed and implemented numerous digital technologies and solutions.
Digitalisation is now one of our key strategic priorities. We envisage a fully digitalised, customer-oriented, and flexible operating model by 2026. We have implemented digital innovations across all our plants and in many of our processes. Leveraging digital technologies, we are optimising our manufacturing operations and supply chain, while increasing productivity, enhancing reliability of our assets, improving energy efficiency, reducing building costs, boosting circularity and enhancing customer service.
Data management is a key focus for digitalisation. Using thousands of specially designed sensors embedded in our cement plants and our logistics infrastructure, we collect vast amounts of data generated during the manufacturing process and develop artificial intelligence models that optimise plant and supplychain operations.
Among these are AI-based, autonomous real-time optimisers, pioneering in the cement industry, which have now been installed in two thirds of our equipment. Benefits include boosting productivity by over 10 percent, improving product quality and helping us reduce energy consumption and carbon emissions (over 40,000 tonnes of CO2 emissions prevented in less than two years) – with minimal investments.
Our predictive and prescriptive maintenance solution, which detects issues and prevents failures, is now live at all our plants, increasing reliability and maximising operational efficiency. As a result, we have avoided over 20,000 hours of potential manufacturing downtime in recent years.
Among other initiatives, we have also developed a Dynamic Logistics solution to harness the power of data and optimise the distribution of ready-mix concrete – from order placement to scheduling and dispatch. This solution is now used across most of our US operations, resulting in substantial increase in productivity and improvement in customer service through live notifications.
We have also launched pilot tests aimed at automating the extraction and processing of raw materials, and at predicting cement quality months before the product is applied on the construction site. Six of our plants are now fully digitalised, leveraging solutions for both manufacturing optimisation in real time and predictive maintenance.
It’s not only within our own business that we are making waves, though. We believe knowledge and innovation grow when shared, so in 2022, we made the decision to establish CemAI in the US – a spin-off that offers other companies next-generation solutions for predictive plant maintenance and real-time optimisation of manufacturing process.

Under CemAI, our solutions are now avail able to the entire global building materials industry, allowing others to optimise processes and ensure issues are resolved before they affect a plant’s operation. Our objective is to contribute to a broader ecosystem of digital innovation – and one of our most exciting ventures in this space is the TITAN Digital Accelerator. Launched in collaboration with the Centre for Research & Technology Hellas (CERTH) and the International Hellenic University in Greece, this initiative aims at developing cutting-edge digital tools that will revolutionise the building materials industry, benefiting both TITAN and the wider industrial ecosystem. We are currently developing innovative robotic and GenAI solutions for cement manufacturing, leveraging the infrastructure and partnerships of the Digital Accelerator.
Beyond this, we have also established Innovation Hubs in the US and other locations to further promote joint value-creation processes, developing partnerships with customers, scientists and the wider start-up ecosystem.
At TITAN, everything is about people. So is innovation of any kind, which we leverage for the growth, enablement and empowerment of our people. We believe the real value of technology comes from what people do with it. We want
employees to be able to focus on high-value tasks that call for strategic thinking, creativity, intuition and emotion, while technology boosts efficiency on simpler tasks.
And we want to ensure nobody gets left behind. To that end, last year we launched a learning tool to help our employees assess and elevate their digital skills; all 6,000 TITAN employees will soon be able to become certified digital enthusiasts, ready for the next phase of the industrial-meets-digital transformation.
Through a broad range of other learning programmes and initiatives – tailored to address the differing needs of employees from diverse backgrounds and roles – our aim is to support employees to leverage digital technologies, making sure their skills keep apace with the rate of transformation underway. We will also offer ongoing training around the benefits, uses and limitations of AI to ensure its optimal use.
It is not just AI skills that we want our employees to develop, of course; our vision is to foster a broader entrepreneurial mindset that helps lead growth in the business. We believe everyone can innovate, as long as they have the tools, motivation and support. With that in mind, in 2023 we introduced ‘Ideation Challenge’ – an internal ideas competition that promotes, encourages and rewards innovation among our employees, regardless of their role, position or level.


OUR VISION IS TO FOSTER A BROADER ENTREPRENEURIAL MINDSET THAT HELPS LEAD GROWTH IN THE BUSINESS
The response to this was impressive; the first challenge saw more than 220 ideas submitted. Our second Ideation Challenge, launched in 2024, saw nearly 10 percent of our people participate, covering all areas of innovation – from manufacturing, products and services to brand awareness, the customer experience, workplace environment and beyond. It’s another way to embrace innovation across the organisation, while empowering employees to have a genuine impact.
But our focus on employee development goes beyond technology and innovation. We believe people are the cornerstone of our longterm success, and continuous learning in every area is a vital part of our approach. In recent years, we have accelerated the rollout of innovative and increasingly personalised learning tools across our business. These programmes are designed to develop technical expertise, strengthen leadership behaviours and foster a mindset of curiosity and accountability. We want to attract top-tier talent and ensure continuous development opportunities for every employee.
To help achieve this, last year we launched the TITAN Leadership Model, a framework designed to support leadership growth across every level of the organisation. This reflects our belief that everyone should have the op-
portunity to lead, grow and leave their mark. By investing in people, we want to unlock their full potential and strengthen the foundations of our business for the long term.
This focus on people isn’t limited to employees; it also translates into working with local communities around our operations. Ensuring we make a meaningful and sustainable contribution to all our stakeholders is an integral part of our history, and it’s still a key commitment today.
We conduct local assessments to help us understand the issues that matter most to each community and contribute resources to help build solid foundations. These efforts focus on the environment, health and safety, employability, entrepreneurship, social inclusion, education and poverty reduction, with a particular focus on helping young people to develop their professional skills. In 2024, we offered 365 internships in different regions across the world.
Key examples of value-creating initiatives include our partnership with ReGeneration, the largest paid placement, professional and personal development programme in Greece; the launch of various programmes promoting the development of digital skills; and initiatives in the US designed to provide young women with the skills needed to work in the industry in the future; and programs in Brazil introducing young minds to the world of robotics.
Financial results show our efforts are paying off. Last year, we achieved record sales of €2.64bn as net profit reached €315m, and earnings per share exceeded €4.20 (on a likefor-like basis). These achievements were driven by higher performance across all prod-
uct lines, pricing performance and enhanced operational and cost efficiencies.
In another key milestone, our US business, Titan America, was also successfully listed on the New York Stock Exchange – a bold step that underscores our commitment to unlocking value and expanding our reach. We expect a further improved financial performance in 2025. The need for construction materials and solutions remains robust for the long term, as urbanisation and population growth drive demand for housing and infrastructure.
There are challenges to face, however. Energy prices remain volatile, calling for greater efficiency and innovation. At the same time, housing deficits are pressing – especially in the social sector. We have the tools and technology needed to help meet demand, but we need to move faster. Building performance requirements, such as circularity, insulation and energy efficiency, are also growing fast.
Amid heightened uncertainty, TITAN remains focused on what it does best. We are proud to have built a culture of collaboration, bold thinking and continuous improvement everywhere we operate – and we believe innovation, digitalisation, AI and technology can help us and the wider industry meet performance and environmental goals.
How industries across the board fare remains to be seen. But whether through innovative sustainable solutions, advanced digitalisation or strategic expansion, we remain committed to growing and shaping a better, more sustainable world – and we are excited to help forge a path into the future, both within our sector and beyond it.
All this, while sticking to our values: At TITAN we care, we dare, we build to last, and we walk the talk. These have always been and will remain our guiding principles. n
As tensions between China and the US escalate during Trump’s second term, global investors are turning to India – not just as a backup, but as a rising star poised to lead the next wave of growth
WORDS BY
Antonia Di Lorenzo FEATURES WRITER



With the US doubling down on economic nationalism during President Trump’s second term, multinational corporations are accelerating their ‘China-plus-one’ strategies – and increasingly, that ‘plus-one’ is India. With its tech-savvy workforce, swelling middle class, and pro-business policy incentives, India is fast becoming more than a hedge against China: it is emerging as a standalone growth story. The shifting geopolitical winds, coupled with India’s demographic advantage, are redirecting global capital – and few relationships matter more in this transition than the one between Washington and New Delhi.
According to research by the German financial services multinational Allianz, India’s talent pool and demographic advantages, coupled with lower unit labour costs relative to its Asian neighbours, make it an attractive choice for re-shoring operations. Moreover, economic reforms and initiatives by the government to revitalise the manufacturing sector such as the Production Linked Incentive – a scheme that incentivises firms to increase domestic production – will be contributing factors for multinational firms to choose India to be China’s plus one. The share of high and medium skill-intensive manufacturing sectors out of the total was 64 percent in India in 2022, and grew by five percent from 2016, outpacing China, Malaysia, Indonesia, Thailand and Vietnam in terms of growth. Through knowledge spillovers, efficiency gains and innovation, high and medium skill-intensive manufacturers can further accelerate the manufacturing sector in India.
“India offers what investors seek in the post-globalisation world: scale, stability and strategic alignment with the West,” says Fei Chen, CEO of Intellectia AI, an AI-native investment platform based in Hong Kong. “The macro story is increasingly hard to ignore.”
global growth. The sectors attracting capital reflect not only India’s strategic ambitions but also investors’ desire for long-term scalability and resilience. Semiconductors sit at the heart of this ambition. India’s $10bn semiconductor mission is luring global chipmakers like Micron, AMD and Tower Semiconductor to set up shop with generous subsidies, land grants, and infrastructure support. Electric vehicles (EVs) and renewables are another fast-rising
ceutical ingredients. India, once known as the ‘pharmacy of the world,’ is seeing renewed investment in healthcare R&D and production. Meanwhile, digital infrastructure and tech services remain a perennial draw. Global hyperscalers – Google, Amazon and Microsoft – are expanding data centres, AI labs and cloud investments. India’s robust SaaS ecosystem and deep engineering talent pool are helping position it as a global hub for

Walmart) and Meesho, as well as global companies like Amazon and Rakuten.
India’s information technology (IT) industry, valued at around $250bn, already serves many of the world’s leading companies, and its market for AI services is growing rapidly. Moreover, India has an abundance of IT talent, and given the shortage of AI talent globally, this wealth of expertise could be a significant competitive advantage in a market for AI services that
Further, major Indian companies are diving in. For example, Reliance Industries has launched AI initiatives in highpotential sectors such as energy and telecommunications, and Tata Consultancy Services has announced a $1.5bn investment in its Generative AI project pipeline.
While the macro story is compelling, the micro often frustrates. India’s bureaucratic hurdles, regulatory unpredictability, and fragmented federal system can slow even the best-laid business plans. Despite years of reforms, state-by-state inconsistencies in labour laws, tax policy and infrastructure quality persist. “There is a tendency to weaponise regulations retroactively,” warns Schulman. “Global tech firms have had to navigate everything from sudden data localisation mandates to retrospective tax disputes. That unpredict-
India’s geopolitical positioning, while generally favourable, is also complex. Its strategic alignment with the US coexists uneasily with longstanding relationships with Russia and Iran – and a tense, if economically inter-
That said, the broader economic indicators are actually quite promising. Inflation is cooling (projected at four percent in FY2026), the fiscal deficit is narrowing (down to 4.4 percent), and the current account deficit remains modest at 1.1 percent. India’s exports hit a record $820bn in FY2025, and its dependence on exports (only 22 percent of GDP) makes it relatively resilient to global trade shocks. “The fundamentals are solid,” says King. “What investors need is patience and precision – it’s a long game.”
Fei Chen argues that the India pivot is no longer just about derisking from China – it is about embracing India as a standalone growth story. “Investors aren’t expecting frictionless returns,” he says. “They are betting that India’s digital momentum, demographic edge, and policy frameworks will pay off over the next decade.”
ONCE SEEN AS JUST A BACKUP TO CHINA, INDIA IS NOW BECOMING THE MARKET OTHERS MUST HEDGE AGAINST
Indeed, with a median age of 28, an expanding digital consumer base, and deepening capital markets, India is one of the few large economies with long-term, endogenous growth drivers. Initiatives like ‘Make in India,’ coupled with newer schemes like the Design-Linked Incentive (DLI) for innovation, are helping create a more compelling and beneficial ecosystem for start-ups and multinationals alike. Still, challenges remain. Infrastructure development, while improving, lags behind China’s in scale and execution speed. Interstate coordination on industrial policy can be clunky. And the lingering perception of ‘policy risk’ continues to spook some long-term investors. Yet, optimism endures. Goldman Sachs forecasts that India will become the world’s second-largest economy by 2075, with a projected GDP of $52.5trn (see Fig 1). That may feel distant, but it is a signal of just how expansive the India bet really is.
India’s investment moment has arrived Once seen as just a backup to China, India is now becoming the market others must hedge against. The world isn’t just betting big – it is betting forward. The convergence of geopolitical realignment, structural reforms, and digital dynamism has created a moment of genuine opportunity. Whether India can fully seize that moment depends on its ability to translate promise into execution – and maintain the investor goodwill it has worked so hard to earn.
However, Schulman highlights that “corruption is not as endemic as it once was, but navigating bureaucracy still requires local savvy and strong partnerships…and while geopolitical alignment with the US is strengthening, India’s relationships with Russia and Iran, plus its balancing act with China, complicate the narrative,” he said.
In short, India isn’t just a plug-and-play growth story – but rather it is a strategic allocation that requires patience, persistence, precision and a bit of luck. n
As Europe ramps up defence spending in response to war on its eastern flank, leaders are reviving economies through military Keynesianism – yet critics warn this strategy neglects urgent needs like climate action, equality and public investment
WORDS BY Grace Blakeley ECONOMIST, AUTHOR & JOURNALIST






As Russia’s war on Ukraine rages on Europe’s eastern frontier, the continent’s leaders are finally willing to admit they have the power to revive their ailing economies. After decades of austerity, they are ready to spend again – but not to end poverty, accelerate decarbonisation, or reverse the collapse of essential public services. Instead, Europe’s fiscal firepower is being directed toward tanks, missiles and fighter jets. Reorganising the economy around state-supported defence spending is known as military Keynesianism, though John Maynard Keynes – who rose to prominence by condemning the punitive post-World War I peace treaty that was imposed on Weimar Germany, which ultimately helped set the stage for Hitler’s rise and another war – would probably not have endorsed the term.
The reasoning behind the resurgence of military Keynesianism is not entirely without merit, as the pursuit of austerity policies has left many European economies punching below their weight. European productivity, which has grown at half the pace of the US over the past decade, declined by one percent in 2023. Real wages fell by 4.3 percent in 2022 and 0.7 percent in 2023, following a decade of stagnation. Meanwhile, investment is nowhere near where it needs to be to tackle the twin crises of inequality and climate breakdown. Europe’s self-defeating commitment to austerity is epitomised by the German doctrine of ‘schwarze Null’ (black zero).
Even when Germany’s economic miracle was in full swing, politicians refused to invest in long-term growth. As a result, Germany –like most of the continent – has suffered from chronic underinvestment in physical and social infrastructure, constraining productivity.
The arms industry
Against this backdrop, rearmament may look like an easy fix. Unlike social expenditure, defence spending faces little political resistance. It enables politicians to appear tough – a
valuable asset in an age of strongman politics – and keeps the arms industry, a powerful lobby with deep ties to political elites, flush with public money.
But military Keynesianism is a dead end – both economically and politically. For starters, it is a weak engine of long-term growth. Modern weapons production relies on advanced manufacturing processes that use relatively little labour, so the industry has low multipliers compared to investments in health, education or green energy. It creates fewer jobs per euro spent and contributes little to the broader economy’s productive capacity. Military Keynesianism also deepens
revenues have accounted for 30–50 percent of Russia’s federal budget over the past decade and still represent roughly 60 percent of its export revenues. These industries provide the vital dollars that enable Russia to import military technologies and other critical inputs. Without that income, the Russian economy would quickly collapse under the weight of hyperinflation.
The most effective long-term strategy for countering Russian aggression, then, is not to ramp up military spending but to accelerate the green transition. What Europe needs is a real Green New Deal: a democratic, continent-wide mobilisation to decarbonise the economy, ensure energy security and create millions of well-paying green jobs. To be sure, this would require massive investment in renewable energy, public transit, retrofitting, and industrial electrification. It would also mean reshaping supply chains, restoring

Expanding defence capabilities means locking in demand for carbon-intensive technologies at a time when Europe should be phasing them out. Worse still, prioritising defence over decarbonisation sustains the very system of petropolitics that gives regimes like Russian President Vladimir Putin’s the resources to wage war in the first place.
As the Guardian reported earlier this year, the European Union has spent more on Russian fossil-fuel imports over the past three years than it has on financial aid to Ukraine. If the EU is serious about defeating Russia – not just on the battlefield, but geopolitically – then the bloc must confront the real source of the Kremlin’s power: oil and gas exports. Russia, after all, is a petrostate, and its war machine is financed by the revenues that flow from Europe’s addiction to fossil fuels. Oil and gas
MODERN MILITARIES ARE AMONG THE PLANET’S LARGEST INSTITUTIONAL FOSSILFUEL CONSUMERS
public ownership of key infrastructure, and breaking the stranglehold of fossil-fuel capital on European politics. But a Green New Deal would do more to strengthen the EU’s geopolitical standing than any number of new tanks and artillery shells. A Europe that produces its own clean energy, builds resilient green industries, and reduces its dependence on volatile global commodity markets is a Europe that cannot be held hostage by petro-tyrants. Europe’s political elite faces a stark choice: continue propping up a broken growth model by funnelling public money into the militaryindustrial complex, or invest in a liveable future rooted in solidarity, sustainability and democratic control. In the long run, building an inclusive green economy is the only way to counter the rage and alienation fuelling the rise of far-right forces – the greatest and most immediate threat to Europe’s democracies. n













PRESIDENT TRUMP’S ‘LIBERATION DAY’ HAS TRIGGERED A WAVE OF PROTECTIONISM THAT MAY PROVE DIFFICULT TO REVERSE, ALEX KATSOMITROS REPORTS »


hen US President Donald Trump announced an unprecedented increase in tariffs against foes and allies on April 2nd, the so-called ‘Liberation Day,’ Goodfellow, a UK advanced materials and metals supplier, suf fered a setback overnight. An initial review estimated that the cost base for its American sales rose by approximately 10 percent, a blow for a firm that derives 35 percent of its busi ness from the US. “From prior experience of the Trump administration, we always knew there would be some significant measures in troduced and the President didn’t disappoint,” says Andrew Watson, Goodfellow’s chief fi nance officer. Although Goodfellow sources a small amount of its purchases from China, 150 percent cost hikes can cause major disrup tion. “While we can try to re-source this, it is not always possible, particularly with some materials that can only reliably be sourced from China,” says Watson, adding: “We also have incidents of US origin products – bound for China – that cannot now be sold economically.” The company exports to over 60 countries and potential EU retaliatory tariffs would raise costs for its Baltimore-based subsidiary. “We can deal with the consequences of the ‘new normal,’ but we cannot plan for constant changes,” Watson warns. “There is no way of getting around the simple fact that even the best scenario results in higher prices for customers and changes to supply chains.”
Few people were surprised by the Trump administration’s embrace of tariffs as a means of reshoring manufacturing jobs. During his campaign, Trump expressed his support for an aggressive trade policy. Yet, such a massive spike in tariffs, pushing average rates back to mid-20th-century levels, surprised even the staunchest protectionists, as even traditional US allies such as Australia and Japan were affected. The method used to calculate new rates also raised questions. When Trump presented a cardboard chart with the new rates, it was assumed that they incorporated a combination of existing tariffs and other trade barriers. It later emerged that for each country the US administration had divided the trade deficit in goods by total imports and then halved the result. Even net importers
nesses spend and invest more than they earn, meaning that it may persist despite increasing tariffs. With many trade partners, the deficit stems from geography, for example fruit being easier to grow in warmer climates. These practicalities seem of little interest to an administration determined to overturn the status quo. “Trump wants to end up with low and balanced tariffs,” says George Calhoun, who teaches quantitative finance at the Stevens Institute of Technology, pointing to a 2018 G7 summit where Trump called for the elimination of all tariffs. “He wants to equalise or ‘reciprocalise’ the trade landscape among major trading partners. The era where the US ran a parallel Marshall plan for trade by allowing highly asymmetric trade arrangements to continue is coming to an end.”
Supporters of the US President argue that the tariffs are merely the first step in a longerterm strategy. If true, a 90-day pause on tariffs higher than 10 percent announced in late April was a strategic move to provide time for concessions from trading partners. For opponents, the climb-down signalled a major policy failure, partly imposed by turmoil in
EVEN THE BEST SCENARIO RESULTS IN HIGHER PRICES FOR CUSTOMERS AND CHANGES TO SUPPLY CHAINS
nearly a percentage point less than previ ously projected in 2025. JPMorgan Chase CEO Jamie Dimon expressed concerns that a recession was imminent, which reportedly pushed Trump to scale back the tariffs. Undoing the damage that tariffs have done to business confidence will be difficult, says Nick Rakovsky, CEO of DataDocks, a logistics software company processing US warehouse appointments. “The pause removed an immediate cost spike and helped with cash-flow forecasts, but it hasn’t repaired confidence. Without a clear timeline, scope and escalation path, companies prefer the flexibility of short bookings and higher safety stock to committing long term.” However, revenue from tariffs could help fill government coffers ahead of any stimulus required to prevent a recession, and could also be used to pay down government debt, says Nick Baker, an expert on trade at FTI Consulting.
Political considerations also come into play. A recession could lead to a Republican loss in the mid-term elections in November 2026. Trump’s own electorate will feel the pinch, with inflation expected to rise up to four percent if the initial tariff rates are maintained. A survey by the Cato Institute and YouGov found that 40 percent of Americans were concerned about inflation and just one percent about trade. Unravelling long-established supply chains will be difficult, given that producers will take time to switch to domestic suppliers and imports


won’t drop immediately. “Many sectors rely on complex supply chains that have been forged over many years. You can’t simply rip this up, wave a magic wand and have a US supply chain that does everything,” says Goodfellow’s Watson, adding: “Rare materials often come from a limited number of global sources and any disruption caused by tariffs or trade restrictions could create bottlenecks for research and industry.” Most trade between developed economies is intra-industry, notably trade in machinery used in manufacturing, meaning that the tariffs would indirectly hit US producers too, notes Stephen Buzdugan, who teaches international business at Manchester Metropolitan University: “Tariffs of 20 percent or higher on imports from Japan, Korea, China and the EU will have knock-on effects on production costs across the US and other industrialised countries.”
For the EU, a key US trade partner, ‘Liberation Day’ wasn’t a surprise, given Trump’s aggressive trade policy during his first term and his accusations that the EU is “ripping off” the US. The Trump administration has claimed that the EU imposes a 39 percent tariff on US products, despite a World Trade Organisation (WTO) estimate of just five percent. For their part, European policymakers perceive the tariffs as an existential threat, given the EU’s role as a defender of a rules-based trade order. The US has imposed a 25 percent tariff on European steel, aluminium and cars, as well as a blanket 10 percent tariff on all EU imports. A doubling of the latter has been paused until July, as the two sides have exchanged negoti-
ating documents. Although the EU suspended its initial retaliatory tariffs to leave room for negotiation, if this fails it plans to respond with a €100bn tariff package targeting imports that include Boeing aircraft, medical devices, cars and bourbon whiskey.
The bloc’s response will be shaped by political calculations regarding its relationship with the US and internal divisions. Member states with strong US exports, such as Ireland and Italy, have called for a more conciliatory approach, while others are urging the bloc to stand firm against Trump’s bullying tactics. A decision will be reached through qualified majority voting, but the US has little chance of dividing its European trade partners, says Niclas Poitiers, a research fellow at the Brussels-based think tank Bruegel, pointing to Brexit and recent EU levies on Chinese electric vehicles as examples of member state alignment despite disagreements: “You want to have a broad support for your measures, otherwise they might not be credible as a threat towards the US, but there is no need for unanimity.” Some member states are cautious about antagonising the US due to security concerns, with a recent Nato summit set to discuss European defence spending amid the Ukraine war. Trump has demanded that European allies increase their defence spending to five percent of GDP and assume more responsibility for the continent’s defence. Some observers think a scenario similar to last May’s UK-US trade deal is the most likely outcome. The UK managed to secure cuts to the 25 percent tariffs on car and steel exports but failed to reverse the flat 10 percent levy, which has left Britain facing a tougher trad-
YOU CAN’T SIMPLY RIP THIS UP, WAVE A MAGIC WAND AND HAVE A US SUPPLY CHAIN THAT DOES EVERYTHING
ing relationship with the US. One ace up the EU’s sleeve is targeting digital services, an area where the US maintains a net surplus. “If you want to include services, you have to think outside of the box,” says Poitiers, adding that the EU has a new tool, the Anti-Coercion Instrument, that allows it to employ the entire toolbox of regulation available to hit US tech giants. Ireland, which hosts many of them, may face pressure to revise its favourable tax regime. “That is member competence and Ireland does not want to kill the golden goose. They will probably be opposed to any measures that will undermine their business model,” Poitiers notes, adding that the Commission could still take a creative approach. “There is a lot of retaliation potential that could escalate this beyond a traditional trade conflict.”
A side effect of strained EU-US relations might be closer ties with other major trade partners. Brussels is reviving a plan to form a strategic partnership with a 12-country Indo-Pacific trade bloc that includes Canada, Japan, Mexico and the UK. Trade relations with China may also improve, despite tariff tensions over electric vehicles. However, the trade imbalance between the two has only grown worse, despite the EU’s efforts to curb it. “The European and Chinese economic models are not compatible, and the spillover effect of China’s economic model exporting into Europe has a level of a deindustrialisation risk,” says Jacob Gunter, lead economist at the Berlin-based think tank Mercator Institute for China Studies (MERICS), adding: “There is no agreement that the EU and China could come up with that would prevent that from happening.”
If the European Union hopes to meet Trump halfway, China finds itself in a different position. As the country with the world’s largest trade surplus, the Asian country is the primary target of US protectionism, which threatens to undermine its export-driven economic model. For now, the two countries have agreed to a temporary pause, reducing US tariffs from 145 to 30 percent, while China slashed its retaliatory tariffs from 125 to 10 percent. “This ceasefire is functionally a recognition that the escalation ladder was scaled too high and too quickly, and that the pace of US-China decoupling needs to be adjusted to
» avoid a crisis undesired by both sides – like a complete breakdown in global value chains or a recession,” says Gunter from MERICS, adding: “The fundamentals in the economic and technological relationship, to say nothing of the security and geopolitical situation, remain deeply imbalanced and increasingly irreconcilable.”
China has signalled its intention to resist unilateralism by restricting rare earth exports and agricultural and energy imports, while also issuing travel advisories discouraging Chinese tourists from visiting the US. Its strongest weapon remains its dominance of rare earths, with further export restrictions to rare earth elements and magnets potentially threatening US production of robots, fighter jets, wind turbines and cars. “China has done a lot more to prepare for a shootout like this with the US. That has been the central pillar of their economic policymaking for the last 10–15 years, especially since the first Trump administration,” says Gunter. Trump has imposed port fees of $1.5m on China-built vessels, a measure the World Shipping Council estimates could double the cost of shipping US exports. If the US wanted to escalate, it could further restrict China’s access to critical technologies. “What keeps Xi Jinping up at night is getting technologically cut off. The US could simply ban the sale of chips and specific equipment to China,” Gunter says. “That choking-off has happened in semiconductors, semiconductor manufacturing equipment and lithography machines. But it has been relatively limited and less effective than hawks in Washington would prefer.”
The domestic front is equally important. US tariffs will hit Chinese exports, depreciating the yuan and indirectly leading to capital flight, a serious risk to the Chinese regime, Calhoun estimates. China has more to lose since it is more committed to a global economy, says Shameen Prashantham, who teaches at the China Europe International Business School, given that its “export-oriented companies will face strong headwinds and some of them will fail to survive, leading to job losses and a drag on growth.” On the other side of the Pacific, if enough Republicans side with Democrats in Congress, they could strip the president of his unilateral tariff powers. “China might wait to see how their negotiating position improves as small companies have to fire workers and truckers and port workers have less demand because of fewer goods coming into the US,” Gunter says.

and India. President Xi Jinping has launched a charm offensive targeting Vietnam, Malaysia and Cambodia – countries through which China diverted exports to the US during Trump’s first term – but has also warned them against striking bilateral deals with the US.
Many experts have pointed as a desired endgame for the Trump administration a China-US agreement similar to the Plaza Accord in 1985, when the Reagan administration effectively forced its trade partners, notably a surging Japan, to appreciate their currencies against the dollar to reduce the US trade deficit. Economists believe this marked the beginning of Japan’s economic stagnation. “Chinese leadership is afraid of the Plaza Accord and will absolutely resist anything like that,” Gunter says. Another scenario is a temporary truce with a deal that makes Trump believe he won by committing China to purchases of LNG, soybeans and Boeing jets. “That would be a victory for China, because what Xi wants
THE WTO HAS FAILED TO MANAGE A FAIR TRADE REGIME, DESPITE ITS HIGH ASPIRATIONS
globalisation? Optimists argue that such forecasts are premature, given that global trade growth is expected to be driven by emerging economies. Recent trade deals, such as the EU-Mercosur agreement, demonstrate continued appetite for market liberalisation. Even if the US chooses isolation, it accounts for just 13 percent of goods imports. Booming trade in services is expected to offset a decline in goods exchanges. International supply chains remain robust, argues Poitiers from Bruegel, pointing to the pandemic as proof of their resilience: “This was an incredible shock, much larger than the trade shock we experience now. Despite all the talk about the end of global value chains, it didn’t happen.”
It is no surprise that in such a precarious geopolitical landscape, international organisations like the WTO have come under fire as outdated pillars of multilateralism and a rules-based trading regime in an increasingly unilateral world. Pessimists warn that the trade war could be the final nail in its coffin. “It may well be the end of the WTO as we know it. The WTO has failed to manage a fair trade regime, despite its high aspirations,” says Calhoun, adding: “The proliferation of non-tariff trade barriers has raged on, with the level of complaints surging from many countries, and
tion (MFN) treatment, which some experts interpret as de facto US withdrawal. “Their-
ten a history of the organisation, adding that current US policy undermines the MFN rule.

Dollar and treasuries: Still safe havens?
At the centre of the global trade war lies a surprising US grievance: the dollar’s position as the global reserve currency. In a controversial paper published last November, Stephen Miran, chief economic adviser to President Trump, claimed that the dollar’s status as the reserve currency is a ‘burden’ contributing to chronic trade deficits. The paper, which is believed to have influenced US policy, concluded that the US should deliberately weaken the dollar and compel holders of US sovereign bonds (known as treasuries) to fund its defence spending. Financial market turbulence since ‘Liberation Day’ suggests that foreign investors are not convinced, effectively questioning the role of treasuries as the global reserve asset and driving up US debt refinancing costs. The head of Congress’ fiscal watchdog has warned that this crisis could mark a tipping point in investor willingness to hold US assets, potentially sparking a capital flight crisis.
China’s recorded treasury holdings have dropped below those of the UK for the first time since 2000, a sign the country is diversifying away from US assets.
Last May, Moody’s stripped the US of its final triple-A credit rating, citing rising government debt and a growing budget deficit. For the first time in history, the US no longer holds a top rating from any of the three major credit rating agencies. “Rising protectionism and economic nationalism may lead to a gradual fragmentation of financial markets, where capital becomes more regionally concentrated rather than flowing freely across borders,” says Supriya Kapoor, who teaches finance at Trinity Business School. “Financial institutions may face increased regulatory divergence, higher compliance costs, and restrictions on cross-border mergers, acquisitions and operations, all of which could dampen the efficiency and profitability of global financial services.
CHINA HAS DONE A LOT MORE TO PREPARE FOR A SHOOTOUT LIKE THIS WITH THE US
sation, but the US staying as a spoiler would be worse,” VanGrasstek argues, adding that there is a possibility that other members may try to expel the US. Optimists, however, believe that the tumult caused by the trade war could reinvigorate the WTO by accelerating longawaited reforms, notably of its dispute settlement mechanism. A US withdrawal would also push other countries to work together, with BRICS members and the EU taking the lead. “China sees a lot of value in the WTO. It’s the framework through which it trades with the world,” Poitiers says. “If countries representing 85 percent of global GDP still want to use the system in its current form, it can chug along for quite a while.”
The role of trade has fluctuated over time, with protectionism making an ugly comeback every few decades. Many historians draw parallels to the 1930s, when the infamous Smoot-Hawley Tariff Act raised US tariffs, prolonging the Great Depression and fuelling populist forces that led to the Second World War. However, unravelling decades of global economic integration would be much more difficult today. A decoupling of the Chinese and US economies in particular would have major consequences for the global economy, from higher inflation rates to lower growth. “Smoot-Hawley was very destructive, but didn’t increase tariffs to unprecedented heights because average tariff rates were very high back then. Current US tariffs are enacted in a period of unprecedented economic interdependence. The effects are in a league of their own,” Poitiers says, adding: “The US is withdrawing as a leading force of globalisation, but it will likely pay a high price for that.”
The real threat is not the end of globalisation, but a fragmentation of the current system into competing trading blocs, warns VanGrasstek. What is worse, we might be at an unprecedented junction of history where no superpower has an incentive to maintain an open trading system, VanGrasstek argues, given that even China’s economy is becoming less exports-driven. “Both the US and China have very strong incentives to move towards bloc formation, and that is where we may be headed. That means that we are moving into a 1930s style system, and that is very dangerous.” n

Today’s threats to executives are more frequent, personal, and complex. Responding effectively means swift triage, informed assessment, and proactive action. Striking the right balance is vital – overreacting or ignoring threats can be equally dangerous. Prevention must replace reaction
WORDS BY Graeme Hudson VICE PRESIDENT OF CRISIS & SECURITY CONSULTING, CRISIS24
sassination of UnitedHealthcare CEO Brian Thompson in December 2024 was a stark reminder of the real threats faced by business leaders and high-profile individuals.
Threats must be assessed quickly, discounting those lacking credibility while focusing on individuals posing genuine physical harm. While easier said than done, effective triage is essential. Law enforcement primarily focuses on evidence collection rather than real-time threat assessment; the burden often falls on the organisation or individual to determine what requires urgent action.
In one instance, an organisation’s leadership faced a social media backlash sparked by a high-profile critic. Personal details were published alongside executives’ names, drawing thousands of comments – many explicitly threatening violence. Immediate security guidance was issued while a deeper assessment began, with the priority being staff safety.












‘I am a hitman, hired to kill you, but I see you are a good man. If you pay me $5,000 I will cancel the job, otherwise I’m coming to your house to kill you and your wife.’ This message appeared one morning in a Chief Financial Officer’s inbox. Questions raced through his mind: Who sent this? Should I be worried? This was not the first time experts had seen such tactics, with similar cases appearing frequently each year.
Digital investigations confirmed the wording matched scripts sold on the dark web. The message lacked specific knowledge about the CFO – no names or addresses were mentioned. It was also established that his email had been compromised in a social media data breach. This was simply a scam targeting many victims, similar to ‘sextortion’ emails from previous years. Like many organisations, the CFO’s company lacked security resources to support staff in such situations.
For organisations without dedicated security resources, these moments can be unsettling.
Threats can arrive via various channels: text messages (including WhatsApp, Signal), voice calls, emails, physical mail and social media. The priority is always assessing credibility before action. Anyone can make a threat, but do they mean it?
Threat actors span many categories: disgruntled employees or ex-employees, obsessed individuals, angry customers, or malicious troublemakers. For some leaders, the sheer volume of threats can quickly overwhelm them and their security teams – particularly those associated with politically divisive organisations. The targeted as-
1. What was said? Is the threat explicit or implied?
2. What do they want? Is there an extortion demand, or are they purely making threats to harm?
3. Who are they? What identifying information can be extracted (such as phone numbers, email addresses, metadata, etc)?
4. What is the motive? Often financial, though when money is not mentioned, deeper reasons may exist.
5. Do they have capability and intent? Can they carry out their threat, and do they mean what they say?
6. What options exist for both victim and threat actor? What is likely to happen next, and how can the target be protected?
When handling mass digital threats, establishing capability is the first priority. In this case, all threatening accounts were identified, users geolocated, and historical activity analysed. The targeted executives were based in southern England, while the individuals behind the threats were largely outside the UK. Most were in the US and the geographically closest was in West Africa. Though travel remained theoretically possible, this context reduced the likelihood of a credible threat.
A crisis response consultant was mobilised to provide strategic advice on managing the situation while forensic research was conducted into the threat actors’ profiles, including image analysis to verify geolocation data. In select cases, psychological profi ling is used to distil behavioural insights directly from threat language.
For organisations, taking proactive steps to monitor emerging risks can make a difference. Events like AGMs, financial disclosures, or leadership changes often trigger heightened threat activity. Early identification of highrisk individuals or groups allows for strategic monitoring, deploying safeguards before escalation occurs.
The modern threat landscape is evolving – becoming more personal, frequent and sophisticated. Responding effectively means finding a balance between urgency and rational decision-making. The right expertise can cut through the noise, enabling swift, informed action that ensures security without unnecessary alarm. n

The Yangtze River Delta – China’s busiest economic zone and rail hub – has upgraded its high-speed rail operations. The newly implemented train operation map, which rolled out in April, has introduced increased service frequency and optimised routes aimed at better supporting regional business, logistics and tourism demand. Home to cities like Shanghai, Nanjing and Hangzhou, the Delta region
relies on high-speed rail as a backbone of its modern infrastructure network. With over 3,500 highspeed train movements per day, the area represents a crucial artery in China’s national transport grid. This operational update will see the addition of 36 new services and adjustments to 60 existing schedules, reducing travel time on popular business routes by up to 15 minutes. Passenger volume is
Passenger capacity expected to rise by 8.2% in 2025 with the new operation map
expected to rise by 8.2 percent in the second quarter alone, underlining the importance of efficient, scalable transport for China’s fast-evolving urban clusters. As global investors watch infrastructure growth closely in the world’s second-largest economy, moves like this signal continued commitment to transit modernisation and regional integration in Eastern China.
36 new train services and optimised schedules for 60 existing routes will improve travel times
The region accounts for 24% of China’s total rail passenger traffic annually
Aerial view of bullet trains waiting on storage tracks at Nanjing South Railway Station, Jiangsu Province of China
The Nanjing South Railway Station alone handled over 85 million passengers in 2024
Corporate governance serves as the cornerstone of an organisation’s success, ensuring transparency, accountability and ethical conduct. As the role of boards transitions from regulatory oversight to strategic leadership, they become pivotal in shaping the organisation’s future, fostering sustainable value creation and cultivating a culture of excellence
WORDS BY Wajahat Gul Memon
CORPORATE GOVERNANCE LEAD, COMMERCIAL BANK OF DUBAI






Corporate governance constitutes a framework of rules, practices and processes by which an organisation is directed and controlled. It represents the relationships among an organisation’s shareholders, board of directors, management and other stakeholders, ensuring transparency and accountability in decision-making. This framework builds trust and integrity, which are essential for enhancing corporate performance and profitability. In adhering to high standards of governance, organisations can align their strategic goals with stakeholder interests, thereby establishing a solid foundation for sustainable success.
From oversight to strategy
Previously, serving as a board member was often regarded as a distinguished role and a recognition of a successful professional career. The composition of the board was not a major topic of discussion, and it was common for individuals to hold multiple board memberships, sometimes serving as board members and chairpersons for numerous organisations, at times exceeding 10 organisations. This practice was driven by the belief that experienced professionals could offer useful advice and connections to many organisations at the same time.
Gradually, boards began to function as supervisory bodies, focusing on governance and compliance and serving primarily as a required oversight function. They fulfilled
regulatory requirements rather than actively contributing to the strategic direction of the organisation.
Today, the role of the board has evolved significantly. Boards are now instrumental in defining the future and strategy of organisations. The qualifications of board members aim to facilitate meaningful contributions. The board’s composition is now closely scrutinised to ensure it includes the skills and expertise needed for long-term success, effective oversight of compliance and governance and appropriate delegation of operations to management. This shift reflects a forward-looking approach that prioritises the strategic and sustainable growth of organisations.
Boards are expected to help shape an organisation’s vision and strategy by guiding management, aligning with long-term goals, and tackling new challenges and opportunities. This requires board members to have a broad range of skills, such as strategic thinking, financial knowledge, industry expertise, and the ability to understand complex regulations and market trends.
Organisations now look for members who offer fresh perspectives and specialised knowledge to handle diverse issues. A diverse board is better equipped to make smart decisions, manage risks and identify opportunities, offering purposeful oversight and strategic direction.
Overall, the evolution of the board’s role reflects a broader shift towards more dynamic and proactive corporate governance. Boards are no longer merely fulfilling regulatory requirements. They are driving long-term value creation and ensuring that the organisation remains resilient in the face of changing market conditions.

This transformation highlights the importance of having qualified, diverse, and engaged board members who can navigate the complexities of modern business and contribute to the organisation’s success.
An effective board is characterised by key traits that drive good governance and the achievement of strategic goals. This starts with a healthy balance of executive, non-executive and independent directors, who together offer the right mix of skills, knowledge and experience to enable better decision-making and governance. Each board member must clearly understand their roles and responsibilities, including their fiduciary duties. Ongoing professional development is essential to keep directors up to date with industry trends and best practices. Independent oversight is critical and should be supported by regular assessments of each director’s independence

to ensure objectivity. Regular performance evaluations of the board, its committees and individual directors, help identify areas for improvement and reinforce alignment with governance objectives. Ultimately, effective boards are made up of the right people, equipped with timely and accurate information, who use their time wisely, lead with purpose, collaborate well, and maintain strong, constructive relationships with executive management.
practices in the UAE
Corporate governance in the United Arab Emirates (UAE) has transformed significantly in recent years, driven by evolving regulations and the UAE’s commitment to transparency, accountability and ethical conduct. As a seasoned practitioner in the field of corporate governance, I have had the privilege of witnessing dynamic changes and proactive measures implemented to elevate corporate
Excellence in governance at CBD Commercial Bank of Dubai (CBD) is committed to enhancing its governance framework to ensure unparalleled transparency, accountability and ethical conduct across all operations. This steadfast dedication secures our integrity while driving sustainable, long-term value for our stakeholders. Our governance practices are continuously evolving to align with the latest regulations and trends, ensuring that we remain at the forefront of corporate governance excellence.
This focus has driven our success in promoting transparency, accountability and ethical conduct across all operations, reinforcing our position as a regional leader in governance. The board of directors at CBD collectively possess the requisite skills, knowledge, and experience to effectively govern and steer the bank. Further, the board actively enhances its members’ expertise through ongoing professional development. This approach enables the creation of a diverse and well-rounded skill set, addresses gaps, and prepares members to navigate a dynamic and evolving environment.
governance practices. These initiatives have ensured that organisations operate with enhanced transparency and accountability, aligning with both local and international standards. The adoption of international standards has attracted foreign investment, helping to drive economic growth. Proactive measures such as stringent reporting requirements, regular audits and the establishment of dedicated governance committees have strengthened corporate governance across various sectors.
These initiatives have further created a culture of accountability, where organisations focus on long-term sustainability, risk management, stakeholder engagement and creating long-term value for stakeholders. Overall, the UAE’s dedication to a transparent, accountable, and ethically sound business environment has positioned it as a leader in corporate governance, promoting sustainable growth and attracting investment.
The bank has established five board committees to ensure effective delegation and oversight across key areas of its operations. These include specialised committees focused on strategy, business growth, compliance and risk management, and board composition and succession. This structure allows for targeted attention to critical functions, ensuring that specialised tasks are addressed efficiently and with the appropriate expertise. It reflects modern governance principles that prioritise strategic leadership, diverse capabilities and proactive management of emerging challenges and opportunities.
As corporate governance continues to evolve, CBD remains firmly committed to the highest standards of transparency, accountability, and ethical leadership. The bank encourages a strong governance culture, reinforced by ongoing development, rigorous oversight, and a forward-looking board. As such, the bank is well-positioned to navigate emerging challenges, drive strategic growth, and deliver long-term value to its stakeholders. These purpose-driven efforts underscore the bank’s leadership in corporate governance across the region. n
Ten years ago, our company established continuous dialogue with shareholders as a commitment in its pioneering ‘Ongoing Shareholder Engagement Policy,’ which remains one of the keys to its successful governance model, writes Iberdrola
Being the largest electricity company in Europe and one of the two largest worldwide, Iberdrola is the holding company of a multinational group present in Spain, the US, the UK, Australia, Mexico, Brazil, Germany, France and other member states of the European Union, among other countries.
The company firmly believes that electrification is a great opportunity to increase energy autonomy and security, competitiveness, industrialisation and the generation of employment, at the same time as protecting the environment and human health.
In March 2024, Iberdrola announced an investment of €41bn by 2026 to help create a secure and sustainable energy future for all. Net profit reached €5.6bn and EBITDA reached €16.8bn in 2024, driven by record investments of €17bn. The next Capital Markets Day, where the company will update its investment outlook, will take place in September 2025.
Its business model is focused on the sustainable creation of value, in accordance with the provisions of the ‘By-Laws’ and with the corporate policies approved by the Board of Directors, including one of the first engagement policies on the international scene.
The company’s ‘Ongoing Shareholder Engagement Policy’ was initially approved in 2015, upon a proposal from a committee made up of professionals with special qualifications and experience in corporate governance and shareholder movements. According to that policy, shareholder engagement occurs not only during the general meeting but throughout the year via a continuous and inclusive dialogue to understand the interests of shareholders.
To this end, the company maintains permanent communication channels and instruments, which enable it to identify and respond to the opinions and concerns of shareholders,
developing reciprocal and continuous feedback that contributes to decision-making that is more informed and aligned with the corporate interest.
SHAREHOLDER ENGAGEMENT OCCURS NOT ONLY DURING THE GENERAL MEETING BUT THROUGHOUT THE YEAR
In this continuous relationship with the shareholders, the company attends to the entire shareholder base, resulting in meetings held with around 1,600 investors and thousands of contacts with retail shareholders in 2024. From the viewpoint of the shareholders, engagement extends and strengthens their rights to information and participation recognised in applicable law, as shown by the following measures that the company has developed.
The ‘Ongoing Shareholder Engagement Policy’ fosters ongoing interaction that is not limited to the holding of the general meeting, with the aspiration of maintaining an effective and constructive relationship throughout the year, based on the following principles.
>Transparency : Endeavour to ensure transparency through clear, continuous and responsible communication, sharing truthful, appropriate, relevant, correct, complete, reliable and useful information.
>Participation: Promote shareholder participation in activities organised throughout the year and actively foster their participation in the general meeting.
>Interaction: Proactively and constantly maintain interaction with the shareholders to forge a sense of belonging through direct, fluid, constructive, ongoing, effective and inclusive dialogue that allows for reciprocal understanding.
>Active listening : Know the decisions, opinions, concerns and proposals of the
€5.6bn
Net profits for Iberdrola in 2024

shareholders in order to understand, assess and respond to them and foster a long-term relationship, contributing to more informed decision-making, a better understanding of the community and the implementation of sustainable conduct.
>Respect: Respect equal treatment in the acknowledgement and exercise of the rights of the shareholders in the same situation and who are not affected by any conflict of interest or competition, and protect the legitimate rights and interests of the shareholders.
>Innovation: Use new technologies to engage shareholders, in order to achieve interaction with as many shareholders as possible and to facilitate access to information, with the commitment to use such technologies responsibly and to continue offering alternatives for shareholders who need or prefer to use non-digital mediums.
>Continuous improvement: Be receptive to and take into account generally recognised good governance recommendations and the accumulated experience and opinions of the shareholders, shareholder associations, institutional investors, proxy advisors and other stakeholders.
For this 10th anniversary of its ‘Ongoing Shareholder Engagement Policy,’ Iberdrola has launched a new engagement space on the corporate website, as a hub that sets out

the company’s main communication and contact channels to inform and listen to the shareholders, fostering their participation in the general meeting as well as in other events and meetings throughout the year.
The company makes a commitment to continuously respond to shareholders’ queries and suggestions. Specifically, all shareholders who are registered with the ‘OLS shareholder’s club’ channel may, confidentially or openly vis-à-vis other shareholders and at any time, request such information or clarifications as they deem appropriate, or submit such questions as they consider relevant.
The main milestone for this ongoing interaction is the general shareholders’ meeting, which reached a quorum of 75.55 percent of share capital in 2025, the highest level among Spanish peers with a similar shareholding structure, and a support of over 99 percent the total votes in favour and against, further endorsed by the assurance provided by an independent external firm.
These results consolidate an extraordinary average level of participation in excess of 75 percent over the last 10 years, a very high percentage for a company whose shares are 100 percent freely transferable, except for directors and officers subject to shareholding policies. For this purpose, the company allows all shareholders to participate in the general
Best practices in corporate governance and example of corporate reporting
• Permanent access to information through the engagement channels and specific attention to resolve any questions regarding participation in the general meeting, in addition to the mandatory documentation.
• E xtended participation period to facilitate the maximum dissemination of the documents and favour the participation of the highest possible number of shareholders, publishing the announcement of the call to meeting well in advance of the one-month notice period established in applicable law.
• Participation channels which combine innovative electronic systems implemented for real-time authentication via any device with internet access, the telephone and instant messaging channel, and traditional systems based on personalised attention.
• Accessibility measures to allow the participation of shareholders with hearing or visual impairments, such as simultaneous interpreting into Spanish sign language, electronic subtitling and audio description, and it attends to any need raised in this regard via the shareholder’s office.
• Participation incentives such as the innovative engagement dividend which is payable to all shareholders if the quorum reaches at least 70 percent of the share capital.
• Sustainable management of the general meeting with external certification since 2016, pioneering sustainable management practices at corporate events.
meeting without requiring a minimum number of shares and fosters their participation, so that they can all exercise their rights in an informed and responsible manner, regardless of their place of residence.
All the aforementioned measures have been implemented taking into account the interests of shareholders, internationally recognised best corporate governance practices and the recommendations made in the guidelines of the leading proxy advisors. In turn, in accordance with the ‘By-Laws,’ the shareholders undertake to exercise their rights vis-à-vis the Company and the other shareholders, and to comply with their duties, acting with loyalty, in good faith and transparently, within the framework of the corporate interest as the paramount interest ahead of the private interest of each shareholder and in accordance with law and with the governance and sustainability system.
Thanks to direct knowledge of shareholder and investor expectations as a result of engagement, the company’s corporate reporting is ahead of good governance recommendations and even of legal requirements, as shown by the voluntary publication of the sustainability report 15 years before the statement of non-financial information became mandatory in Spain.
In order to offer a fuller and more transparent view of its governance model, the company has produced its Annual Corporate Governance Report 2024 broadening the legally required content with other material, such as the vision of the corporate purpose and values, the corporate and governance structure of the group, the review of the main milestones and outlook for the previous financial year, the keys to the internal control system for sustainability reporting, and the compliance system of the group’s companies.
This innovation makes it possible to simplify, streamline and facilitate access to all reports on corporate governance that the company voluntarily publishes by compiling here, among other documents, the activities report of the board of directors and of the committees thereof, as well as the report on the application of the ‘Ongoing Shareholder Engagement Policy.’ n

From receptionist to CEO, my journey has taught me that great leadership is all about people. By empowering teams and embracing growth, we can truly multiply greatness together
When it comes to leadership at Agilitas, creating a culture where everyone can thrive is at the top of my list. We follow a ‘total experience’ approach, which means we believe everything is connected. The way our employees feel impacts the way they interact with our customers, and ultimately, that impacts overall business performance. It is a 360-degree approach to growth and success.
Part of that culture-building is about creating a team of A-players. But as anyone who has worked in a high-performing team knows, the secret to success isn’t just about having a group of rockstars. It is about ensuring everyone is working towards a shared vision. Setting clear goals and strategies is key to making sure that alignment happens.
Each quarter, the leadership team at Agilitas heads to a farm in the New Forest for an offsite strategy session. It is a great chance to step away from distractions and really focus on setting the direction for the next quarter. These sessions help ensure that everyone understands the goals, the strategy, and how their roles contribute to the bigger picture.
WORDS BY Sara Wilkes CEO, AGILITAS



Long before I became a CEO I took a temp to perm job as a receptionist at Computacenter in 2006. Fast forward 19 years and I am often asked about my journey from reception to the boardroom, which is still a ‘pinch-me’ moment. I have been lucky enough to work with some incredible leaders in the tech industry, seeing firsthand the styles that lead to success, and, as importantly, those that don’t. My journey has taught me one crucial thing: it is all about the people.
Leadership isn’t static; it is fluid, and how your style is perceived can be a challenge, especially with the diverse personalities around you. But the beauty of it is that by refreshing your approach, you can evolve to become the kind of leader you want to be.
The best leaders make everyone smarter
A tactic that resonates with me is the multiplier effect, a leadership approach that focuses on unleashing the full potential of your team. The idea comes from Liz Wiseman’s
book, Multipliers: How the Best Leaders Make Everyone Smarter, and it is one that has had a profound impact on my own leadership style.
Multipliers get people to think for themselves and unlock their potential. They create an environment where people feel empowered to learn and grow, making a huge contribution not only to the business but also to their own personal development. In my leadership journey, I have learned that when I lead like a multiplier, I don’t just give answers, I ask questions, trigger lightbulb moments and encourage those around me to be bigger and bolder. It is critical to encourage growth and continual learning, not just for your team, but for yourself too. I am not afraid to ask for help, and I have my own mentors who will call me out and help me grow. I read, listen to podcasts, and actively seek out new ways to improve because, as any leader will tell you, if you are not growing, you are falling behind.
When I reflect on my previous role as chair of the diversity and inclusion board, where I helped establish seven employee-led groups, I see how powerful diverse perspectives are in shaping a thriving workplace.
Beyond gender and ethnicity, diversity includes cognitive diversity, championing different ways of thinking, problem-solving, and approaching challenges. This diversity of thought sparks creativity, promotes resilience, and encourages more innovative solutions. Building a culture of inclusion strengthens psychological safety, allowing employees to feel confident in sharing their ideas and taking risks.
I am a firm believer that when people feel valued and empowered, they go above and beyond. When employees feel invested in their work and in the company they are more likely to contribute their best ideas, go the extra mile for customers, and feel part of something bigger. It is the multiplier effect in action: engaged employees lead to satisfied customers, which drives business performance.
“ When people feel valued and empowered, they go above and beyond”
Looking ahead, I am excited about the future at Agilitas and the broader tech industry. By focusing on growth, development, and creating an environment where people feel empowered, we can foster a cycle of growth that creates long-term success and makes an impact. As leaders, we have the power to multiply greatness. Let’s make the most of that. n












For the 18th consecutive year, the World Finance awards continue to honour excellence in a variety of different industries


The global banking industry in the past year has operated within an environment of significant complexity. Economic headwinds, high interest rates, persistent inflation, and geopolitical tensions have all shaped banking strategies worldwide. According to Deloitte’s 2024 outlook, financial institutions contended with diverging regional economic growth – sluggish expansion in developed markets contrasted with robust growth in parts of Asia and Latin America. Meanwhile, banking leaders increasingly recognised the need to adapt legacy operating models to remain competitive and relevant. At the same time, digital transformation continued to accelerate. Artificial intelligence and automation have shifted from being differentiators to essentials. Banks are investing heavily in cloud-native systems and real-time data capabilities to meet evolving customer expectations. Yet with these digital advances come rising concerns around cybersecurity, data governance, and regulatory compliance – challenges that demand agile, cross-functional leadership. Talent gaps have become another pressing issue, particularly as banks compete with tech firms for professionals skilled in areas like data science and cybersecurity. Institutions that succeed are those taking proactive steps to upskill internal talent and embed innovation into their culture. We proudly recognise this year’s winners of the WorldFinance Banking Awards 2025 for their leadership, innovation, and ability to thrive under pressure. These institutions are setting benchmarks for responsible growth and are reimagining the future of global banking.
BEST INVESTMENT BANKS
COUNTRY BANK
Brazil Itau Unibanco
Chile
Colombia
BTG Pactual
BTG Pactual
Dominican Republic Banreservas
France BNP Paribas
Georgia TBC Bank
Germany Deutsche Bank
Hong Kong
Morgan Stanley
Jordan Arab Bank
Kazakhstan Tengri Partners Investment Banking
Kuwait National Investments Company
Mexico BBVA Mexico
Netherlands ABN AMRO
Nigeria Coronation Merchant Bank
Oman Bank Muscat
Pakistan HBL
Taiwan Fubon Financial
Thailand Siam Commercial Bank
Turkey QNB Finansinvest
US JPMorgan Chase & Co
BEST BANKING GROUPS
COUNTRY BANK
Austria BAWAG Group
Brunei Baiduri Bank
Chile Banco Internacional
Denmark Nordea
Dominican Republic Banreservas
Egypt Banque Misr
Finland Nordea
France Crédit Mutuel
Germany Commerzbank
Ghana Zenith Bank Ghana
Hong Kong
HSBC
India Bank of Baroda
Jordan Jordan Islamic Bank
Kosovo BK T
Macau ICBC (Macau)
Nigeria Guaranty Trust Bank
Pakistan Meezan Bank
Saudi Arabia Al-Rahji Bank
Turkey Akbank
UK Lloyds Banking Group
Vietnam Techombank
BEST PRIVATE BANKS
COUNTRY BANK
Afghanistan Ghazanfar Bank
Armenia Ardshinbank
Austria Erste Bank Group
Belgium BNP Paribas Fortis
Brazil BTG Pactual
Bulgaria Postbank
Canada BMO
Cyprus Bank of Cyprus
Czech Republic Raiffeisen Private Banking
Denmark Danske Bank
Dominican Republic Banco Popular Dominicano
France BNP Paribas Banque Privée
Germany Deutsche Bank
Greece Eurobank
Hungary MBH Private Banking
India Kotak Mahindra Bank
Italy BNL BNP Paribas
Kazakhstan FortePremier
Liechtenstein Kaiser Partner
Luxembourg BGL BNP Paribas
Monaco Banque Richelieu

Netherlands Insinger Gilissen
Nigeria First Bank
Norway Nordea Private Banking
Pakistan Easypaisa
Poland Santander Bank Polska
Portugal Santander Private Banking
Romania Raiffeisen Private Banking
Slovakia Tatra banka
Spain Santander Private Banking
Sweden SEB
Switzerland BNP Paribas Wealth Management
Turkey TEB Private Banking
UAE Mashreq
UK HSBC Global Private Bank and Wealth
Uruguay Puente
US BMO
BEST RETAIL BANKS
COUNTRY BANK
Armenia Ardshinbank
Austria Erste Bank Group
Azerbaijan Pasha Bank
Belarus Belarusbank
Belgium Belfius
Bulgaria Postbank
Canada BMO
Chile Santander Chile
Colombia Bancolombia
Costa Rica BAC Credomatic
Denmark Danske Bank
Dominican Republic Banreservas
Finland Nordea
France BNP Paribas
Germany Commerzbank
Greece Eurobank
Hungary
K&H Bank
Iceland Arion
India
Italy
Kuwait
Macau
France
Germany
ICICI Bank
Intesa Sanpaolo
Gulf Bank
BOC Macau
Mexico Banorte
Netherlands ING
Nigeria
BNP Paribas
Deutsche Bank
Hungary OTP Bank
Kazakhstan ForteBank
Macau
GTBank
Norway SpareBank 1
Pakistan Easypaisa
Peru BCP
Poland Santander Bank Polska
Portugal Santander
Saudi Arabia
BOC Macau
Netherlands ING
Nigeria
Zenith Bank
Norway Nordea
Poland mBank
Portugal Banco Finantia
Saudi Arabia Al-Rahji Bank
Singapore
Al Raji Bank
South Africa NedBank
Spain Banco Bilbao Vizcaya Argentaria
Sri Lanka Sampath Bank
Sweden Nordea
UAE Mashreq
UK Lloyds Bank
US Bank of America
Uzbekistan Octobank
BEST COMMERCIAL BANKS
COUNTRY BANK
Austria Raiffeisen Bank International
Belarus Belagroprombank
Belgium BNP Paribas Fortis
Canada BMO
Cape Verde iib West Africa
Colombia Davivienda
Czech Republic CSOB
Denmark Nordea
Dominican Republic Banreservas
OCBC
Sri Lanka Sampath Bank
Sweden SEB
Taiwan Mega International Commercial Bank
Turkey Garanti BBVA
US BMO
Vietnam Techombank
MOST SUSTAINABLE BANKS
COUNTRY BANK
Brazil
Chile
Banco Do Brasil
BCI
China Bank of China
Colombia Bancolombia
Djibouti iib East Africa
Dominican Republic Banco Popular Dominicano
Germany GLS Bank
Macau BOC Macau (Cash Management Services)
Malaysia Maybank
Nigeria
Access Bank
Singapore OCBC
Sri Lanka Commercial Bank of Ceylon
Sweden Handlesbanken
Turkey TKSB

Corporate governance continued to evolve rapidly in 2024, responding to both growing stakeholder expectations and systemic challenges across global markets. According to PwC and the World Economic Forum, companies faced increasing scrutiny over board accountability, climate governance, cybersecurity resilience, and ethical leadership. The line between governance and sustainability has increasingly blurred, with more than 50 countries now mandating climate expertise on corporate boards – a sign of the changing fiduciary landscape. Beyond compliance, leading organisations are embedding ESG oversight into boardroom strategy, aligning remuneration with climate and DEI goals, and fostering diversity of thought. The Parker and FTSE Women Leaders reviews, although UK-specific, reflect a broader global trend: diversity in governance isn’t just a moral imperative – it enhances decision quality and risk oversight. The focus is shifting from box-ticking to authentic engagement, ethical culture, and long-term value creation. Another key development has been the rise of digital governance. As AI and data analytics reshape industries, boards are being challenged to understand and supervise tech risks and opportunities –an area where many still lack sufficient fluency. This year’s award recipients exemplify what modern governance should look like: inclusive, accountable, strategic, and future-focused. Their impact resonates far beyond the boardroom, shaping a corporate world that is better prepared for tomorrow’s demands.
BEST CORPORATE GOVERNANCE
COUNTRY COMPANY
Algeria Mobilis
Angola Etu Energias
Azerbaijan Azercell
Colombia Celsia
Denmark Maersk
Dominican Republic Banreservas
Egypt Commercial International Bank
Finland Valmet
France TotalEnergies
Germany Adidas
Ghana Republic Bank Ghana
Greece TITAN Group
Hungary MOL
India Reliance Industries
Indonesia

The global pension fund sector in 2024 operated at the intersection of long-term responsibility and short-term economic pressures. High inflation, volatile markets, and shifting demographic trends challenged funds to deliver steady returns while maintaining intergenerational equity. According to a report by Mercer, pension funds globally have been rebalancing their portfolios to reduce exposure to underperforming assets and increase resilience in the face of economic shocks. A major theme this year was the acceleration of sustainable investing. The PRI reported that over 90 percent of signatories now incorporate ESG factors into investment analysis and decision-making. At the same time, regulatory expectations have grown more complex. Funds are under pressure to improve transparency, address climate risk disclosures, and demonstrate alignment with international sustainability goals. Technology, too, is transforming how funds manage risk, communicate with beneficiaries, and track performance. Despite these challenges, this year’s winners of the WorldFinancePension Fund Awards 2025 have demonstrated outstanding leadership in the sector.
COUNTRY
COMPANY
Australia Unisuper
Austria
Azerbaijan
Belgium
Bolivia
VAPK Pensionakasse
State Social Protection Fund of Azerbaijan
Anheuser-Busch InBev Nv
BISA Seguros y Reaseguros
Brazil Bradesco Seguros
Canada
Caribbean
Chile
Public Service Pension Plan (Federal)
Scotia Investments Jamaica
AFP Capital (SURA Asset Management)
Colombia Grupo Sura
Croatia
Star Energy Geothermal
Italy Enel
Japan
PBZ Croatia Osiguranje
Czech Republic CSOB
Denmark Danica Pension
Estonia Swedbank
Finland IImarinen
France
Germany
Ghana
Greece
Japan Securities Finance
Jordan Jordan Islamic Bank
Kenya M-Kopa
Kuwait Zain Group
Malaysia MayBank
Mexico Banorte
Netherlands ASML Holding
Nigeria Zenith Bank
Norway Telenor Group
Poland CD Projekt
Qatar Ooredoo Group
Romania Electrica
Saudi Arabia
AG2R La Mondiale
Bosch Pensionsfonds
Pensions Alliance Trust
Piraeus Asset Management
Iceland Lifeyrissjoour Verzlunarmanna
Indonesia BNI
Italy Arca Fondi SRG
Jamaica Scotia Investments Jamaica
Macedonia
Sava Penzisko
Malaysia Gibraltar BSN
Mexico Afore XXI Banorte
Netherlands PGGM
Nigeria
Norway
Saudi Telecoms Company
Singapore UOB
South Africa Discovery
Spain Iberdrola
Thailand TPBI
Turkey Türkiye Sinai Kalkinma Bankasi
UAE Commercial Bank of Dubai
US Chesapeake Utilities Corporation
Fidelity Pension Managers
Oslo Pensjonforsikring
Peru AFP Habitat
Poland
Portugal
Serbia
South Africa
PKO BP Bankowy
SBPI Vida e Pensoes
Dunav Voluntary Pension Fund
Sentinel Retirement Fund
Spain VidaCaixa
Sweden KPA Pension
Switzerland Publica
Thailand
Turkey
US
Kasikorn Asset Management
TEB Asset Management
NYC Board of Education Pension Fund







Sustainability in 2024 remained both a top priority and an immense global challenge. According to the UN’s Sustainable Development Goals (SDG) Progress Report, only 15 percent of targets are currently on track to be met by 2030 – a stark warning that underscores the need for urgent, coordinated action. Climate change-related disasters, including record-breaking wildfires and biodiversity loss, continued to pose serious threats to environmental stability and human health. Yet amid these challenges, there were notable areas of progress. Southeast Asia and parts of Africa made important strides through reforestation efforts and community-led conservation. In the corporate world, sustainability reporting standards became more aligned, with the International Sustainability Standards Board’s (ISSB) global baseline gaining traction among multinational companies. Additionally, financial institutions and corporations increased their commitments to net-zero targets and sciencebased climate action plans. Forward-looking organisations recognised that sustainability is not a side project but a strategic imperative. A 2024 McKinsey study found that companies integrating ESG into core decision-making reported improved resilience and stakeholder trust. However, success depends on credible data, transparency, and long-term accountability – not greenwashing or symbolic gestures. This year’s WorldFinanceSustainability Awards 2025 winners stand out for their ability to lead by example in such a critical domain. They have embedded sustainability at the heart of their operations and are driving real-world impact across environmental, social, and economic dimensions. We honour the leaders in this industry not just for meeting regulatory expectations, but for setting new standards in climate responsibility, social equity, and sustainable innovation. Their work inspires the global shift toward a more resilient and equitable future.
MOST SUSTAINABLE COMPANIES
INDUSTRY COMPANY
Airport Aeroporti di Roma
Asset Management
KBC Asset Management
Automotive Interior Design Antolin
Beauty AS Watson
Computer Hardware Industry
Data Centres
Digital Asset Compute
Engineering
Feminine Hygiene Products
Flag Carrier Airline Turkish
Food Production and Distribution Fresh
For Gender Equality in WealthTech EXANTE
Glass
Hospitality & Leisure Industry
Radisson Hotel Group
Impact Investing Campo
Industrial and Commercial Wood EUCATEX
Logistic
Low-Cost Airline Wizz Air
Marine
Office Furniture
Wärtsilä Corporation
Pharmaceutical Bora Pharmaceuticals
Pulp and Paper
Semiconductors
Stock Exchange (GCC Region)
Telecommunication
Transportation
Travel
Water
Wine Making
Wine
Wellness: Cryotherapy
Preventative wellness is transforming from niche to necessity as recovery technologies such as cryotherapy and oxygen therapy become everyday tools for performance and longevity
WORDS BY Janet Martins MARKETING MANAGER, CTN







technology is designed to make world-class recovery solutions available to everyone –from busy executives combating stress and fatigue, to wellness enthusiasts investing in their future vitality.


Preventative health is no longer an abstract concept – it is quickly becoming the foundation of personal and professional performance. As the global wellness economy surpasses $6trn and continues to expand, businesses, athletes and individuals alike are seeking ways to invest in their longevity, vitality and resilience. At CTN, we have embraced this shift, developing advanced cryotherapy and wellness solutions that make recovery accessible, safe and impactful for everyone.
Historically, recovery treatments such as cryotherapy and hyperbaric oxygen therapy were confined to elite athletic circles and specialised medical facilities. Today, thanks to innovation and technological refinement, these solutions are entering mainstream wellness spaces, corporate environments and even private homes. This democratisation of recovery is setting a new standard for how we care for our bodies and minds – and CTN is proud to be at the forefront of this evolution.
One of the most significant developments in our sector has been the shift from invasive, medically supervised treatments to safe, nonmedical recovery technologies that fit seamlessly into modern lifestyles. CTN’s cryotherapy devices, such as the X°CRYO for targeted cryotherapy and the e°CABIN for whole-body cryotherapy treatments, offer professionalgrade results without the risks associated with traditional liquid nitrogen systems. Our mild hyperbaric oxygen therapy device, OxyPro, and our LedPro red light therapy solution further expand the toolkit for proactive wellness, accelerating recovery, reducing inflammation, and enhancing mental clarity.
Clients today demand more than just onedimensional treatments. They seek comprehensive wellness experiences that combine multiple modalities to deliver faster, longerlasting results. CTN’s technology ecosystem was designed with this integrative mindset. For example, pairing hyperbaric oxygen therapy with whole-body cryotherapy creates a synergistic effect that boosts cellular repair and recovery far beyond what either
treatment could achieve alone. This trend is reshaping not only individual health journeys but also the operational strategies of wellness businesses. Recovery studios, gyms, spas and even corporate wellness programmes are evolving to incorporate these technologies. By offering efficient, automated, and easy-touse devices, CTN enables businesses to stay ahead of this curve – delivering value to their clients while streamlining their own operations. Our solutions require minimal staffing, offer high safety margins, and provide a rapid return on investment, making them an ideal fit for forward-thinking organisations.
Innovation is at the heart of our mission. As the wellness sector continues to evolve, so too must the technologies that support it. At CTN, we are continually researching, developing, and refining our solutions to ensure they align with the latest scientific insights and market needs. Whether through the integration of smart technologies for personalised protocols or through enhanced design for greater comfort and efficiency, we are committed to staying ahead of the curve.
Looking ahead, we foresee a future where recovery technologies are embedded into everyday life, just as fitness and nutrition

Furthermore, the role of recovery technology in preventative health cannot be overstated. As healthcare systems around the world strain under the weight of chronic conditions and ageing populations, a growing emphasis is placed on early intervention and self-care. Recovery modalities such as cryotherapy, oxygen therapy, and red light therapy empower individuals to take proactive steps toward better health, reducing the risk of injury, accelerating healing processes, and improving overall quality of life.
Recovery solutions available to all CTN’s partnerships with elite athletes, such as UFC champion Ilia Topuria and Team Finland’s Olympic and Paralympic squads, have shown that consistent recovery practices lead to measurable improvements in performance and resilience. However, these benefits are not reserved for the world’s best athletes. Our
$6trn
Value of the global wellness industry
WE FORESEE A FUTURE WHERE RECOVERY TECHNOLOGIES ARE EMBEDDED INTO EVERYDAY LIFE
have become integral components of modern living. In this future, recovery is not reactive – it is proactive. It is not about fixing what is broken but about maintaining what is strong. CTN’s cryotherapy and wellness solutions are a blueprint for this future, offering a bridge between cutting-edge science and accessible daily practice. As we move into the next chapter of global wellness, CTN remains dedicated to leading with expertise, innovation, and integrity. We believe that recovery technology has the power to reshape how humanity approaches health and performance – and we are proud to be pioneering that transformation. For those ready to invest in a future of resilience, vitality, and preventative wellness, the journey starts with CTN. n








Carnegie Private Banking is a leading Nordic investment and private bank. We provide tailored wealth management services to private investors and entrepreneurs, along with access to unique investment opportunities and top-rated equity research.
Our long heritage dating back to 1803 gives us the experience to succeed. We have market leading expertise in stock brokerage, tax, law, pension and financial planning. Based on a holistic understanding of our clients’ individual wealth management needs and objectives, our committed team proactively advises them on their entire financial situation.
Carnegie Private Banking is where knowledge and capital connects.
Visit us: www.carnegie.se/privatebanking

Wellness: Therapeutics
A new opportunity for addressing rare GI diseases is being made possible thanks to a plant-based drug, crofelemer, that is coming out of the rainforest and offering fresh hope to people as well as a more sustainable future for pharma
INTERVIEW WITH
Massimo Radaelli PRESIDENT & CEO, NAPO THERAPEUTICS
Can you explain what type of product crofelemer is, and why it may provide a novel therapeutic option for patients with intestinal failure due to MVID and SBS-IF?






Massimo Radaelli, PhD, is a European pharmaceutical industry leader and entrepreneur who has devoted more than 30 years to the innovation of therapies to treat rare diseases. He is President and CEO of Napo Therapeutics, a pharmaceutical company established in Milan, Italy, in 2021 by California-based Jaguar Health to develop and commercialise the plant-based drug crofelemer in Europe, with a particular focus on rare gastroenterological diseases. Radaelli explained to World Finance why a drug sustainably derived from an Amazon Rainforest tree may provide a novel therapeutic option for patients with intestinal failure due to microvillus inclusion disease and short bowel syndrome.
First of all, congratulations on your recent awards. What pleases you most about the recognition?
I am extremely honoured to have been recognised by European CEO as ‘2024 CEO of the Year in the Pharmaceutical Industry,’ and also to have been named ‘Best European Biopharmaceutical Innovator CEO of the Year 2024’ by The European. I believe this latest award – from European CEO (sister brand of World Finance) – recognises once more, at an international level, my lifelong commitment to the research and development of orphan medicines for the care and therapy of patients with rare diseases. I am grateful both for the recognition and to have been able to spend decades focused on helping patients suffering from rare diseases around the world.
Can you tell us about intestinal failure?
Intestinal failure is a condition where the intestines cannot adequately absorb the necessary water, macronutrients – carbohydrates, protein and fat – micronutrients, and electrolytes sufficient to sustain life. Patients with intestinal failure due to the rare diseases microvillus inclusion disease (MVID) and short bowel syndrome (SBS-IF) suffer from devastating diarrhea and dehydration caused by these debilitating, lifelong conditions and

often require total parenteral nutrition (TPN) up to seven days a week for more than 12 hours a day. TPN is a medical feeding method where nutrients are delivered directly into a vein through an IV line, bypassing the digestive system, and chronic TPN use carries the risk of morbidity, infections, metabolic complications, liver and kidney problems and neurodevelopmental delay. Limited therapeutic options exist for SBS-IF beyond TPN, and there are no approved drug treatments for MVID. MVID and SBS-IF are devastating, lifelong conditions. The biggest impact one can have on a patient with intestinal failure is reduction in the quantity and time of TPN. We are always concerned about the quality of life of patients with MVID and SBS-IF, most of whom are children. They are not able to eat or drink and spend most of their waking hours hooked up to an IV.
“The Croton lechleri sap…has a long history of medicinal use by indigenous peoples”
Crofelemer is a plant-based drug sustainably derived from the red bark sap of the Croton lechleri tree – a rapidly growing tree species common in tropical forests of Colombia, Ecuador, Peru and Bolivia. The Croton lechleri sap, commonly known as sangre de drago –which translates to ‘dragon’s blood’ in Spanish – has a long history of medicinal use by indigenous peoples. Crofelemer works by reducing chloride ion secretion into the gut lumen and normalising the electrolyte and fluid balance. It is the active ingredient in Jaguar Health’s FDA-approved prescription drug for the symptomatic relief of noninfectious diarrhea in adults with HIV/AIDS on antiretroviral therapy, and in Jaguar Health’s FDA conditionally approved prescription drug for treatment of chemotherapy-induced diarrhea in dogs. As announced in April, the initial results of an ongoing investigator-initiated proof-of-concept trial of a novel liquid formulation of crofelemer in the UAE show that crofelemer reduced the required TPN and/or supplementary intravenous fluids – collectively referred to as parenteral support – in pediatric patients with intestinal failure due to MVID and short bowel syndrome by up to 27 percent and 12.5 percent respectively. This data also showed crofelemer reduced stool volume output and/or frequency of watery stools, and increased urine output – an indicator of improved nutrient oral absorption.
We are very excited about these initial results. While short bowel syndrome affects approximately 10,000 to 20,000 people in Europe and roughly the same number in the US, MVID is an ultra-rare condition – with an estimated prevalence of just a couple of hundred patients globally. Given this situation, initial results in a very small number of MVID patients showing benefit with crofelemer may allow us to explore pathways for expedited regulatory approval for this indication, including the European Medicines Agency’s PRIME programme and the FDA’s Breakthrough Therapy programme.
Crofelemer is currently the subject of five clinical efforts for MVID and SBS-IF in the US, EU and Middle East regions – two placebo-controlled Phase two studies that Napo Therapeutics is managing, and three investigator-initiated trials. Additional proofof-concept results from investigator-initiated trials are expected throughout 2025. n
WHERE LUXURY IS REDEFINED
WHERE LUXURY IS REDEFINED




































Embark on a rejuvenating journey to a private island hideaway surrounded by sparkling lagoons and coral reefs.
Embark on a rejuvenating journey to a private island hideaway surrounded by sparkling lagoons and coral reefs.



Embark on a rejuvenating journey to a private island hideaway surrounded by sparkling lagoons and coral reefs.



BOOK DIRECT EXCLUSIVE
BOOK DIRECT EXCLUSIVE
BOOK DIRECT EXCLUSIVE
Enjoy USD 1,000 resort credit, daily breakfast and dinner when you stay with us for 4 nights before 30 September 2025
Enjoy USD 1,000 resort credit, daily breakfast and dinner when you stay with us for 4 nights before 30 September 2025
Enjoy USD 1,000 resort credit, daily breakfast and dinner when you stay with us for 4 nights before 30 September 2025
Rates include choice of accommodation, half-board plan, 50% reduction on return speedboat transfer when you book direct. Children under 12 get to stay and dine on us, teens below 18 receive 50% off extra person rate with half board inclusion. Complimentary return speedboat transfers for stays of 6 nights or more.
Rates include choice of accommodation, half-board plan, 50% reduction on return speedboat transfer when you book direct. Children under 12 get to stay and dine on us, teens below 18 receive 50% off extra person rate with half board inclusion. Complimentary return speedboat transfers for stays of 6 nights or more.
Rates include choice of accommodation, half-board plan, 50% reduction on return speedboat transfer when you book direct. Children under 12 get to stay and dine on us, teens below 18 receive 50% off extra person rate with half board inclusion. Complimentary return speedboat transfers for stays of 6 nights or more.
For bookings, please email: reservations@gili-lankanfushi.com or visit gili-lankanfushi.com/offers/book-direct-exclusive/. Terms & conditions apply
For bookings, please email: reservations@gili-lankanfushi.com or visit gili-lankanfushi.com/offers/book-direct-exclusive/. Terms & conditions apply
For bookings, please email: reservations@gili-lankanfushi.com or visit gili-lankanfushi.com/offers/book-direct-exclusive/. Terms & conditions apply


Indonesia’s indomitable finance minister, Dr. Mulyani Indrawati, has shaped the nation’s economic destiny for nearly two decades – steering it through crises, reforms and transformation with steady resolve
Selwyn Parker
FEATURES WRITER





Indonesian finance minister Dr. Mulyani Indrawati is the woman the country can’t do without. Regardless of the party in power, she has overseen the nation’s finances for 16 years and it is unlikely that her long-running reign will come to an end anytime soon.
As the Singapore Straits Times wrote recently, she has “long been regarded as one of Asia’s finest finance ministers.” And she is certainly the longest-serving female finance minister. But there is no doubt that the 62-year-old occupies a hot seat. When she first took office 20 years ago, her desk was piled high with much-needed reforms – and it still is. When she was first appointed in 2005, the country’s economy was in tatters. Indonesia had not fully recovered from the Asia-wide financial crisis and had just been battered by a tsunami and earthquakes that required a heavy injection of capital. The cost of reconstruction of the hardest-hit region, Aceh, alone was $4.5bn, albeit some of that amount was funded through grants.
Attracting foreign investment
Natural disasters aside, Dr. Indrawati had plenty on her plate. The biggest bank, stateowned Mandiri, was mired in corruption and the banking sector in general was inefficient. Poverty and unemployment were high. The sprawling fi nance ministry and Bank of Indonesia was overdue a spring clean. And as the International Monetary Fund reported at the time, one of her top priorities was to implement reforms rapidly and attract foreign investors back to pay for new infrastructure.
Then in 2008 Indonesia was particularly hard-hit by the global financial crisis leading indirectly to the bail-out of an important institution, Bank Century. This turned into one of the longest-running cases in Indonesian financial history. In this highly political
event the details are that the privately owned bank was rescued with state funds in a bid to prevent a run on the entire banking sector. It was not until late 2010 that a corruption commission began investigating the rescue amid arguments that, in summary, it may not have been necessary. It was also alleged that some of the $675m rescue funds may have got into the wrong hands. Ultimately, the ruckus led to her departure from office in 2010 for a six-year stint at the World Bank, where she served as chief operating officer and deputy managing director. It was the World Bank’s gain and Indonesia’s loss.
By then though, Dr. Indrawati had already made a big impression on the economy. In her first five years as finance minister she was fortunate to take office under the reform-minded president Susilo Bambang Yudhoyono, who supported the new broom. As the IMF reported, “the new president has continued and deepened these policies, notably by maintaining a restrained budget stance, replacing managements in state banks in a bid to improve governance, and taking steps to enhance the investment environment.”
Most importantly, Dr. Indrawati knew that the potential of her country of about 285 million people, making it the fourth-highest populated country in the world located in the heart of the fast-growing ASEAN region, was high. It just had to be funded and harnessed.
$286bn
Indonesia’s GDP in 2005
$1.5trn
Indonesia’s GDP in 2025
PRODUCTIVITYDRIVEN, PRIVATE SECTOR-LED GROWTH IS THE CORNERSTONE OF JOB CREATION IN ALL COUNTRIES
Nearly 20 years later, she has been back in the job for a decade and the proof is there for all to see. Indonesia’s economy has been thoroughly overhauled. Debt has been slashed and borrowing costs have consequently declined. Meanwhile, the nation’s wealth as measured by gross domestic product has increased sixfold, jumping from $286bn in 2005 and is heading to nearly $1.5trn by the end of 2025. Though still one of Indonesia’s biggest government departments, the finance ministry has
been streamlined. And as corruption has declined and opportunities increased, foreign investors have returned.
Challenging landscape
It has been a long and sometimes uphill battle. In 2017, just after Dr. Indrawati returned to the job after her six-year period of service at the World Bank, a research paper from the OECD concluded Indonesia still had some way to go: “The quality of public governance, as measured by the World Bank estimate of government effectiveness, puts Indonesia well behind countries like the Philippines, Thailand, Malaysia, Vietnam and Singapore.”

To put things into perspective, Indonesia faced unique challenges. With the population growing by about three million a year, the strain on public finances was considerable – and remains so. Also, people were pouring into the cities at one of the highest rates in the region, which required huge expenditure on infrastructure. Simultaneously, in a far-flung nation, money had to be found for remote poorer communities that needed “basic public services such as sanitation, water, education and health,” the OECD explained.
The dearth of infrastructure was particularly damaging. “Indonesia’s competitiveness (ranked 41st out of 140 countries) is dragged

munities. She hails from relatively humble origins. Born in the Lampung region on the southern tip of the mountainous island of Sumatra to a large family, she attended a mixed public school where, she said in an interview several years ago, the girls never suffered discrimination and were encouraged to ‘reach for the stars.’ And they did; one of her school friends, Retno Marsudi, served for 10 years as Indonesia’s first female foreign minister.
“If one school can produce the first female finance minister and the first female foreign minister in this republic, then our alma mater and its educators must be doing something right,” recalled Indrawati some 40 years later. A diligent student, she went on to obtain a Bachelor of Economics in the University of Indonesia before embarking for the US, where she picked up a master’s degree in policy economics and a PhD from the University of Il-
a nation out of economic mediocrity. In just one example, when she first took office, she established a simple formula in all new appointments at the ministry: at least one woman must be included in every 10 promotions.
“So they were forced to look for female candidates,” she recalled just before leaving the World Bank and returning to her old job. “Good jobs are the surest pathway out of poverty.” That is partly why nearly half of all Indonesia’s small and medium-sized enterprises were jump-started by women.
SHE ENSURED THAT WOMEN WERE AT THE FOREFRONT OF DRAGGING A NATION OUT OF ECONOMIC MEDIOCRITY
“Although women’s participation in the formal sector only reaches 32 percent, their contribution in job creation through SMEs is
2025 as well as the creation of vast rice and sugar cane farms that would enable Indonesia to be more self-sufficient.
The markets have taken fright at the cost of these programmes and, reportedly, his finance minister is resisting. “Speculation grew that Dr Indrawati could resign, with whispers suggesting that she could be replaced by one of three people, including her deputy at the Finance Ministry – Prabowo’s nephew, Thomas Djiwandono,” wrote the Singapore Straits Times. So far Dr. Indrawati is standing firm. “I am not resigning and will continue my role in safeguarding state finances,” she told a news conference recently. “We are here, we are responsible.”
The president’s office hastily denied any talk she would be replaced. But if it does come to a battle, one of the region’s most able finance ministers surely holds all the cards. n

The question of how to teach in times of war has never been more relevant. Rather than shying away from difficult discussions in the classroom, educators should instead equip themselves with skills and strategies for presenting unbiased information and supporting their students’ emotional well-being
The second principle is critical thinking. The first casualty in war is the truth: propaganda abounds and the chaotic, unfiltered world of social media both desensitises users and feeds them ideologically skewed accounts of conflict. Knowing what to trust and how to form an opinion is difficult, and this is why students need to be introduced to an empirical criterion of meaning.
Hence the second strategy is to check your bias and get students to check theirs. Ask yourself what your assumptions are and how you project them, unconsciously or consciously, onto the way you chair discussions and present materials. The job of the teacher is to educate students how to think, not to tell them what to think. For their part, students should always ask themselves what their sources of information are.
The third principle concerns higher order moral imperatives. The teacher’s work is ultimately to lead the discussion to a level that is more general and is transferable to other situations.
WORDS BY Conrad Hughes
DIRECTOR GENERAL, ECOLE INTERNATIONALE DE GENÈVE








One of the most challenging problems of practice that teachers face in schools is how to discuss burning political events, including war. This is especially delicate in international schools, such as the Ecole Internationale de Genève, where many nationalities are represented in the community, sometimes from the very nations at war. There is a temptation to avoid any mention of sensitive events, since schools are not political entities. However, decades of research on preventing prejudice and violence through education remind us that students must be given a space to discuss how they feel. The problem for teachers is how to scaffold such discussions.
In 2020, I led the publication of a UNESCO study entitled ‘Preventing violent extremism through education: from policy to practice,’ with contributions from curriculum experts, psychologists and philosophers. Based on
what came out of this work, I would like to suggest three principles and strategies for educators to consider.
The first principle is that everyone is safe here. Wars create fear, anxiety and distress but also scapegoating, bullying and ostracism. It is the first duty of educators to know their students and the extent to which they might be affected by a conflict. No teasing, accusation, or discriminatory behaviour is ever acceptable, but this message needs to be reinforced in times of war. We should approach children from affected areas openly and check if they are alright. There should be a plan in place so that traumatised children know where to go to if the burden becomes too much.
So, the third strategy is to take discussions to this higher level. This allows students to leave the lesson with powerful syntheses or ‘headlines’ that are philosophical in nature. It also means closing discussions above the confusion of heated positions and moving towards a place of agreement. Sometimes we cannot end with a universal understanding, but instead a lingering universal question.
THE JOB OF THE TEACHER IS TO EDUCATE STUDENTS HOW TO THINK, NOT TO TELL THEM WHAT TO THINK
The first strategy is therefore to create a safe space. Ask students how they are, as a class and individually. Be attentive to their mood and behaviour and give them a chance to express how they are feeling. Use school resources, including psychologists and counsellors, to create a programme to support distressed students.
To assist teachers in this aspect of their work, we are offering a new course at the Ecolint Institute of Learning and Teaching entitled ‘Teaching in Times of Conflict.’ This twosession in-person, one-session online workshop provides educators with various practical strategies. Delivered through expert-led presentations and facilitated breakout sessions, the course covers presenting unbiased information, supporting students’ emotional well-being, answering challenging student questions and reflecting on these practices. Participants will leave with a Certificate of Completion from the Ecolint Institute, recognising their participation and skills development.
The need to look after students and colleagues affected by war is of paramount importance. But avoiding the discussion of global events will not help students to become caring, critical thinkers. Hence the challenge facing us as educators. One thing is for sure, if we do not curate these discussions, social media will do it for us and that will not provide the support needed to nurture critically minded global citizens. n

with our caring cabin crew








Amid rising competition for the thawing Arctic’s resources and strategic dominance, Russia is flexing its technological muscle – an area where it claims an undisputed edge. But is its position more fragile than it appears?

WORDS BY Khatia Shamanauri FEATURES WRITER






When a thunderous Russian voice announces Vladimir Putin’s entrance, the setting is typically expected to be imposing – carefully staged to project power and dominance. But this time was different. As the familiar voice echoed through the hall, the Russian president stepped onto an unexpectedly modest stage. The occasion was an international Arctic forum in Russia’s far northern Murmansk region. Held on March 26–27, 2025, the forum ran under the slogan ‘Live in the North!’ In a lengthy speech, Putin reaffirmed the strategic importance of the Arctic for Russia and emphasised its rising global relevance.
“Unfortunately, geopolitical competition and the struggle for influence in this region are also intensifying,” he said. Putin added that Russia is closely monitoring developments and responding by boosting its military capabilities and modernising infrastructure across the Arctic. The Arctic has ranked high on the Kremlin’s strategic agenda for more than two decades. Following the collapse of the Soviet Union, state support for the region dwindled, and in the 1990s, the Russian Arctic
was largely seen as a socio-economic liability. Substantial reinvestment resumed only in the 21st century. As climate change accelerates the retreat of Arctic ice, new shipping routes and untapped resource opportunities are enhancing the region’s strategic value. Rich in rare-earth elements and home to vast oil and gas reserves – much of which remains underexplored – the Arctic has become central to Moscow’s long-term ambitions. In the wake of Western sanctions over the war in Ukraine, it holds even greater economic and geopolitical significance.
“The Arctic is economically important,” Pavel Devyatkin of the Arctic Institute tells World Finance. “A large share of Russia’s oil, gas and natural resource exports originate from the Arctic.” Around 10 percent of the country’s GDP can be traced to the region. But its significance goes beyond economics. “From a security perspective, the Arctic constitutes Russia’s entire northern border,” Devyatkin adds. “Given the growing competition with Western Arctic states, it is critical for Russia to maintain control over the area and protect those economic projects there.”
According to Russian sources, while other nations pursued maritime expeditions to discover new lands, Russian pioneers advanced steadily overland toward the continent’s northern and eastern edges. Today, the Krem-
lin portrays itself as a global leader in Arctic exploration. But with the Arctic now a frontier of intense competition, a critical question emerges: does Russia possess a technological edge – and if so, can it sustain it?
Sergey Sukhankin, a Senior Fellow at the Jamestown Foundation, believes that –for now – Russia maintains a technological edge over the West in the Arctic. However, he points out that this advantage is mostly limited to one area: icebreakers. “Russia’s main strength lies in its superiority across various classes of icebreakers,” he says. “This includes both civilian vessels, like the Sibir, and socalled military icebreakers – smaller ships that can be equipped with a range of weapons systems, including Zircon and other types of missiles.”
Russia currently operates 42 icebreakers, including eight nuclear-powered vessels, according to Russian media. Prime Minister Mikhail Mishustin recently announced that the fleet will soon be bolstered by five additional nuclear-powered icebreakers. Among them is the Rossiya, a vessel from the ‘leader project,’ boasting a displacement of 71,380 tons and a power output of 163,150 horsepower – capable of escorting ships through ice as thick as four metres.

Of Russia’s GDP stems from the Arctic region
NEW
Speaking at the International Arctic Forum, Putin reaffirmed Russia’s dominance in this field, stating that the country already possesses the largest icebreaker fleet in the world. “No other country has such a fleet,” he declared, adding that Russia must continue to build next-generation vessels, particularly nuclear-powered ones, to consolidate its leadership. While the scale of Russia’s icebreaker fleet is often framed in geopolitical terms, experts emphasise its primarily commercial role. “Icebreakers are one of the greatest technological capabilities that Russia has in the Arctic,” says Devyatkin. “But they have very limited military applications. Even though sea ice is melting, icebreakers are still important for moving through the Arctic because there is still a lot of ice.”
Beyond logistics, Russia has also sought to monetise its icebreaking fleet through tourism. Nuclear-powered icebreakers now ferry travellers to the North Pole, with cruise operators marketing the experience as a unique journey through ancient ice floes. Promotional materials on Russian websites proclaim: “You will be travelling on one of the most powerful nuclear-powered icebreakers in the world, capable of overcoming centuriesold ice up to three metres thick.”
Still, beyond their commercial and even tourism uses, the Kremlin views these vessels
as central to its strategic goals in the Arctic. By enabling year-round navigation through Arctic waters, icebreakers support Russia’s ambition to transform the Northern Sea Route (NSR) into a major global trade artery – one that could ultimately rival traditional shipping lanes such as the Suez Canal.
Strategic asset or symbolic display? Russia’s ambitions in the Arctic are not limited to its formidable icebreaker fleet. During a recent ceremony, Putin hailed the launch of the Perm nuclear submarine – armed with Zircon hypersonic cruise missiles – as a significant milestone in the advancement of the Russian Navy.
“Yasen-M-class submarines are equipped with modern navigation, communication and hydroacoustic systems. They carry high-precision weapons and are fitted with robotic equipment,” the Russian supreme commander-in-chief said. However, some experts remain sceptical about the strategic utility of such weaponry in the Arctic context. Sukhankin argues that, while dangerous under specific conditions, these systems are unlikely to be deployed without triggering full-scale conflict. “In most scenarios, this type of weaponry is more dangerous than it is useful,” he explains. “Its deployment would likely mean an all-out war between Russia and NATO.”
Even within Russian military discourse, the likelihood of conventional warfare in the Arctic remains low. “When Russian strategists talk about potential conflict in the region, they usually refer to hybrid tactics rather than open confrontation,” Sukhankin notes.
The Kremlin also boasts of developing extreme cold-resistant drones capable of operating in harsh Arctic conditions. In parallel, Russia started working on robotic systems to mine the Arctic Ocean floor. In a surprising and ambitious development, Russian media reports that the country is now exploring the use of nuclear submarines to transport liquefied natural gas (LNG). According to these reports, Russia has begun designing nuclearpowered submarines to export LNG from the Arctic to Asia, aiming to significantly reduce shipping time along the NSR.
Sukhankin notes that this idea dates back to the early 2000s, when elements within the Russian business and political elite sought to impress Putin. “The concept was eventually shelved because it could not withstand basic scrutiny from a security standpoint,” he says. “How can you store the necessary
volume of LNG on a submarine in the first place?” Sukhankin asks. “If you run the numbers on break-even costs, it simply does not make sense. What kind of submarine would you build? Russia does not have the capacity to build such vessels – and no one would build them for Russia either.”
He adds that it remains unclear whether this initiative is a genuine project or merely another attempt by Russian elites to curry favour with Putin. “At this point, it’s difficult to tell whether this is aimed at a domestic audience or designed to impress internationally,” he concludes.
In a modest hall in Russia’s Murmansk region, Putin opened his speech not by celebrating Russia’s achievements, but by stressing the urgent need for renewed collaboration with various countries.
“Russia is the largest Arctic power. We have advocated and continue to advocate for equal cooperation in the region,” Putin said. “Moreover, we are ready to work not only with Arctic states, but with all those who, like us, share responsibility for the planet’s stable, sustainable future and are capable of making balanced, long-term decisions,” he added.
Devyatkin points out that Russia has a centuries-long history of operating in the Arctic and possesses deep expertise in resource extraction and navigating the region’s harsh environment. However, he emphasises that cooperation with other Arctic states remains valuable, as these partnerships bring in capital, advanced technologies, and access to export markets.
Some analysts argue that there may be a strategic calculation behind the Kremlin’s cooperative rhetoric. While Russia has demonstrated an edge in certain technologies and weaponry, doubts remain over its ability to sustain systemic production and long-term growth. “Russia’s own internal domestic capabilities to modernise are quite questionable,” says Sukhankin. Accordingly, Russia is seeking greater collaboration to advance its technological ambitions in the Arctic region.
Each time Russia announces the production of new drones, nuclear submarines, or other vessels, alarm grows over Moscow’s apparent lead in this strategic competition. Yet, according to Sukhankin, this perception is deliberately cultivated. “This is exactly what Russians want. If you read the basics of what Russians are writing about information psychological warfare, this is exactly what they mean,” he says. n

As the race for critical minerals heats up, companies and governments have set their sights on the mineral-rich deep sea.
But what is the environmental cost of extracting these resources – and is it really worth the risk? Rachel Richards reports >>
magine diving into the deep blue waters of the open ocean, approximately 500 miles southeast of Hawaii. At first, there would be some sunlight, but this would soon fade as you begin your descent. By about 650 feet, there is no longer enough light for photosynthesis to occur, and by 3,000 feet, light no longer penetrates at all. You have entered a strange new world, one where remarkable creatures have adapted to the crushing pressure and constant darkness.
Once you hit 12,000 feet, you have reached your deepwater destination. This is the Clarion-Clipperton Zone, a vast abyssal plain as wide as the continental US. Little is known about the creatures that live at these depths, with over 88 percent of the region’s species thought to be entirely new to science. But as well as being rich in marine life, the zone is also home to another source of extraordinary value – untapped stores of critical minerals.
According to some studies, the Clarion-Clipperton Zone could contain more cobalt, nickel and manganese than all terrestrial reserves combined, making it an area of extreme interest for mining companies and governments alike. Back on dry land, the global race for critical minerals is heating up. Considered to be the ‘new oil’ powering the international economy, rare earth elements and critical minerals are needed for much of our modern technology, and will be crucial to fuelling the green energy transition in the years to come. As a result, demand for critical raw materials is soaring – and so is competition. In a bid to get ahead in the race to the seafloor, US president Donald Trump recently signed an executive order aimed at fast-tracking deep-sea mining activities in both American seas and international waters. The controversial move has been widely condemned by scientists and environmen-
tal campaigners, who are concerned about the impact of commercial seabed mining on some of our world’s most ecologically important habitats. Yet despite alarm bells ringing on all sides, the Trump administration looks set to forge ahead with activities on the seafloor, in an effort to “counter China’s growing influence over seabed mineral resources.”
But as the US looks to the deep sea as its next geopolitical battleground, it risks sailing into uncharted waters.
For decades, miners and traders have theorised about the mineral treasure trove of the world’s seabeds. Now, for the first time, mining technology might be ready to make their vision a reality. Commercial deep-sea exploration is gaining momentum, with nations including China and India carrying out mining tests in both territorial and international waters. And while commercial-scale seabed mining is yet to begin in earnest, 2025 could be a defining year for the controversial practice.
RARE EARTH ELEMENTS AND CRITICAL MINERALS ARE NEEDED FOR MUCH OF OUR MODERN TECHNOLOGY
Amid the great rush for critical minerals, private companies and politicians are turning their attention to the deep sea, where significant reserves of precious metals can be found in potato-sized ‘polymetallic nodules’ on the ocean floor. First discovered in Siberia’s Kara Sea at the end of the 19th century, these slow-forming nodules contain rich concentrations of metals, including nickel, cobalt, copper and manganese.
The scientific expeditions of the HMS Challenger in the 1870s found evidence of polymetallic nodules in most of the world’s oceans, with clusters covering more than 70 percent of the sea floor in some locations. Now, over a century on from the Challenger expeditions, economic interest in these mineral-rich nodules is gaining traction. ▲

Exploratory deep-sea mining began in the 1970s, and in 1994, the International Seabed Authority (ISA) was established to regulate mineral-related operations on the international seabed. As of 2025, the ISA has granted 31 contracts for ocean-floor exploration, with China, Russia and South Korea leading the pack. Taken together, these contracts cover over 1.5 million square kilometres of the seabed – representing an area four times the size of Germany. With companies working up further plans for full-scale commercial operations, it seems that the race to the bottom of the sea may now be underway, despite concerns that the risks of deep-sea mining are not yet fully understood.
Mining at the earth’s surface is an extremely destructive process. The extraction of minerals from the earth involves extensive clearing of land, and can result in habitat destruction and biodiversity loss, as well as the contamination of soil and groundwater. Once extracted, minerals must then be processed before use – a water-intensive operation that releases carbon dioxide and other greenhouse gases into the atmosphere. If surface-level mining is any indication, the mining process for the deep sea will be both intensive and invasive. Deploying heavy mining equipment on the seabed would disturb delicate ecosystems that have – until now – been largely untouched by human activity. And, with the deep sea holding many mysteries, seabed mining represents a step into a fragile and vulnerable unknown.
500%
Estimated increase in demand for minerals by 2040

$300bn
Estimated boost in US GDP over a 10year period from deep-sea mining
100%
Of the EU’s heavy rare earth metals are supplied by China
31
Contracts for ocean-floor exploration granted by the ISA
12,000 ft
Depth of the ClarionClipperton Zone



The deep sea is the largest ecosystem on the planet, accounting for around 90 percent of our oceans. But its high pressure, constant darkness and perpetual cold conditions make it a challenging environment for us land-based mammals to access, as very few research vessels are capable of surviving the journey into the deep, dark abyss. Despite decades of study, the deep sea remains poorly understood, with 80 percent of our oceans entirely unexplored. What scientists are certain of, however, is the abundance of life in the deep.

It was once thought that life without sunlight was impossible, but the 19th century brought a host of breakthrough discoveries that challenged this long-held belief. Then in 1977, a team of marine geologists made a discovery that would completely redefine our understanding of requirements for life in the deep sea: hydrothermal vents. Found on the ocean floor in more volcanically active areas of the globe, hydrothermal vents can be thought of as underwater geysers, releasing a steady flow of heat and chemicals into the water around them. Here, large clams, humansized tube worms and other unique organisms are able to thrive by converting chemicals from the vents into energy, in a process known as chemosynthesis. Thanks to these underwater hot springs, rich ecosystems are flourishing in even the most extreme conditions. With new organisms regularly being discovered in the deep, scientists now believe that as many as 10 million different species may live in wa-
Production support vessel

800–2,500 metres deep




COBALT CRUSTS

Cobalt-rich ferromanganese crusts


RETURN PIPE rejected mining material is pumped back into the water
RISER PIPE
1,000–4,000 metres deep 4,000–6,500 metres deep







ters deeper than 200 metres. And while life at these depths is plentiful, it is also fragile.
The extraordinary creatures of the deep are delicate organisms, and are more sensitive to change than those living in the shallows. Slight shifts in temperature, oxygen levels or pH can have a significant impact on organisms that have adapted to the stable environment of the deep ocean. Life also moves at a slower pace in the deep, with organisms taking a long time to grow, and recovering slowly from any disturbances. Polymetallic nodules are thought to take tens of millions of years to reach the size of a small potato, with some scientists estimating a growth rate of between one and three millimetres per million years. These nodules are an important habitat for many deep-sea fauna, and their removal or disruption could drastically unbalance this delicate ecosystem.
Above the seafloor, deep-sea mining may have other unintended consequences for marine life. The light pollution from mining vessels could be disruptive and disorientating to organisms that have adapted to minimal sunlight. Ocean noise pollution already impacts how marine mammals communicate and navigate, and increased noise from heavy machinery could further threaten whale and dolphin populations that rely on sound to feed, migrate and reproduce. Discharge and waste products from intensive mining activities could spread over vast distances, posing a
SEAFLOOR MASSIVE SULPHIDES POLYMETALLIC NODULES
threat to open ocean fish. Plumes of fine sediments are already known to damage respiratory and feeding structures in fish, and could easily be stirred up by collector vehicles working on the seabed. While the full impact of mining this vast and mysterious environment is still uncertain, it is clear that it would have significant and long-lasting consequences that stretch far beyond the seafloor.
Even as scientists and campaigners sound the alarm bells on deep-sea mining, interest in the controversial practice continues to grow.
In April, President Trump signed an executive order to increase seabed mining activities in US and international waters, marking his latest bid to increase America’s access to critical minerals.
The order, which is unprecedented in its support for the practice, directs federal agencies to expedite the process for reviewing and issuing permits for mining the seafloor, both in US waters and in “areas beyond national jurisdiction.” Once implemented, the order will make it easier for private companies to begin commercial mining operations in earnest – essentially allowing them to proceed outside of any international frameworks.
While the ISA has set regulations on seabed mining, the US is the only major global economy that is not a member of the organisation, and does not recognise its authority. For

years, the ISA has been working on a mining code, which would set further international standards for deep-sea mining operations. This long-delayed code would require all seabed mining activity to adhere to rules on waste products, discharge depths and environmental mitigations when occurring in international waters. The organisation is set to meet in July of this year, with a view to finalising its code, but Trump’s executive order gives little heed to these ongoing negotiations.
In fact, the order appears to bypass any burgeoning multilateral agreements on deepsea mining, in a move that China says violates international law. “The US authorisation violates international law and harms the overall interests of the international community,” Chinese foreign ministry spokesman Gu Jiakun said after the order was signed.
And China is not alone in its criticism of Trump’s push into international waters. The executive order puts the US at odds with the rest of the world on this issue, as mounting environmental concerns have started to curb initial enthusiasm for the controversial practice. In December, the Norwegian government announced a one-year pause on its plans to start mining its seabed, after previously voting overwhelmingly in favour of launching seabed operations. Elsewhere, more than 30 countries – including Germany, Spain, Canada and the UK – have called for a 10-year moratorium on the practice, while French president Emmanuel Macron has backed a complete ban on deep-sea mining. A growing

number of private companies also support a pause on seabed mining activity, with car manufacturers such as BMW, Renault, Volvo and Volkswagen all pledging not to use deepsea minerals in their vehicles. Tech giants Google and Samsung have also announced their support for the global moratorium, promising not to use seabed minerals in their supply chains until the environmental risks are “comprehensively understood.”
Amid these growing calls for caution, the US is set to take a very different path. But even as the Trump administration gears up to fasttrack permits, the economic merits of deepsea mining are still far from clear.
Need or greed?
Supporters of deep-sea mining argue that they are motivated by economic necessity. It is true that the global demand for minerals is growing, and access to raw materials is becoming increasingly politicised in this new era of heightened US protectionism. By some estimates, demand for minerals could increase by nearly 500 percent by 2040, as countries race to scale up their decarbonisation efforts. Yet it is important to remember that demand forecasting is not an exact science. Projections are subject to highly changeable factors, including economic shocks and shifting consumer
demand. The future needs of the rapidly evolving technology sector are particularly difficult to predict, given the current pace of change. Advances in artificial intelligence, machine learning and robotics have increased the pace of change tenfold, making long-term demand forecasting ever more challenging for analysts.
Indeed, despite warnings of a global scramble for lithium, nickel, copper and cobalt, supply has largely outstripped demand in recent years. Global production of lithium hit a new high in 2024, but weaker-thanexpected demand for electric vehicles contributed to a surplus of almost 154,000 tonnes of the mineral last year alone. Similarly, a boom in the Indonesian nickel industry has seen three consecutive years of oversupply, and nickel prices have almost halved since 2022 as a result. Production of cobalt continues to exceed demand, with prices plummeting to their lowest level since 2016, while the copper market is facing its largest glut in four years.
▲
THE ECONOMIC MERITS OF DEEPSEA MINING ARE STILL FAR FROM CLEAR
facturers are now moving towards battery designs that use more sustainable elements. Tesla, the world’s second-largest manufacturer of electric vehicles, already uses cobaltfree batteries in half of its fleet, while other leading firms are pioneering their own new battery chemistries. Recycling technologies are also becoming ever more efficient, helping to relieve pressure on future demand for critical minerals. According to the International Energy Agency (IEA), a successful scale-up of mineral recycling could reduce the need for new mining activity by 25 to 40 percent by 2050.
Along with overproduction, shifting trends in the tech sector have impacted the global minerals market of late. Cobalt has traditionally been a key component in many electric vehicle batteries, but some manu-
In EV production and beyond, these shifts are having a significant impact on mineral supplies, prompting analysis to question whether deep-sea mining is really necessary to meet demand. Studies indicate that there is no real shortage of mineral resources on land, but for some proponents of seabed mining, the economic lure of the deep sea is hard to resist. The Trump administration estimates that deep-sea mining could boost US GDP by $300bn over a 10-year period, and create approximately 100,000 jobs. Even if this vision is realised, however, any economic benefits will surely come at a great environmental cost.

As mining companies ready themselves for their first deep-sea operations, it is becoming increasingly clear that the race to the ocean floor is as much about political power as economic necessity. On dry land, Beijing dominates global supply chains of critical minerals and rare earths. According to the IEA, China accounts for 61 percent of rare earth mineral production and 92 percent of their processing, giving it a near monopoly over the supply of some of the world’s most valuable raw materials.
“While the Middle East has oil, China has rare earths,” the former Chinese leader Deng Xiaoping famously declared on a visit to one of Inner Mongolia’s largest mineral mines. Since the 1980s, China has been ramping up its rare earth mining activities. Decades of statebacked investment in its domestic processing industry have established China as the global leader in critical minerals, able to effectively decide which countries and companies receive supplies of these crucial resources.
Amid the ever-escalating US-China trade war, Beijing has dramatically curbed its mineral exports to the US, revealing just how dependent America is on these vital imports. Across the Atlantic, meanwhile, the EU is similarly reliant on China for many critical
minerals, including 100 percent of its heavy rare earth metals. In an era of heightened geopolitical tension, this high level of dependency leaves the bloc vulnerable and exposed to global economic shocks.
While the EU and the US are both looking to become more self-sufficient in mineral extraction and processing, it will be difficult for any major power to challenge China’s dominant position in the critical mineral sector – at least at sea level. By setting its sights on the ocean floor, the Trump administration may be seeking to reshape the balance of power on the global stage.
“We want the US to get ahead of China in this resource space under the ocean, on the ocean bottom,” a US official told the BBC upon the signing of the controversial order.
▲
ISA, opening up the international seafloor to potential exploitation.
The 1982 United Nations Convention on the Law of the Sea recognises that the ocean floor is ‘the common heritage of mankind,’ and that it is ‘beyond the limits of national jurisdiction.’ Significantly, the US stands alone as the only major economy that has not ratified the treaty, and now appears to be creating its own rules on exploiting seabed resources. If other nations follow suit and break with the Law of the Sea treaty, then a scramble for the international seafloor could commence.
In the ongoing Sino-American trade war, the international seabed could become the next geopolitical arena. Until now, deep-sea mining tests have followed the ISA framework, but Trump’s executive order may set a new precedent. If implemented, the order could allow commercial companies to effectively bypass the multilateral regulations imposed by the
Our oceans make all life on Earth possible, and are home to delicate ecosystems that we are just beginning to comprehend. The exploitation of these resources is not just an economic question – it is an existential one. As companies ready themselves to take the plunge, we risk causing irreversible damage to the very heart of our planet. Whether we are willing to further endanger the health of our oceans for the sake of winning the minerals race is something all nations ought to carefully consider. The fate of entire ecosystems depends on the decisions we make today – and there is no going back. n
Misinformation is no longer a fringe concern for companies – it is a fast-moving, reputation-wrecking force. As false narratives go viral, organisations must act swiftly to detect, counter and contain the damage
Neil Hodge FEATURES WRITER






Until recently, the chances of a company suffering any lasting damage due to a deliberate misinformation campaign were so low as to not even be included on the corporate risk register. But not anymore. Now, companies can see their share value nosedive overnight if a lie gains enough traction that customers boycott a company’s products and services over fabricated fears that they are unsafe, are made unethically, are of poor quality, or even linked to extremist groups.
The seriousness of the spread of false information should not be downplayed. The World Economic Forum’s (WEF) latest Global Risks Report cites government misinformation and disinformation as one of the key leading short-term risks that could fuel instability and undermine trust in authority. But it also warns that this growing trend could have a negative impact on corporates: for example, misinformation and disinformation around some industries could stifle growth and sales. For sectors like biotech, this is a serious problem, with biohackers and other non-medical professionals touting ‘unproven’ health remedies or performance-enhancing procedures and slamming ones that actually work, are regulated and are safe.
Furthermore, the WEF warns that some governments may foment aggressive misinformation and disinformation campaigns about goods and services from targeted countries, hardening public perception that could lead to more frequent consumer boycotts of products – hardly a welcome development in an era of increased geopolitical tension that has already spilled over into trade wars and spiralling tariffs. AI could exacerbate consumer boycotts further, it warns, as algorithms programmed to highlight trending or popular content could prioritise reader engagement over accuracy and unintentionally promote misinformation in the process.
Unfortunately, companies can’t necessarily count on the law to correct falsehoods, remedy reputational damage, or regain financial loss, as it is supremely difficult to hold any person or company to account for spreading misinformation via the internet or social media sites. In the US, for example, online platforms are immune from civil liability for content provided by their users under Section 230 of the US Communications Decency Act. It also shields them from moderation activities that they undertake in good faith to remove certain content. And pursuing defamation claims in the US – or anywhere else – to try to right wrongs and gain financial redress is another costly gamble that not many organisations can consider.
Deliberate sabotage
“At its worst, deliberate deception has the potential to destabilise or create financial or reputational damage,” says Ant Moore, a senior managing director in strategic communications at business consultancy FTI Consulting. “Where misinformation is often fuelled by false information (a doctored photograph or an impersonated voice, for example), disinformation is characterised by a more deliberate attempt at sabotage. In all cases, literacy around determining fake content isn’t always where it should be.”
There are a range of ways misinformation can threaten companies. Besides consumer boycotts, false narratives can quickly shape public perception and erode brand trust, leading to loss of investor confidence and reputational harm. It can also lead to disengaged and polarised workforces, resulting in employees leaving or refusing to join organisations they believe are misaligned with their values. Misinformation campaigns that target specific industries can also create increased legal and regulatory scrutiny as authorities, shareholders and stakeholders demand increased assurance.
Some high-profile companies have already experienced problems. In 2016 the sportswear company New Balance faced considerable backlash on social media after misinformation circulated that the brand was closely aligned with far-right movements. Similarly, in 2022 Eli Lilly’s stock price fell by 4.37 percent after a fake Twitter account impersonating the pharmaceutical brand falsely announced that insulin would be given away for free (as opposed to the $1,000 monthly pricetag it could cost some US citizens without health insurance at the time). In 2023 the CEO of brewer Anheuser-Busch InBev Michel Doukeris blamed misinformation on social media for stoking a conservative consumer boycott of Bud Light that saw sales drop by a quarter after the best-selling US beer was promoted by transgender influencer Dylan Mulvaney.
“When it comes to the risk posed to corporates, the only surprise is that this hadn’t come sooner,” says Chris Clarke, co-founder of strategic comms agency Fire on the Hill. “Companies have been operating in an increasingly complex and globally connected landscape, with new forms of media growing in prominence. It makes information impossible to control and makes identifying trustworthy information from reliable sources harder than ever.”
Clarke continued: “In the current information environment – chaotic, fragmented and lacking in trust – the ground is fertile for misinformation to go viral and bad actors to purposely spread misleading and false information. Whether those bad actors are foreign governments targeting the economic interests of other states, activist groups, or competitors, deploying strategies to mitigate risks should be a top priority.”
Given the speed at which false stories can be created with AI and proliferate and spread on social media, experts say companies need to learn how to proactively monitor for malicious stories in real-time before they spiral out of control. The challenge, however, arises in how companies currently monitor for these sorts of malicious attacks. “Historically, communications and PR teams have focused their attentions on tracking comments and trends across mainstream social media such as X, Instagram or TikTok,” says Rebecca Jones, as-

sociate director of client accounts at business intelligence firm Sibylline. “However, that is not where these disinformation campaigns begin, and arguably, by the time disinformation hits these sites, the issue has already gone viral and you are in crisis.”
More often than not, says Jones, disinformation begins on alternative social sites, where the audience is more likely to react to a story that may seem a little unbelievable, but which triggers emotions: indeed, an issue can sit in this ecosystem slowly being refined and gathering momentum over the course of hours, days or even weeks before it migrates to mainstream and goes viral. Monitoring these sites for potential threats can be a game changer, as it can help teams to get ahead of a potential crisis before it takes place.
“Even if it can’t be stopped – which is usually the case – hopefully such an early warning mechanism enables teams to have a plan of action in place for when it does hit the mainstream: your executives are prepped, the press team is ready to respond, and perhaps you have even taken steps to pre-bunk the story,” says Jones.
Chris Walker, managing director of Be The Best Communications, says companies should make sure they control their own narrative. “Facts are more impressive than fiction. Gather your evidence which disproves the claim and which highlights your organisation’s commitment to doing the right thing,” he says. Companies should also challenge the source of fake news to reveal what evidence they have to back up their claim: if they can’t ‘put up,’ they may ‘shut up.’
Alice Regester, Co-founder and CEO at specialist communications agency 33Sec-
YOU
onds, agrees that it is increasingly important for companies to control and have access to channels of communication to quickly debunk falsehoods. “The value of information companies are sharing via their owned channels is increasingly important,” she says, adding that this is a good way to “ensure they are building a voice of trust and authenticity on both websites and blogs, as well as social media channels, so consumers know they can come directly to the brand for the truth.”
Having friends is also a very useful weapon to deflect malicious claims, say experts: it can certainly pay for companies to identify potential spokespeople outside of their organisations who can be called upon to help push back against false narratives. Businesses can collaborate with customers, fact-checking organisations, consumer advocacy groups, and trusted media to amplify credible information. Building an influencer programme can also be a good way for companies to protect themselves, says Adam Blacker, PR director at website hosting information site HostingAdvice.com. “It is really hard to do everything yourself. You need to build a strong community of fans who love and support your brand. They in turn become brand ambassadors,” he says. So-called ‘social listening’ tools – essentially, software applications that companies can use to continuously scan social media sites for mentions of their name, brands, and
industry trends – are also fast becoming critical solutions. By analysing conversations in real time, companies have the advantage of being able to verify and fact-check claims early enough to take action.
Andy Grayland, CISO at threat intelligence tech company Silobreaker, says traditional crisis management approaches are no longer sufficient – companies must transition from reactive damage control to proactive defence.
“Cyber threat intelligence (CTI) solutions provide that necessary early-warning system. By continuously monitoring brandrelated risks across open-source intelligence (OSINT), including news sites, forums, social media, and the deep web, organisations can detect and neutralise threats before they escalate,” says Grayland. “AI-powered tools are now essential for cutting through the noise, identifying real risks, and flagging coordinated disinformation campaigns before they gain traction,” he adds.
As an example, such monitoring would detect and alert a pharmaceutical company if an anti-vaccine movement that normally averages 50 mentions of a particular drug brand a day suddenly increases that number to 500. By tracking the influencers behind these kinds of movements in real-time and identifying shifts in narratives relating to a company or brand, companies have a better chance of either engaging strategically or correcting the narrative.
Early detection translates into real business value, says Grayland. “With real-time visibility into emerging threats, businesses can mitigate financial losses, prevent reputational crises, and stay ahead of regulatory and shareholder concerns. In a world where disinformation spreads at the speed of social media, CTI tools provide the radar and response capabilities needed to protect brand integrity and the bottom line,” Grayland says.
While experts say that misinformation and disinformation are hardly new challenges, they add that their impact on companies has become far more acute – thanks to the scale and speed at which they can spread. “Businesses have always been vulnerable to false narratives, but the digital age and AI has turbocharged that risk,” says Ryan McSharry, crisis specialist at international PR agency Infinite. The difference now, he says, is the sheer volume and immediacy with which misinformation can erode trust and disrupt markets, making it a much more potent threat to a company’s reputation.
“The question isn’t whether companies should be concerned – it is how they should be responding,” McSharry warns. n
Once a golden ticket to growth, the subscription model is showing signs of strain. As consumers tire of mounting monthly fees, businesses face rising churn and a critical moment of reckoning. Is the golden era of recurring revenue over?
WORDS BY Vikki Davies
FEATURES WRITER






For more than a decade, the subscription model has reigned supreme. From streaming giants like Netfl ix to SaaS start-ups and direct-to-consumer services, recurring revenue has become the holy grail for business models across sectors. Investors love the predictability, companies value the customer loyalty it fosters and consumers, at least initially, embraced the convenience.
Now it appears that subscription fatigue is setting in. The term coined to describe consumers’ growing reluctance to engage with an ever-expanding roster of recurring payments is fast becoming a concern for business leaders and investors. With consumers re-evaluating their digital wallets and churn rates on the rise, it is time to ask: Has the subscription economy peaked? Or is this merely a necessary recalibration in a maturing market?
From innovation to saturation
The success of the subscription model was once considered a sign of forward-thinking business acumen. The model delivered steady income streams, customer loyalty and higher lifetime value. It transformed product categories, turning everything from software and entertainment to pet food and razors into services. Between 2012 and 2022, the subscription economy grew by more than 435 percent, according to data from Zuora’s Subscription
Economy Index. SaaS companies like Salesforce and Adobe became household names. Traditional businesses rushed to pivot. Even carmakers began experimenting with subscription-based access to vehicle features.
But as the model scaled, cracks began to show. What started as a convenience, a singleclick, monthly bill for services we used regularly has become, for many, an overwhelming tangle of micro-payments. The average consumer today manages anywhere from six to 12 paid subscriptions, depending on geography and age group. The mental load is growing. And so is the frustration.
A recent academic paper published at the Proceedings of the third International Conference on Optimisation Techniques in the Field of Engineering (ICOFE–2024) takes a deep dive into the subscription phenomenon. Titled ‘Statistical Analysis of Subscription Fatigue: A Growing Consumer Phenomenon,’ the study by Sunori, Mittal and Gangola investigates the psychological and behavioural triggers behind subscription fatigue.
The authors identify three key drivers: lack of perceived value, hidden or unpredictable fees and loss of control. As more companies adopt subscriptions, the uniqueness of the model has eroded. Many users now feel they are paying regularly for content or services that deliver little incremental benefit. Consumers also increasingly report frustration with tiered pricing, automatic renewals and freemium models that lead to unexpected charges.
Finally, the inability to manage or track multiple subscriptions easily contributes to a growing sense of overwhelm, leading to attrition. Combined, these factors erode loyalty and trust, two foundational elements of the subscription promise.
The numbers behind the trend
While full-scale collapse is unlikely, the subscription economy is clearly entering a more mature and arguably more volatile phase. A 2024 report from Antenna, a subscription market analytics firm, revealed that churn rates for video-on-demand services reached an all-time high of 44 percent in Q4 2024. SaaS businesses, too, are seeing rising customer acquisition costs and declining net revenue retention, a double hit that undercuts the long-term profitability of the model.
Consumer surveys tell a similar story. According to the UK’s Department for Business and Trade who have launched a consultation on measures to crack down on what they call ‘subscription traps,’ nearly 10 million of 155 million active subscriptions in the UK are unwanted, costing consumers £1.6bn a year.
AS MORE COMPANIES ADOPT SUBSCRIPTIONS, THE UNIQUENESS OF THE MODEL HAS ERODED
Business Secretary Jonathan Reynolds said: “Our mission, which is tackling subscription traps that rip people’s earnings away, is an important part of that. Everyone hates seeing money leave their account for a subscription they thought they had cancelled, or a trial that unexpectedly

Growth in the subscription market between 2012 and 2022
THE
gets extended. We are looking to hear from as many businesses, consumer groups and other interested groups as possible to allow us to set fair regulations that stop this corporate abuse of power while retaining the benefits of subscriptions for consumers and businesses.”
Deloitte’s 19th annual ‘Digital Media Trends’ report also found that consumers are increasingly dissatisfied with the value of paid streaming services. Even though 53 percent of consumers surveyed say that streaming video on demand services are the paid media and entertainment services they use most frequently, almost half (47 percent) say they pay too much for the streaming services they use, and 41 percent believe the content available on these services is not worth the price (up five percent from 2024). A price hike of $5 would be likely to make the majority (60 percent) of consumers cancel their favourite service.
And while the cost-of-living crisis in parts of Europe and North America certainly contributes, the deeper issue is structural: subscriptions are no longer novel, and consumers are becoming more discerning about where they spend their monthly budgets.
Importantly, not all subscription businesses are experiencing the same levels of fatigue. Some have weathered the storm better than others. The difference lies in how well the service aligns with customer value and how flexible the business is in responding to changing expectations. Services that are truly integral to daily life, such as productivity tools like Microsoft 365 and Dropbox, health and wellness
platforms like Strava, or high-engagement entertainment like Spotify or Disney+ tend to maintain stronger retention. These companies have invested heavily in clear pricing and cancellation policies, personalised content or features and frequent, visible product updates. Crucially, they make it easy for customers to understand what they are paying for, and why it is worth it.
On the other end of the spectrum, many niche services or companies with minimal product differentiation are struggling. Despite having 45 million subscribers, Apple TV+, for example, reportedly incurs over $1bn in annual losses. The platform captures less than one percent of total US streaming viewership, lagging behind competitors like Netflix. High production costs and limited audience engagement contribute to this subscription model’s financial struggles.
Amazon Prime is also struggling. The introduction of additional advertisements in 2025 has led to subscriber dissatisfaction. Users now need to pay extra to avoid ads, prompting some to consider cancelling their subscriptions. Companies like Garmin and Polar have introduced subscription fees for features that were previously free, also leading to user backlash. Consumers have expressed frustration over paying for functionalities that were once included with device purchases.
The era of ‘everything-as-a-subscription’ from digital fitness classes to premium recipe apps is being ruthlessly culled by consumer pragmatism. Likewise, businesses that rely on passive engagement (the assumption that users will forget to cancel) are seeing that strategy backfire. With fintech tools and banking apps now offering subscription tracking and cancellation features, the days of accidental renewals are coming to an end.
Is this the end of recurring revenue?
Not quite. But it is the end of blind faith in the model. The golden era of subscriptions was driven by novelty and investor enthusiasm. But like all financial trends, the hype curve eventually levels off. What is left is a need for quality and sustainable economics.
Investors, once obsessed with monthly recurring revenue, are now scrutinising unit economics more closely. What is the actual cost to acquire and retain a subscriber? How long does it take to recoup that investment? And is the model still viable without aggressive discounting?
Subscription businesses are being pushed to evolve. In many cases, that means offering
hybrid models that combine one-time purchases with added subscription perks and creating modular pricing tiers that better reflect real usage patterns. Rather than chasing pure subscriber volume, companies are increasingly focusing on metrics like net retention and user engagement. This evolution mirrors a broader shift in the digital economy, from a growth-at-all-costs mentality to a more responsible, resilient approach to long-term success.
A recent study by research agency 2CV highlights growing consumer frustration with subscription models and how to build trust and long-term loyalty, suggesting that providers must focus on clear and consistent communication.
As the report notes: “Subscription providers need to properly understand their subscribers, what are their expectations, their preferences, wants and needs? Really knowing your audience and aligning subscription plans to their preferences can help retain consumers, build loyalty and prevent them from cancelling in preference for more appealing offers elsewhere.”
For financial professionals and corporate strategists, the implications are significant. Key questions for subscription-based businesses today include whether their model genuinely reflects real consumer value or if it is simply propped up by customer inertia. They must also consider what safeguards are in place to protect against churn shocks, particularly during economic downturns. Agility in adjusting pricing and packaging is critical, as is ensuring that KPIs and dashboards measure the quality of retention, not just the number of subscribers.
It is also a moment to re-assess valuation models. Recurring revenue still offers stability, but the premium investors have placed on the model may need recalibrating. In short: it is no longer enough to have subscriptions; you must have subscribers who stay.
Much like the evolution of e-commerce or mobile apps, the subscription model is entering a new phase where survival depends on depth, not breadth. Companies will need to earn their recurring revenue every month, not assume it. The future of subscriptions lies in trust, transparency and tangible value. Those who listen to consumer signals and respond with clarity, flexibility and innovation will not only survive this phase, but thrive in it. And for the rest? The unsubscribe button has never been easier to find. n

Many a player in the airline industry describe carbon offsetting as the holy grail of eco-friendly flying. Having already implemented a number of initiatives across far-reaching projects, Turkish Airlines begs to differ, proposing a more multi-pronged approach
WORDS BY Ahmet Bolat
CHAIRMAN OF THE BOARD, TURKISH AIRLINES
offset their carbon footprint with ease. Supported projects – all of which are internationally recognised gold standard and VCS-certified – include renewable energy generation, ecosystem restoration and community-based initiatives, enabling passengers to actively contribute to a more eco-friendly world.
To offer a more detailed rundown of these initiatives, the ‘renewable energy’ projects revolve around wind, solar and hydroelectric power to reduce fossil fuel consumption, while the ‘ecosystem restoration’ category helps to preserve natural ecosystems, increasing carbon sequestration capacity for long-term impact. The third in the family of initiatives – ‘community care’ – provides fuelefficient stoves in developing regions to reduce carbon emissions and improve local communities’ quality of life.



‘Sustainable aviation’ is increasingly in the spotlight, and for good reason. But working towards this important goal is far from simple. At Turkish Airlines, we see it as a comprehensive and realistic approach to minimising our environmental impact – but there is no denying that carbon offsetting alone is insufficient. The issue has to be tackled from multiple angles. In our case the pillars are: the integrating of fuel efficiency, operational improvements, fleet renewal and the adoption of sustainable aviation fuels (SAF). In short, we strive to integrate sustainability into our operations and engage passengers through user-friendly platforms such as CO₂mission.
Carbon footprint-reducing measures
As mentioned above, our sustainability approach is multi-pronged and we have worked hard towards it for many years, long before ‘sustainability’ was the buzzword it is today. Since 2008, Turkish Airlines has implemented over 100 operational optimisation projects aimed at increasing fuel efficiency. In 2024 alone, these projects resulted in approximately 70,000 tons of fuel savings and prevented more than 220,000 tons of CO₂ emissions. Our fuel saving committee and
advanced fuel management information systems help ensure continuous improvements. We have made significant progress but our primary focus remains the same, namely to keep fine-tuning operational efficiency and promoting the use of SAF.
Elsewhere, we have initiated projects such as ‘statistical contingency fuel’ to minimise excess fuel carriage on flights using data analytics. Additionally, we have phased out single-use plastic cups, introduced FSCcertified paper products and adopted lighter cabin equipment to reduce weight and fuel consumption. Collectively, these initiatives enhance both operational efficiency and environmental sustainability.
We have noticed that projects that offer social benefits, such as the community-based cookstove initiatives, have been particularly popular, achieving increased overall engagement. It is evident that passengers appreciate seeing tangible impacts from their contributions. As for the physical in-flight experience, we strive to create awareness through sustainable practices such as digital menus and the use of biodegradable products. These initiatives aim to motivate passengers to become more environmentally conscious – whether they happen to be on a plane or elsewhere.
Without a doubt, the limited availability and high production costs of SAF pose the biggest challenge for our industry. In 2024, SAF accounted for only about 0.3 percent of global jet fuel usage. Scaling SAF production and making it economically viable requires extensive collaboration across the aviation sector, significant investments and supportive policies.
220,000
Tons of CO2 emissions prevented in 2024
It is imperative to motivate passengers on sustainability and there are a number of ways to go about this. To engage our passengers, we have developed a dedicated hub – the CO₂mission platform. Though this multifunctional platform does not eliminate carbon emissions directly, it provides passengers with a transparent and verified system, encouraging them to contribute to global climate action. In order to inspire passenger participation, we have put a lot of effort into creating a platform with a user-friendly interface, allowing them to calculate and
As for our own ongoing efforts, we are fully invested in our mission to reduce our environmental impact and will accelerate our sustainability initiatives with the goal of becoming a carbon neutral airline by 2050. To go about this, we will make full use of the multifaceted strategy we have developed over the years – and as ever continue to improve it. The areas of focus involve the increased use of sustainable aviation fuels, continued fleet modernisation and the expansion of datadriven fuel optimisation projects. Additionally, we have published our comprehensive ‘climate transition plan.’ Complacency has no place in the fight for the environment, and Turkish Airlines is determined to continue to invest in new technologies to further reduce our environmental footprint. n

Each year, Wonosobo’s sky fills with colour as hundreds of hot air balloons rise in celebration of Eid al-Fitr. First held in 1950, this cherished festival blends faith, folklore, and eco-conscious creativity, with most balloons crafted
from recycled paper and secured by ropes. In 2025, over 700 balloons soared above Central Java, drawing an estimated 120,000 visitors. This large surge in tourism boosted local hospitality and retail revenue by 18.5 percent
compared to 2024. With 75 percent of the floating displays made from sustainable materials, the event also highlights the growing synergy between heritage tourism and environmental responsibility in Southeast Asia.
An aerial image shows hot air balloons, mostly made from recycled paper and tied with ropes, in Wonosobo, Central Java, Indonesia
The
Local tourism revenue increased by 18.5% during the festival week
Event dates back to 1950 — one of Southeast Asia’s longest-running Eid traditions
Autonomous aircraft are fast becoming a reality as global aviation growth accelerates. From cargo drones to air taxis, aerospace leaders and tech startups are racing to transform the future of flight
WORDS BY Indrabati Lahiri FEATURES WRITER







The global aviation industry has seen a number of developments in the last few years, such as more sustainable and green travel, electric aircraft and better maintenance, repair and overhaul (MRO) technology. The International Air Transport Association (IATA) expects total global airline industry revenues to reach $1.01trn in 2025. If so, this will be the first time that the industry’s revenues surpass the $1trn barrier, while also being a 4.4 percent rise from 2024.
Passenger numbers are likely to touch 5.2 billion this year, which would be an increase of 6.7 percent from last year. Cargo volumes are estimated to rise 5.8 percent on an annual basis and hit 72.5 million tonnes as well. This expected growth in the global aviation sector has led to several aerospace and tech companies attempting to develop autonomous airplanes.
At the moment, major sector giants such as Boeing, Airbus, Lockheed Martin and Northrop Grumman, as well as innovative tech start-ups such as Whisk, Joby and Elroy Air, are working on developing autonomous flight technologies and systems. Countries with strong government funding, sophisticated aerospace ecosystems and strategic defence priorities, such as China, the US and some EU nations, are leading this development.
The timescales involved
Although vehicles with varying degrees of autonomy have become more common recently, fully autonomous cars (level five) are not commercially available to the general public as yet. Similarly, fully autonomous airplanes could still take several years to be available on the open market, although related technologies such as automatic target recognition have been operational for a while now. Autonomous military and speciality unmanned aerial vehicles (UAVs) or drones have also been functional for years. Dan Bubb, aviation historian and associate professor in residence, UNLV
Honors College, noted: “There is no doubt aviation technology continues to make giant leaps including in automation. Some businesses predict that autonomous aircraft will dominate aviation by the 2040s. I can envision that in the military, cargo, and general aviation sectors.”
Dr. Walter Stockwell, vice president of Engineering at ANELLO Photonics, also expects autonomous aircraft versions to be more adopted in surveillance, specialised missions and cargo in the near term, with broader commercial passenger applications likely to happen in the next 10–15 years. “Hybrid models combining autonomy with human oversight could be dominating the skies by the early 2030s,” Stockwell said.
The Covid-19 pandemic, ongoing RussiaUkraine war and Middle Eastern tensions have all contributed to a surge in supply chain bottlenecks and constraints in the last few years. These have led to long shipping delays and detours, a shortage of certain products, as well as significant financial losses.
Autonomous cargo and logistics aircraft have the potential to largely reduce many of these constraints. As such, these could likely be ready for large-scale operations as soon as the next five to 10 years, according to Sylvester Kaczmarek, chief technology officer at OrbiSky Systems. However, one of the main factors affecting the timeline for autonomous aircraft is how long it takes to properly understand the risks around artificial intelligence and autonomy, as well as to bring about the appropriate legislation to regulate this technology.
Autonomous aircraft can enhance decisionmaking and situational awareness, especially when analysing data with AI. They can also make hazardous area and remote operations easier, while slashing operational costs and having the potential for 24/7 operations. These aircraft could drastically increase efficiency as well, mainly through optimised fuel consumption and flight routes.
Bill Irby, the CEO of AgEagle Aerial Systems, explained: “The potential payoff is huge. Airlines and military organisations have gone

through many periods of shortages and surplus of pilots and flight crews. Implementing autonomy could help even out the staffing surges.”
Autonomy could mean that more AI technicians and remote operators are required, rather than pilots, significantly changing the landscape of the aviation labour market. Smaller airline crews overall may become the norm. New business models from urban air taxis to high-frequency cargo drones could potentially transform the aviation industry at every level, according to Stockwell. Other business models include rapid middle-mile cargo and specialised delivery and surveillance airplanes.
Michael Healander, CEO and co-founder of Airspace Link, believes that the immediate impact of autonomous aviation will be seen through drones in areas such as infrastructure inspection, emergency services and agricultural monitoring.
“As the digital infrastructure matures, we will see integration with traditional aviation that will eventually extend to autonomous air taxis that move people as well as goods, revolution-

ising urban transportation networks while generating new revenue streams for airports and municipalities,” Healander explained. On the other hand, autonomy will also affect air space management, while requiring the entire industry to bring in more regulations relating to safety, security and fair use of technology.
According to a recent report by McKinsey, a number of companies developing autonomous aircraft could potentially need anywhere between $1bn and $2bn for the development, prototyping and testing needed for type certification alone.
Irby noted that some of those investments were already underway. “Several Advanced Air Mobility (AAM)-focused organisations are already investing many millions of dollars in this emerging area. Government offices are engaged as well, and given what has been underway for the last few years in combat zones, it is evident that government tech investments need to increase to develop and field these technologies at a faster pace,” Irby said.
According to Healander, the US is now in a prime position to lead in the higher-value segments of autonomous systems and airspace management infrastructure. However, more investments from US tech giants, logistics and aerospace companies will be needed to speed
Forecast total global airline industry revenues for 2025
WITH AUTONOMOUS AIRCRAFT, I THINK IT WILL TAKE LONGER TO CONVINCE THE PUBLIC
up this transition. New models of declaring airworthiness and new equipment standards from both government and industry are critical too.
“The countries that will ultimately lead this space will be those that best balance innovation with appropriate regulatory frameworks – creating safe systems for autonomous operations at scale rather than just manufacturing the hardware,” Healander said. To launch autonomous aircraft on a large scale, along with regulatory frameworks, investment also needs to focus on public acceptance and technological infrastructure.
The private sector needs to keep working on detect-and-avoid systems, aircraft design and command-control solutions, among other things. Along with that, public-private partnerships will be key in accelerating this transition. One of the other things required would be advanced inertial navigation systems (INS), which includes next-generation optical gyroscopes. Better AI and autonomous decision-making systems are also needed, which are capable of safety-critical and real-time judgements across the aviation ecosystem.
Along with the significant financial investment needed, one of the main challenges with developing and scaling autonomous aircraft is
creating strong detect-and-avoid capabilities that will ensure safety in dynamic and complex environments. Developing the robust digital infrastructure needed to handle millions of daily flights remotely is also difficult.
Irby highlighted: “True machine-learning and autonomy are very complex areas that require tremendous computing power. This is one pacing limitation if edge-autonomy is the intent, given the size-weight-power tradeoff for aircraft.”
Irby added: “The other complex area is moral clarity and moral application of autonomy. Nations have differing views on the technologies’ application, especially when considering the preciousness of human life.”
Navigating the changing regulatory landscape while retaining public trust can be tricky too, especially when vehicles already offering some autonomous features, like Tesla, continue to face issues.
Bubb said: “How do we regulate autonomous aircraft to ensure they are safe? Given the recent spate of crashes that have taken place, and the deep concern the public has about aviation safety, how do we overcome that concern? With autonomous aircraft, I think it will take longer to convince the public, and we will have to work even harder than we are now.”
However, he pointed out that rapid developments in aircraft technology such as better navigation instruments, aerodynamic efficiency and cabin design are very encouraging. Real-world testing is also much more difficult for autonomous aircraft than it is for autonomous cars, despite some of their similarities. “A UAV cannot just pull over to the side of the highway if there is a problem – so access to airspace for testing and acceptance of test failures are critical to advancing the technology,” said Stockwell.
Another major issue is cybersecurity protection of autonomous systems, as well as a risk management plan in case of technical issues and outages, especially given the widespread impact of the recent Microsoft and Crowdstrike outage. Cybersecurity can ensure that key tools such as navigation, command links and onboard systems are protected from attacks.
Air traffic integration, which involves managing mixed airspace with manned and autonomous aircraft safely, can be difficult too. “We believe the foundation of successful autonomy lies in navigation technologies that are fault-tolerant, precise, and independent, ensuring autonomous flight is not just possible, but safe and scalable in all environments,” Stockwell concluded. n
Airports face growing climate risks, but also new opportunities. Aeroporti di Roma is leading the way with a proactive strategy to enhance resilience, reduce vulnerabilities, and integrate sustainable innovation
WORDS BY Marco Troncone CEO, AEROPORTI DI ROMA






Airports are increasingly exposed to the effects of climate change, which pose significant risks to their operations, safety, economic sustainability and long-term resilience. Yet, within these challenges also lie opportunities. Aeroporti di Roma (ADR) is committed to positioning itself at the forefront of climaterelated initiatives in the airport sector, aiming not only to manage risks but also to seize emerging opportunities.
As complex infrastructures, airports consist of numerous interrelated systems, each with varying degrees of exposure and sensitivity to climate hazards. Many major airports, including those managed by ADR, have been expanded over decades, and the age of certain infrastructure elements can impact their ability to withstand extreme weather events or long-term climate shifts. ADR fully recognises that climate change entails multidimensional risks with clear economic consequences. These include potential higher operating costs, potential declines in revenues, and reduced ability to attract investment or access capital markets.
In response to these challenges, ADR has developed a comprehensive climate change risk analysis methodology, which not only aligns with international best practices such as ICAO guidelines and ISO 14091, but in many areas exceeds them. This methodology categorises climate risks into two broad types: physical risks – those directly related to climate impacts such as storms, floods, heatwaves and sea level rise – and transition risks, which arise from the global shift towards a low-carbon economy. ADR’s primary focus, for now, is on the physical risks.
The analysis process begins with a thorough screening of relevant climate hazards, using the classifications defined in the EU taxonomy. This is followed by the identification of critical airport assets – such as runways, taxiways, aprons and drainage systems – and
The results of the climate change risk analysis have guided the development of ADR’s climate adaptation plan – a strategic and forward-looking framework designed to address future challenges. The plan outlines a series of targeted measures to reduce vulnerability and enhance resilience across all areas of airport infrastructure. These interventions are aligned with broader environmental objectives and are designed to integrate where possible with emission reduction efforts.
In particular, the climate adaptation plan has produced a list of measures defined for the mitigation of the main physical risks related to climate change for Fiumicino and Ciampino airport. The list of measures can be summarised in the following categories: measures to integrate design requirements to take account of the changing climatic phenomena, integra-

Moreover, the anticipated intensification of climate impacts may require additional insurance coverage for critical assets and significant investments to upgrade or rebuild vulnerable infrastructure. All these economic risks are deeply linked to a company’s reputation – an essential factor in maintaining stakeholder trust and ensuring long-term financial viability. At the same time, ADR believes that climate change can generate new avenues for business development through innovation and sustainable solutions in airport operations.
an evaluation of their exposure, sensitivity and capacity to adapt. A dynamic risk modelling phase then assesses how these assets might be affected under different climate scenarios and time horizons, taking into account the possible implementation of mitigation measures.
This detailed and data-driven approach has enabled ADR to identify areas of possible future vulnerability, particularly under the SSP2-4.5 scenario – a ‘middle of the road’ projection in which the global average temperature could rise by around 2.7°C by the end of the century. Based on this analysis, ADR has built a robust foundation for planning and decision-making.
ADR
tion or extension of control models (thermal or energy) or existing monitoring, integration or extension of monitoring and maintenance plans and measures to increase asset resilience against climate changes.
By integrating these technically robust and forward-looking measures, ADR’s climate adaptation plan reflects a proactive and comprehensive approach to climate resilience. It demonstrates the company’s deep commitment to sustainability, not just as a regulatory or reputational necessity, but as a strategic pillar for the future of airport operations. In doing so, ADR aims to maintain stakeholder trust and secure the long-term viability of the infrastructures under its management. n



Data centres are the lynchpin that enables global connectivity. As demand for data centre services continues to intensify, data centres need a forward-looking strategy that delivers the land, power and equipment to support immediate and future requirements, while promoting sustainable choices and energy efficiency
BY
WORDS
Megan Hofmeyer SUSTAINABILITY DIRECTOR, QTS


The development of artificial intelligence and the use of social media, streaming services and other technology is driving unprecedented demand for data centres. Building new data centres is impeded by a lack of viable land in primary data centre markets, a constrained power grid, supply chain delays and labour constraints. A heightened focus on sustainability adds another layer of complexity. To address these challenges and meet immediate and future demand, data centre providers need to modernise their growth strategies.
QTS’s approach to procurement integrates strategic investments in land, large-scale power and critical equipment – as well as access to carbon-free energy – to address both immediate and future infrastructure needs for customers. Leveraging this approach, we have created a roadmap to introduce more than 35 new facilities with more than 3,800 megawatts by 2028.
Land availability has become increasingly limited due to difficult-to-secure entitlements and new government regulations that limit new data centre development to preserve land for other uses. With primary data centre markets oversaturated, data centre providers are moving outside of traditional locales to areas with ample land, rich connectivity and carbon-free energy sources. This shift positions data centres to scale to meet future demand and satisfy hyperscalers’ preference for large-scale data centre campuses.
QTS’s land-banking strategy evaluates multiple future sites well in advance to enable mega campuses that maximise the number of
onsite facilities, minimising community impact and offering options for long-range customer deployments. The transition to large campuses also delivers economic benefits and helps solve labour constraints by providing predictable, long-term projects for construction partners.
Accessing power amid a restricted power grid is another obstacle. Utilities are struggling to keep pace with demand, lengthening power procurement timelines. Data centre providers with contracted power capacity at scale are better able to support incremental demand from key hyperscale tenants.
QTS implements long-term power provider partnerships and utility agreements years before commissioning. QTS also works closely with utility companies to identify innovative and sustainable ways to generate and secure power that best serve our customers, the community and the environment.
QTS has signed long-term contracts for solar- and wind-generated energy in multiple states, including Texas, Illinois, New Jersey and Georgia. We also advocate for more costeffective renewables pricing. In partnership with the Clean Energy Buyers Alliance (CEBA), we strive to unlock the marketplace for all non-residential energy buyers and transition to a zero-carbon energy future.
To address equipment and infrastructure delivery timelines, which have more than doubled in the past two years, QTS pre-positions standardised equipment more than 24 months in advance, securing a long-term growth roadmap. This advanced purchasing model is reinforced by our Freedom Standard Data
Year by which 35 new facilities with more than 3,800 megawatts are planned

Centre Design, which standardises every element of the data centre. Utilising consistent equipment across facilities allows us to lean in and buy hundreds of megawatts worth of equipment to alleviate supply chain delays.
Sustainable initiatives and conservation
As data centres adapt their expansion strategies, sustainability and energy efficiency remain focal points. QTS is an industry leader in sustainability and data centre efficiency. We support policy change and integrate a variety of energy-efficient practices and solutions into our facilities, including energy-efficient cooling, Energy Star appliances, LED lighting and occupancy sensors.
To create a more sustainable future, we developed the QTS Freedom Design, a bestin-class standardised data centre model implemented across all our new data centres. The design employs a low-pressure pumped refrigerant system to remove heat without consuming water. By eliminating the use of water to cool data centres, the Freedom De-

sign system saves more than 48 million gallons of water annually per data centre – the equivalent of water use from more than 2,200 US homes per year. Because the cooling system does not consume water, QTS Freedom Design data centres deliver a water usage effectiveness (WUE) of zero. WUE is the most relevant metric for measuring water use and conservation in the data centre industry. All new data centre builds will continue to use this water-free cooling system to improve water conservation in every community in which we operate. To conserve water in legacy facilities, QTS employs additional watersaving and reuse practices, including rooftop rainwater collection systems and reclaimed water programmes.
QTS’s water conservation efforts extend beyond our data centre operations. We partner with World Vision, a world leader in humanitarian efforts, to provide clean water to in-need individuals and communities across the globe. Through our Water Fund programme, QTS supplies clean drinking water
DATA
to three people for every 100kW of customer contracted power, continuing the donation for the life of each contract. For larger, 12+MW contracts, QTS finances the construction of a sustained clean water source, such as a well or water point, for the duration of each contract, providing an entire community with a long-term supply of clean water. To date, QTS has subsidised 23 water points, supporting over 65,000 individuals, including those in the region of Makusa B, Zambia, in September 2024.
QTS is committed to economic development that provides meaningful return on investment for the communities we call home. That includes creating construction, manufacturing and technology jobs, fostering economic growth through tax revenues, working with
local suppliers, and operating as trusted neighbours and responsible stewards of the environment and community resources.
Data centres generate hundreds of millions of dollars in tax revenue for local communities. This revenue goes to advancing community initiatives while significantly reducing the tax burden on residents. To enhance our communities, we implement plans to preserve, improve and create public amenities; provide workforce development programmes, training and job opportunities; and protect the natural environment and its wildlife.
As widespread digitalisation increases data centre demand, data centres with innovative solutions will be prepared to address market trends and guide strategic investments to remain ahead of the curve. QTS is at the forefront of digital transformation with a forward-leaning plan that integrates mega data centre campuses, large-scale power procurement and aggressive purchasing timelines to support global connectivity and hyperscaler expectations, sustainably. n
As climate change reshapes global water realities, DuPont Water Solutions is driving innovation in treatment technologies – helping industries reduce costs, cut emissions, and build a more resilient, sustainable water future
In another example, the Sustainability Navigator was used to measure the CO2 emission savings generated by advancing the performance of reverse osmosis membranes as compared to predecessor technology.
Tina Arrowood
GLOBAL






Water and sustainability have always been inextricably linked. As our planet warms, we feel the impact of climate change through changes in water. Climate change is increasing the frequency and severity of droughts, flooding, sea level rise and other phenomena, putting the quantity and quality of our freshwater resources at risk. That is why the role of the water sector is more important than ever – innovating numerous ways to optimise this precious resource to meet our domestic, industrial and agricultural needs.
Today, DuPont Water Solutions technologies purify more than 50 million gallons of water every minute in 112 countries. While some of these water purification approaches have been trusted and used for decades, our most recent advancements are unlocking previously untapped water sources and enabling our customers to reliably treat challenging waters – including wastewater – for reuse.
With water resiliency solutions more vital than ever, water treatment innovators are in line with the overarching water sector objective – to reduce the total cost of water. This goes beyond lowering operational costs but also includes reducing the environmental footprint. While the sector embraces this need, it has often been hard to compare solutions or make the business case for modernisation for sustainability. As such, in 2024 our team introduced the Water Solutions Sustainability Navigator, a digital tool that enables users to compare how different potential water treatment solutions impact sustainability indicators, including carbon emissions, chemical usage, wastewater produced, solid waste generated, and spatial footprint – with calculations third-party verified to be in conformance with relevant ISO standards.
The tool compares various water treatment technologies, whether from DuPont or from other manufacturers. Currently, the tool allows users to input four different water treatment technologies – reverse osmosis, ultrafiltration, ion exchange resins, and membrane bioreactors – used alone or in combination. With many factors influencing the design and selection of water treatment solutions, the tool helps users better understand the interconnection of sustainability-driven choices and the cost of operations.
By uncovering solutions that require fewer chemicals, less energy or a smaller spatial footprint, our customers are not only reducing their impact on the planet, but also driving

Using the World Business Council for Sustainable Development (WBCSD) Avoided Emissions Guidance, a recent case study showcases how DuPont’s commitment to advance the performance of its membranes, such as FilmTec BW30 PRO-400 reverse osmosis elements, supports the reduction of carbon emissions among their global customers.
Advanced FilmTec BW30 PRO-400 RO elements, introduced to the market in 2022, transform brackish water sources into highquality freshwater to secure water access for industrial, energy, or municipal users while using lower operating pressures, as compared to the previous versions.

down the total cost of water. In one example of the tool’s use, the United Arab Emirates’ (UAE) energy strategy includes a commitment to Net Zero by 2050. This region relies on energy-intensive seawater desalination to supply freshwater and was seeking a lower carbon footprint desalination process.
OUR MOST RECENT ADVANCEMENTS ARE UNLOCKING PREVIOUSLY UNTAPPED WATER SOURCES
As such, these advanced membranes require three percent less energy to operate –leading to reduced carbon emissions (180 MT CO2e for a mid-sized facility over a five-year operating lifetime of the element) and costs for users.
50 million
Gallons of water purified by DuPont technologies every single minute
A planned 320MM litre per day UAE desalination system was studied using the navigator tool, and the use of FilmTec Seamaxx RO element was estimated to provide the lowest carbon impact and energy use over its estimated five-year operating life compared to other elements in its class. In a system this size, the potential carbon impact savings over the next best element alternative were estimated at 46,000 MT CO2e.
As achieving water resiliency continues to rise in priority around the globe, DuPont’s water treatment innovations are ready to be put to work and help make more freshwater available regardless of the local water challenges. Moreover, choosing technologies best suited to lower the cost of operations and reduce the environmental footprint is made easier through the use of the Water Solutions Sustainability Navigator. We are especially proud to be named by World Finance as the most sustainable in the water sector – increasing the sustainability of our sector will enable a more secure water future for humans in every part of the world. n











The green pound is up for grabs, and companies are keen to help us spend ours. But how do consumers spend in a way that is genuinely less harmful to the environment and avoid the greenwashing trap?
Ruth Kibble FEATURES WRITER






The climate crisis has rightly or wrongly become a multi-billion-dollar marketing opportunity, but for individual consumers, the simple decision to ‘buy green’ can in fact be fraught with challenges. What use is buying an item marketed as eco-friendly but purchasing it from well-known polluters like Temu, which mass-produce thousands of tons of plastic per day, wrap it in more plastic, and ship to your door from thousands of miles away? And can we expect the everyday consumer to know and understand the implications of every single purchase in order to arrive at a decision that feels good but actually does good too?
For decades, small-scale, profitable eco-initiatives that blended environmental messaging with commercial success have launched, grown, become darlings of the market, and been snapped up by multinationals or, worse, had a crash down to earth after initial success. Big names that seemed to get this right for a long time were Tesla (at the vanguard of the EV sector until the recent catastrophic market consequences of Musk’s entry into politics), the Body Shop (independent for decades, bought by L’Oréal in 2006, and barely survived administration in 2024), Innocent Smoothies (famously now owned by Coca-Cola) and Wild plastic-free deodorant (recently acquired by Unilever).
Buying green and feeling seen Ethical start-ups capture the hearts and minds of consumers who want to ease their conscience, but is it ‘selling out’ when those brands are acquired by big players, even if they are offering the capacity and resources to make the large-scale impact founders dream of? With every small start-up product that gets snapped up, fans of the original complain vehemently, but it also speaks to the willingness of corporates to pay attention and respond to consumer demand.
Certainly, big companies are buying the disruptors’ reputations that they could not generate organically, but it also speaks to an awareness of market trends towards that

able as well as lucrative. It is a tricky route to navigate; maintaining the authenticity of these brands after acquisitions is crucial, as that often serves as their key differentiator. The moment that unique appeal fades, the brand risks becoming just another product, leading to disillusioned customers going elsewhere. But the reality is that customers who buy these products are often prepared to pay a premium, and big brands know this. They can market the product as a way for consumers to ‘do their bit’ and charge more accordingly, often because higher-quality, low-carbon emissions products genuinely do cost more to make and distribute, but also because there is a healthy profit margin that can be built in when such production happens at the scale that the big brands can access.
Anything and everything we purchase takes some sort of resource from somewhere, and that can feel difficult to grapple with for large, research-heavy purchases like cars, let alone dozens of times per week in your average supermarket shop.
“Customers who buy these products are often prepared to pay a premium, and big brands know this”
No one can claim ignorance of the crisis at hand: buying any item in 2025 means stewardship and responsibility of that item, including its packaging, carbon footprint, air miles, and disposal at the end of its useful life. That should be considered when making the decision to buy.
It is easy to simply say ‘buy less,’ but even that requires a level of diligence and determination to beat the algorithms slickly designed to sell, sell, sell, no matter the environmental cost. We can, and should, take a moment before spending our money anywhere to think – do I really need this? Where is my money going? Can I afford it, and what is the impact?
However, from making the items that are available in the first place, to considering options for environmentally friendly disposal at the end of their life, every consumer is operating within an imperfect system. Those of us privileged enough to be able to choose can do so in a way that strikes a balance between ethical and convenient. But the poorest in society, those who cannot access high-quality organic foods, plastic-free household items, electric vehicles and so on, must also operate within such a system, and with less privilege and bandwidth to allocate to such decisions. It is how the system supports itself, and us, to do better, that makes a bigger difference. While green consumerism is a step forward, vigilance is needed to ensure real impact, not just profit or empty promises. n

Is cork helping to decarbonise the wine industry? Corticeira Amorim, the world leader in cork stoppers, explains how innovation and nature combine to deliver stoppers with a negative carbon footprint
WITH
INTERVIEW
Antonio Rios de Amorim
CEO & CHAIRMAN, CORTICEIRA AMORIM



Cork has been part of winemaking history for centuries, but today it is helping to shape a more sustainable future. At the heart of this transformation is Corticeira Amorim, the world’s largest producer and exporter of cork products, recognised for its commitment to natural solutions with a positive environmental impact. Founded in Portugal in 1870, Corticeira Amorim has grown from a family business to a global leader with operations in more than 100 countries. While its product range now extends from flooring to aerospace-grade composites, it remains best known for its high-performance cork stoppers, producing over 5.3 billion a year.
Yet this is far from an old-world industry. With heavy investment in R&D, technical innovation and sustainability, Corticeira Amorim is redefining the role of the humble cork stopper. New data verified by APCER (the Portuguese Association for Certification) confirms that Corticeira Amorim is capable of producing cork stoppers with a negative carbon footprint – making them not only one of the most natural ways to seal a bottle of wine, but also among the most climate-friendly.
A tree that gives back more than it takes To understand cork’s environmental superpower, you have to start at the source: the cork oak tree. Native to the Mediterranean and central to Portugal’s unique Montado (cork oak forest), the cork oak is the only tree whose bark can regenerate after harvesting. Far from harming the tree, regular stripping every nine years keeps it healthy and allows it to capture even more carbon.
In fact, cork oak forests not only sequester carbon, but also retain it over long periods of time, as the trees live on average for 200 years.
According to an investigation cited by Corticeira Amorim, cork oak forests sequester up to 73 tonnes of CO₂ for every tonne of cork harvested. This makes cork a highly effective natural carbon sink, while also helping to preserve rich biodiversity and prevent desertification. Because the carbon is stored in the bark itself, and not just the tree, harvesting and using cork products doesn’t deplete that storage, it extends it. That is a large part of what makes cork-based products like Corticeira Amorim’s stoppers environmentally positive across their life cycle.
73 tonnes
Of CO2 is sequestered by cork oak forests for every tonne of cork harvested
Stretching across southern Portugal and parts of Spain, the cork oak forest is
a unique agroforestry system dominated by cork oaks. It is a delicate balance of economy, ecology and culture that has been sustained for centuries. But cork is only part of the cork oak forest’s story. This system supports a remarkable level of biodiversity, including endangered species like the Iberian lynx and the Spanish imperial eagle. The cork oak itself is vital in preventing desertification, storing carbon and supporting soil health. Unlike monoculture plantations, the cork oak forest offers a model of sustainable land use, where economic productivity and environmental stewardship go hand-in-hand.
Because of its unique environmental, economic, and cultural importance, there is growing support for the cork oak forest to be recognised as a UNESCO World Heritage Site. This would acknowledge not only its ecological value but also the deep-rooted human traditions that have helped preserve it over generations.
Corticeira Amorim’s recent carbon footprint studies, based on ISO 14067 standards (a standard that provides guidelines for quantifying and reporting the carbon footprint of a product) and verified by APCER, analysed around 60 percent of its stopper portfolio. The results were striking. From natural corks to advanced technical solutions like Spark Top II, all tested stoppers showed a negative carbon footprint, ranging from –28.7g CO₂ eq per stopper to as much as –56.4g CO₂ eq.
That means that each cork not only requires little energy to produce, but also ac-

tively removes more carbon than it emits throughout its production cycle – from bark to bottling. For winemakers, the implications are significant. More than half of the greenhouse gas emissions in the wine industry are attributed to the manufacture and shipping of glass bottles. By using cork stoppers, the overall carbon footprint of the wine packaging can be reduced. Switching to cork becomes one effective way to decarbonise operations, without compromising quality or sensory performance. “Cork stoppers continue to be a strong ally for producers of still, sparkling and fortified wines,” says António Rios de Amorim, Chairman and CEO. “In addition to their unique technical characteristics, they make a significant contribution to reducing the overall carbon footprint of wine packaging.”
Sustainability backed by science
Corticeira Amorim’s footprint assessments cover the entire cradle-to-gate journey of the product, from raw material extraction through to the factory gate. This includes all greenhouse gases, not just CO₂, but also methane, nitrous oxide and others, across each life cycle phase.
This method ensures consistency and comparability across different products and manufacturing models, regardless of regional differences in energy sources, transport or recycling infrastructure. It also allows winemakers, regulators, and environmentallyconscious consumers to make informed decisions based on reliable, third-party verified data.
The cork industry produces no cork waste in the traditional sense”
António Rios de Amorim adds: “At Corticeira Amorim we work daily to develop more sustainable solutions, in line with a continuous strategy to reduce the environmental impact of our processes, while preserving the unique ecosystem that is the cork oak forest.”
Every day, Corticeira Amorim produces around 21 million cork stoppers. With three core market segments, still wine, sparkling wine and spirits, the company’s reach spans both the traditional heartlands of Europe (France, Italy, Spain, Germany and Portugal) and major New World wine regions, such as the US and Chile. To support this vast production while ensuring quality and performance, Corticeira Amorim invests heavily in R&D, particularly in the areas of sensory neutrality and trichloroanisole (TCA) detection. Its cutting-edge screening techniques ensure that cork taint (caused by TCA compounds) is effectively eliminated, allowing producers to benefit from cork’s sustainability without sacrificing consistency. This combination of scale, science and sustainability is why so many leading global wineries now view Corticeira Amorim as an integral part of their climate strategy, not just a supplier.
A circular economy
5.3 billion
One of Corticeira Amorim’s defining strengths is its commitment to circularity. The cork industry produces no cork waste in the traditional sense. Every off-cut or byproduct is transformed into valuable raw material from stopper-grade granules to insulation, flooring and even aerospace applications. This model ensures that every gram of cork serves a purpose, often in multiple sectors. Corticeira Amorim’s ‘zero waste’ philosophy from cork means that stoppers don’t just close bottles, they open doors to maximise the potential of the Corticeira Amorim cork solutions business across multiple industries from aerospace to automotive. It is a system built not only on innovation, but also on respect for a natural material that has been serving human needs for generations.
Recycling cork: closing the loop
In addition to repurposing manufacturing by-products, Corticeira Amorim leads and supports extensive cork recycling initiatives across Europe and North America. These programmes invite consumers to return used cork stoppers via wine retailers, restaurants and collection points, giving cork a valuable second life.
While recycled cork can’t be used to make new stoppers, it can be transformed into everything from acoustic panels and sports flooring to shoe soles, designer furniture, and car components. This reuse supports Corticeira Amorim’s circular economy principles, extending cork’s lifecycle, reducing waste and preserving its environmental benefits, including carbon retention.
Corticeira Amorim backs several highimpact recycling projects. In Portugal, ‘Green Cork’ supports native reforestation through cork collection. In France, ‘ÉcoBouchon’ combines recycling with charitable giving and now leads globally in cork collection. Italy’s ETICO programme involves thousands of volunteers and supports social causes through stopper donations. A partnership with NH Hotel Group has placed hundreds of collection bins in hotels across Europe, while a South African initiative adds job creation to the recycling effort.
In the US, the ‘Cork Collective’ continues this global commitment to sustainability. Launched in 2024, the initiative is a collaboration between Corticeira Amorim, Rockwell Group, BlueWell, and Southern Glazer’s Wine & Spirits, focused on collecting and recycling cork stoppers from leading hotels and restaurants across New York. Using electric vehicles, the stoppers are gathered from venues including Gramercy Tavern, Nobu and the Marriott hotel chain, then transported to a specialist facility in Wisconsin where they are cleaned, crushed, and repurposed into products ranging from flooring to aerospace materials.
These programmes not only reduce waste but also help inform consumers about the importance of material recovery and sustainable product choices. By extending the value chain beyond the bottle, they make cork a catalyst for environmental engagement, not just in wineries, but in homes and communities around the world. n
BA Glass is advancing its sustainability journey with measurable impact, from reducing carbon emissions and boosting cullet use to adopting renewable energy and low-emission transport across its operations
WORDS BY

crucial role in our environmental efforts. Last year alone, this initiative led to the production of 15 million lighter glass containers, resulting in a reduction of approximately 240 tons of CO₂ into the atmosphere.

Tiago Moreira da Silva CEO, BA GLASS



BA Glass continues to lead the way in sustainability, building on a long-standing commitment to reducing environmental impact. Every step taken reinforces the company’s role in driving positive changes for a greener future.
Sustainability in business is not merely a trend topic, but a critical responsibility. As global expectations for environmental and social accountability continue to rise, at BA Glass sustainability is at the core of every decision-making process. We believe that transparency is essential to building a sustainable future – much like the inherent qualities of glass itself. Guided by its core sustainability pillars – people, social accountability, environmental responsibility, shareholders, customers and consumers – BA Glass ensures a balanced and responsible approach to growth and innovation.
As part of our ongoing commitment and in alignment with Science Based Targets initiative (SBTi) goals, we have made measurable progress in reducing our carbon footprint. In 2020, BA Glass had its emissions reduction targets approved by the SBTi, committing to a 50 percent reduction in scope one and two emissions by 2035. Since then, we have made steady progress – in the past year alone, we reduced our scope one emissions by nearly two percent, placing us approximately nine percent ahead of the SBTi trajectory. These results continually strengthen our confidence in reaching our ultimate goal of carbon neutrality by 2050.
In 2024, BA Glass made significant strides in reducing its carbon footprint by enhancing the use of cullet (recycled glass) in the production process. The cullet incorporation rate increased by five percentage points compared to 2023, leading to an estimated reduction of 26,000 tons in CO2 emissions, highlighting the focus on circularity and sustainable resource management. In Romania, the introduction of Deposit-Return System (DRS)
improved significantly the glass collection and the volumes of cullet available, resulting in a big increase of cullet incorporation when compared to previous years. In the future we expect to continue to increase the cullet volume, reaching a record level.
Also, in consonance with its commitment to circularity and to ensure greater availability of recycled glass, BA Glass acquired the Recresco Glass Recycling Group in 2024. This integration of Recresco’s operations into the BA Glass Group reinforces our dedication to closing the loop on glass packaging. With Recresco’s sorting and processing facilities now part of our network, BA Glass is better positioned to boost cullet recovery, enhance operational efficiency and further accelerate progress towards its decarbonisation goals.
Although BA Glass has increased the recycled glass incorporation, the ambition to progress further remains strong. The greatest challenge continues to be the cullet’s attainability. In this context, the Plataforma Vidro+ was created in Portugal – of which BA Glass is a member – to unite efforts between companies and citizens, playing a crucial role in promoting best practices and reinforcing cullet use in production, which resulted in the growth of memberships and related initiatives.
Beyond a continuous focus on circularity, BA Glass is committed to optimising the efficiency of its furnaces, supported by a sustained investment strategy in advanced technologies. These upgrades are essential in improving operational sustainability and reducing overall environmental impact.
A significant milestone in our sustainability efforts is the successful incorporation of biomethane at one of our production plants. By transitioning from natural gas to biomethane, BA Glass has reduced CO₂e emissions by approximately 1,500 tons. This initiative places the company at the forefront of biomethane adoption in the glass packaging industry.
Our commitment to sustainability also encompasses the design of our products. Through continuous innovation in packaging design, our ‘lightweight programme’ plays a
Recognising our long-term commitment to responsible growth, all electricity consumed at BA Glass’ plants, since 2022, has been sourced entirely from renewable energy, resulting in zero scope two emissions. We remain firmly committed to this clean energy strategy and plan to increase the installed capacity of photovoltaic systems in the coming year, reinforcing our renewable energy infrastructure. Driven by our sustainability goals, at BA Glass we have made significant progress in managing returnable packaging. Despite ongoing market growth, we have maintained high pallet return levels, successfully retrieving over 3.6 million pallets, reducing material waste, and improving operational flow.
In line with our commitment to sustainable logistics, BA Glass continues to advance lowemission transport solutions. At the end of 2024, the first electric truck was tested in Villafranca de los Barros plant and is now operating routes to Seville, with plans to expand the electric fleet in the coming year. The use of alternative fuels – including biomethane, HVO and bio-LNG – was also extended across divisions, contributing to further CO₂ reductions in transportation. To improve efficiency on key routes, intermodal logistics were strengthened by combining road, rail, and short-sea shipping. Additionally, the adoption of duo trailers has supported fuel savings and a further decrease in emissions.
In addition to these initiatives, collaboration with our clients is essential to driving progress in sustainability. Through our Collab2Zero initiative, these partnerships have been strengthened, promoting collective action towards decarbonisation. In 2024, productive discussions with key customers led to impactful actions and significant progress in reducing environmental impact.
BA Glass’ commitment to sustainability is a continuous journey, built on a strategy that evolves with time. By integrating sustainability into every aspect of our operations, we remain focused on driving positive change that not only benefits the environment but also society as a whole. n

As global temperatures continue to rise and consumers become evermore conscious of their footprint, companies across the board are upping their sustainability measures. Laura French reports >>
2024 was the first calendar year to see global temperatures average more than 1.5°C higher than pre-industrial levels, according to data by the Copernicus Climate Change Service –leading experts to fear we are one step closer to reaching the longer-term 1.5°C rise the 2015 Paris agreement has long attempted to prevent. “We must exit this road to ruin – and we have no time to lose,” UN Secretary-General António Guterres said in his 2025 New Year message, describing the last decade – which marked the 10 warmest years on record – as “climate breakdown.”
While the spate of record-breaking highs doesn’t necessarily mean we are doomed, it is certainly a wake-up call to countries and corporations to take action (and fast). Many businesses are doing their bit – for the sake of their bottom line as much as the planet. Consumers are demanding sustainability and accountability from corporations in ever-increasing numbers, and as Gen Z and Millennials continue to take on an ever-increasing slice of the pie, organisations that don’t take genuine action are likely to get left behind.
According to a recent report by AI platform First Insight, 62 percent of Gen Z shoppers prefer to buy from sustainable brands, and 73 percent would pay more for sustainable products. A recent Morgan Stanley survey meanwhile found that 99 percent of Millennials and 73 percent of Gen Z are interested in sustainable investing.
“Both Gen Z and Millennials expect sustainability to be part of the baseline – not just a brand add-on,” says Philippa Cross, Founder and CEO of sustainability collective Marshall Sustainability. “Research also shows the vast majority of Millennials and Gen Z want to work for companies with strong environmental values,” she says. With these two groups set to make up 74 percent of the global workforce by 2030, according to research firm Forrester, it is crucial for businesses to adapt if they are to attract top talent.
“In response, we are seeing more businesses set net-zero goals, create greener workplaces and support employees with education, incentives and Employee Resource Groups focused on sustainability,” she says. Adriel Lubarsky, Founder of Beehive Climate, believes ESG in business is about managing risk. “Companies excel at handling cyber, geopolitical and operational risks – sustainability should be no different,” he told Forbes. “To win with Gen Z, companies need to understand the risk of inaction or inauthentic action, weigh that against the risk of lost market share, and lean into ESG and sustainable values hard, all underpinned by transparency.”
Because if doing the basics or simply waxing lyrical once cut it, it doesn’t now. “Thanks to frameworks like EU CSRD and growing scrutiny, brands are being held to account for where they truly impact and influence,” says Cross. “As sustainability matures, the focus is shifting from glossy commitments to real delivery – especially at the product and service level.”
Cross continues: “The key is honest, proportional storytelling. Recycled packaging is a start, but real credibility comes from tackling the biggest impacts – like raw material sourcing in the core product.” So how are companies across the globe meeting the challenge? From IKEA to Apple, we have profiled a handful of businesses taking steps in the right direction to reduce their carbon footprint, embrace a circular economy and support communities across the world.

Adventure clothing brand and B-Corp, Patagonia, has been a sustainability pioneer since its California beginnings in 1973. Under Founder Yvon Chouinard – a pioneering rock climber and long-time environmental champion – the company began donating one percent of its sales to environmental preservation in 1985. Chouinard then encouraged other businesses to do the same by co-launching ‘one percent for the planet,’ a global network that now has around 5,000 members following suit.
Under the scheme, Patagonia has pledged more than $140m to grassroots environmental groups in the US and beyond, adding to a whole raft of other initiatives. These include carbon-cutting measures such as using only ‘preferred materials’ – namely organic cotton and recycled polyester and nylon – and using 100 percent renewable energy for its owned-and-operated stores and offices. The company has also partnered with organisations to fund residential solar units, and with local communities to protect natural spaces. It launched a ‘Worn Wear’ programme, enabling customers to trade in and buy second-hand clothes, established Patagonia Action Works to connect individuals to organisations targeting
environmental issues, and regularly petitions; in 2017, Patagonia even attempted to sue President Trump in coalition with other groups to protect Native American land. But the most drastic measure of them all came in 2022, when Chouinard donated ownership of the entire $3bn company to trust and non-profit organisation Holdfast Collective – meaning all profits would be used to fight climate change and protect the planet.
ALL PROFITS WOULD BE USED TO FIGHT CLIMATE CHANGE AND PROTECT THE PLANET
“We are going to give away the maximum amount of money to people who are actively working on saving this planet,” Chouinard told The New York Times. “I didn’t know what to do with the company because I didn’t ever want a company,” he said. “I didn’t want to be a businessman. Now I could die tomorrow and the company is going to continue doing the right thing for the next 50 years, and I don’t have to be around.”
Patagonia is a winning example of sustainability and philanthropy at its best. And if the numbers are to go by – revenue reportedly exceeded $1bn in 2024 – it has certainly paid off from a business standpoint, too. n
$140m
€7.5bn INVESTED IN RENEWABLE ENERGY PROJECTS
It might sound like a paradox for a company long centred on fast, disposable furniture to be truly sustainable, but the Swedish furniture brand has taken significant strides in going green.
Circularity is at the heart of many of its initiatives, including a buy-back and resell programme which means customers can return used furniture in exchange for store credit. The company is also transitioning to clean energy (75 percent of its production was already running on renewable electricity in 2024), and is investing more than €7.5bn in renewable energy projects, including wind and solar farms.
Electric vehicles have also been introduced to its delivery fleet to help meet its environmental goals – which include cutting greenhouse gas emissions from its value chain by 50 percent by 2030 compared to 2016, and reaching net-zero emissions by 2050.
Working with local communities is also a key focus for the brand. “In 2024, IKEA supported over 81,000 people through community programmes, and expanded efforts in refugee employment and biodiversity,” Karen Pflug, Chief Sustainability Officer, told World Finance. Last year in the US, the firm even constructed and donated a sustainably built home to a small village in Texas that would house vulnerable residents, using “trauma-informed design” to support wellbeing.
Experts agree IKEA is doing things the right way. “I often point to IKEA as a sustainability leader,” says Marshall Sustainability’s Cross. “They don’t shy away from the tough conversations – including the role that affordable goods can play in driving overconsumption,” she says.
WE ARE FOCUSED ON MAKING SUSTAINABLE LIVING MORE AFFORDABLE AND ACCESSIBLE
“Instead, they have tackled it head-on with initiatives like sourcing FSC-certified wood, improving product durability and experimenting with circular models. I also appreciate their transparency; they openly share the challenges they face and invite feedback, which is key to building trust and real progress.”
Pflug, meanwhile, says making sustainability more accessible is a key focus for the company. “We know that people want to take more climate action, but often face barriers like cost and convenience,” she says. “We are focused on making sustainable living more affordable and accessible – through services like buyback and resell, and by continuing to improve how we bring products and solutions that help people live more sustainably every day.”

Where things go from here remains to be seen, but the furniture company certainly looks set to be trailblazing a promising path. n

$34.4m PUT TOWARDS NON-PROFIT CAUSES
Workday – which provides businesses with financial, IT and human capital management solutions through an AI platform –reached net-zero carbon emissions in 2020 and has been operating entirely on renewable energy since then. The organisation is one of the first in the world to have achieved a lifetime net-zero carbon footprint, and in 2023 joined Frontier, donating new funds to help the $1bn advance market commitment targeted at supporting carbon removal technologies.
In 2024, the company also committed to a multi-year carbon credit offtake agreement to support projects in partnership with climate tech firm Patch. These range from protecting forest in the Amazon using remote sensing to carbon removal using biochar in Namibia, and plugging orphaned oil and gas wells to target methane emissions. Other efforts include donating $1m to support mangrove reforestation projects in Mexico and Kenya to sequester carbon.
Under a Green Team Leadership Programme, employees are meanwhile encouraged to lead sustainability initiatives in their local offices – from waste reduction campaigns to Earth Day activities and com-
As the first wind-powered brewery in the US and the producer of the country’s first certified carbon neutral beer (Fat Tire), Fort Collins-based New Belgium Brewing Company is something of a pioneer in the beer field. It uses a number of innovations – from ‘sun tubes’ for natural lighting to methane produced from wastewater to generate energy – and has a goal for all production facilities to be powered solely by renewable energy by 2030.
The company also advocates for climate action as a member of the ‘We Are Still In’ movement – where it sits on the leadership circle alongside Microsoft and other giants – and co-founded the Glass Recycling Coalition to boost recycling rates. To encourage sustainable commutes, employees are even given an ‘anniversary bike’ when they have been with the company for a year. Wider sustainability efforts range from regenerative agriculture and water stewardship to responsible sourcing and land use.
The self-proclaimed ‘Human Powered Business’ also works heavily with local communities; in 2024, it invested in more than 360 non-profit organisations (and last September its distribution centre in Asheville became a drop-in for those affected by Hurricane Helene).
munity projects – with budget and promotional material provided by the company.
The goal of the Green Teams is to enable employees to become “stewards of the Earth,” according to Erik Hansen, Chief Sustainability Officer. Workday Green Teams have helped a school district go green by implementing a composting, recycling and landfill system; cleaned up the coast of Bull Island in Dublin by recycling and composting hundreds of pounds of waste; and planted young trees in Auckland, New Zealand.
“We put some bold commitments in place several years ago at Workday to keep moving in a positive direction to protect our planet, and we are certainly not slow ing down,” Hansen says.
According to Hansen, an internal sur vey found 96 percent of employees felt Workday was doing its fair share to reduce its environmental impact. DitchCarbon, a platform that analyses business’ emissions, meanwhile gives it a score higher than 99 percent of others in the industry – proof in the pudding that this is another company taking genuine steps to address some of the planet’s most pressing issues. n
It was also the first brewery to join ‘one percent for the planet’ back in 2008. “This means that for every barrel of beer sold, we donate $1 to non-profits across the US,” says Meghan Oleson, Social Impact Senior Manager. “That amounts to a total of more than $34.4m put towards helping solve some of the world’s most pressing social and environmental challenges.”
But Walker Modic, Senior Director of Environmental Programs, recognises there are still obstacles to overcome. “There are many challenges to meeting sustainability goals. One such challenge is that much of our impact happens outside our operational control,” he says. “For example, our packaging materials are recyclable, but that doesn’t mean they always get recycled due to regional recycling infrastructure challenges or consumer behaviour, which are both difficult to change.
“However, by using less energy, switching to cleaner sources and collaborating across our value chain, we can do our bit to reduce costs and minimise environmental harm,” he says. “If we can be the proof point that business can be a force for good and that doing so makes it a stronger business, we believe it will be that little bit easier for other businesses to do the same.” n
Workday
$1m DONATED TO SUPPORT MANGROVE REFORESTATION PROJECTS


Sustainability and cars might not always go hand in hand, but electrification and other efforts are helping to go some way in mitigating impact – and Renault is among those leading the charge. It launched the Refactory – ‘Europe’s first circular economy factory dedicated to mobility’ – in the French commune of Flins in 2021, aimed at extending vehicle life through a ‘retrofit, re-energy, recycle and restart’ programme, in the words of the company. Services range from repairing and reconditioning EV batteries to retrofitting combustion-engine cars into electric vehicles.
It is not the only step being taken. The group has set a goal to achieve carbon neutrality in Europe 2040 and worldwide by 2050 through a number of other measures, not least EVs; 90 percent of its vehicles in Europe are due to be battery-electric by 2030. Some progress has already been made toward the targets – Renault saw its carbon footprint fall by 28 percent from 2010 to 2023 – and the company is aiming to create positive impact in the wider industry, too. In 2022, it launched ‘The Future is NEUTRAL,’ offering recycled materials and reused parts to “support industry players in moving towards resource neutrality,” in the words of Chief Executive Jean-Philippe Bahuaud.
Renault says it is also aiming to up its use of recycled materials in production. The Scenic E-Tech, an electric family SUV launched in 2024, uses recycled materials for a quarter of its parts, with 90 percent of the car’s mass also recyclable. Innovations include floor mats made from recycled plastic bottles, recycled seat upholstery, a steering wheel coated in bio-sourced materials and cotton weft, and a cockpit that uses 26 percent recycled plastic.
The electric Renault 5 E-Tech – the ‘city car’ being rolled out this year – will meanwhile feature a slew of sustainability features, with its modules designed to have a 35 percent lower carbon footprint than those of its predecessor, ZOE, by 2030.
The automobile firm is also attempting to help mitigate impact on wildlife through various initiatives – including a project in Thailand to train local farmers in agroforestry and help reduce the impact of rubber cultivation on biodiversity (in partnership with Michelin). While there is still some way to go before the car industry could be considered the height of sustainability, Renault is among those forging a positive path. n

From resource extraction to energy-guz zling production lines, mobile phone and tech manufacturers might not be the poster child for eco-friendliness, either; but many, including both Samsung and Apple, are taking notable strides to reduce their impact.
In April, Apple announced it had cut its global greenhouse gas emissions by more than 60 percent compared to 2015 levels, marking significant progress towards its 2030 goal of becoming carbon neutral.
The brand introduced its first fully carbon neutral products in 2023 in the form of various Apple Watches, achieving a 75 percent reduction in emissions (with the remaining emissions offset via carbon credits invested in nature-based projects).
Last October, a carbon neutral Mac mini was rolled out, made with over 50 percent recycled content, while the new MacBook Air, introduced in early 2025, uses over 55 percent recycled content.
All Apple-designed batteries are now made from 99 percent recycled cobalt – and for those looking to get rid of their old devices, Apple Trade In allows customers to bring in old Apple products to be recycled in exchange for credit. The recent Environment Progress Report outlined a series of
other milestones – not least having powered every Apple facility with renewable energy since 2018. “That progress is quickly making its way across our global supply chain, and today, our suppliers now support more than 17.8 gigawatts of clean energy around the world,” wrote Lisa Jackson, Vice President of Environment, Policy and Social Initiatives, in the report.
Waste issues are meanwhile being addressed under a Zero Waste programme; in 2024, participating suppliers redirected around 600,000 metric tons of waste from landfills. The company’s Supplier Clean Water Programme has also seen more than 90 billion gallons of fresh water saved since it was introduced in 2013, promoting water reuse at facilities around the world.
WE CAN PROTECT THE PLANET AND SUPPORT THE COMMUNITIES MOST SIGNIFICANTLY IMPACTED
“We are also investing in clean energy projects to match the energy our customers use to charge their devices,” she said, pointing to the company’s Power for Impact programme, which includes renewable energy projects in the Philippines, Thailand, South Africa and beyond. “By expanding access to safe, reliable electricity, we can protect the planet and support the communities most significantly impacted by climate change.”
Apple is also investing in carbon removal projects through its Restore Fund, whose projects include reforesting the Atlantic Forest in Brazil, now “filled with native tree species that could have been lost forever,” in Jackson’s words.
There is still more to be done – not least around flying; Apple’s corporate travel emissions were down 31 percent in 2023 compared to 2019, but this lags behind the average reduction seen by other major tech companies, according to a Travel Smart campaign by Transport and Environment.
Nonetheless, the tech giant is certainly a promising example, using innovation to drive sustainability in characteristically Apple fashion, all while benefitting the bottom line.
Revenue grew by more than 65 percent in the same period that emissions fell by 60 percent, showing that profitability and sustainability can go hand in hand if done in the right way – and as we move into the future, and watch as Gen Z takes to the stage, the first might just well become the key to achieving the second. n


David Orrell
AUTHOR AND ECONOMIST
Since first challenging the myths of mainstream economics, it is clear many of those old assumptions still shape the field, despite mounting real-world contradictions
I wrote my first Econoclast column for this magazine 15 years ago, in the spring of 2010. The economy at the time was recovering from the deepest recession since the 1930s. As I argued in the column, the recession had been blamed on many things, but the real reasons could be traced back to a set of economic myths which have been cultivated and maintained over the last century and a half, ever since economics was invented. These myths include the ideas that markets are stable, self-regulating and efficient; the idea of rational economic man; and even the idea that the economy can be described in terms of mathematical laws.
Today of course things have moved on. For one thing, I see that the number one song in March 2010 (by Kesha) was called ‘Tik Tok’ but it had nothing to do with an app! In the world of economics, though, we still seem to be stuck in the past. Nobel laureate economist Paul Krugman wrote in 2018 that “Neither the financial crisis nor the Great Recession that followed required a rethinking of basic ideas” and most economists seem to agree.
For an update from the front line, I contacted Cahal Moran, who was a co-founder of the Post-Crash Economics Society, a student group set up in 2012. He now runs the YouTube channel Unlearning Economics and is a Visiting Fellow at the London School of Economics. In his opinion, “equilibrium approaches still dominate modelling” although organisations such as the Bank of England “supplement their approaches with some more heterodox or historical analysis.”
And while there is more interest today in areas such as behavioural economics or datadriven approaches, an economics education – the famous Econ 101 – is still biased towards the core concepts, or economyths as I called them, of rationality, equilibrium and efficiency. Perhaps though we shouldn’t expect things to change so quickly.
After all, while the field of neoclassical economics has only been around since the late 19th century, the underlying myths go back much further.
The focus of that first 2010 column was the myth of equilibrium, as acted out by ye olde ‘law of supply and demand.’ This imagines markets as consisting of suppliers on one side, and consumers on the other. The propensity of the former to supply the good is represented as a function of price by a line going up, so the dearer the good, the more is produced. The propensity of the consumer to buy the good is represented by a line going down.
The point where these two curves intersect represents the optimal price which gives a sta-
ble equilibrium between buyer and seller, and in theory optimises the utility of both buyer and seller. Or, as the neoclassical economist William Stanley Jevons put it in 1871, both parties then “rest in satisfaction and equilibrium, and the degrees of utility have come to their level, as it were.”
The picture is therefore of an economy in a state of happy equilibrium where everything finds its proper level. It was later formalised by Eugene Fama’s efficient market hypothesis – variously described as ‘the best established fact in all social sciences’ and ‘probably the best-tested proposition in all the social sciences’ – which claimed that prices effectively adjust instantaneously to new information.
This view of the markets as stable and optimal would be familiar to any first-year student studying economics in 2010 or equally
2025. But the idea that everything finds its level would have been equally acceptable two millennia earlier.
According to Aristotle, whose word was considered sacrosanct well into the Middle Ages, the universe was made up of the four elements earth, water, air and fire, plus the fi fth element, ether, which was reserved for the heavens. Each element had its place, so earth would tend to sink and air would rise. In a vacuum, each element would find its level instantaneously, which was why ‘nature abhors a vacuum’ (Medieval philosopher: ‘probably the best established fact in natural philosophy’). In neoclassical economics, the perfect vacuum exists, and it is the market. Prices always find their proper level, and dynamics don’t really matter, although they are sometimes included as a kind of friction to slow adjustment, just as in Aristotelian physics.
Now, one would think that an event like the 2007–08 financial crisis would be enough information to shake economics out of its own Aristotelian state of happy equilibrium. As I pointed out in 2010, other fields – such as computational biology – don’t try to model a complex, organic, dynamic, living system by using an equilibrium model. In biology, if a system is at equilibrium, it is dead.
And speaking as an applied mathematician who has worked in diverse areas including engineering, weather forecasting, and drug development, I can report that the approach of modelling such a system as the intersection of two lines, as in the law of supply and demand, is …unusual.
But if there is one other thing that we can learn from the endurance of Aristotelian philosophy, it is that once ideas become established, they can be very hard to get rid of. Let’s just hope this equilibrium doesn’t last another 15 years, let alone 2,000. n







